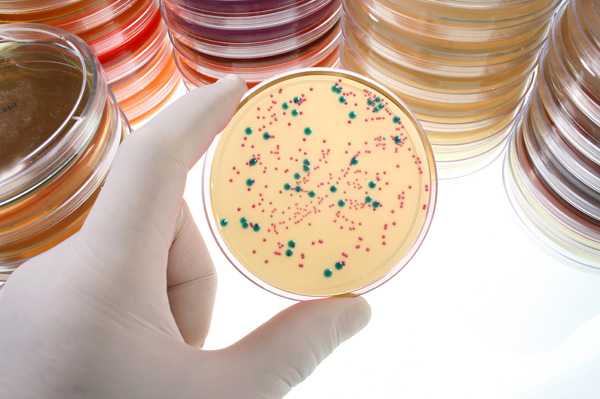

ΠΡΠ΄Π΅Π»Π΅Π½ΠΈΡ ΠΏΠΎΡΠ»Π΅ ΠΏΡΠΈΠΆΠΈΠ³Π°Π½ΠΈΡ ΡΡΠΎΠ·ΠΈΠΈ ΡΠ΅ΠΉΠΊΠΈ ΠΌΠ°ΡΠΊΠΈ: ΠΊΠ°ΠΊΠΈΠΌΠΈ ΠΎΠ½ΠΈ Π΄ΠΎΠ»ΠΆΠ½Ρ Π±ΡΡΡ Π² Π½ΠΎΡΠΌΠ΅?
ΠΠ²ΡΠΎΡΡ | ΠΠΎΡΠ»Π΅Π΄Π½Π΅Π΅ ΠΎΠ±Π½ΠΎΠ²Π»Π΅Π½ΠΈΠ΅: 2019
ΠΠ½Π΅ Π·Π°Π²ΠΈΡΠΈΠΌΠΎΡΡΠΈ ΠΎΡ Π²ΡΠ±ΡΠ°Π½Π½ΠΎΠ³ΠΎ ΠΌΠ΅ΡΠΎΠ΄Π°, ΠΏΡΠΈΠΆΠΈΠ³Π°Π½ΠΈΠ΅ ΡΠ΅ΠΉΠΊΠΈ ΠΌΠ°ΡΠΊΠΈ β ΡΡΠΎ ΡΡΠ°Π²ΠΌΠ°. ΠΠΎΡΠ»Π΅ Π»Π΅ΡΠ΅Π½ΠΈΡ ΠΎΠ±ΡΠ°Π·ΡΠ΅ΡΡΡ ΡΠ°Π½Π΅Π²Π°Ρ ΠΏΠΎΠ²Π΅ΡΡ Π½ΠΎΡΡΡ, ΠΎΡΠΊΡΡΡΠ°Ρ Π΄Π»Ρ ΠΏΡΠΎΠ½ΠΈΠΊΠ½ΠΎΠ²Π΅Π½ΠΈΡ ΠΈΠ½ΡΠ΅ΠΊΡΠΈΠΈ. ΠΠ°ΠΆΠΈΠ²Π»Π΅Π½ΠΈΠ΅ ΡΠΊΠ°Π½Π΅ΠΉ ΠΏΡΠΎΡ ΠΎΠ΄ΠΈΡ ΠΎΠΏΡΠ΅Π΄Π΅Π»Π΅Π½Π½ΡΠ΅ ΡΡΠ°ΠΏΡ, ΠΈ Π²ΡΠ΄Π΅Π»Π΅Π½ΠΈΡ ΠΏΠΎΡΠ»Π΅ ΠΏΡΠΈΠΆΠΈΠ³Π°Π½ΠΈΡ ΡΡΠΎΠ·ΠΈΠΈ ΡΠ΅ΠΉΠΊΠΈ ΠΌΠ°ΡΠΊΠΈ Π²ΠΎΠ·Π½ΠΈΠΊΠ°ΡΡ Π½Π΅ΠΈΠ·Π±Π΅ΠΆΠ½ΠΎ. ΠΡ Ρ Π°ΡΠ°ΠΊΡΠ΅Ρ ΠΌΠΎΠΆΠ΅Ρ Π±ΡΡΡ ΡΠ°Π·Π»ΠΈΡΠ½ΡΠΌ: Π²ΡΠ΅ ΠΎΠΏΡΠ΅Π΄Π΅Π»ΡΠ΅ΡΡΡ Π΄Π½Π΅ΠΌ ΠΏΠΎΡΠ»Π΅ ΠΏΡΠΎΡΠ΅Π΄ΡΡΡ ΠΈ ΠΎΠ±ΡΠΈΠΌ ΡΠΎΡΡΠΎΡΠ½ΠΈΠ΅ΠΌ ΠΆΠ΅Π½ΡΠΈΠ½Ρ. ΠΠΎΠ·ΠΌΠΎΠΆΠ½ΠΎ ΠΏΠΎΡΠ²Π»Π΅Π½ΠΈΠ΅ ΠΏΠ°ΡΠΎΠ»ΠΎΠ³ΠΈΡΠ΅ΡΠΊΠΈΡ Π²ΡΠ΄Π΅Π»Π΅Π½ΠΈΠΉ, ΠΊΠΎΡΠΎΡΡΠ΅ ΡΡΠ΅Π±ΡΡΡ Π΄ΠΎΠΏΠΎΠ»Π½ΠΈΡΠ΅Π»ΡΠ½ΠΎΠΉ Π΄ΠΈΠ°Π³Π½ΠΎΡΡΠΈΠΊΠΈ ΠΈ Π»Π΅ΡΠ΅Π½ΠΈΡ.
Β
ΠΠ°ΠΊ ΠΏΡΠΎΠΈΡΡ ΠΎΠ΄ΠΈΡ Π½ΠΎΡΠΌΠ°Π»ΡΠ½ΠΎΠ΅ Π·Π°ΠΆΠΈΠ²Π»Π΅Π½ΠΈΠ΅
ΠΡΠ±Π°Ρ ΡΠ°Π½Π° ΠΏΡΠΎΡ ΠΎΠ΄ΠΈΡ Π½Π΅ΡΠΊΠΎΠ»ΡΠΊΠΎ ΡΠ°Π·, ΠΏΡΠ΅ΠΆΠ΄Π΅ ΡΠ΅ΠΌ Π½Π° Π΅Π΅ ΠΌΠ΅ΡΡΠ΅ ΠΎΠ±ΡΠ°Π·ΡΠ΅ΡΡΡ Π½ΠΎΠ²ΡΠΉ ΡΠΏΠΈΡΠ΅Π»ΠΈΠΉ:
- ΠΠΎΡΠΏΠ°Π»Π΅Π½ΠΈΠ΅;
- ΠΡΠΎΠ»ΠΈΡΠ΅ΡΠ°ΡΠΈΡ;
- ΠΠΏΠΈΡΠ΅Π»ΠΈΠ·Π°ΡΠΈΡ.
ΠΡΠΎΠ±Π΅Π½Π½ΠΎΡΡΡΡ Π·Π°ΠΆΠΈΠ²Π»Π΅Π½ΠΈΡ ΡΠ°Π½Ρ ΠΏΠΎΡΠ»Π΅ ΠΏΡΠΈΠΆΠΈΠ³Π°Π½ΠΈΡ ΡΡΠΎΠ·ΠΈΠΈ ΡΠ²Π»ΡΠ΅ΡΡΡ ΡΠΎ, ΡΡΠΎ ΠΎΠ½ΠΎ ΠΏΡΠΎΠΈΡΡ ΠΎΠ΄ΠΈΡ ΠΏΠΎΠ΄ ΡΡΡΡΠΏΠΎΠΌ. ΠΡΡΡΡΠΎ ΠΎΠ±ΡΠ°Π·ΠΎΠ²Π°Π²ΡΠΈΠ΅ΡΡ ΡΠ³ΡΡΡΠΊΠΈ ΠΊΡΠΎΠ²ΠΈ Π·Π°ΠΊΡΠΏΠΎΡΠΈΠ²Π°ΡΡ ΡΠΎΡΡΠ΄Ρ, ΠΊΡΠΎΠ²ΠΎΡΠ΅ΡΠ΅Π½ΠΈΡ Π½Π΅Ρ. Π‘Π²Π΅ΡΠ½ΡΠ²ΡΠ°ΡΡΡ ΠΊΡΠΎΠ²Ρ, Π»ΠΈΠΌΡΠ° ΠΈ ΡΠΊΠ°Π½Π΅Π²Π°Ρ ΠΆΠΈΠ΄ΠΊΠΎΡΡΡ ΠΎΠ±ΡΠ°Π·ΡΡΡ Π½Π° ΠΏΠΎΠ²Π΅ΡΡ Π½ΠΎΡΡΠΈ ΡΠ°Π½Ρ ΠΊΠΎΡΠΊΡ, ΠΊΠΎΡΠΎΡΠ°Ρ Π·Π°ΡΠΈΡΠ°Π΅Ρ ΠΎΡ ΠΏΡΠΎΠ½ΠΈΠΊΠ½ΠΎΠ²Π΅Π½ΠΈΡ ΠΌΠΈΠΊΡΠΎΠ±ΠΎΠ² ΠΈΠ»ΠΈ ΠΏΠΎΠ²ΡΠΎΡΠ½ΠΎΠΉ ΡΡΠ°Π²ΠΌΡ.
Π€Π°Π·Π° Π²ΠΎΡΠΏΠ°Π»Π΅Π½ΠΈΡ Π²ΡΡΠ°ΠΆΠ΅Π½Π° Π½Π΅Π·Π½Π°ΡΠΈΡΠ΅Π»ΡΠ½ΠΎ. Π ΠΌΠ΅ΡΡΡ ΡΡΠ°Π²ΠΌΡ ΡΡΠ΅ΠΊΠ°ΡΡΡΡ Π»Π΅ΠΉΠΊΠΎΡΠΈΡΡ ΠΈ ΡΠΈΠ±ΡΠΎΠ±Π»Π°ΡΡΡ, ΠΊΠΎΡΠΎΡΡΠ΅ ΠΏΠΎΠ³Π»ΠΎΡΠ°ΡΡ ΠΏΠΎΠ²ΡΠ΅ΠΆΠ΄Π΅Π½Π½ΡΠ΅ ΠΊΠ»Π΅ΡΠΊΠΈ ΠΈ Π²Π΅ΡΠ΅ΡΡΠ²Π°, ΠΎΠ±ΡΠ°Π·ΠΎΠ²Π°Π²ΡΠΈΠ΅ΡΡ Π² ΠΏΡΠΎΡΠ΅ΡΡΠ΅ ΡΠ°ΡΠΏΠ°Π΄Π°. Π ΡΡΠΎ ΠΆΠ΅ Π²ΡΠ΅ΠΌΡ ΡΡΠΈΠΌΡΠ»ΠΈΡΡΠ΅ΡΡΡ ΡΠΈΠ½ΡΠ΅Π· ΠΊΠΎΠ»Π»Π°Π³Π΅Π½Π°.
Π ΡΠ°Π·Ρ ΠΏΡΠΎΠ»ΠΈΡΠ΅ΡΠ°ΡΠΈΠΈ Π³ΡΠ°Π½ΡΠ»ΡΡΠΈΠΎΠ½Π½Π°Ρ ΡΠΊΠ°Π½Ρ ΠΏΠΎΠ΄ ΡΡΡΡΠΏΠΎΠΌ ΠΏΠΎΡΡΠ΅ΠΏΠ΅Π½Π½ΠΎ ΡΠ°Π·ΡΠ°ΡΡΠ°Π΅ΡΡΡ, Π² Π½Π΅Π΅ ΠΏΡΠΎΡΠ°ΡΡΠ°ΡΡ ΠΌΠ΅Π»ΠΊΠΈΠ΅ ΡΠΎΡΡΠ΄Ρ. Π ΠΊΠΎΠ½ΡΡ ΡΡΠΎΠ³ΠΎ ΡΡΠ°ΠΏΠ° Π½Π° ΡΠΎΠ½ΠΊΠΎΠΉ ΠΎΠ±ΡΠ°Π·ΠΎΠ²Π°Π½Π½ΠΎΠΉ ΠΊΠΎΠ»Π»Π°Π³Π΅Π½ΠΎΠΌ ΡΠΊΠ°Π½ΠΈ Π²ΠΎΠ·Π½ΠΈΠΊΠ°Π΅Ρ ΠΌΠΎΠ»ΠΎΠ΄ΠΎΠΉ ΡΠΏΠΈΡΠ΅Π»ΠΈΠΉ, ΠΈ ΡΡΡΡΠΏ ΠΎΡΠΏΠ°Π΄Π°Π΅Ρ. Π Π½ΠΎΡΠΌΠ΅ ΡΡΠΎ ΠΏΡΠΎΠΈΡΡ ΠΎΠ΄ΠΈΡ Π½Π° 8-20 ΡΡΡΠΊΠΈ. ΠΡΠ΅ΠΌΡ Π·Π°Π²ΠΈΡΠΈΡ ΠΎΡ ΡΠ°Π·ΠΌΠ΅ΡΠ° Π΄Π΅ΡΠ΅ΠΊΡΠ° Π½Π° ΡΠ΅ΠΉΠΊΠ΅ ΠΈ ΡΠ΅Π°ΠΊΡΠΈΠ²Π½ΠΎΡΡΠΈ ΡΠ°ΠΌΠΎΠ³ΠΎ ΠΎΡΠ³Π°Π½ΠΈΠ·ΠΌΠ°.
ΠΡΠΎΠ»ΠΈΡΠ΅ΡΠ°ΡΠΈΠ²Π½Π°Ρ ΡΠ°Π·Π° ΠΏΡΠΈ Π·Π°ΠΆΠΈΠ²Π»Π΅Π½ΠΈΠΈ ΡΡΠΎΠ·ΠΈΠΈ ΡΠ΅ΠΉΠΊΠΈ ΠΌΠ°ΡΠΊΠΈ Π·Π°ΠΊΠ»ΡΡΠ°Π΅ΡΡΡ Π² ΡΠ°Π·ΡΠ°ΡΡΠ°Π½ΠΈΠΈ ΡΠΏΠΈΡΠ΅Π»ΠΈΠ°Π»ΡΠ½ΠΎΠΉ ΡΠΊΠ°Π½ΠΈ ΠΈ Π·Π°ΠΌΠ΅Π½Π΅ ΠΏΠ΅ΡΠ²ΡΡ Π½Π΅ΠΆΠ½ΡΡ ΠΊΠΎΠ»Π»Π°Π³Π΅Π½ΠΎΠ²ΡΡ Π²ΠΎΠ»ΠΎΠΊΠΎΠ½ Π±ΠΎΠ»Π΅Π΅ ΠΏΡΠΎΡΠ½ΡΠΌΠΈ. Π ΡΡΠΎ Π²ΡΠ΅ΠΌΡ ΡΠ΅ΡΠ°Π΅ΡΡΡ, Π±ΡΠ΄Π΅Ρ Π½Π° ΠΌΠ΅ΡΡΠ΅ ΡΠ°Π½Ρ ΠΏΠΎΡΠ»Π΅ ΠΏΡΠΈΠΆΠΈΠ³Π°Π½ΠΈΡ ΡΡΠ±Π΅Ρ ΠΈΠ»ΠΈ ΡΡΠΎΡΠΌΠΈΡΡΠ΅ΡΡΡ Π·Π΄ΠΎΡΠΎΠ²Π°Ρ ΡΠΏΠΈΡΠ΅Π»ΠΈΠ°Π»ΡΠ½Π°Ρ ΡΠΊΠ°Π½Ρ. ΠΡΠ»ΠΈ Π² ΠΊΠ°ΡΠ΅ΡΡΠ²Π΅ Π»Π΅ΡΠ΅Π±Π½ΠΎΠΉ ΠΏΡΠΎΡΠ΅Π΄ΡΡΡ Π±ΡΠ»Π° Π²ΡΠ±ΡΠ°Π½Π° ΡΠ»Π΅ΠΊΡΡΠΎΠΊΠΎΠ°Π³ΡΠ»ΡΡΠΈΡ, ΡΠΎ ΠΏΠΎΠ²ΡΠ΅ΠΆΠ΄Π΅Π½ΠΈΡ ΠΏΠΎΡΠ»Π΅ Π½Π΅Π΅ Π³Π»ΡΠ±ΠΎΠΊΠΈΠ΅. ΠΠ° ΠΏΠΎΠ²Π΅ΡΡ Π½ΠΎΡΡΠΈ ΡΠ΅ΠΉΠΊΠΈ ΠΏΡΠ΅ΠΎΠ±Π»Π°Π΄Π°Π΅Ρ ΡΠΎΡΠΌΠΈΡΠΎΠ²Π°Π½ΠΈΠ΅ ΠΊΠΎΠ»Π»Π°Π³Π΅Π½ΠΎΠ²ΡΡ Π²ΠΎΠ»ΠΎΠΊΠΎΠ½, ΠΊΠΎΡΠΎΡΡΠ΅ ΠΎΠ±ΡΠ°Π·ΡΡΡ ΡΡΠ±ΡΠΎΠ²ΡΡ ΡΠΊΠ°Π½Ρ. ΠΠΎΡΠ»Π΅ ΡΠ΄Π°Π»Π΅Π½ΠΈΡ ΡΡΠΎΠ·ΠΈΠΈ Β«Π‘ΡΡΠ³ΠΈΡΡΠΎΠ½ΠΎΠΌΒ», ΠΆΠΈΠ΄ΠΊΠΈΠΌ Π°Π·ΠΎΡΠΎΠΌ, Π»Π°Π·Π΅ΡΠΎΠΌ ΠΏΠΎΠ²ΡΠ΅ΠΆΠ΄Π΅Π½ΠΈΡ ΠΏΠΎΠ²Π΅ΡΡ Π½ΠΎΡΡΠ½ΡΠ΅, ΠΏΠΎΡΡΠΎΠΌΡ ΠΊΠ»Π΅ΡΠΊΠΈ Π²ΠΎΡΡΡΠ°Π½Π°Π²Π»ΠΈΠ²Π°ΡΡΡΡ Π±ΡΡΡΡΠ΅Π΅, ΡΠ΅ΠΌ ΡΠ°ΡΡΠ΅Ρ ΡΠΎΠ΅Π΄ΠΈΠ½ΠΈΡΠ΅Π»ΡΠ½Π°Ρ ΡΠΊΠ°Π½Ρ, ΠΈ ΡΡΠ±ΡΡ Π½Π΅ ΡΠΎΡΠΌΠΈΡΡΡΡΡΡ.

Π Π°Π΄ΠΈΠΎΠ²ΠΎΠ»Π½ΠΎΠ²ΠΎΠΉ ΠΌΠ΅ΡΠΎΠ΄ Π»Π΅ΡΠ΅Π½ΠΈΡ Π°ΠΏΠΏΠ°ΡΠ°ΡΠΎΠΌ Β«Π‘ΡΡΠ³ΠΈΡΡΠΎΠ½Β» ΠΏΠΎΠ·Π²ΠΎΠ»ΡΠ΅Ρ ΠΈΠ·Π±Π΅Π³Π°ΡΡ ΡΡΠ±ΡΠ΅Π²Π°Π½ΠΈΡ ΡΠΊΠ°Π½ΠΈ, Π° Π²ΠΎΡΡΡΠ°Π½ΠΎΠ²ΠΈΡΠ΅Π»ΡΠ½ΡΠΉ ΠΏΠ΅ΡΠΈΠΎΠ΄ ΡΠ°ΡΠ΅ Π²ΡΠ΅Π³ΠΎ Π½Π΅ ΡΠΎΠΏΡΠΎΠ²ΠΎΠΆΠ΄Π°Π΅ΡΡΡ ΠΏΠΎΡΠ²Π»Π΅Π½ΠΈΠ΅ΠΌ Π±ΠΎΠ»Π΅Π²ΡΡ ΠΎΡΡΡΠ΅Π½ΠΈΠΉ.
Β
ΠΠ°ΠΊΠΈΠ΅ Π²ΡΠ΄Π΅Π»Π΅Π½ΠΈΡ ΠΎΠΆΠΈΠ΄Π°ΡΡ ΠΏΠΎΡΠ»Π΅ ΠΏΡΠΈΠΆΠΈΠ³Π°Π½ΠΈΡ
Π‘ΡΠ°Π·Ρ ΠΏΠΎΡΠ»Π΅ ΠΏΡΠΈΠΆΠΈΠ³Π°Π½ΠΈΡ ΡΡΠΎΠ·ΠΈΠΈ Π²ΡΡΠ°ΠΆΠ΅Π½Π½ΠΎΠ³ΠΎ ΠΊΡΠΎΠ²ΠΎΡΠ΅ΡΠ΅Π½ΠΈΡ Π½Π΅ Π½Π°Π±Π»ΡΠ΄Π°Π΅ΡΡΡ: ΡΡΡΡΠΏ Π½Π°Π΄Π΅ΠΆΠ½ΠΎ ΡΠΈΠΊΡΠΈΡΡΠ΅Ρ ΡΠΎΡΡΠ΄Ρ. Π ΠΏΠ΅ΡΠ²ΡΠ΅ Π΄Π½ΠΈ ΠΌΠΎΠ³ΡΡ ΠΏΠΎΡΠ²ΠΈΡΡΡΡ Π²ΠΎΠ΄ΡΠ½ΠΈΡΡΡΠ΅ Π²ΡΠ΄Π΅Π»Π΅Π½ΠΈΡ. ΠΠ½ΠΈ ΠΏΡΠΎΠ·ΡΠ°ΡΠ½ΡΠ΅, Π½Π΅Π±ΠΎΠ»ΡΡΠΎΠΉ ΠΈΠ½ΡΠ΅Π½ΡΠΈΠ²Π½ΠΎΡΡΠΈ, Π² Π½ΠΈΡ ΠΌΠΎΠΆΠ΅Ρ Π±ΡΡΡ ΠΏΡΠΎΠΆΠΈΠ»ΠΊΠ°ΠΌΠΈ ΠΊΡΠΎΠ²Ρ. Π’Π°ΠΊΠΈΠ΅ Π²ΡΠ΄Π΅Π»Π΅Π½ΠΈΡ ΠΈΠ΄ΡΡ Π΄ΠΎ 10 Π΄Π½Π΅ΠΉ. ΠΠΎΡΡΠ΅ΠΏΠ΅Π½Π½ΠΎ ΠΎΠ½ΠΈ ΠΌΠ΅Π½ΡΡΡΡΡ Π½Π° ΡΠΎΠ·ΠΎΠ²ΡΠ΅ ΡΠ»ΠΈΠ·ΠΈΡΡΡΠ΅, ΠΊΠΎΡΠΎΡΡΠ΅ Π²ΡΠ³Π»ΡΠ΄ΡΡ Π±ΠΎΠ»Π΅Π΅ Π³ΡΡΡΡΠΌΠΈ. ΠΠ½ΡΠ΅Π½ΡΠΈΠ²Π½ΠΎΡΡΡ ΠΎΠΊΡΠ°ΡΠΈΠ²Π°Π½ΠΈΡ ΠΌΠΎΠΆΠ΅Ρ Π±ΡΡΡ ΡΠ°Π·Π»ΠΈΡΠ½ΠΎΠΉ: ΠΎΡ Π±Π»Π΅Π΄Π½ΠΎ-ΡΠΎΠ·ΠΎΠ²ΠΎΠ³ΠΎ Π΄ΠΎ ΠΊΡΠ°ΡΠ½ΠΎΠ²Π°ΡΠΎΠ³ΠΎ.
ΠΠ° ΡΠ»Π΅Π΄ΡΡΡΠ΅ΠΌ ΡΡΠ°ΠΏΠ΅ ΠΏΠΎΡΠ»Π΅ ΠΏΡΠΈΠΆΠΈΠ³Π°Π½ΠΈΡ ΡΡΠΎΠ·ΠΈΠΈ ΠΎΠΏΡΠ΅Π΄Π΅Π»ΡΡΡΡΡ ΡΠΊΡΠ΄Π½ΡΠ΅ ΠΊΠΎΡΠΈΡΠ½Π΅Π²ΡΠ΅ Π²ΡΠ΄Π΅Π»Π΅Π½ΠΈΡ. ΠΠ½ΠΈ Π³ΡΡΡΡΠ΅, ΠΌΠ°ΠΆΡΡΠΈΠ΅, Π΄Π»ΡΡΡΡ Π½Π΅ Π΄ΠΎΠ»ΡΡΠ΅, ΡΠ΅ΠΌ Π½Π΅Π΄Π΅Π»Ρ.
Π Π½Π΅ΠΊΠΎΡΠΎΡΡΡ ΡΠ»ΡΡΠ°ΡΡ ΡΡΡΡΠΏ ΠΎΡΡ ΠΎΠ΄ΠΈΡ ΠΏΠΎΡΡΠ΅ΠΏΠ΅Π½Π½ΠΎ, ΡΠΎΠ³Π΄Π° Π½Π° ΠΏΡΠΎΡΡΠΆΠ΅Π½ΠΈΠΈ Π²ΡΠ΅Π³ΠΎ Π²ΡΠ΅ΠΌΠ΅Π½ΠΈ ΠΏΠΎΡΠ»Π΅ ΠΏΡΠΈΠΆΠΈΠ³Π°Π½ΠΈΡ ΠΏΠΎΡΠ²Π»ΡΡΡΡΡ Π΅Π³ΠΎ ΠΊΡΡΠΎΡΠΊΠΈ Π² Π²ΠΈΠ΄Π΅ ΠΏΠ»ΠΎΡΠ½ΡΡ ΡΠ³ΡΡΡΠΊΠΎΠ² ΠΊΡΠΎΠ²ΠΈ. ΠΠ½ΠΎΠ³Π΄Π° ΠΊΡΠΎΠ²ΠΎΡΠ΅ΡΠ΅Π½ΠΈΠ΅ ΡΡΠΈΠ»ΠΈΠ²Π°Π΅ΡΡΡ Π½Π° 8-20 Π΄Π΅Π½Ρ ΠΏΠΎΡΠ»Π΅ ΠΏΡΠΈΠΆΠΈΠ³Π°Π½ΠΈΡ. ΠΡΠΎ ΠΏΠΎΠΊΠ°Π·Π°ΡΠ΅Π»Ρ ΠΏΠΎΠ»Π½ΠΎΠ³ΠΎ ΠΎΡΡ ΠΎΠΆΠ΄Π΅Π½ΠΈΡ ΡΡΡΡΠΏΠ°, Π½ΠΎ Π½Π΅ΠΊΠΎΡΠΎΡΡΠ΅ ΡΠΎΡΡΠ΄Ρ ΠΏΡΠΈ ΡΡΠΎΠΌ ΠΏΠΎΠ²ΡΠ΅ΠΆΠ΄Π°ΡΡΡΡ, ΠΈ Π½Π°ΡΠΈΠ½Π°Π΅ΡΡΡ ΠΊΡΠΎΠ²ΠΎΡΠ΅ΡΠ΅Π½ΠΈΠ΅. ΠΠ½ΠΎ Π΄ΠΎΠ»ΠΆΠ½ΠΎ ΠΏΡΠ΅ΠΊΡΠ°ΡΠΈΡΡΡΡ Π·Π° Π½Π΅ΡΠΊΠΎΠ»ΡΠΊΠΎ ΡΠ°ΡΠΎΠ².
ΠΠ°ΠΆΠ½ΠΎ
ΠΡΠ»ΠΈ ΠΊΡΠΎΠ²ΠΎΡΠ΅ΡΠ΅Π½ΠΈΠ΅ Π½Π΅ ΠΏΡΠ΅ΠΊΡΠ°ΡΠ°Π΅ΡΡΡ ΠΈΠ»ΠΈ Π²Π½Π΅Π·Π°ΠΏΠ½ΠΎ ΡΡΠΈΠ»ΠΈΠ²Π°Π΅ΡΡΡ, Π½ΡΠΆΠ½ΠΎ ΡΡΠΎΡΠ½ΠΎ ΡΠΎΠΎΠ±ΡΠΈΡΡ ΠΎΠ± ΡΡΠΎΠΌ Π²ΡΠ°ΡΡ.
ΠΠΎ Π²ΡΠ΅ΠΌΡ ΠΏΡΠΈΠΆΠΈΠ³Π°Π½ΠΈΡ Π²ΠΎΠ·ΠΌΠΎΠΆΠ½ΠΎ ΠΏΠΎΠ²ΡΠ΅ΠΆΠ΄Π΅Π½ΠΈΠ΅ ΡΠΎΡΡΠ΄Π°, ΠΊΠΎΡΠΎΡΡΠΉ ΠΊΡΠΎΠ²ΠΎΡΠΎΡΠΈΡ Π½Π΅ΠΊΠΎΡΠΎΡΠΎΠ΅ Π²ΡΠ΅ΠΌΡ ΠΏΠΎΡΠ»Π΅ ΠΏΡΠΎΡΠ΅Π΄ΡΡΡ. ΠΠΎ Π² Π±ΠΎΠ»ΡΡΠΈΠ½ΡΡΠ²Π΅ ΡΠ»ΡΡΠ°Π΅Π² ΠΊΡΠΎΠ²ΡΠ½ΠΈΡΡΡΠ΅ Π²ΡΠ΄Π΅Π»Π΅Π½ΠΈΡ ΠΏΠΎΡΡΠ΅ΠΏΠ΅Π½Π½ΠΎ ΡΠΌΠ΅Π½ΡΡΡΡΡ Π±Π»Π΅Π΄Π½ΠΎ-ΡΠΎΠ·ΠΎΠ²ΡΠΌΠΈ ΠΈ Π²ΡΠΊΠΎΡΠ΅ ΡΠΎΠ²ΡΠ΅ΠΌ ΠΏΡΠ΅ΠΊΡΠ°ΡΠ°ΡΡΡΡ.

ΠΠ»Π΅Π΄Π½ΠΎ-ΡΠΎΠ·ΠΎΠ²ΡΠ΅ Π²ΡΠ΄Π΅Π»Π΅Π½ΠΈΡ ΠΏΠΎΡΠ»Π΅ ΠΏΡΠΈΠΆΠΈΠ³Π°Π½ΠΈΡ ΡΡΠΎΠ·ΠΈΠΈ ΡΠ΅ΠΉΠΊΠΈ ΠΌΠ°ΡΠΊΠΈ Π½Π°Π±Π»ΡΠ΄Π°ΡΡΡΡ Π² ΡΠ΅ΡΠ΅Π½ΠΈΠ΅ 10-14 Π΄Π½Π΅ΠΉ. ΠΠΎΡΠ»Π΅ ΠΏΠΎΠ»Π½ΠΎΠ³ΠΎ Π·Π°ΠΆΠΈΠ²Π»Π΅Π½ΠΈΡ ΡΡΠ°ΡΡΠΊΠ° Π²ΠΎΠ·Π΄Π΅ΠΉΡΡΠ²ΠΈΡ Π²ΡΠ΄Π΅Π»Π΅Π½ΠΈΡ ΠΏΡΠ΅ΠΊΡΠ°ΡΠ°ΡΡΡΡ.
ΠΠΎΡΠΌΠ°Π»ΡΠ½ΡΠΌΠΈ ΠΌΠΎΠΆΠ½ΠΎ ΡΡΠΈΡΠ°ΡΡ Π²ΡΠ΄Π΅Π»Π΅Π½ΠΈΡ, ΠΊΠΎΡΠΎΡΡΠ΅ Π΄Π»ΡΡΡΡ Π΄ΠΎ 3 Π½Π΅Π΄Π΅Π»Ρ, ΠΏΠΎΡΡΠ΅ΠΏΠ΅Π½Π½ΠΎ ΠΌΠ΅Π½ΡΡΡ ΡΠ²ΠΎΠΉ ΡΠ²Π΅Ρ ΠΈ Π³ΡΡΡΠΎΡΡ ΠΈ Π½Π΅ ΠΈΠΌΠ΅ΡΡ Π½Π΅ΠΏΡΠΈΡΡΠ½ΠΎΠ³ΠΎ Π·Π°ΠΏΠ°Ρ Π°, Π½Π΅ ΡΠΎΠΏΡΠΎΠ²ΠΎΠΆΠ΄Π°ΡΡΡΡ ΠΆΠΆΠ΅Π½ΠΈΠ΅ΠΌ ΠΈ Π·ΡΠ΄ΠΎΠΌ. ΠΠ°ΡΠ΅ΠΌ ΠΏΠΎΡΠ²Π»ΡΡΡΡΡ ΠΎΠ±ΡΡΠ½ΡΠ΅ Π±Π΅Π»ΠΈ, ΠΏΠΎΡΠ»Π΅ ΡΠ΅Π³ΠΎ Π½Π°ΡΡΡΠΏΠ°Π΅Ρ Π²ΡΠ΅ΠΌΡ ΠΌΠ΅Π½ΡΡΡΡΠ°ΡΠΈΠΈ.
Β
ΠΠΎΠ·ΠΌΠΎΠΆΠ½ΡΠ΅ ΠΎΡΠ»ΠΎΠΆΠ½Π΅Π½ΠΈΡ ΠΏΠΎΡΠ»Π΅ ΠΏΡΠΎΡΠ΅Π΄ΡΡΡ
ΠΠΎΡΠ»Π΅Π΄ΡΡΠ²ΠΈΡ Π»Π΅ΡΠ΅Π½ΠΈΡ ΡΡΠΎΠ·ΠΈΠΈ ΡΠ΅ΠΉΠΊΠΈ ΠΌΠ°ΡΠΊΠΈ ΠΌΠΎΠ³ΡΡ Π±ΡΡΡ ΡΠ°Π·Π»ΠΈΡΠ½ΡΠΌΠΈ. ΠΡΠΈ ΠΈΡΠΏΠΎΠ»ΡΠ·ΠΎΠ²Π°Π½ΠΈΠΈ ΡΠΎΠ²ΡΠ΅ΠΌΠ΅Π½Π½ΡΡ ΠΌΠ΅ΡΠΎΠ΄ΠΎΠ² β ΡΠ°Π΄ΠΈΠΎΠ²ΠΎΠ»Π½ΠΎΠ²ΠΎΠ³ΠΎ ΠΈ Π»Π°Π·Π΅ΡΠ½ΠΎΠ³ΠΎ ΠΏΡΠΈΠΆΠΈΠ³Π°Π½ΠΈΡ β ΠΎΠ½ΠΈ ΠΌΠΈΠ½ΠΈΠΌΠ°Π»ΡΠ½Ρ. Π Π·Π°Π²ΠΈΡΠΈΠΌΠΎΡΡΠΈ ΠΎΡ Π²ΠΈΠ΄Π° ΠΎΡΠ»ΠΎΠΆΠ½Π΅Π½ΠΈΡ ΠΌΠΎΠΆΠ΅Ρ ΠΈΠ·ΠΌΠ΅Π½ΡΡΡΡΡ Ρ Π°ΡΠ°ΠΊΡΠ΅Ρ Π²ΡΠ΄Π΅Π»Π΅Π½ΠΈΠΉ:
- ΠΠΎΠ²ΡΠ΅ΠΆΠ΄Π΅Π½ΠΈΠ΅ ΠΊΡΡΠΏΠ½ΠΎΠ³ΠΎ ΡΠΎΡΡΠ΄Π° β ΠΊΡΠΎΠ²ΡΠ½ΡΠ΅, ΡΡΠΊΠΎΠ³ΠΎ Π°Π»ΠΎΠ³ΠΎ ΡΠ²Π΅ΡΠ°;
- ΠΡΠΈΡΠΎΠ΅Π΄ΠΈΠ½Π΅Π½ΠΈΠ΅ ΠΈΠ½ΡΠ΅ΠΊΡΠΈΠΈ β ΠΌΠ΅Π½ΡΠ΅ΡΡΡ ΡΠ²Π΅Ρ ΠΈ Π·Π°ΠΏΠ°Ρ ;
ΠΠ½Π΄ΠΎΠΌΠ΅ΡΡΠΈΠΎΠ· ΡΠ΅ΠΉΠΊΠΈ ΠΌΠ°ΡΠΊΠΈ β Π½Π΅ΠΎΠ±ΡΡΠ½ΡΠ΅ ΡΡΠΎΠΊΠΈ ΠΊΡΠΎΠ²ΡΠ½ΠΈΡΡΠΎΠΉ ΠΌΠ°Π·Π½ΠΈ;- ΠΠΈΡΡΡ β ΠΊΠΎΠ½ΡΠ°ΠΊΡΠ½ΡΠ΅ ΠΊΡΠΎΠ²ΠΎΡΠ΅ΡΠ΅Π½ΠΈΡ;
- Π Π΅ΡΠΈΠ΄ΠΈΠ² ΡΡΠΎΠ·ΠΈΠΈ β ΡΠ²Π΅ΡΠ»ΡΠ΅ ΠΈΠ»ΠΈ ΠΊΡΠΎΠ²ΡΠ½ΠΈΡΡΡΠ΅ Π²ΡΠ΄Π΅Π»Π΅Π½ΠΈΡ.
ΠΡΠΈΠΆΠΈΠ³Π°Π½ΠΈΠ΅ Π½Π΅Π±ΠΎΠ»ΡΡΠΎΠ³ΠΎ Π΄Π΅ΡΠ΅ΠΊΡΠ° ΡΠ΅Π΄ΠΊΠΎ ΡΠΎΠΏΡΠΎΠ²ΠΎΠΆΠ΄Π°Π΅ΡΡΡ ΡΠ°Π·Π²ΠΈΡΠΈΠ΅ΠΌ ΠΎΡΠ»ΠΎΠΆΠ½Π΅Π½ΠΈΠΉ. ΠΠΎΠ»ΡΡΠΈΠ΅ ΠΈ Π·Π°ΠΏΡΡΠ΅Π½Π½ΡΠ΅ ΡΡΠΎΠ·ΠΈΠΈ, ΠΊΠΎΡΠΎΡΡΠ΅ ΡΡΠ΅Π±ΡΡΡ Π±ΠΎΠ»Π΅Π΅ ΡΡΠ°ΡΠ΅Π»ΡΠ½ΠΎΠ³ΠΎ Π²ΡΠ±ΠΎΡΠ° ΠΌΠ΅ΡΠΎΠ΄Π° Π»Π΅ΡΠ΅Π½ΠΈΡ, ΡΠ°ΡΠ΅ ΡΠΎΠΏΡΠΎΠ²ΠΎΠΆΠ΄Π°ΡΡΡΡ Π½Π΅ΠΏΡΠΈΡΡΠ½ΡΠΌΠΈ ΠΏΠΎΡΠ»Π΅Π΄ΡΡΠ²ΠΈΡΠΌΠΈ.
Β
Π§ΡΠΎ ΡΡΠΈΡΠ°ΡΡ Π½Π΅ΠΎΠ±ΡΡΠ½ΡΠΌΠΈ Π²ΡΠ΄Π΅Π»Π΅Π½ΠΈΡΠΌΠΈ
ΠΠ° ΠΈΠ·ΠΌΠ΅Π½Π΅Π½ΠΈΠ΅ΠΌ Ρ Π°ΡΠ°ΠΊΡΠ΅ΡΠ° Π²ΡΠ΄Π΅Π»Π΅Π½ΠΈΠΉ Π½Π΅ΠΎΠ±Ρ ΠΎΠ΄ΠΈΠΌΠΎ Π½Π°Π±Π»ΡΠ΄Π°ΡΡ. ΠΠ»Ρ ΡΠ΄ΠΎΠ±ΡΡΠ²Π° Π½ΡΠΆΠ½ΠΎ ΠΈΡΠΏΠΎΠ»ΡΠ·ΠΎΠ²Π°ΡΡ Π² ΡΡΠΎΡ ΠΏΠ΅ΡΠΈΠΎΠ΄ ΠΏΡΠΎΠΊΠ»Π°Π΄ΠΊΠΈ Ρ ΡΠ΅Π»Π»ΡΠ»ΠΎΠ·Π½ΠΎΠΉ ΠΏΠΎΠ²Π΅ΡΡ Π½ΠΎΡΡΡΡ, Π° Π½Π΅ ΡΠ΅ΡΠΎΡΠΊΠΎΠΉ. ΠΡΠΈΠΌΠ΅Π½ΡΡΡ ΡΠ°ΠΌΠΏΠΎΠ½Ρ ΠΏΠΎΡΠ»Π΅ ΠΏΡΠΈΠΆΠΈΠ³Π°Π½ΠΈΡ ΡΡΠΎΠ·ΠΈΠΈ ΠΊΠ°ΡΠ΅Π³ΠΎΡΠΈΡΠ΅ΡΠΊΠΈ Π·Π°ΠΏΡΠ΅ΡΠ΅Π½ΠΎ. ΠΡΠΎΠΊΠ»Π°Π΄ΠΊΠΈ Ρ Π·Π°ΠΏΠ°Ρ ΠΎΠΌ ΡΠ°ΠΊΠΆΠ΅ Π»ΡΡΡΠ΅ Π½Π΅ ΠΈΡΠΏΠΎΠ»ΡΠ·ΠΎΠ²Π°ΡΡ: Ρ ΠΈΠΌΠΈΡΠ΅ΡΠΊΠΈΠ΅ Π°ΡΠΎΠΌΠ°ΡΠΈΠ·Π°ΡΠΎΡΡ Π²ΡΡΡΡΠΏΠ°ΡΡ Π΄ΠΎΠΏΠΎΠ»Π½ΠΈΡΠ΅Π»ΡΠ½ΡΠΌ ΡΠ°Π·Π΄ΡΠ°ΠΆΠ°ΡΡΠΈΠΌ ΡΠ°ΠΊΡΠΎΡΠΎΠΌ, ΠΊΠΎΡΠΎΡΡΠΉ ΡΠΏΠΎΡΠΎΠ±Π΅Π½ Π²ΡΠ·Π²Π°ΡΡ Π²ΠΎΡΠΏΠ°Π»ΠΈΡΠ΅Π»ΡΠ½ΡΡ Π»ΠΈΠ±ΠΎ Π°Π»Π»Π΅ΡΠ³ΠΈΡΠ΅ΡΠΊΡΡ ΡΠ΅Π°ΠΊΡΠΈΡ ΠΈΠ»ΠΈ ΡΠΏΡΠΎΠ²ΠΎΡΠΈΡΠΎΠ²Π°ΡΡ ΠΌΠΎΠ»ΠΎΡΠ½ΠΈΡΡ.

ΠΠΎΡΠ»Π΅ ΠΊΠΎΠ°Π³ΡΠ»ΡΡΠΈΠΈ ΡΡΠΎΠ·ΠΈΠΈ ΡΠ΅ΠΉΠΊΠΈ ΠΌΠ°ΡΠΊΠΈ ΠΏΠΎΠ»ΡΠ·ΠΎΠ²Π°ΡΡΡΡ ΡΠ°ΠΌΠΏΠΎΠ½Π°ΠΌΠΈ ΡΡΡΠΎΠ³ΠΎ Π·Π°ΠΏΡΠ΅ΡΠ΅Π½ΠΎ, ΠΏΠΎΡΠΊΠΎΠ»ΡΠΊΡ ΡΡΠΎ ΠΌΠΎΠΆΠ΅Ρ ΠΏΡΠΈΠ²Π΅ΡΡΠΈ ΠΊ ΡΡΠ°Π²ΠΌΠ΅ ΡΠ»ΠΈΠ·ΠΈΡΡΠΎΠΉ Π²Π»Π°Π³Π°Π»ΠΈΡΠ°, Π° ΡΠ°ΠΊΠΆΠ΅ Π½Π΅Π³Π°ΡΠΈΠ²Π½ΠΎ Π²ΠΎΠ·Π΄Π΅ΠΉΡΡΠ²ΠΎΠ²Π°ΡΡ Π½Π° Π΅Π³ΠΎ ΠΌΠΈΠΊΡΠΎΡΠ»ΠΎΡΡ.
ΠΠΎΠΌΠΎΡΡ Π²ΡΠ°ΡΠ° Π½Π΅ΠΎΠ±Ρ ΠΎΠ΄ΠΈΠΌΠ° ΠΏΡΠΈ Π½Π΅ΡΠΎΠΎΡΠ²Π΅ΡΡΡΠ²ΠΈΠΈ Π²ΡΠ΄Π΅Π»Π΅Π½ΠΈΠΉ Π½ΠΎΡΠΌΠ°Π»ΡΠ½ΡΠΌ ΠΏΠΎΠΊΠ°Π·Π°ΡΠ΅Π»ΡΠΌ.
ΠΠ΅ΡΠΏΠΎΠΊΠΎΠΈΡΡΡΡ Π½ΡΠΆΠ½ΠΎ Π² ΡΠ°ΠΊΠΈΡ ΡΠ»ΡΡΠ°ΡΡ :
Β
ΠΡΠΎΠ²ΠΎΡΠ΅ΡΠ΅Π½ΠΈΠ΅
ΠΠΎΡΠ²Π»Π΅Π½ΠΈΠ΅ Π°Π»ΠΎΠΉ ΠΊΡΠΎΠ²ΠΈ ΡΠΆΠ΅ ΡΠ΅ΡΠ΅Π· ΡΡΡΠΊΠΈ ΠΏΠΎΡΠ»Π΅ ΠΏΡΠΈΠΆΠΈΠ³Π°Π½ΠΈΡ ΡΡΠΎΠ·ΠΈΠΈ Π³ΠΎΠ²ΠΎΡΠΈΡ ΠΎ ΡΠ°Π½Π΅Π½ΠΈΠΈ ΠΊΡΡΠΏΠ½ΠΎΠ³ΠΎ ΡΠΎΡΡΠ΄Π°. Π‘Π°ΠΌΠΎΡΡΠΎΡΡΠ΅Π»ΡΠ½ΠΎ ΡΠ°ΠΊΠΎΠ΅ ΠΊΡΠΎΠ²ΠΎΡΠ΅ΡΠ΅Π½ΠΈΠ΅ ΠΎΡΡΠ°Π½ΠΎΠ²ΠΈΡΡ Π½Π΅Π²ΠΎΠ·ΠΌΠΎΠΆΠ½ΠΎ, ΠΏΠΎΡΡΠΎΠΌΡ Π½ΡΠΆΠ½ΠΎ ΠΎΠ±ΡΠ°ΡΠΈΡΡΡΡ ΠΊ Π²ΡΠ°ΡΡ, ΠΊΠΎΡΠΎΡΡΠΉ ΠΏΡΠΎΠ²ΠΎΠ΄ΠΈΠ» ΠΎΠΏΠ΅ΡΠ°ΡΠΈΡ, ΠΈ ΠΏΠΎΠΏΡΠΎΡΠΈΡΡ ΡΡΡΡΠ°Π½ΠΈΡΡ Π΄Π΅ΡΠ΅ΠΊΡ. ΠΡΠΎ ΠΌΠΎΠΆΠ΅Ρ Π±ΡΡΡ Π²ΡΠΏΠΎΠ»Π½Π΅Π½ΠΎ ΠΌΠ΅ΡΠΎΠ΄ΠΎΠΌ ΠΊΠΎΠ°Π³ΡΠ»ΡΡΠΈΠΈ β ΠΏΡΠΈΠΆΠΈΠ³Π°Π½ΠΈΡ, ΠΈΠ»ΠΈ ΠΏΡΡΠ΅ΠΌ ΠΏΠ΅ΡΠ΅Π²ΡΠ·ΠΊΠΈ ΡΠΎΡΡΠ΄Π°. ΠΡΠ±ΠΎΡ ΡΠ°ΠΊΡΠΈΠΊΠΈ Π·Π°Π²ΠΈΡΠΈΡ ΠΎΡ Π»ΠΎΠΊΠ°Π»ΠΈΠ·Π°ΡΠΈΠΈ ΡΠΎΡΡΠ΄ΠΎΠ² ΠΈ ΡΠΎΠ³ΠΎ, Π½Π°ΡΠΊΠΎΠ»ΡΠΊΠΎ ΡΠΈΠ»ΡΠ½ΡΠ΅ Π²ΡΠ΄Π΅Π»Π΅Π½ΠΈΡ.
ΠΡΠ»ΠΈ ΠΊΡΠΎΠ²Ρ ΠΏΠΎΡΠ²ΠΈΠ»Π°ΡΡ ΡΠ΅ΡΠ΅Π· 8-20 Π΄Π½Π΅ΠΉ, Π½ΠΎ Π΅Π΅ Π²ΡΠ΄Π΅Π»Π΅Π½ΠΈΠ΅ ΠΏΡΠ΅ΠΊΡΠ°ΡΠΈΠ»ΠΎΡΡ ΡΠ΅ΡΠ΅Π· Π½Π΅ΡΠΊΠΎΠ»ΡΠΊΠΎ ΡΠ°ΡΠΎΠ², ΡΠΎ ΡΡΠΎ ΠΊΡΠΎΠ²ΠΎΡΠ΅ΡΠ΅Π½ΠΈΠ΅ ΡΠ²ΡΠ·Π°Π½ΠΎ Ρ ΠΎΡΡ ΠΎΠΆΠ΄Π΅Π½ΠΈΠ΅ΠΌ ΡΡΡΡΠΏΠ°. ΠΠ΅ΠΏΡΠ΅ΠΊΡΠ°ΡΠ°ΡΡΠ΅Π΅ΡΡ ΠΊΡΠΎΠ²ΠΎΡΠ΅ΡΠ΅Π½ΠΈΠ΅, ΠΏΠΎΠ΄ΡΠ΅ΠΌ ΡΠ΅ΠΌΠΏΠ΅ΡΠ°ΡΡΡΡ β ΡΡΠΎ ΠΏΠΎΠ²ΠΎΠ΄ ΠΎΠ±ΡΠ°ΡΠΈΡΡΡΡ ΡΠΊΡΡΡΠ΅Π½Π½ΠΎ ΠΊ Π²ΡΠ°ΡΡ.
ΠΡΠ΄Π΅Π»Π΅Π½ΠΈΠ΅ ΠΊΡΠΎΠ²ΠΈ ΠΌΠΎΠΆΠ΅Ρ Π½Π°ΡΠ°ΡΡΡΡ ΠΏΠΎΡΠ»Π΅ Π·Π°ΠΆΠΈΠ²Π»Π΅Π½ΠΈΡ ΡΡΠΎΠ·ΠΈΠΈ ΠΈ ΠΏΡΠΎΡΠ΅Π΄ΡΠ΅ΠΉ ΠΌΠ΅Π½ΡΡΡΡΠ°ΡΠΈΠΈ. ΠΠ½ΠΎΠ³Π΄Π° ΠΏΠΎΡΠ»Π΅ ΠΏΠΎΠ»ΠΎΠ²ΠΎΠ³ΠΎ Π°ΠΊΡΠ° Π½Π°Π±Π»ΡΠ΄Π°Π΅ΡΡΡ Π½Π΅ΡΠΈΠ»ΡΠ½Π°Ρ ΠΊΡΠΎΠ²ΡΠ½ΠΈΡΡΠ°Ρ ΠΌΠ°Π·Π½Ρ. Π§Π°ΡΡΠΎ ΠΎΠ½Π° ΡΠ²Π»ΡΠ΅ΡΡΡ ΡΠ΅Π·ΡΠ»ΡΡΠ°ΡΠΎΠΌ ΡΠ°Π·Π²ΠΈΠ²ΡΠ΅Π³ΠΎΡΡ ΠΎΡΠ»ΠΎΠΆΠ½Π΅Π½ΠΈΡ β ΠΊΠΈΡΡ ΡΠ΅ΠΉΠΊΠΈ ΠΌΠ°ΡΠΊΠΈ. Π£ Π½ΠΈΡ Π½Π΅Ρ ΡΠΏΠ΅ΡΠΈΡΠΈΡΠ΅ΡΠΊΠΈΡ ΡΠΈΠΌΠΏΡΠΎΠΌΠΎΠ².
ΠΡΠ»ΠΎΠΆΠ½Π΅Π½ΠΈΠ΅ ΠΌΠΎΠΆΠ΅Ρ ΡΠ°Π·Π²ΠΈΡΡΡΡ ΠΏΠΎΡΠ»Π΅ ΠΏΡΠΈΠΆΠΈΠ³Π°Π½ΠΈΡ ΡΠ΅ΠΉΠΊΠΈ ΠΆΠΈΠ΄ΠΊΠΈΠΌ Π°Π·ΠΎΡΠΎΠΌ, ΠΊΡΠΈΠΎΠ΄Π΅ΡΡΡΡΠΊΡΠΈΠΈ ΠΈ Π΄ΡΡΠ³ΠΈΡ ΠΌΠ΅ΡΠΎΠ΄ΠΎΠ². ΠΡΠΈ ΡΡΠΎΠΌ ΡΡΡΡΠΏ Π·Π°ΠΊΡΠΏΠΎΡΠΈΠ²Π°Π΅Ρ ΠΆΠ΅Π»Π΅Π·Ρ ΠΈ Π½Π΅ ΠΏΠΎΠ·Π²ΠΎΠ»ΡΠ΅Ρ Π½ΠΎΡΠΌΠ°Π»ΡΠ½ΠΎ ΠΎΡΡΠ΅ΠΊΠ°ΡΡ ΠΈΡ ΡΠΎΠ΄Π΅ΡΠΆΠΈΠΌΠΎΠΌΡ. ΠΠΎΡΡΠ΅ΠΏΠ΅Π½Π½ΠΎ ΠΎΠ±ΡΠ°Π·ΡΡΡΡΡ ΠΊΠΈΡΡΠΎΠ·Π½ΡΠ΅ ΡΠ°ΡΡΠΈΡΠ΅Π½ΠΈΡ, ΠΊΠΎΡΠΎΡΡΠ΅ ΠΌΠΎΠ³ΡΡ Π»ΠΎΠΏΠ°ΡΡΡΡ Π²ΠΎ Π²ΡΠ΅ΠΌΡ ΠΏΠΎΠ»ΠΎΠ²ΠΎΠ³ΠΎ Π°ΠΊΡΠ° Ρ Π²ΡΠ΄Π΅Π»Π΅Π½ΠΈΠ΅ΠΌ Π½Π΅Π±ΠΎΠ»ΡΡΠΎΠ³ΠΎ ΠΊΠΎΠ»ΠΈΡΠ΅ΡΡΠ²Π° ΠΊΡΠΎΠ²ΠΈ.
ΠΡΠΎΠ²ΡΠ½ΠΈΡΡΠ°Ρ ΠΌΠ°Π·Π½Ρ, ΠΊΠΎΡΠΎΡΠ°Ρ Π²ΠΎΠ·Π½ΠΈΠΊΠ°Π΅Ρ Π½Π΅Π·Π°Π΄ΠΎΠ»Π³ΠΎ Π΄ΠΎ ΠΌΠ΅Π½ΡΡΡΡΠ°ΡΠΈΠΈ, Π³ΠΎΠ²ΠΎΡΠΈΡ ΠΎΠ± ΡΠ½Π΄ΠΎΠΌΠ΅ΡΡΠΈΠΎΠ·Π΅ ΡΠ΅ΠΉΠΊΠΈ ΠΌΠ°ΡΠΊΠΈ. ΠΠ³ΠΎ ΡΠ°Π·Π²ΠΈΡΠΈΠ΅ ΠΏΡΠΎΠ²ΠΎΡΠΈΡΡΠ΅Ρ ΡΠ°Π½Π½Π΅Π΅ Π½Π°ΡΠ°Π»ΠΎ ΠΌΠ΅ΡΡΡΠ½ΡΡ , Π΅ΡΠ΅ Π΄ΠΎ ΡΠΎΠ³ΠΎ Π²ΡΠ΅ΠΌΠ΅Π½ΠΈ, ΠΊΠΎΠ³Π΄Π° ΠΏΡΠΎΠΈΠ·ΠΎΠΉΠ΄Π΅Ρ ΠΏΠΎΠ»Π½Π°Ρ ΡΠΏΠΈΡΠ΅Π»ΠΈΠ·Π°ΡΠΈΡ ΡΠ°Π½Π΅Π²ΠΎΠ³ΠΎ Π΄Π΅ΡΠ΅ΠΊΡΠ°. ΠΠ»Π΅ΡΠΊΠΈ ΡΠ½Π΄ΠΎΠΌΠ΅ΡΡΠΈΡ Π·Π°ΠΊΡΠ΅ΠΏΠ»ΡΡΡΡΡ ΠΈ Π½Π°ΡΠΈΠ½Π°ΡΡ ΡΠ°ΠΌΠΎΡΡΠΎΡΡΠ΅Π»ΡΠ½ΡΠΉ ΡΠΎΡΡ. ΠΡΠΈ Π·Π½Π°ΡΠΈΡΠ΅Π»ΡΠ½ΡΡ ΡΠ΅ΠΌΠΏΠ°Ρ ΠΈΡ ΡΠ°Π·Π²ΠΈΡΠΈΡ Π½Π° ΡΠ΅ΠΉΠΊΠ΅ ΠΌΠΎΠ³ΡΡ ΠΎΠ±ΡΠ°Π·ΠΎΠ²ΡΠ²Π°ΡΡΡΡ ΠΊΠΈΡΡΡ, Π·Π°ΠΏΠΎΠ»Π½Π΅Π½Π½ΡΠ΅ ΠΊΡΠΎΠ²ΡΠ½ΠΈΡΡΠΎ-ΠΊΠΎΡΠΈΡΠ½Π΅Π²ΡΠΌ ΡΠΎΠ΄Π΅ΡΠΆΠΈΠΌΡΠΌ.
ΠΠ± ΡΠ½Π΄ΠΎΠΌΠ΅ΡΡΠΈΠΎΠ·Π΅ ΡΠ΅ΠΉΠΊΠΈ ΠΌΠ°ΡΠΊΠΈ ΠΌΠΎΠ³ΡΡ Π³ΠΎΠ²ΠΎΡΠΈΡΡ ΠΌΠ°ΠΆΡΡΠΈΠ΅ ΠΊΡΠΎΠ²ΡΠ½ΠΈΡΡΡΠ΅ Π²ΡΠ΄Π΅Π»Π΅Π½ΠΈΡ, ΠΏΠΎΡΠ²Π»ΡΡΡΠΈΠ΅ΡΡ Π΄ΠΎ ΠΌΠ΅Π½ΡΡΡΡΠ°ΡΠΈΠΈ.
Β
ΠΠ·ΠΌΠ΅Π½Π΅Π½ΠΈΠ΅ ΡΠ²Π΅ΡΠ° Π²ΡΠ΄Π΅Π»Π΅Π½ΠΈΠΉ
ΠΠΊΡΠ°ΡΠ΅Π½Π½ΡΠ΅ Π² ΡΠΎΠ·ΠΎΠ²ΡΠΉ ΠΈΠ»ΠΈ ΠΊΠΎΡΠΈΡΠ½Π΅Π²ΡΠΉ ΡΠ²Π΅Ρ Π²ΡΠ΄Π΅Π»Π΅Π½ΠΈΡ ΠΌΠΎΠ³ΡΡ ΠΈΠ·ΠΌΠ΅Π½ΠΈΡΡ Π΅Π³ΠΎ Π½Π° Π΄ΡΡΠ³ΠΎΠΉ. ΠΡΠ»ΠΈ Π²ΡΠ΄Π΅Π»Π΅Π½ΠΈΡ ΡΡΠ°Π½ΠΎΠ²ΡΡΡΡ ΠΆΠ΅Π»ΡΡΠΌΠΈ ΠΈΠ»ΠΈ Π·Π΅Π»Π΅Π½ΠΎΠ²Π°ΡΡΠΌΠΈ, ΠΏΠΎ ΠΊΠΎΠ½ΡΠΈΡΡΠ΅Π½ΡΠΈΠΈ Π±ΠΎΠ»Π΅Π΅ ΠΆΠΈΠ΄ΠΊΠΈΠΌΠΈ, ΡΠΎ ΡΡΠΎ ΠΌΠΎΠΆΠ΅Ρ Π±ΡΡΡ ΠΏΡΠΈΠ·Π½Π°ΠΊΠΎΠΌ ΠΈΠ½ΡΠΈΡΠΈΡΠΎΠ²Π°Π½ΠΈΡ.
Π ΡΠΎΠΌ, ΠΊΠ°ΠΊΠΈΠ΅ Π²ΡΠ΄Π΅Π»Π΅Π½ΠΈΡ ΡΡΠΈΡΠ°ΡΡΡΡ ΠΏΠ°ΡΠΎΠ»ΠΎΠ³ΠΈΡΠ΅ΡΠΊΠΈΠΌΠΈ ΠΈ ΠΎ ΡΠ΅ΠΌ ΠΌΠΎΠΆΠ΅Ρ ΡΠ°ΡΡΠΊΠ°Π·Π°ΡΡ ΠΈΡ Ρ Π°ΡΠ°ΠΊΡΠ΅Ρ, ΡΠ°ΡΡΠΊΠ°Π·ΡΠ²Π°Π΅Ρ Π°ΠΊΡΡΠ΅Ρ-Π³ΠΈΠ½Π΅ΠΊΠΎΠ»ΠΎΠ³ ΠΠΌΠΈΡΡΠΈΠΉ ΠΡΠ±Π½ΠΈΠ½ Π² ΡΠ»Π΅Π΄ΡΡΡΠ΅ΠΌ Π²ΠΈΠ΄Π΅ΠΎ:
ΠΡΠΈΡΠΈΠ½ΠΎΠΉ ΡΠ°Π·Π²ΠΈΡΠΈΡ ΡΡΠΎΠ³ΠΎ ΠΎΡΠ»ΠΎΠΆΠ½Π΅Π½ΠΈΡ ΠΌΠΎΠΆΠ΅Ρ Π±ΡΡΡ Π½Π΅Π΄ΠΎΡΡΠ°ΡΠΎΡΠ½Π°Ρ ΡΠ°Π½Π°ΡΠΈΡ Π²Π»Π°Π³Π°Π»ΠΈΡΠ° ΠΏΠ΅ΡΠ΅Π΄ ΠΏΡΠΎΠ²Π΅Π΄Π΅Π½ΠΈΠ΅ΠΌ ΠΏΡΠΈΠΆΠΈΠ³Π°Π½ΠΈΡ. ΠΡΠ»ΠΈ ΠΏΠΎ ΠΌΠ°Π·ΠΊΠ°ΠΌ Π±ΡΠ»Π° ΡΡΡΠ°Π½ΠΎΠ²Π»Π΅Π½Π° 3-4 ΡΡΠ΅ΠΏΠ΅Π½Ρ ΡΠΈΡΡΠΎΡΡ, ΡΠΎ Π½Π΅ΠΎΠ±Ρ ΠΎΠ΄ΠΈΠΌΠΎ Π»Π΅ΡΠ΅Π½ΠΈΠ΅ ΠΊΠΎΠ»ΡΠΏΠΈΡΠ° ΠΈ ΡΠ΅ΡΠ²ΠΈΡΠΈΡΠ° ΠΏΠ΅ΡΠ΅Π΄ ΠΏΡΠΎΡΠ΅Π΄ΡΡΠΎΠΉ. ΠΠ»Ρ ΡΡΠΎΠ³ΠΎ ΠΈΡΠΏΠΎΠ»ΡΠ·ΡΡΡ Π²Π°Π³ΠΈΠ½Π°Π»ΡΠ½ΡΠ΅ ΡΠ²Π΅ΡΠΈ, ΡΠ°Π±Π»Π΅ΡΠΊΠΈ ΠΈ Π΄ΡΡΠ³ΠΈΠ΅ ΠΌΠ΅ΡΡΠ½ΡΠ΅ Π»Π΅ΠΊΠ°ΡΡΡΠ²Π΅Π½Π½ΡΠ΅ ΡΡΠ΅Π΄ΡΡΠ²Π° Ρ ΡΡΠ΅ΡΠΎΠΌ Π²ΡΡΠ²Π»Π΅Π½Π½ΠΎΠΉ ΡΠ»ΠΎΡΡ.
ΠΠ΅ΠΊΠΎΡΠΎΡΡΠ΅ Π·Π°Π±ΠΎΠ»Π΅Π²Π°Π½ΠΈΡ ΠΏΡΠΎΡΠ²Π»ΡΡΡΡΡ ΡΠΏΠ΅ΡΠΈΡΠΈΡΠ΅ΡΠΊΠΈΠΌ Ρ Π°ΡΠ°ΠΊΡΠ΅ΡΠΎΠΌ Π²ΡΠ΄Π΅Π»Π΅Π½ΠΈΠΉ. ΠΡΠΎ Π²ΠΎΠ·ΠΌΠΎΠΆΠ½ΠΎ ΠΏΡΠΈ ΠΈΠ½ΡΠ΅ΠΊΡΠΈΡΡ , ΠΏΠ΅ΡΠ΅Π΄Π°Π²Π°Π΅ΠΌΡΡ ΠΏΠΎΠ»ΠΎΠ²ΡΠΌ ΠΏΡΡΠ΅ΠΌ. ΠΠ°ΠΏΡΠΈΠΌΠ΅Ρ, ΠΏΡΠΈ ΡΠ°Π·Π²ΠΈΡΠΈΠΈ ΡΡΠΈΡ ΠΎΠΌΠ°Π½ΠΈΠ°Π·Π° Π²ΡΠ΄Π΅Π»Π΅Π½ΠΈΡ ΡΡΠ°Π½ΠΎΠ²ΡΡΡΡ ΠΆΠΈΠ΄ΠΊΠΈΠΌΠΈ, Ρ Π·Π΅Π»Π΅Π½ΠΎΠ²Π°ΡΡΠΌ ΠΎΡΡΠ΅Π½ΠΊΠΎΠΌ, ΠΏΠ΅Π½ΠΈΡΡΡΠ΅.
ΠΠ½ΠΎΠ³Π΄Π° Π½Π°Π±Π»ΡΠ΄Π°Π΅ΡΡΡ ΡΠ°Π·Π²ΠΈΡΠΈΠ΅ Π±Π°ΠΊΡΠ΅ΡΠΈΠ°Π»ΡΠ½ΠΎΠ³ΠΎ Π²Π°Π³ΠΈΠ½ΠΎΠ·Π°. Π’ΠΎΠ³Π΄Π° Π²ΡΠ΄Π΅Π»Π΅Π½ΠΈΡ ΠΏΡΠΈΠΎΠ±ΡΠ΅ΡΠ°ΡΡ Π±Π΅Π»ΡΠΉ ΠΈΠ»ΠΈ ΡΠ΅ΡΠΎΠ²Π°ΡΠΎ-Π±Π΅Π»ΡΠΉ ΡΠ²Π΅Ρ.
Π Π΅Π΄ΠΊΠΎ ΠΏΠΎΡΠ»Π΅ Π»Π΅ΡΠ΅Π½ΠΈΡ ΡΡΠΎΠ·ΠΈΠΈ Π²ΠΎ Π²Π»Π°Π³Π°Π»ΠΈΡΠ΅ ΠΌΠΎΠΆΠ΅Ρ ΠΏΠΎΡΠ²ΠΈΡΡΡΡ Π³ΡΠΈΠ±ΠΎΠΊ β ΠΊΠ°Π½Π΄ΠΈΠ΄ΠΎΠ·. ΠΡΠΈΡΠΈΠ½ΠΎΠΉ ΡΡΠΎΠ³ΠΎ ΡΠ²Π»ΡΠ΅ΡΡΡ ΡΠ½ΠΈΠΆΠ΅Π½ΠΈΠ΅ ΠΌΠ΅ΡΡΠ½ΠΎΠ³ΠΎ ΠΈΠΌΠΌΡΠ½ΠΈΡΠ΅ΡΠ°, ΡΠ½Π΄ΠΎΠΊΡΠΈΠ½Π½Π°Ρ ΠΏΠ°ΡΠΎΠ»ΠΎΠ³ΠΈΡ ΠΈΠ»ΠΈ Π΄ΡΡΠ³ΠΈΠ΅ Ρ ΡΠΎΠ½ΠΈΡΠ΅ΡΠΊΠΈΠ΅ Π·Π°Π±ΠΎΠ»Π΅Π²Π°Π½ΠΈΡ. ΠΡΠΈ ΡΡΠΎΠΌ Π²ΡΠ΄Π΅Π»Π΅Π½ΠΈΡ ΡΡΠ°Π½ΠΎΠ²ΡΡΡΡ ΡΠ²ΠΎΡΠΎΠΆΠΈΡΡΡΠΌΠΈ, Π±Π΅Π»ΡΠΌΠΈ, Π±Π΅ΡΠΏΠΎΠΊΠΎΠΈΡ Π·ΡΠ΄ ΠΈ ΠΆΠΆΠ΅Π½ΠΈΠ΅.
Β
ΠΠ°ΠΏΠ°Ρ
ΠΠΎΠΊΠ° ΠΏΡΠΎΠ»Π΅ΡΠ΅Π½Π½Π°Ρ ΡΡΠΎΠ·ΠΈΡ Π·Π°ΠΆΠΈΠ²Π°Π΅Ρ, Π²ΡΠ΄Π΅Π»Π΅Π½ΠΈΡ Π½Π΅ ΡΠΎΠΏΡΠΎΠ²ΠΎΠΆΠ΄Π°ΡΡΡΡ Π²ΡΡΠ°ΠΆΠ΅Π½Π½ΡΠΌ Π·Π°ΠΏΠ°Ρ ΠΎΠΌ. ΠΠΎ ΠΈΠ½ΠΎΠ³Π΄Π° Π΅Π³ΠΎ ΠΏΠΎΡΠ²Π»Π΅Π½ΠΈΠ΅ Π³ΠΎΠ²ΠΎΡΠΈΡ ΠΎ Π½Π°ΡΡΡΠ΅Π½ΠΈΠΈ Π½ΠΎΡΠΌΠ°Π»ΡΠ½ΠΎΠ³ΠΎ Π²ΠΎΡΡΡΠ°Π½ΠΎΠ²Π»Π΅Π½ΠΈΡ ΡΠ»ΠΈΠ·ΠΈΡΡΠΎΠΉ.
Π Π°Π·ΠΌΠ½ΠΎΠΆΠ΅Π½ΠΈΠ΅ ΡΡΠ»ΠΎΠ²Π½ΠΎ-ΠΏΠ°ΡΠΎΠ³Π΅Π½Π½ΠΎΠΉ ΡΠ»ΠΎΡΡ (Π³Π°ΡΠ΄Π½Π΅ΡΠ΅Π»Π»Ρ) ΠΏΡΠΈΠ²ΠΎΠ΄ΠΈΡ ΠΊ ΡΠΈΠΌΠΏΡΠΎΠΌΠ°ΠΌ Π±Π°ΠΊΡΠ΅ΡΠΈΠ°Π»ΡΠ½ΠΎΠ³ΠΎ Π²Π°Π³ΠΈΠ½ΠΎΠ·Π°. ΠΡΠΎΡ ΠΌΠΈΠΊΡΠΎΠΎΡΠ³Π°Π½ΠΈΠ·ΠΌ Π² ΠΏΡΠΎΡΠ΅ΡΡΠ΅ ΠΆΠΈΠ·Π½Π΅Π΄Π΅ΡΡΠ΅Π»ΡΠ½ΠΎΡΡΠΈ Π²ΡΠ΄Π΅Π»ΡΠ΅Ρ Π»Π΅ΡΡΡΠΈΠ΅ Π°ΠΌΠΈΠ½Ρ, ΠΊΠΎΡΠΎΡΡΠ΅ ΠΏΠΎ Π·Π°ΠΏΠ°Ρ Ρ Π½Π°ΠΏΠΎΠΌΠΈΠ½Π°ΡΡ ΡΡΡ Π»ΡΡ ΡΡΠ±Ρ.
ΠΠΏΠ°ΡΠ½ΡΠΌ ΠΏΡΠΈΠ·Π½Π°ΠΊΠΎΠΌ ΡΠ²Π»ΡΡΡΡΡ Π²ΡΠ΄Π΅Π»Π΅Π½ΠΈΡ Ρ Π½Π΅ΠΏΡΠΈΡΡΠ½ΡΠΌ Π·Π°ΠΏΠ°Ρ ΠΎΠΌ Π³Π½ΠΈΠ΅Π½ΠΈΡ. Π’Π°ΠΊΠΈΠ΅ ΡΠΈΠΌΠΏΡΠΎΠΌΡ Π²ΠΎΠ·Π½ΠΈΠΊΠ°ΡΡ ΠΏΡΠΈ ΡΠ°Π·Π²ΠΈΡΠΈΠΈ Π³Π½ΠΎΠΉΠ½ΠΎΠ³ΠΎ ΠΏΡΠΎΡΠ΅ΡΡΠ° Π² ΠΌΠ°ΡΠΊΠ΅ ΠΈ ΠΏΡΠΈΠ΄Π°ΡΠΊΠ°Ρ . ΠΡΠ° ΠΏΠ°ΡΠΎΠ»ΠΎΠ³ΠΈΡ ΡΡΠ΅Π±ΡΠ΅Ρ ΡΠΊΡΡΡΠ΅Π½Π½ΠΎΠ³ΠΎ Π²ΠΌΠ΅ΡΠ°ΡΠ΅Π»ΡΡΡΠ²Π°. Π‘ΠΎΡΠ΅ΡΠ°Π½ΠΈΠ΅ Π½Π΅ΠΏΡΠΈΡΡΠ½ΠΎΠ³ΠΎ Π·Π°ΠΏΠ°Ρ Π° ΠΈ ΠΆΠ΅Π»ΡΠΎΠ³ΠΎ Π³Π½ΠΎΠ΅ΠΏΠΎΠ΄ΠΎΠ±Π½ΠΎΠ³ΠΎ Π²ΡΠ΄Π΅Π»Π΅Π½ΠΈΡ ΠΈΠ· ΠΏΠΎΠ»ΠΎΠ²ΡΡ ΠΏΡΡΠ΅ΠΉ β ΠΏΠΎΠΊΠ°Π·Π°Π½ΠΈΠ΅ Π΄Π»Ρ ΡΡΠΎΡΠ½ΠΎΠ³ΠΎ ΠΎΠ±ΡΠ°ΡΠ΅Π½ΠΈΡ ΠΊ Π²ΡΠ°ΡΡ.
Β
ΠΡΡΠ³ΠΈΠ΅ Π½Π΅ΠΏΡΠΈΡΡΠ½ΡΠ΅ ΡΠΈΠΌΠΏΡΠΎΠΌΡ
ΠΠΎΠΏΠΎΠ»Π½ΠΈΡΠ΅Π»ΡΠ½ΠΎ Π»ΡΠ±ΠΎΠΉ ΠΈΠ· ΠΏΠ΅ΡΠ΅ΡΠΈΡΠ»Π΅Π½Π½ΡΡ ΠΏΡΠΈΠ·Π½Π°ΠΊΠΎΠ² ΠΎΡΠΊΠ»ΠΎΠ½Π΅Π½ΠΈΠΉ ΠΌΠΎΠΆΠ΅Ρ ΡΠΎΠΏΡΠΎΠ²ΠΎΠΆΠ΄Π°ΡΡΡΡ ΡΠ°ΠΊΠΈΠΌΠΈ ΡΠΈΠΌΠΏΡΠΎΠΌΠ°ΠΌΠΈ, ΠΊΠ°ΠΊ Π±ΠΎΠ»Ρ, Π»ΠΈΡ ΠΎΡΠ°Π΄ΠΊΠ°.
ΠΠΎΡΠ»Π΅ ΠΏΡΠΈΠΆΠΈΠ³Π°Π½ΠΈΡ ΡΡΠΎΠ·ΠΈΠΈ Π½Π΅ΠΊΠΎΡΠΎΡΠΎΠ΅ Π²ΡΠ΅ΠΌΡ Π½Π΅Π·Π½Π°ΡΠΈΡΠ΅Π»ΡΠ½Π°Ρ Π±ΠΎΠ»Ρ ΠΌΠΎΠΆΠ΅Ρ Π±ΡΡΡ Π½ΠΎΡΠΌΠΎΠΉ. Π£ΡΠΈΠ»Π΅Π½ΠΈΠ΅ Π±ΠΎΠ»Π΅Π²ΠΎΠ³ΠΎ ΡΠΈΠ½Π΄ΡΠΎΠΌΠ° Π½Π° ΡΠΎΠ½Π΅ ΠΎΠ±ΠΈΠ»ΡΠ½ΡΡ ΠΊΡΠΎΠ²ΡΠ½ΠΈΡΡΡΡ Π²ΡΠ΄Π΅Π»Π΅Π½ΠΈΠΉ ΡΡΠ΅Π±ΡΠ΅Ρ Π²ΡΠ°ΡΠ΅Π±Π½ΠΎΠ³ΠΎ Π²ΠΌΠ΅ΡΠ°ΡΠ΅Π»ΡΡΡΠ²Π°.
ΠΠΎΠ»Ρ ΠΌΠΎΠΆΠ΅Ρ Π±ΡΡΡ ΠΏΠΎΠΊΠ°Π·Π°ΡΠ΅Π»Π΅ΠΌ ΡΠ°Π·Π²ΠΈΠ²ΡΠ΅Π³ΠΎΡΡ Π²ΠΎΡΠΏΠ°Π»Π΅Π½ΠΈΡ. ΠΡΠ»ΠΈ ΠΈΠ½ΡΠ΅ΠΊΡΠΈΡ ΠΈΠ· ΡΠ΅ΡΠ²ΠΈΠΊΠ°Π»ΡΠ½ΠΎΠ³ΠΎ ΠΊΠ°Π½Π°Π»Π° ΠΏΡΠΎΠ½ΠΈΠΊΠ»Π° Π²ΡΡΠ΅, Π² ΡΠ΅Π»ΠΎ ΠΌΠ°ΡΠΊΠΈ ΠΈΠ»ΠΈ ΠΏΡΠΈΠ΄Π°ΡΠΊΠΈ, ΠΈΠ»ΠΈ ΠΏΡΠΎΠΈΠ·ΠΎΡΠ»ΠΎ ΠΎΠ±ΠΎΡΡΡΠ΅Π½ΠΈΠ΅ Ρ ΡΠΎΠ½ΠΈΡΠ΅ΡΠΊΠΎΠ³ΠΎ ΠΏΡΠΎΡΠ΅ΡΡΠ°, ΡΠΎ Π±ΠΎΠ»Ρ ΡΡΠ°Π½ΠΎΠ²ΠΈΡΡΡ ΡΡΠΏΠΎΠΉ, ΡΡΠ½ΡΡΠ΅ΠΉ, ΠΊΠΎΡΠΎΡΠ°Ρ ΠΌΠΎΠΆΠ΅Ρ ΠΈΠ½ΠΎΠ³Π΄Π° ΡΡΠΈΠ»ΠΈΠ²Π°ΡΡΡΡ. ΠΡΠΈ ΠΏΠΎΡΠ°ΠΆΠ΅Π½ΠΈΠΈ ΠΏΡΠΈΠ΄Π°ΡΠΊΠΎΠ² Π±ΠΎΠ»Ρ Π»ΠΎΠΊΠ°Π»ΠΈΠ·ΡΠ΅ΡΡΡ Π½Π° ΡΡΠΎΡΠΎΠ½Π΅ ΡΠ°Π·Π²ΠΈΡΠΈΡ Π²ΠΎΡΠΏΠ°Π»Π΅Π½ΠΈΡ.

ΠΠ½ΠΎΠ³Π΄Π° ΠΏΠΎΡΠ»Π΅ ΠΏΡΠΈΠΆΠΈΠ³Π°Π½ΠΈΡ ΡΡΠΎΠ·ΠΈΠΈ ΡΠ΅ΠΉΠΊΠΈ ΠΌΠ°ΡΠΊΠΈ Ρ ΠΆΠ΅Π½ΡΠΈΠ½Ρ ΠΌΠΎΠΆΠ΅Ρ Π²ΠΎΠ·Π½ΠΈΠΊΠ½ΡΡΡ ΡΠ΅ΡΡΠ΅Π·Π½ΡΠΉ Π΄ΠΈΡΠΊΠΎΠΌΡΠΎΡΡ Π² ΠΎΠ±Π»Π°ΡΡΠΈ Π½ΠΈΠΆΠ½Π΅ΠΉ ΡΠ°ΡΡΠΈ ΠΆΠΈΠ²ΠΎΡΠ°. ΠΡΠ»ΠΈ Π±ΠΎΠ»Ρ ΡΡΠΈΠ»ΠΈΠ²Π°Π΅ΡΡΡ β ΡΡΠΎ ΠΌΠΎΠΆΠ΅Ρ Π±ΡΡΡ ΠΏΡΠΈΠ·Π½Π°ΠΊΠΎΠΌ ΡΠ°Π·Π²ΠΈΠ²Π°ΡΡΠ΅Π³ΠΎΡΡ Π²ΠΎΡΠΏΠ°Π»Π΅Π½ΠΈΡ.
ΠΠ΅Π±Π»Π°Π³ΠΎΠΏΡΠΈΡΡΠ½ΡΠΌ ΠΏΡΠΈΠ·Π½Π°ΠΊΠΎΠΌ ΡΠ²Π»ΡΠ΅ΡΡΡ ΠΏΠΎΠ²ΡΡΠ΅Π½ΠΈΠ΅ ΡΠ΅ΠΌΠΏΠ΅ΡΠ°ΡΡΡΡ ΡΠ΅Π»Π°. ΠΠ½ΠΎ Π²ΡΠ΅Π³Π΄Π° Π³ΠΎΠ²ΠΎΡΠΈΡ ΠΎ Π²ΠΎΡΠΏΠ°Π»ΠΈΡΠ΅Π»ΡΠ½ΠΎΠΉ ΡΠ΅Π°ΠΊΡΠΈΠΈ, ΠΊΠΎΡΠΎΡΡΡ Π½ΡΠΆΠ½ΠΎ Π»Π΅ΡΠΈΡΡ Π°Π½ΡΠΈΠ±ΠΈΠΎΡΠΈΠΊΠ°ΠΌΠΈ.
Β
ΠΠ»Π³ΠΎΡΠΈΡΠΌ Π΄Π΅ΠΉΡΡΠ²ΠΈΠΉ ΠΏΡΠΈ ΠΎΠ±Π½Π°ΡΡΠΆΠ΅Π½ΠΈΠΈ ΠΏΠ°ΡΠΎΠ»ΠΎΠ³ΠΈΡΠ΅ΡΠΊΠΈΡ Π²ΡΠ΄Π΅Π»Π΅Π½ΠΈΠΉ
Π§ΡΠΎΠ±Ρ Π½Π΅ ΠΏΡΠΎΠΏΡΡΡΠΈΡΡ ΡΠ°Π·Π²ΠΈΡΠΈΠ΅ ΠΎΡΠ»ΠΎΠΆΠ½Π΅Π½ΠΈΠΉ, Π½ΡΠΆΠ½ΠΎ ΡΠ΅ΡΠΊΠΎ ΡΠ»Π΅Π΄ΠΎΠ²Π°ΡΡ Π²ΡΠ°ΡΠ΅Π±Π½ΡΠΌ ΡΠ΅ΠΊΠΎΠΌΠ΅Π½Π΄Π°ΡΠΈΡΠΌ ΠΏΠΎΡΠ»Π΅ ΠΏΡΠΈΠΆΠΈΠ³Π°Π½ΠΈΡ ΡΡΠΎΠ·ΠΈΠΈ. ΠΠΎ Π΅ΡΠ»ΠΈ ΠΌΠ΅Π½ΡΠ΅ΡΡΡ Ρ Π°ΡΠ°ΠΊΡΠ΅Ρ Π²ΡΠ΄Π΅Π»Π΅Π½ΠΈΠΉ ΠΈΠ»ΠΈ ΠΎΠ½ΠΈ Π΄ΠΎΠ»Π³ΠΎ Π½Π΅ ΠΏΡΠΎΡ ΠΎΠ΄ΡΡ, Π½ΡΠΆΠ½ΠΎ ΠΏΡΠΈΠ΄Π΅ΡΠΆΠΈΠ²Π°ΡΡΡΡ ΠΈΠ½ΠΎΠ³ΠΎ Π°Π»Π³ΠΎΡΠΈΡΠΌΠ° Π΄Π΅ΠΉΡΡΠ²ΠΈΠΉ:
- ΠΠ±ΠΈΠ»ΡΠ½ΠΎΠ΅ ΠΊΡΠΎΠ²ΠΎΡΠ΅ΡΠ΅Π½ΠΈΠ΅ Π² ΠΏΠ΅ΡΠ²ΡΠ΅ Π½Π΅ΡΠΊΠΎΠ»ΡΠΊΠΎ ΡΡΡΠΎΠΊ β ΡΠΊΡΡΡΠ΅Π½Π½ΠΎΠ΅ ΠΎΠ±ΡΠ°ΡΠ΅Π½ΠΈΠ΅ Π·Π° ΠΌΠ΅Π΄ΠΈΡΠΈΠ½ΡΠΊΠΎΠΉ ΠΏΠΎΠΌΠΎΡΡΡ;
- Π‘ΡΠΊΡΠΎΠ²ΠΈΡΠ° ΠΏΠΎΡΠ»Π΅ ΠΏΡΠΈΠΆΠΈΠ³Π°Π½ΠΈΡ ΠΏΡΠΈΠΎΠ±ΡΠ΅ΡΠ°Π΅Ρ Π½Π΅ΠΏΡΠΈΡΡΠ½ΡΠΉ Π·Π°ΠΏΠ°Ρ , Π½Π΅ ΡΡΠ°Π½ΠΎΠ²ΠΈΡΡΡ Π³ΡΡΡΠΎΠΉ, Π° Π½Π°ΠΎΠ±ΠΎΡΠΎΡ, ΠΎΡΡΠ°Π΅ΡΡΡ ΠΆΠΈΠ΄ΠΊΠΎΠΉ ΠΈΠ»ΠΈ ΠΏΠ΅Π½ΠΈΡΡΡ β ΠΎΠ±ΡΠ°ΡΠΈΡΡΡΡ ΠΊ Π²ΡΠ°ΡΡ ΠΆΠ΅Π½ΡΠΊΠΎΠΉ ΠΊΠΎΠ½ΡΡΠ»ΡΡΠ°ΡΠΈΠΈ;
- ΠΠΎΡΠ²Π»Π΅Π½ΠΈΠ΅ Π»ΠΈΡ ΠΎΡΠ°Π΄ΠΊΠΈ, Π±ΠΎΠ»Π΅ΠΉ Π² ΠΎΠ±Π»Π°ΡΡΠΈ ΠΌΠ°Π»ΠΎΠ³ΠΎ ΡΠ°Π·Π° β ΡΠ°ΠΌΠΎΡΡΠΎΡΡΠ΅Π»ΡΠ½ΠΎ ΠΌΠΎΠΆΠ½ΠΎ ΠΏΡΠΈΠ½ΡΡΡ Π½Π΅ΡΡΠ΅ΡΠΎΠΈΠ΄Π½ΠΎΠ΅ ΠΏΡΠΎΡΠΈΠ²ΠΎΠ²ΠΎΡΠΏΠ°Π»ΠΈΡΠ΅Π»ΡΠ½ΠΎΠ΅ ΡΡΠ΅Π΄ΡΡΠ²ΠΎ ΠΏΡΠΈ ΡΠ΅ΠΌΠΏΠ΅ΡΠ°ΡΡΡΠ΅ Π²ΡΡΠ΅ 38,5 Π³ΡΠ°Π΄ΡΡΠΎΠ² ΠΈ ΠΎΡΠΏΡΠ°Π²ΠΈΡΡΡΡ Π½Π° ΠΏΡΠΈΠ΅ΠΌ ΠΊ ΡΠ²ΠΎΠ΅ΠΌΡ Π²ΡΠ°ΡΡ;
- ΠΠΎΠ½ΡΠ°ΠΊΡΠ½ΡΠ΅ ΠΊΡΠΎΠ²ΠΎΡΠ΅ΡΠ΅Π½ΠΈΡ Π²ΠΎ Π²ΡΠ΅ΠΌΡ ΠΏΠΎΠ»ΠΎΠ²ΠΎΠ³ΠΎ Π°ΠΊΡΠ° ΡΠ΅ΡΠ΅Π· ΠΌΠ΅ΡΡΡ ΠΈ Π±ΠΎΠ»Π΅Π΅ ΠΏΠΎΡΠ»Π΅ ΠΏΡΠΈΠΆΠΈΠ³Π°Π½ΠΈΡ ΡΡΠΎΠ·ΠΈΠΈ β Π·Π°ΠΏΠΈΡΠ°ΡΡΡΡ Π½Π° Π±Π»ΠΈΠΆΠ°ΠΉΡΠΈΠΉ ΠΏΡΠΈΠ΅ΠΌ ΠΊ Π°ΠΊΡΡΠ΅ΡΡ-Π³ΠΈΠ½Π΅ΠΊΠΎΠ»ΠΎΠ³Ρ Π΄Π»Ρ ΠΎΡΠΌΠΎΡΡΠ°.
ΠΠ°ΠΆΠ½ΠΎ
Π‘Π°ΠΌΠΎΡΡΠΎΡΡΠ΅Π»ΡΠ½ΠΎΠ΅ Π»Π΅ΡΠ΅Π½ΠΈΠ΅ ΠΏΡΠΈ ΠΏΠΎΡΠ²Π»Π΅Π½ΠΈΠΈ ΡΠΈΠΌΠΏΡΠΎΠΌΠΎΠ² ΠΎΡΠ»ΠΎΠΆΠ½Π΅Π½ΠΈΠΉ ΠΏΠΎΡΠ»Π΅ ΠΏΡΠΈΠΆΠΈΠ³Π°Π½ΠΈΡ ΡΡΠΎΠ·ΠΈΠΈ Π½Π΅Π΄ΠΎΠΏΡΡΡΠΈΠΌΠΎ. ΠΠ΅Π· Π²Π°Π³ΠΈΠ½Π°Π»ΡΠ½ΠΎΠ³ΠΎ ΠΎΡΠΌΠΎΡΡΠ°, Π½Π΅ΠΊΠΎΡΠΎΡΡΡ Π°Π½Π°Π»ΠΈΠ·ΠΎΠ², ΠΌΠ°Π·ΠΊΠ° ΠΈ Π£ΠΠ ΡΠΎΡΠ½ΠΎ ΠΎΠΏΡΠ΅Π΄Π΅Π»ΠΈΡΡ ΠΏΡΠΈΡΠΈΠ½Ρ ΠΏΠ°ΡΠΎΠ»ΠΎΠ³ΠΈΡΠ΅ΡΠΊΠΈΡ ΠΏΡΠΎΡΠ΅ΡΡΠΎΠ² Π½Π΅Π²ΠΎΠ·ΠΌΠΎΠΆΠ½ΠΎ.
ΠΡΠ»ΠΈΡΠΈΡΡ ΠΌΠ΅ΡΡΡΠ½ΡΠ΅ ΠΎΡ ΠΊΡΠΎΠ²ΠΎΡΠ΅ΡΠ΅Π½ΠΈΡ ΠΏΠΎΡΠ»Π΅ ΡΡΠΎΠ·ΠΈΠΈ ΠΌΠΎΠΆΠ½ΠΎ ΠΏΠΎ Π²ΡΠ΅ΠΌΠ΅Π½ΠΈ Π½Π°ΡΠ°Π»Π° ΠΈ Ρ Π°ΡΠ°ΠΊΡΠ΅ΡΡ Π²ΡΠ΄Π΅Π»Π΅Π½ΠΈΠΉ. ΠΠ΅ΡΠ²Π°Ρ ΠΌΠ΅Π½ΡΡΡΡΠ°ΡΠΈΡ Ρ Π±ΠΎΠ»ΡΡΠΈΠ½ΡΡΠ²Π° ΠΆΠ΅Π½ΡΠΈΠ½ Π½Π°ΡΠΈΠ½Π°Π΅ΡΡΡ ΡΠ΅ΡΠ΅Π· 3-4 Π½Π΅Π΄Π΅Π»ΠΈ ΠΏΠΎΡΠ»Π΅ ΠΏΡΠΈΠΆΠΈΠ³Π°Π½ΠΈΡ. Π ΡΡΠΎΠΌΡ ΠΌΠΎΠΌΠ΅Π½ΡΡ Π²ΡΠ΄Π΅Π»Π΅Π½ΠΈΡ, ΠΊΠΎΡΠΎΡΡΠ΅ Π±ΡΠ»ΠΈ ΠΏΠΎΡΠ»Π΅ Π»Π΅ΡΠ΅Π½ΠΈΡ ΡΡΠΎΠ·ΠΈΠΈ, Π·Π°ΠΊΠ°Π½ΡΠΈΠ²Π°ΡΡΡΡ. Π‘Π°ΠΌΠ° ΠΌΠ΅Π½ΡΡΡΡΠ°ΡΠΈΡ ΠΏΠΎ ΡΠ²Π΅ΡΡ ΠΎΡΠ»ΠΈΡΠ°Π΅ΡΡΡ ΠΎΡ Π΄ΡΡΠ³ΠΈΡ Π²ΡΠ΄Π΅Π»Π΅Π½ΠΈΠΉ. ΠΡΠΎΠ²Ρ Π²ΠΎ Π²ΡΠ΅ΠΌΡ ΠΌΠ΅ΡΡΡΠ½ΡΡ ΡΠ΅ΠΌΠ½Π°Ρ, ΠΈΠ½ΠΎΠ³Π΄Π° ΠΌΠΎΠ³ΡΡ Π±ΡΡΡ Π² Π½Π΅ΠΉ ΡΡΠΆΠΈ ΡΠ½Π΄ΠΎΠΌΠ΅ΡΡΠΈΡ (ΡΠ³ΡΡΡΠΊΠΈ). ΠΡΠ»ΠΈΡΠ°Π΅ΡΡΡ Ρ Π°ΡΠ°ΠΊΡΠ΅Ρ ΠΊΡΠΎΠ²ΠΎΡΠ΅ΡΠ΅Π½ΠΈΡ β Π² ΠΏΠ΅ΡΠ²ΡΠΉ Π΄Π΅Π½Ρ ΠΎΠ½ΠΎ Π½Π΅Π±ΠΎΠ»ΡΡΠΎΠ΅, Π²ΠΎ Π²ΡΠΎΡΠΎΠΉ ΠΈ ΡΡΠ΅ΡΠΈΠΉ Π±ΠΎΠ»Π΅Π΅ ΠΎΠ±ΠΈΠ»ΡΠ½ΠΎΠ΅, Π² ΠΏΠΎΡΠ»Π΅Π΄Π½ΠΈΠ΅ 1-2 Π΄Π½Ρ ΡΠΌΠ΅Π½ΡΡΠ°Π΅ΡΡΡ Π΄ΠΎ ΠΊΡΠΎΠ²ΠΎΠΌΠ°Π·Π°Π½ΡΡ.

ΠΠ°ΡΠΎΠ»ΠΎΠ³ΠΈΡΠ΅ΡΠΊΠΈΠ΅ Π²ΡΠ΄Π΅Π»Π΅Π½ΠΈΡ ΡΠ²ΠΈΠ΄Π΅ΡΠ΅Π»ΡΡΡΠ²ΡΡΡ ΠΎ ΡΠ°Π·Π²ΠΈΡΠΈΠΈ ΠΎΡΠ»ΠΎΠΆΠ½Π΅Π½ΠΈΠΉ ΠΈ ΡΡΠ΅Π±ΡΡΡ Π½Π΅Π·Π°ΠΌΠ΅Π΄Π»ΠΈΡΠ΅Π»ΡΠ½ΠΎΠ³ΠΎ ΠΎΠ±ΡΠ°ΡΠ΅Π½ΠΈΡ Π·Π° ΠΏΠΎΠΌΠΎΡΡΡ ΠΊ Π²ΡΠ°ΡΡ.
Β
ΠΠ°ΠΊ ΡΠ²Π΅ΡΡΠΈ ΠΊ ΠΌΠΈΠ½ΠΈΠΌΡΠΌΡ ΡΠΈΡΠΊΠΈ ΠΏΠΎΡΠ²Π»Π΅Π½ΠΈΡ ΠΎΡΠ»ΠΎΠΆΠ½Π΅Π½ΠΈΠΉ ΠΏΠΎΡΠ»Π΅ ΠΏΡΠΈΠΆΠΈΠ³Π°Π½ΠΈΡ ΡΡΠΎΠ·ΠΈΠΈ
ΠΡΠ°Π²ΠΈΠ»ΡΠ½Π°Ρ ΠΏΠΎΠ΄Π³ΠΎΡΠΎΠ²ΠΊΠ° ΠΊ Π»Π΅ΡΠ΅Π½ΠΈΡ ΡΡΠΎΠ·ΠΈΠΈ ΠΈ ΡΠΎΠ±Π»ΡΠ΄Π΅Π½ΠΈΠ΅ Π²ΡΠ°ΡΠ΅Π±Π½ΡΡ ΡΠ΅ΠΊΠΎΠΌΠ΅Π½Π΄Π°ΡΠΈΠΉ ΠΏΠΎΡΠ»Π΅ ΠΏΡΠΈΠΆΠΈΠ³Π°Π½ΠΈΡ ΠΏΠΎΠΌΠΎΠ³ΡΡ ΠΈΠ·Π±Π΅ΠΆΠ°ΡΡ Π½Π΅ΠΏΡΠΈΡΡΠ½ΡΡ ΠΎΡΠ»ΠΎΠΆΠ½Π΅Π½ΠΈΠΉ.
ΠΠΎ Π»Π΅ΡΠ΅Π½ΠΈΡ ΠΆΠ΅Π½ΡΠΈΠ½Π΅ ΠΎΠ±ΡΠ·Π°ΡΠ΅Π»ΡΠ½ΠΎ Π±Π΅ΡΡΡ ΠΌΠ°Π·ΠΎΠΊ ΠΈΠ· Π²Π»Π°Π³Π°Π»ΠΈΡΠ°. ΠΠ½ ΠΏΠΎΠΊΠ°Π·ΡΠ²Π°Π΅Ρ ΠΎΠ΄Π½Ρ ΠΈΠ· ΡΠ΅ΡΡΡΠ΅Ρ ΡΡΠ΅ΠΏΠ΅Π½Π΅ΠΉ ΡΠΈΡΡΠΎΡΡ, Π³Π΄Π΅ 1 β ΡΡΠΎ Π°Π±ΡΠΎΠ»ΡΡΠ½ΠΎ Π·Π΄ΠΎΡΠΎΠ²ΠΎΠ΅ ΡΠΎΡΡΠΎΡΠ½ΠΈΠ΅, Π° 4 ΡΡΠ΅ΠΏΠ΅Π½Ρ β Π²ΡΡΠ°ΠΆΠ΅Π½Π½ΠΎΠ΅ Π²ΠΎΡΠΏΠ°Π»Π΅Π½ΠΈΠ΅. ΠΡΠ»ΠΈ Ρ ΠΆΠ΅Π½ΡΠΈΠ½Ρ ΠΏΠΎ ΡΠ΅Π·ΡΠ»ΡΡΠ°ΡΠ°ΠΌ ΠΌΠ°Π·ΠΊΠ° ΠΎΠ±Π½Π°ΡΡΠΆΠΈΠ²Π°Π΅ΡΡΡ 3-4 ΡΡΠ΅ΠΏΠ΅Π½Ρ ΡΠΈΡΡΠΎΡΡ, ΡΠΎ Π΄ΠΎ ΠΏΡΠΈΠΆΠΈΠ³Π°Π½ΠΈΡ Π½ΡΠΆΠ½ΠΎ ΠΏΡΠΎΠΉΡΠΈ Π»Π΅ΡΠ΅Π½ΠΈΠ΅ Π²Π°Π³ΠΈΠ½ΠΈΡΠ°. ΠΠ»Ρ ΡΡΠΎΠ³ΠΎ ΠΏΡΠΈΠΌΠ΅Π½ΡΡΡ ΠΌΠ΅ΡΡΠ½ΡΠ΅ ΠΏΡΠ΅ΠΏΠ°ΡΠ°ΡΡ Π² ΡΠΎΡΠΌΠ΅ ΡΠ²Π΅ΡΠ΅ΠΉ ΠΈ Π²Π°Π³ΠΈΠ½Π°Π»ΡΠ½ΡΡ ΡΠ°Π±Π»Π΅ΡΠΎΠΊ, Π½Π°ΠΏΡΠΈΠΌΠ΅Ρ, ΠΠΈΠ½Π΅Π·ΠΎΠ», Π’Π΅ΡΠΆΠΈΠ½Π°Π½. ΠΡΠΈ Π½Π΅Π·Π½Π°ΡΠΈΡΠ΅Π»ΡΠ½ΠΎΠΌ ΠΏΡΠΈΡΡΡΡΡΠ²ΠΈΠΈ ΠΊΠΎΠΊΠΊΠΎΠ²ΠΎΠΉ ΡΠ»ΠΎΡΡ Π²ΡΠ°Ρ ΠΏΡΠ΅Π΄Π»ΠΎΠΆΠΈΡ ΠΏΡΠΎΡΠ°Π½ΠΈΡΠΎΠ²Π°ΡΡ Π²Π»Π°Π³Π°Π»ΠΈΡΠ΅ (Π½Π°ΠΏΡΠΈΠΌΠ΅Ρ, ΡΠ²Π΅ΡΠ°ΠΌΠΈ ΠΠΎΠ²ΠΈΠ΄ΠΎΠ½-ΠΠΎΠ΄).
ΠΡΠ»ΠΈ Π² ΠΌΠ°Π·ΠΊΠ΅ ΠΎΠ±Π½Π°ΡΡΠΆΠ΅Π½ ΠΏΡΠ΅Π²Π΄ΠΎΠΌΠΈΡΠ΅Π»ΠΈΠΉ ΠΈΠ»ΠΈ ΡΠΏΠΎΡΡ ΠΊΠ°Π½Π΄ΠΈΠ΄, ΡΠΎ Π½Π΅ΠΎΠ±Ρ ΠΎΠ΄ΠΈΠΌΠΎ ΠΏΡΠΎΡΠΈΠ²ΠΎΠ³ΡΠΈΠ±ΠΊΠΎΠ²ΠΎΠ΅ Π»Π΅ΡΠ΅Π½ΠΈΠ΅. ΠΠΈΠ½Π΅ΠΊΠΎΠ»ΠΎΠ³ ΠΌΠΎΠΆΠ΅Ρ Π½Π°Π·Π½Π°ΡΠΈΡΡ ΡΠ²Π΅ΡΠΈ ΠΠ»ΠΎΡΡΠΈΠΌΠ°Π·ΠΎΠ», ΠΠΈΠΌΠ°ΡΡΡΠΈΠ½ ΠΈΠ»ΠΈ ΠΎΠ΄Π½ΠΎΠΊΡΠ°ΡΠ½ΠΎ Π²Π½ΡΡΡΡ ΠΏΡΠΈΠ½ΡΡΡ Π€Π»ΡΠΊΠΎΠ½Π°Π·ΠΎΠ».
ΠΠ±Π½Π°ΡΡΠΆΠ΅Π½Π½ΡΠ΅ Π² ΠΌΠ°Π·ΠΊΠ΅ Π³Π°ΡΠ΄Π½Π΅ΡΠ΅Π»Π»Ρ Π³ΠΎΠ²ΠΎΡΡΡ ΠΎΠ± ΠΈΠΌΠ΅ΡΡΠ΅ΠΌΡΡ Π΄ΠΈΡΠ±ΠΈΠΎΠ·Π΅ Π²Π»Π°Π³Π°Π»ΠΈΡΠ° ΠΈ Π²ΠΎΠ·ΠΌΠΎΠΆΠ½ΠΎΠΌ Π±Π°ΠΊΡΠ΅ΡΠΈΠ°Π»ΡΠ½ΠΎΠΌ Π²Π°Π³ΠΈΠ½ΠΎΠ·Π΅. Π ΡΠ°ΠΊΠΎΠΌ ΡΠ»ΡΡΠ°Π΅ Π»Π΅ΡΠ΅Π½ΠΈΠ΅ ΠΏΡΠΎΠ²ΠΎΠ΄ΡΡ, Π½Π°ΠΏΡΠΈΠΌΠ΅Ρ, Π²Π°Π³ΠΈΠ½Π°Π»ΡΠ½ΡΠΌΠΈ ΡΠ°Π±Π»Π΅ΡΠΊΠ°ΠΌΠΈ ΠΠ΅ΡΡΠΎΠ½ΠΈΠ΄Π°Π·ΠΎΠ»Π°.
ΠΡΠ»ΠΈ ΠΏΠΎ ΡΠ΅Π·ΡΠ»ΡΡΠ°ΡΠ°ΠΌ Π°Π½Π°Π»ΠΈΠ·ΠΎΠ² ΠΎΠ±Π½Π°ΡΡΠΆΠ΅Π½Ρ ΠΏΡΠ΅Π΄ΡΡΠ°Π²ΠΈΡΠ΅Π»ΠΈ ΠΈΠ½ΡΠ΅ΠΊΡΠΈΠΈ, ΠΏΠ΅ΡΠ΅Π΄Π°ΡΡΠ΅ΠΉΡΡ ΠΏΠΎΠ»ΠΎΠ²ΡΠΌ ΠΏΡΡΠ΅ΠΌ, ΡΠΎ Π½Π΅ΠΎΠ±Ρ ΠΎΠ΄ΠΈΠΌΠΎ ΠΏΡΠΎΠ²Π΅ΡΡΠΈ ΡΠΎΠΎΡΠ²Π΅ΡΡΡΠ²ΡΡΡΠ΅Π΅ Π»Π΅ΡΠ΅Π½ΠΈΠ΅. Π₯Π»Π°ΠΌΠΈΠ΄ΠΈΠΈ, ΡΡΠ΅Π°ΠΏΠ»Π°Π·ΠΌΡ, ΠΌΠΈΠΊΠΎΠΏΠ»Π°Π·ΠΌΡ, ΡΡΠΈΡ ΠΎΠΌΠΎΠ½Π°Π΄Ρ, Π²ΠΈΡΡΡ ΠΏΠ°ΠΏΠΈΠ»Π»ΠΎΠΌΡ ΡΠ΅Π»ΠΎΠ²Π΅ΠΊΠ° ΡΠ°ΡΡΠΎ ΡΠΎΡΠ΅ΡΠ°ΡΡΡΡ Ρ ΡΡΠΎΠ·ΠΈΠ΅ΠΉ ΡΠ΅ΠΉΠΊΠΈ ΠΌΠ°ΡΠΊΠΈ ΠΈ ΠΏΠΎΠ΄Π΄Π΅ΡΠΆΠΈΠ²Π°ΡΡ Π²ΠΎΡΠΏΠ°Π»ΠΈΡΠ΅Π»ΡΠ½ΡΡ ΡΠ΅Π°ΠΊΡΠΈΡ Π½Π° Π½Π΅ΠΉ.
Π§ΡΠΎΠ±Ρ ΠΈΠ·Π±Π΅ΠΆΠ°ΡΡ ΠΎΡΠ»ΠΎΠΆΠ½Π΅Π½ΠΈΠΉ ΠΏΠΎΡΠ»Π΅ ΠΏΡΠΈΠΆΠΈΠ³Π°Π½ΠΈΡ ΡΡΠΎΠ·ΠΈΠΈ ΡΠ΅ΠΉΠΊΠΈ ΠΌΠ°ΡΠΊΠΈ, Π½Π΅ΠΎΠ±Ρ ΠΎΠ΄ΠΈΠΌΠΎ ΡΡΠ°ΡΠ΅Π»ΡΠ½ΠΎΠ΅ ΠΏΡΠ΅Π΄Π²Π°ΡΠΈΡΠ΅Π»ΡΠ½ΠΎΠ΅ ΠΈΡΡΠ»Π΅Π΄ΠΎΠ²Π°Π½ΠΈΠ΅ Π²Π»Π°Π³Π°Π»ΠΈΡΠ½ΠΎΠΉ ΡΠ»ΠΎΡΡ Π΄Π»Ρ Π²ΡΡΠ²Π»Π΅Π½ΠΈΡ ΠΈ ΠΈΠ΄Π΅Π½ΡΠΈΡΠΈΠΊΠ°ΡΠΈΠΈ Π±Π°ΠΊΡΠ΅ΡΠΈΠΉ.
ΠΠΎΡΠ»Π΅ ΠΊΠΎΠ½ΡΡΠΎΠ»Ρ ΠΏΡΠΎΠ²Π΅Π΄Π΅Π½Π½ΠΎΠ³ΠΎ Π»Π΅ΡΠ΅Π½ΠΈΡ ΠΌΠΎΠΆΠ½ΠΎ ΠΏΠ΅ΡΠ΅Ρ ΠΎΠ΄ΠΈΡΡ Π½Π΅ΠΏΠΎΡΡΠ΅Π΄ΡΡΠ²Π΅Π½Π½ΠΎ ΠΊ ΠΏΡΠΈΠΆΠΈΠ³Π°Π½ΠΈΡ. Π‘ΠΊΠΎΡΠΎΡΡΡ Π·Π°ΠΆΠΈΠ²Π»Π΅Π½ΠΈΡ ΡΠ°Π½Ρ ΠΏΠΎΡΠ»Π΅ ΠΏΡΠΈΠΆΠΈΠ³Π°Π½ΠΈΡ Π·Π°Π²ΠΈΡΠΈΡ ΠΎΡ Π²ΡΠ±ΡΠ°Π½Π½ΠΎΠ³ΠΎ ΠΌΠ΅ΡΠΎΠ΄Π°. ΠΠ°ΠΈΠ±ΠΎΠ»Π΅Π΅ ΡΡΠ°Π²ΠΌΠ°ΡΠΈΡΠ½ΡΠΌ ΡΠ²Π»ΡΠ΅ΡΡΡ ΡΠ»Π΅ΠΊΡΡΠΎΠΊΠΎΠ°Π³ΡΠ»ΡΡΠΈΡ. ΠΡΠΈΠΆΠΈΠ³Π°Π½ΠΈΠ΅ Π»Π°Π·Π΅ΡΠΎΠΌ ΠΈ ΡΠ°Π΄ΠΈΠΎΠ²ΠΎΠ»Π½Π°ΠΌΠΈ β ΡΠΎΠ²ΡΠ΅ΠΌΠ΅Π½Π½ΡΠ΅ ΠΌΠ΅ΡΠΎΠ΄Ρ, ΠΊΠΎΡΠΎΡΡΠ΅ Π² ΠΌΠ΅Π½ΡΡΠ΅ΠΉ ΡΡΠ΅ΠΏΠ΅Π½ΠΈ ΠΏΠΎΠ²ΡΠ΅ΠΆΠ΄Π°ΡΡ ΡΠ΅ΠΉΠΊΡ ΠΈ ΡΠ΅Π΄ΠΊΠΎ ΠΏΡΠΈΠ²ΠΎΠ΄ΡΡ ΠΊ ΡΠ°Π·Π²ΠΈΡΠΈΡ ΠΎΡΠ»ΠΎΠΆΠ½Π΅Π½ΠΈΠΉ. ΠΡΠΈ Π²ΡΠ±ΠΎΡΠ΅ ΡΡ Π΅ΠΌΡ Π»Π΅ΡΠ΅Π½ΠΈΡ ΠΌΠΎΠΆΠ½ΠΎ ΠΎΡΠΈΠ΅Π½ΡΠΈΡΠΎΠ²Π°ΡΡΡΡ Π½Π° ΠΎΡΠ·ΡΠ²Ρ Π΄ΡΡΠ³ΠΈΡ ΠΆΠ΅Π½ΡΠΈΠ½, Π½ΠΎ ΠΎΠ±ΡΠ·Π°ΡΠ΅Π»ΡΠ½ΠΎ ΡΡΠΎΠΈΡ ΠΏΡΠΈΡΠ»ΡΡΠ°ΡΡΡΡ ΠΊ ΠΌΠ½Π΅Π½ΠΈΡ ΡΠ²ΠΎΠ΅Π³ΠΎ Π²ΡΠ°ΡΠ°.
ΠΠΎΡΠ»Π΅ ΠΏΡΠΈΠΆΠΈΠ³Π°Π½ΠΈΡ Π½Π° ΠΏΡΠΎΡΡΠΆΠ΅Π½ΠΈΠΈ Π½Π΅ΡΠΊΠΎΠ»ΡΠΊΠΈΡ Π΄Π½Π΅ΠΉ Π½ΡΠΆΠ½ΠΎ Π½Π°Π±Π»ΡΠ΄Π°ΡΡ Π·Π° Ρ Π°ΡΠ°ΠΊΡΠ΅ΡΠΎΠΌ Π²ΡΠ΄Π΅Π»Π΅Π½ΠΈΠΉ. ΠΠ΅ΠΏΠΎΡΡΠ΅Π΄ΡΡΠ²Π΅Π½Π½ΠΎ Π² ΠΏΠ΅ΡΠΈΠΎΠ΄ Π·Π°ΠΆΠΈΠ²Π»Π΅Π½ΠΈΡ Π½Π΅Π»ΡΠ·Ρ:
- ΠΠ°Π½ΠΈΠΌΠ°ΡΡΡΡ ΡΠ΅ΠΊΡΠΎΠΌ;
- ΠΡΠΈΠ½ΠΈΠΌΠ°ΡΡ Π³ΠΎΡΡΡΡΡ Π²Π°Π½Π½Ρ, ΠΏΠ°ΡΠΈΡΡΡΡ Π² Π±Π°Π½Π΅ ΠΈ ΡΠ°ΡΠ½Π΅;
- ΠΠΎΡΠ΅ΡΠ°ΡΡ ΠΏΡΠΈΡΠΎΠ΄Π½ΡΠ΅ Π²ΠΎΠ΄ΠΎΠ΅ΠΌΡ, ΠΎΠ±ΡΠ΅ΡΡΠ²Π΅Π½Π½ΡΠΉ Π±Π°ΡΡΠ΅ΠΉΠ½;
- ΠΠ°Π³ΠΎΡΠ°ΡΡ;
- ΠΠΎΠ΄Π½ΠΈΠΌΠ°ΡΡ ΡΡΠΆΠ΅ΡΡΠΈ;
- ΠΠ°Π½ΠΈΠΌΠ°ΡΡΡΡ ΡΠΏΠΎΡΡΠΎΠΌ ΠΈΠ»ΠΈ ΡΠΈΠ·ΠΈΡΠ΅ΡΠΊΠΈ ΡΡΠΆΠ΅Π»ΡΠΌ ΡΡΡΠ΄ΠΎΠΌ;
- ΠΠΎΠ»ΡΠ·ΠΎΠ²Π°ΡΡΡΡ ΡΠ°ΠΌΠΏΠΎΠ½Π°ΠΌΠΈ.
ΠΠ»Ρ ΡΡΠΊΠΎΡΠ΅Π½ΠΈΡ ΡΠ΅Π³Π΅Π½Π΅ΡΠ°ΡΠΈΠΈ Π²ΡΠ°Ρ ΠΌΠΎΠΆΠ΅Ρ Π½Π°Π·Π½Π°ΡΠΈΡΡ ΡΠΏΠ΅ΡΠΈΠ°Π»ΡΠ½ΡΠ΅ ΠΏΡΠ΅ΠΏΠ°ΡΠ°ΡΡ. ΠΡΠΎ ΡΠ²Π΅ΡΠΈ ΠΠ΅ΡΠ°Π΄ΠΈΠ½, ΠΠ΅ΠΏΠ°Π½ΡΠΎΠ», ΠΠ΅Π½ΡΠ΅ΡΠΎΠ½, ΡΡΠΏΠΏΠΎΠ·ΠΈΡΠΎΡΠΈΠΈ Ρ ΠΎΠ±Π»Π΅ΠΏΠΈΡ ΠΎΠ²ΡΠΌ ΠΌΠ°ΡΠ»ΠΎΠΌ. Π’Π΅ΠΌ, Ρ ΠΊΠΎΠ³ΠΎ ΡΡΠΎΠ·ΠΈΡ Π±ΡΠ»Π° Π½Π° ΡΠΎΠ½Π΅ Π²ΠΈΡΡΡΠ½ΠΎΠΉ ΠΈΠ½ΡΠ΅ΠΊΡΠΈΠΈ, ΠΌΠΎΠ³ΡΡ Π½Π°Π·Π½Π°ΡΠΈΡΡ ΠΠΎΠ»ΡΠΏΠΎΡΠΈΠ΄ β ΡΡΠΈ ΡΠ²Π΅ΡΠΈ ΠΎΠ±Π»Π°Π΄Π°ΡΡ ΠΏΡΠΎΡΠΈΠ²ΠΎΠ²ΠΈΡΡΡΠ½ΠΎΠΉ Π°ΠΊΡΠΈΠ²Π½ΠΎΡΡΡΡ. ΠΠ½ΡΠΈΠ±Π°ΠΊΡΠ΅ΡΠΈΠ°Π»ΡΠ½ΡΠΉ ΡΡΡΠ΅ΠΊΡ ΠΎΠΊΠ°Π·ΡΠ²Π°ΡΡ Π»Π΅Π²ΠΎΠΌΠ΅ΠΊΠΎΠ»Π΅Π²Π°Ρ ΠΌΠ°Π·Ρ, Π²Π°Π³ΠΈΠ½Π°Π»ΡΠ½ΡΠ΅ ΡΠ°Π±Π»Π΅ΡΠΊΠΈ Π’Π΅ΡΠΆΠΈΠ½Π°Π½.
ΠΡΠΏΠΎΠ»ΡΠ·ΠΎΠ²Π°Π½ΠΈΠ΅ Π½Π°ΡΠΎΠ΄Π½ΡΡ ΠΌΠ΅ΡΠΎΠ΄ΠΎΠ² ΡΡΠΊΠΎΡΠ΅Π½ΠΈΡ Π·Π°ΠΆΠΈΠ²Π»Π΅Π½ΠΈΡ Π²ΠΎΠ·ΠΌΠΎΠΆΠ½ΠΎ ΡΠΎΠ»ΡΠΊΠΎ ΠΏΠΎΡΠ»Π΅ ΠΊΠΎΠ½ΡΡΠ»ΡΡΠ°ΡΠΈΠΈ ΡΠΎ ΡΠ²ΠΎΠΈΠΌ Π²ΡΠ°ΡΠΎΠΌ. Π‘ΠΏΡΠΈΠ½ΡΠ΅Π²Π°Π½ΠΈΡ, Π·Π°ΠΊΠ»Π°Π΄ΡΠ²Π°Π½ΠΈΠ΅ ΡΠ°ΠΌΠΏΠΎΠ½ΠΎΠ² Π² ΡΡΠΎΡ ΠΏΠ΅ΡΠΈΠΎΠ΄ ΠΊΠ°ΡΠ΅Π³ΠΎΡΠΈΡΠ΅ΡΠΊΠΈ ΠΏΡΠΎΡΠΈΠ²ΠΎΠΏΠΎΠΊΠ°Π·Π°Π½ΠΎ. Π ΠΏΠ΅ΡΠ²ΠΎΠΌ ΡΠ»ΡΡΠ°Π΅ Π±ΡΠ΄Π΅Ρ Π²ΡΠΌΡΠ²Π°ΡΡΡΡ Π½ΠΎΡΠΌΠ°Π»ΡΠ½Π°Ρ ΠΌΠΈΠΊΡΠΎΡΠ»ΠΎΡΠ° Π²Π»Π°Π³Π°Π»ΠΈΡΠ° ΠΈ ΡΡΡΠ΅ΡΡΠ²ΡΠ΅Ρ ΠΎΠΏΠ°ΡΠ½ΠΎΡΡΡ Π²ΠΎΡΡ ΠΎΠ΄ΡΡΠ΅Π³ΠΎ ΠΈΠ½ΡΠΈΡΠΈΡΠΎΠ²Π°Π½ΠΈΡ, Π° ΡΠ°ΠΊΠΆΠ΅ ΠΏΠΎΠ²ΡΠ΅ΠΆΠ΄Π΅Π½ΠΈΡ ΡΡΡΡΠΏΠ° Π½Π° ΡΠ΅ΠΉΠΊΠ΅. ΠΡΠΈ Π²Π²Π΅Π΄Π΅Π½ΠΈΠΈ ΡΠ°ΠΌΠΏΠΎΠ½ΠΎΠ² ΡΠ°ΠΊΠΆΠ΅ ΠΌΠΎΠΆΠ½ΠΎ ΠΏΠΎΠ²ΡΠ΅Π΄ΠΈΡΡ ΠΎΠ±ΡΠ°Π·ΠΎΠ²Π°Π²ΡΡΡΡΡ ΠΊΠΎΡΠΊΡ, Π²ΡΠ·Π²Π°ΡΡ ΠΊΡΠΎΠ²ΠΎΡΠ΅ΡΠ΅Π½ΠΈΠ΅ ΠΈΠ»ΠΈ Π·Π°Π½Π΅ΡΡΠΈ ΠΈΠ½ΡΠ΅ΠΊΡΠΈΡ.
Π£ΡΠΏΠ΅Ρ Π² Π»Π΅ΡΠ΅Π½ΠΈΠΈ Π»ΡΠ±ΠΎΠ³ΠΎ Π·Π°Π±ΠΎΠ»Π΅Π²Π°Π½ΠΈΡ Π·Π°Π²ΠΈΡΠΈΡ ΠΎΡ ΡΠΎΠ³Π»Π°ΡΠΎΠ²Π°Π½Π½ΠΎΡΡΠΈ Π΄Π΅ΠΉΡΡΠ²ΠΈΠΉ Π²ΡΠ°ΡΠ° ΠΈ ΠΏΠ°ΡΠΈΠ΅Π½ΡΠ°. ΠΡΠ»ΠΈ ΠΆΠ΅Π½ΡΠΈΠ½Π° ΠΏΡΠΈΡΠ»ΡΡΠΈΠ²Π°Π΅ΡΡΡ ΠΊ ΡΠ΅ΠΊΠΎΠΌΠ΅Π½Π΄Π°ΡΠΈΡΠΌ, ΠΏΡΠ°Π²ΠΈΠ»ΡΠ½ΠΎ ΠΈΡ Π²ΡΠΏΠΎΠ»Π½ΡΠ΅Ρ, Π° Π΄ΠΎΠΊΡΠΎΡ ΡΡΠΈΡΡΠ²Π°Π΅Ρ ΠΈΠ½Π΄ΠΈΠ²ΠΈΠ΄ΡΠ°Π»ΡΠ½ΡΠ΅ ΠΎΡΠΎΠ±Π΅Π½Π½ΠΎΡΡΠΈ ΠΏΠ°ΡΠΈΠ΅Π½ΡΠΊΠΈ, ΡΠΎ ΡΠ΅Π·ΡΠ»ΡΡΠ°Ρ ΡΠ΅ΡΠ°ΠΏΠΈΠΈ Π±ΡΠ΄Π΅Ρ ΠΏΠΎΠ»ΠΎΠΆΠΈΡΠ΅Π»ΡΠ½ΡΠΌ.
Β
ΠΠΎΠ»Π΅Π·Π½ΠΎΠ΅ Π²ΠΈΠ΄Π΅ΠΎ ΠΎ ΠΏΡΠΎΡΠΈΠ»Π°ΠΊΡΠΈΠΊΠ΅ ΠΎΡΠ»ΠΎΠΆΠ½Π΅Π½ΠΈΠΉ ΠΏΠΎΡΠ»Π΅ ΠΏΡΠΈΠΆΠΈΠ³Π°Π½ΠΈΡ ΡΡΠΎΠ·ΠΈΠΈ ΡΠ΅ΠΉΠΊΠΈ ΠΌΠ°ΡΠΊΠΈ
mioma911.ru
ΠΠ΅ΡΠ΅Π½ΠΈΠ΅ ΠΏΠΎΡΠ»Π΅ ΠΏΡΠΈΠΆΠΈΠ³Π°Π½ΠΈΡ ΡΡΠΎΠ·ΠΈΠΈ ΡΠ΅ΠΉΠΊΠΈ ΠΌΠ°ΡΠΊΠΈ
ΠΡΠΎΠ·ΠΈΡ ΡΠ΅ΠΉΠΊΠΈ ΠΌΠ°ΡΠΊΠΈ ΠΏΡΠ΅Π΄ΡΡΠ°Π²Π»ΡΠ΅Ρ ΡΠΎΠ±ΠΎΠΉ ΠΈΠ·ΡΡΠ·Π²Π»Π΅Π½ΠΈΠ΅ Π½Π° ΡΠ΅ΠΉΠΊΠ΅, ΡΠ°ΡΠ΅ Π²ΠΎΠΊΡΡΠ³ Π½Π°ΡΡΠΆΠ½ΠΎΠ³ΠΎ Π·Π΅Π²Π°, ΠΈΠΌΠ΅ΡΡΠ΅Π΅ ΡΡΠΊΠΎ-ΠΊΡΠ°ΡΠ½ΡΠΉ ΡΠ²Π΅Ρ. ΠΡΠΈ ΡΠΎΠΏΡΠΈΠΊΠΎΡΠ½ΠΎΠ²Π΅Π½ΠΈΠΈ Ρ ΠΏΠΎΠ²ΡΠ΅ΠΆΠ΄Π΅Π½Π½ΠΎΠΉ ΠΏΠΎΠ²Π΅ΡΡ Π½ΠΎΡΡΡΡ, Π²ΡΠ΄Π΅Π»ΡΠ΅ΡΡΡ ΠΊΡΠΎΠ²Ρ.
Π§ΡΠΎ Π² Π½ΠΎΡΠΌΠ΅? Π£ Π·Π΄ΠΎΡΠΎΠ²ΠΎΠΉ ΠΆΠ΅Π½ΡΠΈΠ½Ρ Π²ΡΠ°Ρ Π²ΠΈΠ΄ΠΈΡ Π²ΠΎ Π²ΡΠ΅ΠΌΡ ΠΎΡΠΌΠΎΡΡΠ° ΡΠΎΠ·ΠΎΠ²ΡΡ, Π³Π»Π°Π΄ΠΊΡΡ, Π±Π»Π΅ΡΡΡΡΡΡ ΠΏΠΎΠ²Π΅ΡΡ Π½ΠΎΡΡΡ ΡΠ΅ΠΉΠΊΠΈ ΠΌΠ°ΡΠΊΠΈ. ΠΠ»Π°Π³Π°Π»ΠΈΡΠ½Π°Ρ ΡΠ°ΡΡΡ ΡΠ΅ΠΉΠΊΠΈ ΠΌΠ°ΡΠΊΠΈ Π²ΡΡΠ»Π°Π½Π° ΠΌΠ½ΠΎΠ³ΠΎΡΠ»ΠΎΠΉΠ½ΡΠΌ ΠΏΠ»ΠΎΡΠΊΠΈΠΌ ΡΠΏΠΈΡΠ΅Π»ΠΈΠ΅ΠΌ. ΠΠΎΠ²Π΅ΡΡ Π½ΠΎΡΡΡ ΡΠ΅ΡΠ²ΠΈΠΊΠ°Π»ΡΠ½ΠΎΠ³ΠΎ ΠΊΠ°Π½Π°Π»Π°, Π²Π΅Π΄ΡΡΠ΅Π³ΠΎ Π² ΠΏΠΎΠ»ΠΎΡΡΡ ΠΌΠ°ΡΠΊΠΈ ΡΠΎΡΡΠΎΠΈΡ ΠΈΠ· ΠΊΠ»Π΅ΡΠΎΠΊ ΡΠΈΠ»ΠΈΠ½Π΄ΡΠΈΡΠ΅ΡΠΊΠΎΠ³ΠΎ ΡΠΏΠΈΡΠ΅Π»ΠΈΡ. ΠΠ°ΠΆΠ΄ΡΠΉ ΡΠΈΠΏ ΠΊΠ»Π΅ΡΠΎΠΊ Π²ΡΠΏΠΎΠ»Π½ΡΠ΅Ρ ΡΠ²ΠΎΠΈ ΡΡΠ½ΠΊΡΠΈΠΈ. Π ΠΏΠ΅ΡΠ²ΠΎΠΌ ΡΠ»ΡΡΠ°Π΅ β ΡΡΠΎ ΡΠΎΠ·Π΄Π°Π½ΠΈΠ΅ ΡΡΠ΅Π΄Ρ Π΄Π»Ρ ΠΏΠΎΠ΄Π΄Π΅ΡΠΆΠ°Π½ΠΈΡ Π±Π°Π»Π°Π½ΡΠ° ΠΊΠΈΡΠ»ΠΎΠΌΠΎΠ»ΠΎΡΠ½ΡΡ Π±Π°ΠΊΡΠ΅ΡΠΈΠΉ, ΠΎΡΠ²Π΅ΡΠ°ΡΡΠΈΡ Π·Π° ΠΎΠΏΡΠΈΠΌΠ°Π»ΡΠ½ΡΡ ΠΌΠΈΠΊΡΠΎΡΠ»ΠΎΡΡ Π²Π»Π°Π³Π°Π»ΠΈΡΠ°, Π²ΠΎ Π²ΡΠΎΡΠΎΠΌ β ΠΏΡΠΎΠ΄ΡΠΊΡΠΈΡ ΡΠ»ΠΈΠ·ΠΈ, Π·Π°ΠΏΠΎΠ»Π½ΡΡΡΠ΅ΠΉ ΡΠ΅Π΅ΡΠ½ΡΠΉ ΠΊΠ°Π½Π°Π» ΠΈ Π½Π΅ΠΎΠ±Ρ ΠΎΠ΄ΠΈΠΌΠΎΠΉ Π΄Π»Ρ ΠΏΡΠΎΠ΄Π²ΠΈΠΆΠ΅Π½ΠΈΡ ΡΠΏΠ΅ΡΠΌΠ°ΡΠΎΠ·ΠΎΠΈΠ΄ΠΎΠ² Π² ΠΏΠΎΠ»ΠΎΡΡΡ ΠΌΠ°ΡΠΊΠΈ. ΠΠΎΠ»ΡΡΠ°Π΅ΡΡΡ, ΡΡΠΎ Π·Π΄ΠΎΡΠΎΠ²ΡΠ΅ ΡΠΊΠ°Π½ΠΈ ΡΠ΅ΠΉΠΊΠΈ ΠΌΠ°ΡΠΊΠΈ ΡΠ²Π»ΡΡΡΡΡ ΡΠ²ΠΎΠ΅ΠΎΠ±ΡΠ°Π·Π½ΡΠΌ Π±Π°ΡΡΠ΅ΡΠΎΠΌ Π½Π° ΠΏΡΡΠΈ ΠΈΠ½ΡΠ΅ΠΊΡΠΈΠΎΠ½Π½ΡΡ Π°Π³Π΅Π½ΡΠΎΠ². ΠΠ° ΡΡΠ΅Ρ ΠΏΠΎΠ΄Π΄Π΅ΡΠΆΠ°Π½ΠΈΡ ΠΊΠΈΡΠ»ΠΎΠΉ ΡΡΠ΅Π΄Ρ, ΠΎΠ±Π΅ΡΠΏΠ΅ΡΠΈΠ²Π°ΡΡ Π·Π°ΡΠΈΡΡ ΠΌΠ°ΡΠΊΠΈ ΠΈ ΠΏΡΠΈΠ΄Π°ΡΠΊΠΎΠ² ΠΎΡ ΠΏΠ°ΡΠΎΠ³Π΅Π½ΠΎΠ², ΠΎΠ΄Π½ΠΎΠ²ΡΠ΅ΠΌΠ΅Π½Π½ΠΎ ΡΠΏΠΎΡΠΎΠ±ΡΡΠ²ΡΡ ΠΏΡΠΎΡΠ΅ΡΡΠ°ΠΌ ΠΎΠΏΠ»ΠΎΠ΄ΠΎΡΠ²ΠΎΡΠ΅Π½ΠΈΡ.
ΠΠΎΡΠ΅ΠΌΡ ΡΠΎΡΠΌΠΈΡΡΠ΅ΡΡΡ ΡΡΠΎΠ·ΠΈΡ ΡΠ΅ΠΉΠΊΠΈ ΠΌΠ°ΡΠΊΠΈ? ΠΠ·ΠΌΠ΅Π½ΠΈΡΡ Π΅ΡΡΠ΅ΡΡΠ²Π΅Π½Π½ΡΡ ΡΡΡΡΠΊΡΡΡΡ ΡΠΊΠ°Π½Π΅ΠΉ ΡΠ΅ΠΉΠΊΠΈ ΠΌΠ°ΡΠΊΠΈ ΠΌΠΎΠ³ΡΡ Π²ΠΈΡΡΡΠ½ΡΠ΅, Π²ΠΎΡΠΏΠ°Π»ΠΈΡΠ΅Π»ΡΠ½ΡΠ΅ Π·Π°Π±ΠΎΠ»Π΅Π²Π°Π½ΠΈΡ ΠΆΠ΅Π½ΡΠΊΠΎΠΉ ΠΏΠΎΠ»ΠΎΠ²ΠΎΠΉ ΡΡΠ΅ΡΡ, ΡΡΠ°Π²ΠΌΠΈΡΠΎΠ²Π°Π½ΠΈΠ΅ ΡΠ΅ΠΉΠΊΠΈ Π²ΠΎ Π²ΡΠ΅ΠΌΡ Π»Π΅ΡΠ΅Π½ΠΈΡ ΠΈΠ»ΠΈ ΠΈΠ·-Π·Π° Π°ΠΊΡΠΈΠ²Π½ΠΎΠΉ ΡΠ΅ΠΊΡΡΠ°Π»ΡΠ½ΠΎΠΉ ΠΆΠΈΠ·Π½ΠΈ, Π°Π»Π»Π΅ΡΠ³ΠΈΡΠ΅ΡΠΊΠΈΠ΅ ΡΠ΅Π°ΠΊΡΠΈΠΈ, ΠΏΡΠΈ ΠΏΡΠΈΠΌΠ΅Π½Π΅Π½ΠΈΠΈ Ρ ΠΈΠΌΠΈΡΠ΅ΡΠΊΠΈΡ ΠΌΠ΅ΡΠΎΠ΄ΠΎΠ² ΠΊΠΎΠ½ΡΡΠ°ΡΠ΅ΠΏΡΠΈΠΈ (ΡΠΏΠ΅ΡΠΌΠΈΡΠΈΠ΄Ρ), Π½Π΅ΡΠΌΠ΅Π»ΠΎΠ΅ ΡΠΏΡΠΈΠ½ΡΠ΅Π²Π°Π½ΠΈΠ΅. ΠΡΠ΅ ΠΎΠ΄Π½ΠΈΠΌ ΡΠ°ΠΊΡΠΎΡΠΎΠΌ, ΠΏΡΠΎΠ²ΠΎΡΠΈΡΡΡΡΠΈΠΌ ΡΡΠΎΠ·ΠΈΡ, ΠΌΠΎΠΆΠ΅Ρ ΡΡΠ°ΡΡ ΡΠΌΠ΅Π½Π° ΠΏΠΎΠ»ΠΎΠ²ΠΎΠ³ΠΎ ΠΏΠ°ΡΡΠ½Π΅ΡΠ°. Π‘Π²ΡΠ·Π°Π½ΠΎ ΡΡΠΎ ΠΊΠ°ΠΊ Ρ Π²ΠΎΠ·ΠΌΠΎΠΆΠ½ΠΎΡΡΡΡ Π½ΠΎΡΠΈΡΠ΅Π»ΡΡΡΠ²Π° ΠΌΡΠΆΡΠΈΠ½ΠΎΠΉ ΡΠ°Π·Π»ΠΈΡΠ½ΡΡ ΠΈΠ½ΡΠ΅ΠΊΡΠΈΠΉ, ΡΠ°ΠΊ ΠΈ Ρ ΡΠ΅ΠΌ, ΡΡΠΎ ΠΎΠ½ Π½Π΅ ΡΠ»ΠΈΡΠΊΠΎΠΌ ΡΠ΅ΠΏΠ΅ΡΠΈΠ»Π΅Π½ Π² Π²ΠΎΠΏΡΠΎΡΠ°Ρ ΡΠΎΠ±Π»ΡΠ΄Π΅Π½ΠΈΡ Π³ΠΈΠ³ΠΈΠ΅Π½Ρ. ΠΠ·-Π·Π° ΡΠ΅Π³ΠΎ ΠΏΡΠΈ ΡΠ΅ΠΊΡΡΠ°Π»ΡΠ½ΠΎΠΌ ΠΊΠΎΠ½ΡΠ°ΠΊΡΠ΅ ΠΌΠΎΠΆΠ΅Ρ Π±ΡΡΡ Π½Π°ΡΡΡΠ΅Π½Π° ΠΌΠΈΠΊΡΠΎΡΠ»ΠΎΡΠ° Π²Π»Π°Π³Π°Π»ΠΈΡΠ°.
ΠΡΡΠΈΠ½Π½ΡΡ ΡΡΠΎΠ·ΠΈΡ ΠΎΡΠ»ΠΈΡΠ°ΡΡ ΠΎΡ ΡΠΊΡΠΎΠΏΠΈΠΈ (ΠΏΡΠ΅Π²Π΄ΠΎΡΡΠΎΠ·ΠΈΡ). ΠΡΠΈ Π΄Π°Π½Π½ΠΎΠΌ Π½Π°ΡΡΡΠ΅Π½ΠΈΠΈ ΡΠ΅Π»ΠΎΡΡΠ½ΠΎΡΡΡ ΡΠΊΠ°Π½Π΅ΠΉ ΡΠΎΡ ΡΠ°Π½ΡΠ΅ΡΡΡ, Π½ΠΎ ΡΠΏΠΈΡΠ΅Π»ΠΈΠΉ Π²ΡΠ΄Π΅Π»ΡΡΡΠΈΠΉ ΡΠ΅ΠΊΡΠ΅Ρ ΠΈΠ· ΡΠ΅ΡΠ²ΠΈΠΊΠ°Π»ΡΠ½ΠΎΠ³ΠΎ ΠΊΠ°Π½Π°Π»Π° ΡΠ°Π·ΡΠ°ΡΡΠ°Π΅ΡΡΡ Π½Π° Π²Π»Π°Π³Π°Π»ΠΈΡΠ½ΡΡ ΡΠ°ΡΡΡ ΡΠ΅ΠΉΠΊΠΈ, Π·Π°ΠΌΠ΅Π½ΡΡ ΠΌΠ½ΠΎΠ³ΠΎΡΠ»ΠΎΠΉΠ½ΡΠΉ ΠΏΠ»ΠΎΡΠΊΠΈΠΉ ΡΠΏΠΈΡΠ΅Π»ΠΈΠΉ. ΠΠΎΠΏΠΎΠ»Π½ΠΈΡΠ΅Π»ΡΠ½ΡΠΌΠΈ ΠΏΡΠΈΡΠΈΠ½Π°ΠΌΠΈ, Π½Π°ΡΡΡΠ΅Π½ΠΈΡ Π½ΠΎΡΠΌΠ°Π»ΡΠ½ΠΎΠ³ΠΎ ΡΠΎΡΡΠΎΡΠ½ΠΈΡ ΡΠ΅ΠΉΠΊΠΈ, Π½Π°ΡΡΠ΄Ρ Ρ ΠΏΠ΅ΡΠ΅ΡΠΈΡΠ»Π΅Π½Π½ΡΠΌΠΈ, ΠΏΡΠΈ ΡΠΊΡΠΎΠΏΠΈΠΈ ΡΡΠ°Π½ΠΎΠ²ΡΡΡΡ ΠΈΠ·ΠΌΠ΅Π½Π΅Π½ΠΈΠ΅ Π³ΠΎΡΠΌΠΎΠ½Π°Π»ΡΠ½ΠΎΠ³ΠΎ ΡΠΎΠ½Π°, ΡΠ½Π΄ΠΎΠΊΡΠΈΠ½Π½ΡΠ΅ Π·Π°Π±ΠΎΠ»Π΅Π²Π°Π½ΠΈΡ.
ΠΠ·ΠΌΠ΅Π½Π΅Π½ΠΈΡ ΡΡΡΡΠΊΡΡΡΡ ΡΠ΅ΠΉΠΊΠΈ ΠΎΠΏΠ°ΡΠ½Ρ ΡΠ΅ΠΌ, ΡΡΠΎ ΠΏΠΎΡΠ²Π»Π΅Π½ΠΈΠ΅ ΡΡΠ°ΡΡΠΊΠΎΠ² ΡΡΠΎΠ·ΠΈΠΈ ΡΠ΅ΠΉΠΊΠΈ ΠΌΠ°ΡΠΊΠΈ ΠΈ ΡΠΊΡΠΎΠΏΠΈΠΈ ΠΏΡΠΎΠ²ΠΎΡΠΈΡΡΡΡ ΠΎΡΠ»Π°Π±Π»Π΅Π½ΠΈΠ΅ ΠΌΠ΅ΡΡΠ½ΠΎΠ³ΠΎ ΠΈΠΌΠΌΡΠ½ΠΈΡΠ΅ΡΠ° ΡΠ΅ΠΏΡΠΎΠ΄ΡΠΊΡΠΈΠ²Π½ΠΎΠΉ ΡΠΈΡΡΠ΅ΠΌΡ. ΠΡΠΎ ΡΠΎΠ·Π΄Π°Π΅Ρ ΡΡΠ»ΠΎΠ²ΠΈΡ Π΄Π»Ρ Π²ΠΎΡΠΏΠ°Π»ΠΈΡΠ΅Π»ΡΠ½ΡΡ Π·Π°Π±ΠΎΠ»Π΅Π²Π°Π½ΠΈΠΉ Π½Π΅ ΡΠΎΠ»ΡΠΊΠΎ ΡΠ΅ΠΉΠΊΠΈ, Π½ΠΎ ΠΈ ΠΌΠ°ΡΠΊΠΈ. Π’Π°ΠΊ ΠΆΠ΅ Π½Π° ΡΠΎΠ½Π΅ ΡΠΊΡΠΎΠΏΠΈΠΈ ΠΈΠ»ΠΈ ΡΡΠΎΠ·ΠΈΠΈ ΡΠ΅ΠΉΠΊΠΈ ΠΌΠ°ΡΠΊΠΈ ΠΌΠΎΠ³ΡΡ Π½Π°ΡΠ°ΡΡΡΡ ΠΏΡΠΎΡΠ΅ΡΡΡ Π΄ΠΈΡΠΏΠ»Π°Π·ΠΈΠΈ, Π° ΠΎΠ½ΠΈ ΡΠΆΠ΅ ΡΡΠΈΡΠ°ΡΡΡΡ ΠΏΡΠ΅Π΄ΡΠ°ΠΊΠΎΠ²ΡΠΌΠΈ Π·Π°Π±ΠΎΠ»Π΅Π²Π°Π½ΠΈΡΠΌΠΈ.
Π‘ΠΈΠΌΠΏΡΠΎΠΌΡ ΡΡΠΎΠ·ΠΈΠΈ ΡΠ΅ΠΉΠΊΠΈ ΠΌΠ°ΡΠΊΠΈ
ΠΠ±ΡΠ°ΡΠΈΡΡΡΡ ΠΊ Π³ΠΈΠ½Π΅ΠΊΠΎΠ»ΠΎΠ³Ρ Π½Π΅ΠΎΠ±Ρ ΠΎΠ΄ΠΈΠΌΠΎ Π΅ΡΠ»ΠΈ ΠΎΡΠΌΠ΅ΡΠ°Π΅ΡΡΡ Π±ΠΎΠ»ΡΡΠ΅Π΅ ΡΠΈΡΠ»ΠΎ Π²ΡΠ΄Π΅Π»Π΅Π½ΠΈΠΉ ΠΈΠ· ΠΏΠΎΠ»ΠΎΠ²ΡΡ ΠΏΡΡΠ΅ΠΉ, ΡΠ΅ΠΌ ΠΎΠ±ΡΡΠ½ΠΎ, Π²ΠΎΠ·ΠΌΠΎΠΆΠ½ΠΎ Π³Π½ΠΎΠΉΠ½ΡΡ . ΠΠΎΡΠ»Π΅ ΡΠ΅ΠΊΡΠ° Π½Π° Π±Π΅Π»ΡΠ΅ ΠΏΠΎΡΠ²Π»ΡΠ΅ΡΡΡ ΡΡΠΊΡΠΎΠ²ΠΈΡΠ°. Π‘ΠΎΠΏΡΡΡΡΠ²ΡΡΡΠΈΠΌΠΈ ΡΠΈΠ³Π½Π°Π»Π°ΠΌΠΈ ΡΠ°ΠΊΠΆΠ΅ ΠΌΠΎΠ³ΡΡ ΡΡΠ°ΡΡ ΡΡΠ²ΡΡΠ²ΠΎ Π·ΡΠ΄Π°, ΠΆΠΆΠ΅Π½ΠΈΡ Π² ΠΎΠ±Π»Π°ΡΡΠΈ Π³Π΅Π½ΠΈΡΠ°Π»ΠΈΠΉ. ΠΠ³Π½ΠΎΡΠΈΡΠΎΠ²Π°ΡΡ ΡΠΈΠΌΠΏΡΠΎΠΌΡ, Π½Π΅ΡΠΌΠΎΡΡΡ Π½Π° ΠΈΡ Π½Π΅ΠΎΡΠ΅Π²ΠΈΠ΄Π½ΠΎΡΡΡ (Π²ΡΠ΅Π³Π΄Π° ΠΌΠΎΠΆΠ½ΠΎ ΡΠΏΠΈΡΠ°ΡΡ Π½Π° ΠΈΠ·ΠΌΠ΅Π½Π΅Π½ΠΈΠ΅ Π³ΠΎΡΠΌΠΎΠ½Π°Π»ΡΠ½ΠΎΠ³ΠΎ ΡΠΎΠ½Π°, Π°Π»Π»Π΅ΡΠ³ΠΈΡ), Π½Π΅ Π½Π΅Π»ΡΠ·Ρ. ΠΡΠΎΠ·ΠΈΡ ΡΠ°ΡΡΠΎ Π²ΠΎΠ·Π½ΠΈΠΊΠ°Π΅Ρ Π½Π° ΡΠΎΠ½Π΅ Π²ΠΈΡΡΡΠ½ΡΡ ΠΈΠ½ΡΠ΅ΠΊΡΠΈΠΉ β Π²ΠΈΡΡΡ ΠΏΠ°ΠΏΠΈΠ»Π»ΠΎΠΌΡ ΡΠ΅Π»ΠΎΠ²Π΅ΠΊΠ°, Π³Π΅Π½ΠΈΡΠ°Π»ΡΠ½ΡΠΉ Π³Π΅ΡΠΏΠ΅Ρ, ΠΈΠ½ΡΠ΅ΠΊΡΠΈΠΉ, ΠΏΡΠ΅Π΄Π°Π²Π°Π΅ΠΌΡΠ΅ ΠΏΠΎΠ»ΠΎΠ²ΡΠΌ ΠΏΡΡΠ΅ΠΌ. Π ΠΎΠ½ΠΈ ΡΡΠ΅Π±ΡΡΡ Π½Π΅ΠΎΡΠ»ΠΎΠΆΠ½ΠΎΠ³ΠΎ Π»Π΅ΡΠ΅Π½ΠΈΡ.
Π’Π°ΠΊΡΠΈΠΊΠ° Π΄ΠΈΠ°Π³Π½ΠΎΡΡΠΈΠΊΠΈ ΡΡΠΎΠ·ΠΈΠΈ
Π’ΡΠΈ ΠΏΡΠΎΡΡΡΡ ΡΠ°Π³Π°:
- ΠΎΡΠΌΠΎΡΡ Π³ΠΈΠ½Π΅ΠΊΠΎΠ»ΠΎΠ³Π°, ΡΡΠΎΠ±Ρ ΠΏΠΎΠ΄ΡΠ²Π΅ΡΠ΄ΠΈΡΡ ΠΈΠ»ΠΈ ΠΎΠΏΡΠΎΠ²Π΅ΡΠ³Π½ΡΡΡ ΡΡΠΎΠ·ΠΈΡ ΡΠ΅ΠΉΠΊΠΈ.
- ΠΏΡΠΎΠ²Π΅Π΄Π΅Π½ΠΈΠ΅ ΠΊΠΎΠ»ΡΠΏΠΎΡΠΊΠΎΠΏΠΈΠΈ Π΄Π»Ρ ΡΡΠΎΡΠ½Π΅Π½ΠΈΡ Π΄ΠΈΠ°Π³Π½ΠΎΠ·Π°;
- Π²Π·ΡΡΠΈΠ΅ Π±ΠΈΠΎΠΌΠ°ΡΠ΅ΡΠΈΠ°Π»Π° Π΄Π»Ρ ΡΠΈΡΠΎΠ»ΠΎΠ³ΠΈΡΠ΅ΡΠΊΠΎΠ³ΠΎ ΠΈΡΡΠ»Π΅Π΄ΠΎΠ²Π°Π½ΠΈΡ (ΠΈΡΠΊΠ»ΡΡΠ΅Π½ΠΈΡ ΠΏΠΎΠ΄ΠΎΠ·ΡΠ΅Π½ΠΈΠΉ Π½Π° Π΄ΠΈΡΠΏΠ»Π°Π·ΠΈΡ, ΡΠ°ΠΊ ΡΠ΅ΠΉΠΊΠΈ ΠΌΠ°ΡΠΊΠΈ), ΠΠ¦Π β ΠΈΡΡΠ»Π΅Π΄ΠΎΠ²Π°Π½ΠΈΠ΅ Π½Π° ΠΎΠΏΡΠ΅Π΄Π΅Π»Π΅Π½ΠΈΠ΅ Π²ΠΈΡΡΡΠΎΠ².
ΠΡΠΆΠ½ΠΎ ΠΈΠΌΠ΅ΡΡ Π²Π²ΠΈΠ΄Ρ, ΡΡΠΎ Π½Π΅ΡΠΌΠΎΡΡΡ Π½Π° ΠΊΠ°ΠΆΡΡΡΡΡΡ ΠΏΡΠΎΡΡΠΎΡΡ ΠΌΠ΅ΡΠΎΠ΄ΠΎΠ², Π²ΡΡΠ²Π»ΡΡΡΠΈΡ ΡΡΠΎΠ·ΠΈΡ, ΠΏΡΠΈΡ ΠΎΠ΄ΠΈΡΡ Π½Π° ΠΎΠ±ΡΠ»Π΅Π΄ΠΎΠ²Π°Π½ΠΈΠ΅ ΡΠ»Π΅Π΄ΡΠ΅Ρ Π»ΠΈΡΡ Π² ΠΏΡΠΎΠ²Π΅ΡΠ΅Π½Π½ΡΡ ΠΊΠ»ΠΈΠ½ΠΈΠΊΡ, Π³Π΄Π΅ ΡΠ°Π±ΠΎΡΠ°ΡΡ ΠΊΠ²Π°Π»ΠΈΡΠΈΡΠΈΡΠΎΠ²Π°Π½Π½ΡΠ΅ ΡΠΏΠ΅ΡΠΈΠ°Π»ΠΈΡΡΡ, Π° Π² Π°ΡΡΠ΅Π½Π°Π»Π΅ Π³ΠΈΠ½Π΅ΠΊΠΎΠ»ΠΎΠ³ΠΎΠ² ΠΈΠΌΠ΅Π΅Ρ ΡΠ°ΠΌΠΎΠ΅ ΡΠΎΠ²ΡΠ΅ΠΌΠ΅Π½Π½ΠΎΠ΅ ΠΎΠ±ΠΎΡΡΠ΄ΠΎΠ²Π°Π½ΠΈΠ΅. Π ΠΈΡΠΊΠΎΠΌ Π½Π΅ΠΊΠ°ΡΠ΅ΡΡΠ²Π΅Π½Π½ΠΎΠ³ΠΎ ΠΎΠ±ΡΠ»Π΅Π΄ΠΎΠ²Π°Π½ΠΈΡ (Π½Π΅ ΠΏΡΠ°Π²ΠΈΠ»ΡΠ½ΠΎ Π²Π·ΡΡ ΡΠΎΡΠΊΠΎΠ±, ΠΏΡΠΎΠΏΡΡΠ΅Π½Π° ΠΌΠΈΠΊΡΠΎΡΠΊΠΎΠΏΠΈΡΠ΅ΡΠΊΠ°Ρ Π·ΠΎΠ½Π° ΡΡΠ°Π½ΡΡΠΎΡΠΌΠ°ΡΠΈΠΈ ΡΠΏΠΈΡΠ΅Π»ΠΈΡ) ΠΌΠΎΠΆΠ΅Ρ ΡΡΠ°ΡΡ ΠΏΠΎΠ·Π΄Π½ΡΡ Π΄ΠΈΠ°Π³Π½ΠΎΡΡΠΈΠΊΠ° ΡΠ°ΠΊΠ° ΡΠ΅ΠΉΠΊΠΈ ΠΌΠ°ΡΠΊΠΈ. Π ΠΏΡΠΈΠΌΠ΅ΡΡ, ΡΠΏΠ΅ΡΠΈΠ°Π»ΠΈΡΡΡ ΠΠ»ΠΈΠ½ΠΈΠΊΠΈ Π‘ΠΎΠ²ΡΠ΅ΠΌΠ΅Π½Π½ΡΡ Π’Π΅Ρ Π½ΠΎΠ»ΠΎΠ³ΠΈΠΉ (ΠΠ‘Π’) ΡΠ΅Π³ΡΠ»ΡΡΠ½ΠΎ ΠΏΡΠΎΡ ΠΎΠ΄ΡΡ ΡΠΏΠ΅ΡΠΈΠ°Π»ΠΈΠ·ΠΈΡΠΎΠ²Π°Π½Π½ΠΎΠ΅ ΠΎΠ±ΡΡΠ΅Π½ΠΈΠ΅ ΠΏΠΎ Π²ΠΎΠΏΡΠΎΡΠ°ΠΌ Π½Π°ΠΈΠ»ΡΡΡΠ΅Π³ΠΎ ΠΎΠ±Π΅ΡΠΏΠ΅ΡΠ΅Π½ΠΈΡ Π³ΠΈΠ½Π΅ΠΊΠΎΠ»ΠΎΠ³ΠΈΡΠ΅ΡΠΊΠΎΠΉ ΠΏΠΎΠΌΠΎΡΠΈ. Π ΠΎΡΠ½Π°ΡΠ΅Π½Π° ΠΊΠ»ΠΈΠ½ΠΈΠΊΠΈ ΡΠΎΠ²ΡΠ΅ΠΌΠ΅Π½Π½ΡΠΌ ΠΊΠΎΠ»ΡΠΏΠΎΡΠΊΠΎΠΏΠΎΠΌ β Karl Kaps SOM 52, ΠΎΡΠ»ΠΈΡΠ°ΡΡΠΈΠΌΡΡ ΠΌΠΎΡΠ½ΠΎΠΉ ΠΎΠΏΡΠΈΠΊΠΎΠΉ, ΠΈΠ½Π½ΠΎΠ²Π°ΡΠΈΠΎΠ½Π½ΡΠΌ Π‘Π2 Π»Π°Π·Π΅ΡΠΎΠΌ EraserβC, ΠΏΡΠΈ ΠΏΠΎΠΌΠΎΡΠΈ ΠΊΠΎΡΠΎΡΠΎΠ³ΠΎ ΠΏΠΎΡΠ»Π΅ ΠΎΠ±ΡΠ»Π΅Π΄ΠΎΠ²Π°Π½ΠΈΡ ΠΈ ΠΏΠΎ ΠΏΠΎΠΊΠ°Π·Π°Π½ΠΈΡΠΌ ΠΏΡΠΎΠ²ΠΎΠ΄ΠΈΡΡΡ ΠΌΠ°Π»ΠΎΠΈΠ½Π²Π°Π·ΠΈΠ²Π½ΡΠ΅ ΠΏΡΠΎΡΠ΅Π΄ΡΡΡ Π»Π΅ΡΠ΅Π½ΠΈΡ ΡΠ΅ΠΉΠΊΠΈ.
ΠΡΠΈΠ½ΡΠΈΠΏΡ Π»Π΅ΡΠ΅Π½ΠΈΡ
ΠΡΠ΄Π΅Π»ΡΡΡ Π΄Π²Π° ΠΎΡΠ½ΠΎΠ²Π½ΡΡ Π½Π°ΠΏΡΠ°Π²Π»Π΅Π½ΠΈΡ ΡΠ΅ΡΠ°ΠΏΠΈΠΈ: ΠΊΠΎΠ½ΡΠ΅ΡΠ²Π°ΡΠΈΠ²Π½ΠΎΠ΅ Π»Π΅ΡΠ΅Π½ΠΈΠ΅ ΠΈ ΡΠ°ΠΊ Π½Π°Π·ΡΠ²Π°Π΅ΠΌΠΎΠ΅ ΠΏΡΠΈΠΆΠΈΠ³Π°Π½ΠΈΠ΅ ΡΡΠΎΠ·ΠΈΠΈ ΠΈΠ»ΠΈ Ρ ΠΈΡΡΡΠ³ΠΈΡΠ΅ΡΠΊΠΈΠ΅ ΡΠΏΠΎΡΠΎΠ±Ρ Π»Π΅ΡΠ΅Π½ΠΈΡ.
ΠΠ΅Π΄ΠΈΠΊΠ°ΠΌΠ΅Π½ΡΠΎΠ·Π½ΠΎΠ΅ Π»Π΅ΡΠ΅Π½ΠΈΠ΅ Π·Π°Π²ΠΈΡΠΈΡ ΠΎΡ Π²ΡΡΠ²Π»Π΅Π½Π½ΠΎΠΉ ΠΏΡΠΈΡΠΈΠ½Ρ ΡΠ°Π·Π²ΠΈΡΠΈΡ ΡΡΠΎΠ·ΠΈΠΈ Π½Π° ΡΠ΅ΠΉΠΊΠ΅ ΠΌΠ°ΡΠΊΠΈ. ΠΡΠΈ Π²ΠΈΡΡΡΠ½ΠΎΠΉ ΠΏΡΠΈΡΠΎΠ΄Π΅ Π²ΠΎΡΠΏΠ°Π»Π΅Π½ΠΈΡ Π½Π°Π·Π½Π°ΡΠ°ΡΡ ΠΏΡΠΎΡΠΈΠ²ΠΎΠ²ΠΈΡΡΡΠ½ΡΠ΅, ΠΈΠΌΠΌΡΠ½ΠΎΡΡΠΈΠΌΡΠ»ΠΈΡΡΡΡΠΈΠ΅ ΡΡΠ΅Π΄ΡΡΠ²Π°, ΠΏΡΠΈ Π±Π°ΠΊΡΠ΅ΡΠΈΠ°Π»ΡΠ½ΠΎΠΉ β ΠΏΠΎΠΊΠ°Π·Π°Π½Ρ Π°Π½ΡΠΈΠ±ΠΈΠΎΡΠΈΠΊΠΈ, ΠΏΡΠΈ ΠΊΠ°Π½Π΄ΠΈΠ΄ΠΎΠ·Π΅ β Π°Π½ΡΠΈΠΌΠΈΠΊΠΎΡΠΈΠΊΠΈ. ΠΡΠ»ΠΈ Π½Π°ΡΡΡΠ΅Π½ ΡΠΎΡΡΠ°Π² ΠΌΠΈΠΊΡΠΎΡΠ»ΠΎΡΡ Π²Π»Π°Π³Π°Π»ΠΈΡΠ° ΠΌΠΎΠ³ΡΡ ΠΏΡΠΈΠΌΠ΅Π½ΡΡΡΡ ΠΊΠΎΠΌΠΏΠ»Π΅ΠΊΡΠ½ΡΠ΅ Π²Π°Π³ΠΈΠ½Π°Π»ΡΠ½ΡΠ΅ ΡΡΠ΅Π΄ΡΡΠ²Π°, Π½Π°ΠΏΡΠ°Π²Π»Π΅Π½Π½ΡΠ΅ Π½Π° ΡΡΡΡΠ°Π½Π΅Π½ΠΈΠ΅ Π²ΠΎΡΠΏΠ°Π»Π΅Π½ΠΈΡ ΠΈ ΡΠ½ΠΈΡΡΠΎΠΆΠ΅Π½ΠΈΠ΅ ΠΏΠ°ΡΠΎΠ³Π΅Π½ΠΎΠ². Π Π½Π΅ΠΊΠΎΡΠΎΡΡΡ ΡΠ»ΡΡΠ°ΡΡ Π½Π°Π·Π½Π°ΡΠ°ΡΡ Ρ ΠΈΠΌΠΈΡΠ΅ΡΠΊΠΈΠ΅ ΠΏΡΠ΅ΠΏΠ°ΡΠ°ΡΡ Π΄Π»Ρ ΠΏΡΠΈΠΆΠΈΠ³Π°Π½ΠΈΡ ΡΡΠΎΠ·ΠΈΠΈ, ΡΠΏΠΎΡΠΎΠ±ΡΡΠ²ΡΡΡΠΈΠ΅ ΠΎΡΡΠΎΡΠΆΠ΅Π½ΠΈΡ ΠΏΠΎΡΠ°ΠΆΠ΅Π½Π½ΠΎΠ³ΠΎ ΡΠΏΠΈΡΠ΅Π»ΠΈΡ. Π’Π°ΠΊΠΎΠ΅ ΠΏΡΠΈΠΆΠΈΠ³Π°Π½ΠΈΠ΅ Π½Π°Π·Π½Π°ΡΠ°Π΅ΡΡΡ Π½Π΅ ΡΠ°ΡΡΠΎ, ΡΠ°ΠΊ ΠΊΠ°ΠΊ Π²ΡΡΠΎΠΊΠ° Π²Π΅ΡΠΎΡΡΠ½ΠΎΡΡΡ ΡΠ°Π·Π²ΠΈΡΠΈΡ Π°Π»Π»Π΅ΡΠ³ΠΈΡΠ΅ΡΠΊΠΎΠΉ ΡΠ΅Π°ΠΊΡΠΈΠΈ. Π ΡΡΡΠ΅ΠΊΡ ΠΎΡ ΠΏΡΠΎΠ²Π΅Π΄Π΅Π½ΠΈΡ ΠΏΡΠΈΠΆΠΈΠ³Π°Π½ΠΈΡ ΡΡΠΎΠ·ΠΈΠΈ ΡΠ΅ΠΉΠΊΠΈ ΠΌΠ°ΡΠΊΠΈ Π² ΡΡΠΎΠΌ ΡΠ»ΡΡΠ°Π΅ ΠΌΠΎΠΆΠ΅Ρ Π±ΡΡΡ Π½Π΅Π΄ΠΎΡΡΠ°ΡΠΎΡΠ½ΡΠΌ, ΡΡΠΎΠ·ΠΈΡ ΠΌΠΎΠΆΠ΅Ρ ΡΡΠ°ΡΡ ΡΠ΅ΡΠΈΠ΄ΠΈΠ²ΠΈΡΡΡΡΠ΅ΠΉ. Π₯ΠΈΠΌΠΈΡΠ΅ΡΠΊΠΎΠ΅ ΠΏΡΠΈΠΆΠΈΠ³Π°Π½ΠΈΠ΅ ΡΠ°ΠΊΠΆΠ΅ Π½Π΅ ΡΠ΅ΠΊΠΎΠΌΠ΅Π½Π΄ΠΎΠ²Π°Π½ΠΎ Π΄Π»Ρ Π»Π΅ΡΠ΅Π½ΠΈΡ ΠΆΠ΅Π½ΡΠΈΠ½ Ρ ΠΎΠ±ΡΠΈΡΠ½ΠΎΠΉ ΡΡΠΎΠ·ΠΈΠ΅ΠΉ.
Π ΠΏΡΠΎΡΠΈΠ²ΠΎΠ²Π΅Ρ Ρ ΠΈΠΌΠΈΡΠ΅ΡΠΊΠΎΠΌΡ ΠΏΡΠΈΠΆΠΈΠ³Π°Π½ΠΈΡ ΡΡΠΎΠ·ΠΈΠΈ, Π² ΡΠΎΠ²ΡΠ΅ΠΌΠ΅Π½Π½ΡΡ ΠΊΠ»ΠΈΠ½ΠΈΠΊΠ°Ρ ΠΏΠ°ΡΠΈΠ΅Π½ΡΠΊΠ°ΠΌ Π²ΡΠ°Ρ ΠΏΠΎΡΠΎΠ²Π΅ΡΡΠ΅Ρ Π΄Π²Π΅ Π½Π°ΠΈΠ±ΠΎΠ»Π΅Π΅ ΠΏΠ΅ΡΠ΅Π΄ΠΎΠ²ΡΠ΅ ΠΌΠ΅ΡΠΎΠ΄ΠΈΠΊΠΈ ΡΡΡΡΠ°Π½Π΅Π½ΠΈΡ ΠΏΠ°ΡΠΎΠ»ΠΎΠ³ΠΈΡΠ΅ΡΠΊΠΎΠ³ΠΎ ΠΎΡΠ°Π³Π° β ΡΡΠΎ ΠΏΡΠΈΠΌΠ΅Π½Π΅Π½ΠΈΠ΅ Π΄Π»Ρ ΠΏΡΠΈΠΆΠΈΠ³Π°Π½ΠΈΡ ΡΡΠΎΠ·ΠΈΠΈ ΡΠ°Π΄ΠΈΠΎΠ½ΠΎΠΆΠ° ΠΈ Π»Π°Π·Π΅ΡΠ°.
Π₯ΠΈΡΡΡΠ³ΠΈΡΠ΅ΡΠΊΠΎΠ΅ Π»Π΅ΡΠ΅Π½ΠΈΠ΅ ΡΠ°ΡΡΠΎ Π½Π°Π·ΡΠ²Π°ΡΡ ΠΏΡΠΈΠΆΠΈΠ³Π°Π½ΠΈΠ΅ΠΌ, ΡΡΠΎ Π½Π΅ ΡΠΎΠ²ΡΠ΅ΠΌ Π²Π΅ΡΠ½ΠΎ Ρ ΠΌΠ΅Π΄ΠΈΡΠΈΠ½ΡΠΊΠΎΠΉ ΡΠΎΡΠΊΠΈ Π·ΡΠ΅Π½ΠΈΡ, Π½ΠΎ ΠΏΠΎΠ½ΡΡΠ½ΠΎ ΠΏΠ°ΡΠΈΠ΅Π½ΡΠΊΠ°ΠΌ.
Π Π°Π΄ΠΈΠΎΠ²ΠΎΠ»Π½ΠΎΠ²Π°Ρ Ρ ΠΈΡΡΡΠ³ΠΈΡ. ΠΠ»Ρ ΠΏΠΎΠ΄ΠΎΠ±Π½ΠΎΠ³ΠΎ ΠΏΡΠΈΠΆΠΈΠ³Π°Π½ΠΈΡ ΡΡΠΎΠ·ΠΈΠΈ ΡΠ΅ΠΉΠΊΠΈ ΠΌΠ°ΡΠΊΠΈ ΠΈΡΠΏΠΎΠ»ΡΠ·ΡΡΡ ΡΠ°Π΄ΠΈΠΎΠ½ΠΎΠΆ. ΠΡΠΈ ΡΡΠΎΠΌ, ΠΏΡΠΈ ΠΏΡΠΎΠ²Π΅Π΄Π΅Π½ΠΈΠΈ Π»Π΅ΡΠ΅Π½ΠΈΡ ΡΠ΄Π°Π΅ΡΡΡ ΡΠΎΡ ΡΠ°Π½ΠΈΡΡ ΡΠΊΠ°Π½Ρ Π΄Π»Ρ Π³ΠΈΡΡΠΎΠ»ΠΎΠ³ΠΈΡΠ΅ΡΠΊΠΎΠ³ΠΎ ΠΈΡΡΠ»Π΅Π΄ΠΎΠ²Π°Π½ΠΈΡ, ΡΡΠΎΠ±Ρ ΡΠΎΡΠ½ΠΎ ΠΈΡΠΊΠ»ΡΡΠΈΡΡ ΡΠΈΡΠΊ ΠΎΠ½ΠΊΠΎΠ»ΠΎΠ³ΠΈΠΈ. ΠΡΠΎΡΠ΅Π΄ΡΡΠ° ΡΠ°Π΄ΠΈΠΎΠ²ΠΎΠ»Π½ΠΎΠ²ΠΎΠ³ΠΎ ΠΏΡΠΈΠΆΠΈΠ³Π°Π½ΠΈΡ ΡΡΠΎΠ·ΠΈΠΈ, Π²ΡΠΏΠΎΠ»Π½ΡΠ΅ΠΌΠ°Ρ, ΠΊΠ°ΠΊ ΠΏΡΠ°Π²ΠΈΠ»ΠΎ Ρ ΠΏΠΎΠΌΠΎΡΡΡ ΠΏΡΠΈΠ±ΠΎΡΠ° Β«Π‘ΡΡΠ³ΠΈΡΡΠΎΠ½Β» ΠΈΠΌΠ΅Π΅Ρ ΡΡΠ΄ ΠΏΡΠ΅ΠΈΠΌΡΡΠ΅ΡΡΠ²: ΠΎΠ½Π° Π½Π΅ ΡΡΠ΅Π±ΡΠ΅Ρ ΠΊΡΠΎΠΏΠΎΡΠ»ΠΈΠ²ΠΎΠΉ ΠΏΠΎΠ΄Π³ΠΎΡΠΎΠ²ΠΊΠΈ ΠΈ ΠΏΡΠΎΡ ΠΎΠΆΠ΄Π΅Π½ΠΈΡ Π΄ΠΈΡΠΏΠ°Π½ΡΠ΅ΡΠΈΠ·Π°ΡΠΈΠΈ, Π½Π΅ Π·Π°Π½ΠΈΠΌΠ°Π΅Ρ ΠΌΠ½ΠΎΠ³ΠΎ Π²ΡΠ΅ΠΌΠ΅Π½ΠΈ, Π±Π΅Π·Π±ΠΎΠ»Π΅Π·Π½Π΅Π½Π½Π° (Π½Π΅ΡΠ²Π½ΡΠ΅ ΠΎΠΊΠΎΠ½ΡΠ°Π½ΠΈΡ ΠΊΠΎΠ°Π³ΡΠ»ΠΈΡΡΡΡΡΡ ΡΠ°Π΄ΠΈΠΎΡΠ»Π΅ΠΊΡΡΠΎΠ΄ΠΎΠΌ). Π’Π°ΠΊ ΠΆΠ΅ Π±Π»Π°Π³ΠΎΠ΄Π°ΡΡ Π΄Π΅ΠΉΡΡΠ²ΠΈΡ ΡΠ°Π΄ΠΈΠΎΠ²ΠΎΠ»Π½Ρ ΠΏΡΠΎΠΈΡΡ ΠΎΠ΄ΠΈΡ Π΄ΠΎΠΏΠΎΠ»Π½ΠΈΡΠ΅Π»ΡΠ½ΠΎΠ΅ ΠΎΠ±Π΅Π·Π·Π°ΡΠ°ΠΆΠΈΠ²Π°Π½ΠΈΠ΅ ΡΠΊΠ°Π½Π΅ΠΉ, ΡΡΠΎ ΡΠ½ΠΈΠΆΠ°Π΅Ρ ΡΠΈΡΠΊ Π²ΠΎΡΠΏΠ°Π»Π΅Π½ΠΈΡ, ΡΡΠΊΠΎΡΡΠ΅Ρ Π²ΠΎΡΡΡΠ°Π½ΠΎΠ²Π»Π΅Π½ΠΈΠ΅ Π½ΠΎΡΠΌΠ°Π»ΡΠ½ΠΎΠΉ ΡΡΡΡΠΊΡΡΡΡ ΡΠ΅ΠΉΠΊΠΈ ΠΌΠ°ΡΠΊΠΈ. ΠΡΠΎΠ²Π΅Π΄Π΅Π½Π½ΡΠ΅ ΠΈΡΡΠ»Π΅Π΄ΠΎΠ²Π°Π½ΠΈΡ, ΠΏΠΎΠ΄ΡΠ²Π΅ΡΠ΄ΠΈΠ»ΠΈ, ΠΈ ΡΠΎΡ ΡΠ°ΠΊΡ, ΡΡΠΎ ΠΏΠΎΡΠ»Π΅ ΡΠ°Π΄ΠΈΠΎΠ²ΠΎΠ»Π½ΠΎΠ²ΠΎΠ³ΠΎ ΠΏΡΠΈΠΆΠΈΠ³Π°Π½ΠΈΡ ΡΡΠΎΠ·ΠΈΠΈ ΡΠ΅ΠΉΠΊΠΈ ΠΌΠ°ΡΠΊΠΈ ΠΎΡΠΌΠ΅ΡΠ°Π΅ΡΡΡ Π½ΠΎΡΠΌΠ°Π»ΠΈΠ·Π°ΡΠΈΡ ΡΠΎΡΡΠ°Π²Π° ΠΌΠΈΠΊΡΠΎΡΠ»ΠΎΡΡ ΡΠ΅ΠΉΠΊΠΈ, Ρ ΠΏΡΠ΅ΠΎΠ±Π»Π°Π΄Π°Π½ΠΈΠ΅ΠΌ Π»Π°ΠΊΡΠΎΠ±Π°ΠΊΡΠ΅ΡΠΈΠΉ. ΠΠ½ΡΠΌΠΈ ΡΠ»ΠΎΠ²Π°ΠΌΠΈ, Π·Π°ΠΏΡΡΠΊΠ°ΡΡΡΡ ΠΏΡΠΎΡΠ΅ΡΡΡ Π΅ΡΡΠ΅ΡΡΠ²Π΅Π½Π½ΠΎΠ³ΠΎ Π²ΠΎΡΡΡΠ°Π½ΠΎΠ²Π»Π΅Π½ΠΈΡ ΠΌΠΈΠΊΡΠΎΠ±ΠΈΠΎΡΡ.
ΠΠ°Π·Π΅ΡΠ½Π°Ρ Π΄Π΅ΡΡΡΡΠΊΡΠΈΡ ΠΈΠ»ΠΈ ΠΌΠ΅ΡΠΎΠ΄ΠΈΠΊΠ° ΠΏΡΠΈΠΆΠΈΠ³Π°Π½ΠΈΡ Π»Π°Π·Π΅ΡΠΎΠΌ β Π΄ΠΎΡΡΠΎΠΈΠ½ΡΡΠ²ΠΎΠΌ ΠΏΡΠΈΠΌΠ΅Π½Π΅Π½ΠΈΡ Π»Π°Π·Π΅ΡΠ½ΠΎΠ³ΠΎ ΠΏΡΠΈΠΆΠΈΠ³Π°Π½ΠΈΡ ΡΡΠ°Π½ΠΎΠ²ΠΈΡΡΡ ΡΠ°ΠΊΠΆΠ΅ Π±Π΅Π·Π±ΠΎΠ»Π΅Π·Π½Π΅Π½Π½ΠΎΠ΅ ΡΡΡΡΠ°Π½Π΅Π½ΠΈΠ΅ ΡΡΠΎΠ·ΠΈΠΈ. ΠΡΠΈ ΡΡΠΎΠΌ Π²Π½Π΅Π΄ΡΠ΅Π½ΠΈΠ΅ ΡΠΎΠ²ΡΠ΅ΠΌΠ΅Π½Π½ΡΡ Π»Π°Π·Π΅ΡΠΎΠ², ΠΊ ΠΏΡΠΈΠΌΠ΅ΡΡ, Π‘Π2 Π»Π°Π·Π΅ΡΠ° EraserβC, ΠΏΠΎΠ·Π²ΠΎΠ»ΡΠ΅Ρ Π²ΡΠ°ΡΡ ΠΌΠ°ΠΊΡΠΈΠΌΠ°Π»ΡΠ½ΠΎ ΠΊΠΎΠ½ΡΡΠΎΠ»ΠΈΡΠΎΠ²Π°ΡΡ Π³Π»ΡΠ±ΠΈΠ½Ρ ΠΏΡΠΈΠΆΠΈΠ³Π°Π½ΠΈΡ, Π½Π΅ ΠΏΠΎΠ²ΡΠ΅ΠΆΠ΄Π°Ρ Π·Π΄ΠΎΡΠΎΠ²ΡΠ΅ ΡΠΊΠ°Π½ΠΈ, ΡΠ²Π΅Π»ΠΈΡΠΈΠ²Π°ΡΡ ΡΠΎΡΠ½ΠΎΡΡΡ Π²ΠΎΠ·Π΄Π΅ΠΉΡΡΠ²ΠΈΡ ΡΠΎΠ»ΡΠΊΠΎ Π½Π° ΡΡΠΎΠ·ΠΈΡ, ΠΈΠ·Π±Π΅Π³Π°Ρ Π·Π΄ΠΎΡΠΎΠ²ΡΡ ΡΠΊΠ°Π½Π΅ΠΉ. ΠΡΠΈ ΡΠ°ΠΊΠΎΠΌ ΠΌΠ΅ΡΠΎΠ΄Π΅ Π²ΠΎΡΡΡΠ°Π½ΠΎΠ²Π»Π΅Π½ΠΈΡ ΡΠ΅ΠΉΠΊΠ° Π½Π΅ ΡΡΠ°Π²ΠΌΠΈΡΡΠ΅ΡΡΡ, Π½Π΅ Π²ΠΎΠ·Π½ΠΈΠΊΠ°Π΅Ρ Π²Π΅ΡΠΎΡΡΠ½ΠΎΡΡΡ ΡΠΎΡΠΌΠΈΡΠΎΠ²Π°Π½ΠΈΡ ΡΡΠ±ΡΠΎΠ²ΠΎΠΉ ΡΠΊΠ°Π½ΠΈ, Π·Π°ΠΆΠΈΠ²Π»Π΅Π½ΠΈΠ΅ ΠΏΡΠΎΠΈΡΡ ΠΎΠ΄ΠΈΡ Π΄ΠΎΡΡΠ°ΡΠΎΡΠ½ΠΎ Π±ΡΡΡΡΠΎ.
ΠΠΎΡΡΡΠ°Π½ΠΎΠ²Π»Π΅Π½ΠΈΠ΅ ΠΏΠΎΡΠ»Π΅ Β«ΠΏΡΠΈΠΆΠΈΠ³Π°Π½ΠΈΡΒ» ΡΡΠΎΠ·ΠΈΠΈ
ΠΠΎ β ΠΏΠ΅ΡΠ²ΡΡ , ΠΏΠΎΡΠ»Π΅ ΠΏΡΠΈΠΆΠΈΠ³Π°Π½ΠΈΡ ΡΡΠΎΠ·ΠΈΠΈ ΠΏΠ°ΡΠΈΠ΅Π½ΡΠΊΠ° Π±ΡΠ΄Π΅Ρ Π½Π°Ρ ΠΎΠ΄ΠΈΡΡΡ ΠΏΠΎΠ΄ Π½Π°Π±Π»ΡΠ΄Π΅Π½ΠΈΠ΅ΠΌ Π³ΠΈΠ½Π΅ΠΊΠΎΠ»ΠΎΠ³Π°. ΠΡΠΎ Π·Π½Π°ΡΠΈΡ, ΡΡΠΎ ΠΏΡΠΎΠΏΡΡΠΊΠ°ΡΡ Π½Π°Π·Π½Π°ΡΠ΅Π½Π½ΡΠ΅ Π²ΠΈΠ·ΠΈΡΡ ΠΊ Π²ΡΠ°ΡΡ Π½Π΅Π»ΡΠ·Ρ. ΠΠΌΠ΅Π½Π½ΠΎ Π²ΠΎ Π²ΡΠ΅ΠΌΡ ΠΎΡΠΌΠΎΡΡΠ° Π²ΡΠ°Ρ ΠΏΡΠΎΠ²Π΅Π΄Π΅Ρ Π΄ΠΎΠΏΠΎΠ»Π½ΠΈΡΠ΅Π»ΡΠ½ΡΡ Π°Π½ΡΠΈΡΠ΅ΠΏΡΠΈΡΠ΅ΡΠΊΡΡ ΠΎΠ±ΡΠ°Π±ΠΎΡΠΊΡ ΠΌΠ΅ΡΡΠ° ΠΏΡΠΈΠΆΠΈΠ³Π°Π½ΠΈΡ, Π° ΡΠ°ΠΊΠΆΠ΅ Π²Π²Π΅Π΄Π΅Ρ ΡΠ°ΠΌΠΏΠΎΠ½ Ρ Π²Π΅ΡΠ΅ΡΡΠ²Π°ΠΌΠΈ, ΡΠ»ΡΡΡΠ°ΡΡΠΈΠΌΠΈ ΡΠ΅Π³Π΅Π½Π΅ΡΠ°ΡΠΈΡ ΡΠΊΠ°Π½Π΅ΠΉ. Π ΡΠ΅ΡΠ΅Π½ΠΈΠ΅ Π½Π΅ΡΠΊΠΎΠ»ΡΠΊΠΈΡ Π΄Π½Π΅ΠΉ (Π½Π΅Π΄Π΅Π»ΠΈ) ΠΈΡΠΏΠΎΠ»ΡΠ·ΠΎΠ²Π°Π½ΠΈΠ΅ ΠΏΡΠ΅ΠΏΠ°ΡΠ°ΡΠΎΠ² Π΄Π»Ρ Π·Π°ΠΆΠΈΠ²Π»Π΅Π½ΠΈΡ ΡΠ΅ΠΉΠΊΠΈ ΠΌΠΎΠΆΠ΅Ρ ΡΠ΅ΠΊΠΎΠΌΠ΅Π½Π΄ΠΎΠ²Π°ΡΡΡΡ ΠΈ Π΄Π»Ρ Π»Π΅ΡΠ΅Π½ΠΈΡ Π² Π΄ΠΎΠΌΠ°ΡΠ½ΠΈΡ ΡΡΠ»ΠΎΠ²ΠΈΡΡ .
ΠΠ΅ΠΊΠΎΡΠΎΡΡΠΌ ΠΏΠ°ΡΠΈΠ΅Π½ΡΠΊΠ°ΠΌ, ΠΎΡΠΎΠ±Π΅Π½Π½ΠΎ, Ρ ΡΠ°Ρ Π°ΡΠ½ΡΠΌ Π΄ΠΈΠ°Π±Π΅ΡΠΎΠΌ, ΡΠ΅Π³ΡΠ»ΡΡΠ½ΠΎ ΠΏΡΠΈΠ½ΠΈΠΌΠ°ΡΡΠΈΠΌ ΠΏΡΠ΅ΠΏΠ°ΡΠ°ΡΡ Π°Π½ΡΠΈΠΊΠΎΠ°Π³ΡΠ»ΡΠ½ΡΡ ΡΠ°ΡΡΠΎ ΡΡΠ΅Π±ΡΠ΅ΡΡΡ Π΄ΠΎΠΏΠΎΠ»Π½ΠΈΡΠ΅Π»ΡΠ½Π°Ρ ΠΌΠ΅Π΄ΠΈΠΊΠ°ΠΌΠ΅Π½ΡΠΎΠ·Π½Π°Ρ ΡΠ΅ΡΠ°ΠΏΠΈΡ. ΠΡΠΈΡΠΈΠ½Π° ΡΡΠΈΠ»Π΅Π½Π½ΠΎΠ³ΠΎ Π»Π΅ΡΠ΅Π½ΠΈΡ Π·Π°ΠΊΠ»ΡΡΠ°Π΅ΡΡΡ Π² ΠΏΠΎΠ²ΡΡΠ΅Π½Π½ΠΎΠΌ ΡΠΈΡΠΊΠ΅ ΠΊΡΠΎΠ²ΠΎΡΠ΅ΡΠ΅Π½ΠΈΡ Π΄Π°ΠΆΠ΅ ΠΏΡΠΈ ΠΏΡΠΎΠ²Π΅Π΄Π΅Π½ΠΈΠΈ ΠΌΠ°Π»ΠΎΠΈΠ½Π²Π°Π·ΠΈΠ²Π½ΠΎΠ³ΠΎ Π²ΠΌΠ΅ΡΠ°ΡΠ΅Π»ΡΡΡΠ²Π° β ΠΏΡΠΈΠΆΠΈΠ³Π°Π½ΠΈΡ. ΠΡΠΎΠΌΠ΅ ΡΠΎΠ³ΠΎ, Π½Π° ΡΠΎΠ½Π΅ ΡΠ½Π΄ΠΎΠΊΡΠΈΠ½Π½ΡΡ , ΡΠ΅ΡΠ΄Π΅ΡΠ½ΠΎ-ΡΠΎΡΡΠ΄ΠΈΡΡΡΡ Π·Π°Π±ΠΎΠ»Π΅Π²Π°Π½ΠΈΠΉ Π²ΠΎΡΡΡΠ°Π½ΠΎΠ²Π»Π΅Π½ΠΈΠ΅ ΡΠΊΠ°Π½Π΅ΠΉ ΠΌΠΎΠΆΠ΅Ρ Π·Π°ΠΌΠ΅Π΄Π»ΡΡΡΡΡ.
ΠΡΠΈ ΡΠ΅ΡΠΈΠ΄ΠΈΠ²ΠΈΡΡΡΡΠ΅ΠΉ ΡΡΠΎΠ·ΠΈΠΈ ΠΌΠΎΠ³ΡΡ Π±ΡΡΡ Π½Π°Π·Π½Π°ΡΠ΅Π½Ρ ΠΏΡΠ΅ΠΏΠ°ΡΠ°ΡΡ Π΄Π»Ρ ΡΡΠΈΠΌΡΠ»ΡΡΠΈΠΈ Π΅ΡΡΠ΅ΡΡΠ²Π΅Π½Π½ΡΡ Π·Π°ΡΠΈΡΠ½ΡΡ ΡΠΈΠ» ΠΎΡΠ³Π°Π½ΠΈΠ·ΠΌΠ°, Π²ΠΈΡΠ°ΠΌΠΈΠ½Π½ΠΎ-ΠΌΠΈΠ½Π΅ΡΠ°Π»ΡΠ½ΡΠ΅ ΠΊΠΎΠΌΠΏΠ»Π΅ΠΊΡΡ, Π³ΠΎΡΠΌΠΎΠ½Π°Π»ΡΠ½Π°Ρ ΡΠ΅ΡΠ°ΠΏΠΈΡ.
ΠΠΎΡΠ»Π΅ Π²ΠΌΠ΅ΡΠ°ΡΠ΅Π»ΡΡΡΠ²Π° Π½Π° ΠΏΡΠΎΡΡΠΆΠ΅Π½ΠΈΠΈ ΠΎΠ΄Π½ΠΎΠ³ΠΎ ΠΌΠ΅Π½ΡΡΡΡΠ°Π»ΡΠ½ΠΎΠ³ΠΎ ΡΠΈΠΊΠ»Π°, Π½ΡΠΆΠ½ΠΎΠ³ΠΎ Π΄Π»Ρ ΡΠ΅Π³Π΅Π½Π΅ΡΠ°ΡΠΈΠΈ ΡΠΏΠΈΡΠ΅Π»ΠΈΡ, ΠΏΠΎΠΊΠ°Π·Π°Π½ ΠΏΠΎΠ»ΠΎΠ²ΠΎΠΉ ΠΏΠΎΠΊΠΎΠΉ.
ΠΠΊΡΠΈΠ²Π½Π°Ρ ΡΠΈΠ·ΠΈΡΠ΅ΡΠΊΠ°Ρ Π½Π°Π³ΡΡΠ·ΠΊΠ°, Π±Π°Π½Π½ΡΠ΅ ΠΏΡΠΎΡΠ΅Π΄ΡΡΡ, ΠΏΡΠΈΠ½ΡΡΠΈΠ΅ Π²Π°Π½Π½Ρ ΡΠ°ΠΊΠΆΠ΅ Π½Π΅ ΡΠ°Π·ΡΠ΅ΡΠ΅Π½Ρ. ΠΠΆΠ΅Π΄Π½Π΅Π²Π½Π°Ρ Π³ΠΈΠ³ΠΈΠ΅Π½Π° β ΡΠ΅ΠΏΠ»ΡΠΉ, Π½Π΅ Π³ΠΎΡΡΡΠΈΠΉ Π΄ΡΡ.
Π‘ΡΠΎΠΈΡ ΠΈΠ·Π±Π΅Π³Π°ΡΡ ΠΏΠ΅ΡΠ΅ΠΎΡ Π»Π°ΠΆΠ΄Π΅Π½ΠΈΠΉ, Β«ΠΏΡΠΎΡΡΡΠ΄Π°Β» ΡΠΏΠΎΡΠΎΠ±Π½Π° ΠΏΡΠΈΠ²Π΅ΡΡΠΈ ΠΊ ΡΠ½ΠΈΠΆΠ΅Π½ΠΈΡ ΠΈΠΌΠΌΡΠ½ΠΈΡΠ΅ΡΠ° ΠΈ Π°ΠΊΡΠΈΠ²ΠΈΠ·Π°ΡΠΈΠΈ Ρ ΡΠΎΠ½ΠΈΡΠ΅ΡΠΊΠΎΠΉ Π²ΠΈΡΡΡΠ½ΠΎΠΉ ΠΈΠ½ΡΠ΅ΠΊΡΠΈΠΈ, ΡΡΠΎ Π·Π°ΠΌΠ΅Π΄Π»ΠΈΡ ΠΏΡΠΎΡΠ΅ΡΡΡ Π»Π΅ΡΠ΅Π½ΠΈΡ.
ΠΠΎ Π²ΡΠ΅ΠΌΡ ΠΏΠ΅ΡΠ²ΠΎΠΉ ΠΌΠ΅Π½ΡΡΡΡΠ°ΡΠΈΠΈ, ΠΏΠΎΡΠ»Π΅ ΠΏΡΠΈΠΆΠΈΠ³Π°Π½ΠΈΡ, Π½Π΅ ΡΠ°Π·ΡΠ΅ΡΠ°Π΅ΡΡΡ ΠΈΡΠΏΠΎΠ»ΡΠ·ΠΎΠ²Π°ΡΡ ΡΠ°ΠΌΠΏΠΎΠ½Ρ ΠΈΠ»ΠΈ ΠΌΠ΅Π½ΡΡΡΡΠ°Π»ΡΠ½ΡΠ΅ ΡΠ°ΡΠΈ.
ΠΠ΅ ΡΠ΅ΠΊΠΎΠΌΠ΅Π½Π΄ΡΠ΅ΡΡΡ ΠΏΠ»Π°Π½ΠΈΡΠΎΠ²Π°ΡΡ Π² ΠΏΠ΅ΡΠ²ΡΠΉ ΠΌΠ΅ΡΡΡ ΠΏΠΎΡΠ»Π΅ Π»Π΅ΡΠ΅Π½ΠΈΡ ΠΏΠΎΠ΅Π·Π΄ΠΊΠΈ Π½Π° ΠΌΠΎΡΠ΅, ΠΈΠ΄ΡΠΈ ΠΏΠ»Π°Π²Π°ΡΡ Π² Π±Π°ΡΡΠ΅ΠΉΠ½. ΠΡΡΡΠ΅ Π΄Π°ΡΡ Π²ΠΎΠ·ΠΌΠΎΠΆΠ½ΠΎΡΡΡ ΡΠΏΠΈΡΠ΅Π»ΠΈΡ ΡΠ΅ΠΉΠΊΠΈ ΠΏΠΎΠ»Π½ΠΎΡΡΡΡ Π²ΠΎΡΡΡΠ°Π½ΠΎΠ²ΠΈΡΡΡΡ, Π½Π΅ ΠΏΠΎΠ΄Π²Π΅ΡΠ³Π°ΡΡΡ ΡΠΈΡΠΊΡ Π²ΠΎΠ·Π΄Π΅ΠΉΡΡΠ²ΠΈΡ ΠΏΠ°ΡΠΎΠ³Π΅Π½ΠΎΠ², ΠΎΠ±ΠΈΡΠ°ΡΡΠΈΡ Π² Π²ΠΎΠ΄Π΅.
Π§ΡΠΎΠ±Ρ Π½Π΅ ΡΠΎΠ·Π΄Π°Π²Π°ΡΡ Π΄ΠΎΠΏΠΎΠ»Π½ΠΈΡΠ΅Π»ΡΠ½ΡΠ΅ ΠΏΠΎΠ²ΠΎΠ΄Ρ Π΄Π»Ρ ΡΡΡΠ΅ΡΡΠΎΠ², ΡΠ΅ΠΊΠΎΠΌΠ΅Π½Π΄ΡΠ΅ΡΡΡ ΠΏΡΠΈΠ΄Π΅ΡΠΆΠΈΠ²Π°ΡΡΡΡ ΡΠ±Π°Π»Π°Π½ΡΠΈΡΠΎΠ²Π°Π½Π½ΠΎΠΉ Π΄ΠΈΠ΅ΡΡ. ΠΠ½ΠΈΡΠ΅Π»ΡΠ½ΡΠ΅ ΠΏΠ°ΡΠΈΠ΅Π½ΡΠΊΠΈ Π½Π΅ ΡΠ΅Π΄ΠΊΠΎ ΠΏΡΠΈΠ½ΠΈΠΌΠ°ΡΡ Π±ΠΎΠ»ΠΈ Π² ΠΎΠ±Π»Π°ΡΡΠΈ ΠΊΠΈΡΠ΅ΡΠ½ΠΈΠΊΠ° Π·Π° ΠΎΡΠ»ΠΎΠΆΠ½Π΅Π½ΠΈΠ΅ Ρ ΠΈΡΡΡΠ³ΠΈΡΠ΅ΡΠΊΠΎΠ³ΠΎ Π»Π΅ΡΠ΅Π½ΠΈΡ Π² ΠΎΠ±Π»Π°ΡΡΠΈ ΠΏΠΎΠ»ΠΎΠ²ΡΡ ΠΎΡΠ³Π°Π½ΠΎΠ².
ΠΠΎΡΠ»Π΅ Π²ΠΎΡΡΡΠ°Π½ΠΎΠ²Π»Π΅Π½ΠΈΡ ΡΠ΅ΠΉΠΊΠΈ ΠΌΠ°ΡΠΊΠΈ ΠΏΠ°ΡΠΈΠ΅Π½ΡΠΊΠ°ΠΌ ΡΠ°Π·ΡΠ΅ΡΠ°Π΅ΡΡΡ Π²Π΅ΡΠ½ΡΡΡΡΡ ΠΊ ΠΏΡΠΈΠ²ΡΡΠ½ΠΎΠΌΡ ΡΠΈΡΠΌΡ ΠΆΠΈΠ·Π½ΠΈ.
ΠΡΠ΅ ΡΠ°Π· ΡΡΠΎΠΈΡ Π·Π°ΠΌΠ΅ΡΠΈΡΡ, ΡΡΠΎ Π² Π²ΠΎΠΏΡΠΎΡΠ°Ρ ΡΠΎΡ ΡΠ°Π½Π΅Π½ΠΈΡ ΡΠ΅ΠΏΡΠΎΠ΄ΡΠΊΡΠΈΠ²Π½ΠΎΠ³ΠΎ Π·Π΄ΠΎΡΠΎΠ²ΡΡ ΠΆΠ΅Π½ΡΠΈΠ½Π΅ Π²Π°ΠΆΠ½ΠΎ Π΄ΠΎΠ²Π΅ΡΡΡΡ Π»Π΅ΡΠ°ΡΠ΅ΠΌΡ Π³ΠΈΠ½Π΅ΠΊΠΎΠ»ΠΎΠ³Ρ, Π° Π½Π΅ ΡΠΎΠ²Π΅ΡΠΎΠ²Π°ΡΡΡΡ Ρ Β«ΠΏΠΎΠ΄ΡΡΠ³Π°ΠΌΠΈ ΠΏΠΎ Π½Π΅ΡΡΠ°ΡΡΡΡΒ» Π½Π° ΡΠ°Π·Π»ΠΈΡΠ½ΡΡ ΡΠΎΡΡΠΌΠ°Ρ . ΠΠ½ΠΎΠ³ΠΈΠ΅ ΠΌΠ΅ΡΠΎΠ΄Ρ, ΡΠ°ΠΊΠΈΠ΅ ΠΊΠ°ΠΊ Π²Π²Π΅Π΄Π΅Π½ΠΈΠ΅ ΡΠ°ΠΌΠΏΠΎΠ½ΠΎΠ², ΠΏΡΠΎΠΏΠΈΡΠ°Π½Π½ΡΡ ΠΌΠ°ΡΠ»ΠΎΠΌ ΡΠΈΠΏΠΎΠ²Π½ΠΈΠΊΠ°, ΠΎΠ±Π»Π΅ΠΏΠΈΡ ΠΈ ΠΏΡΠΈΠ·Π½Π°Π½Ρ ΡΡΡΠ°ΡΠ΅Π²ΡΠΈΠΌΠΈ Π½Π΅ ΡΠ»ΠΈΡΠΊΠΎΠΌ Π΄Π΅ΠΉΡΡΠ²Π΅Π½Π½ΡΠΌΠΈ. Π§ΡΠΎΠ±Ρ Π±ΡΡΡ ΡΠ²Π΅ΡΠ΅Π½Π½ΠΎΠΉ Π² Π½Π°Π·Π½Π°ΡΠ΅Π½ΠΈΡΡ Π²ΡΠ°ΡΠ° ΡΡΠΎΠΈΡ ΠΎΠ±ΡΠ°ΡΠ°ΡΡΡΡ ΡΠΎΠ»ΡΠΊΠΎ Π² ΠΏΡΠΎΠ²Π΅ΡΠ΅Π½Π½ΠΎΠ΅ ΠΌΠ΅Π΄ΠΈΡΠΈΠ½ΡΠΊΠΎΠ΅ ΡΡΡΠ΅ΠΆΠ΄Π΅Π½ΠΈΠ΅. ΠΠ»ΠΈΠ½ΠΈΠΊΠ° ΠΠ‘Π’ ΡΠΆΠ΅ 20 Π»Π΅Ρ ΡΠ°Π±ΠΎΡΠ°Π΅Ρ Π΄Π»Ρ ΡΠΎΠ³ΠΎ, ΡΡΠΎΠ±Ρ ΠΊΠ°ΠΆΠ΄Π°Ρ ΠΆΠ΅Π½ΡΠΈΠ½Π° ΡΡΠ²ΡΡΠ²ΠΎΠ²Π°Π»Π° ΡΠ΅Π±Ρ ΠΏΡΠ΅Π²ΠΎΡΡ ΠΎΠ΄Π½ΠΎ!
kst-clinic.ru
ΠΡΠ΄Π΅Π»Π΅Π½ΠΈΡ ΠΏΠΎΡΠ»Π΅ ΠΏΡΠΈΠΆΠΈΠ³Π°Π½ΠΈΡ ΡΡΠΎΠ·ΠΈΠΈ ΡΠ΅ΠΉΠΊΠΈ ΠΌΠ°ΡΠΊΠΈ: ΡΠΎΠ·ΠΎΠ²ΡΠ΅, ΠΆΠ΅Π»ΡΡΠ΅, Π±Π΅Π»ΡΠ΅, ΠΊΡΠΎΠ²ΡΠ½ΠΈΡΡΡΠ΅, ΠΊΠΎΡΠΈΡΠ½Π΅Π²ΡΠ΅
ΠΠ΅ΠΊΠΎΡΠΎΡΠΎΠ΅ ΠΊΠΎΠ»ΠΈΡΠ΅ΡΡΠ²ΠΎ Π²ΡΠ΄Π΅Π»Π΅Π½ΠΈΠΉ ΠΈΠ· Π²Π»Π°Π³Π°Π»ΠΈΡΠ° β Π΅ΡΡΠ΅ΡΡΠ²Π΅Π½Π½ΠΎΠ΅ ΡΠ²Π»Π΅Π½ΠΈΠ΅. ΠΡ ΠΊΠΎΠ½ΡΠΈΡΡΠ΅Π½ΡΠΈΡ, ΠΊΠΎΠ»ΠΈΡΠ΅ΡΡΠ²ΠΎ, Π·Π°ΠΏΠ°Ρ ΠΈ ΡΠ²Π΅Ρ ΡΠ²ΠΈΠ΄Π΅ΡΠ΅Π»ΡΡΡΠ²ΡΡΡ ΠΎ ΡΠΎΡΡΠΎΡΠ½ΠΈΠΈ ΡΠ΅ΠΏΡΠΎΠ΄ΡΠΊΡΠΈΠ²Π½ΠΎΠΉ ΡΠΈΡΡΠ΅ΠΌΡ ΠΈ ΠΎΠ±ΡΠ΅ΠΌ ΡΠΎΡΡΠΎΡΠ½ΠΈΠΈ Π·Π΄ΠΎΡΠΎΠ²ΡΡ ΠΆΠ΅Π½ΡΠΈΠ½Ρ.
ΠΠ·ΠΌΠ΅Π½Π΅Π½ΠΈΠ΅ Ρ Π°ΡΠ°ΠΊΡΠ΅ΡΠ° Π²ΡΠ΄Π΅Π»Π΅Π½ΠΈΠΉ Π±ΡΠ²Π°Π΅Ρ ΠΏΠ΅ΡΠ²ΡΠΌ ΠΈΠ»ΠΈ Π΄Π°ΠΆΠ΅ Π΅Π΄ΠΈΠ½ΡΡΠ²Π΅Π½Π½ΡΠΌ ΠΎΡΠ΅Π²ΠΈΠ΄Π½ΡΠΌ ΡΠΈΠΌΠΏΡΠΎΠΌΠΎΠΌ Π³ΠΈΠ½Π΅ΠΊΠΎΠ»ΠΎΠ³ΠΈΡΠ΅ΡΠΊΠΈΡ Π·Π°Π±ΠΎΠ»Π΅Π²Π°Π½ΠΈΠΉ.
Π Π°ΡΡΠΌΠΎΡΡΠΈΠΌ ΡΠ°ΠΊΠΈΠ΅ ΠΏΠΎΡΠ»Π΅Π΄ΡΡΠ²ΠΈΡ ΠΏΠΎΡΠ»Π΅ ΠΏΡΠΈΠΆΠΈΠ³Π°Π½ΠΈΡ ΡΡΠΎΠ·ΠΈΠΈ ΡΠ΅ΠΉΠΊΠΈ ΠΌΠ°ΡΠΊΠΈ, ΠΊΠ°ΠΊ Π²ΡΠ΄Π΅Π»Π΅Π½ΠΈΡ (ΠΆΠ΅Π»ΡΡΠ΅, Π±Π΅Π»ΡΠ΅, ΠΊΡΠΎΠ²ΡΠ½ΠΈΡΡΡΠ΅ ΠΈ Ρ. Π΄.), Π±ΠΎΠ»ΠΈ Π²Π½ΠΈΠ·Ρ ΠΆΠΈΠ²ΠΎΡΠ°, Π΄ΡΡΠ³ΠΈΠ΅ ΡΠΈΠΌΠΏΡΠΎΠΌΡ.
ΠΡΠΎΠ±Π΅Π½Π½ΠΎΡΡΠΈ Π»Π΅ΡΠ΅Π½ΠΈΡ Π·Π°Π±ΠΎΠ»Π΅Π²Π°Π½ΠΈΡ
ΠΡΠΎΠ·ΠΈΡ ΡΠ΅ΠΉΠΊΠΈ ΠΌΠ°ΡΠΊΠΈ ΠΌΠΎΠΆΠ΅Ρ Π³ΠΎΠ΄Π°ΠΌΠΈ ΠΏΡΠΎΡΠ΅ΠΊΠ°ΡΡ Π±Π΅ΡΡΠΈΠΌΠΏΡΠΎΠΌΠ½ΠΎ ΠΈ ΡΠ°ΡΡΠΎ Π²ΡΡΠ²Π»ΡΠ΅ΡΡΡ ΡΠ»ΡΡΠ°ΠΉΠ½ΠΎ, ΠΏΡΠΈ ΠΎΠ±ΡΠ°ΡΠ΅Π½ΠΈΠΈ ΠΏΠΎ Π΄ΡΡΠ³ΠΎΠΌΡ ΠΏΠΎΠ²ΠΎΠ΄Ρ ΠΈΠ»ΠΈ Π²ΠΎ Π²ΡΠ΅ΠΌΡ ΠΏΡΠΎΡΠΈΠ»Π°ΠΊΡΠΈΡΠ΅ΡΠΊΠΎΠ³ΠΎ ΠΎΡΠΌΠΎΡΡΠ°.
Π‘ΡΡΠ΅ΡΡΠ²ΡΠ΅Ρ Π½Π΅ΡΠΊΠΎΠ»ΡΠΊΠΎ ΠΌΠ΅ΡΠΎΠ΄ΠΎΠ² Π»Π΅ΡΠ΅Π½ΠΈΡ ΠΠ¨Π β ΠΎΡ ΠΊΠΎΠ½ΡΠ΅ΡΠ²Π°ΡΠΈΠ²Π½ΠΎΠΉ ΡΠ΅ΡΠ°ΠΏΠΈΠΈ ΠΈ Π΄ΠΎ ΡΠ°Π΄ΠΈΠΊΠ°Π»ΡΠ½ΠΎΠ³ΠΎ Ρ ΠΈΡΡΡΠ³ΠΈΡΠ΅ΡΠΊΠΎΠ³ΠΎ Π²ΠΌΠ΅ΡΠ°ΡΠ΅Π»ΡΡΡΠ²Π°.Π§Π°ΡΠ΅ Π²ΡΠ΅Π³ΠΎ ΠΏΡΠΈΠΌΠ΅Π½ΡΡΡΡΡ ΠΌΠ΅ΡΠΎΠ΄Ρ Π½Π΅ΠΏΠΎΡΡΠ΅Π΄ΡΡΠ²Π΅Π½Π½ΠΎΠ³ΠΎ ΡΠΈΠ·ΠΈΡΠ΅ΡΠΊΠΎΠ³ΠΎ Π²ΠΎΠ·Π΄Π΅ΠΉΡΡΠ²ΠΈΡ, ΡΠ°Π·ΡΡΡΠ°ΡΡΠ΅Π³ΠΎ ΡΡΠ°ΡΡΠΎΠΊ ΡΡΠΎΠ·ΠΈΠΈ.
ΠΠΎΡΠ»Π΅ Π»Π΅ΡΠ΅Π½ΠΈΡ Π½ΡΠΆΠ½ΠΎ ΠΏΠΎΠ±Π΅ΡΠ΅ΡΡ ΡΠ΅Π±Ρ, ΡΡΠΎΠ±Ρ Π½Π΅ Π·Π°Π½Π΅ΡΡΠΈ Π² ΠΎΠ±ΡΠ°Π±ΠΎΡΠ°Π½Π½ΡΡ Π·ΠΎΠ½Ρ ΠΈΠ½ΡΠ΅ΠΊΡΠΈΡ ΠΈ Π½Π΅ ΡΡΠ°Π²ΠΌΠΈΡΠΎΠ²Π°ΡΡ ΡΠ΅ΠΉΠΊΡ ΠΌΠ°ΡΠΊΠΈ. ΠΡΠΆΠ½ΠΎ ΠΈΠ·Π±Π΅ΠΆΠ°ΡΡ ΡΠ΅ΡΠΈΠ΄ΠΈΠ²Π° ΡΡΠΎΠ·ΠΈΠΈ ΠΈ Π΄ΡΡΠ³ΠΈΡ
Π²ΠΎΠ·ΠΌΠΎΠΆΠ½ΡΡ
ΠΎΡΠ»ΠΎΠΆΠ½Π΅Π½ΠΈΠΉ.
ΠΡΠΈ ΡΠ°Π·ΡΡΡΠ΅Π½ΠΈΠΈ ΡΡΠ°ΡΡΠΊΠ° ΡΠΊΡΠΎΠΏΠΈΡΠ΅ΡΠΊΠΎΠ³ΠΎ ΡΠΏΠΈΡΠ΅Π»ΠΈΡ Π½Π° Π΅Π³ΠΎ ΠΌΠ΅ΡΡΠ΅ ΠΎΠ±ΡΠ°Π·ΡΠ΅ΡΡΡ ΡΠ°Π½ΠΊΠ°, ΠΏΠΎΠΊΡΡΡΠ°Ρ ΡΡΡΡΠΏΠΎΠΌ. ΠΠΎ ΠΌΠ΅ΡΠ΅ Π²ΠΎΡΡΡΠ°Π½ΠΎΠ²Π»Π΅Π½ΠΈΡ Π½ΠΎΡΠΌΠ°Π»ΡΠ½ΠΎΠ³ΠΎ ΡΠΏΠΈΡΠ΅Π»ΠΈΡ ΡΡΡΡΠΏ ΠΎΡΡΠ»Π°ΠΈΠ²Π°Π΅ΡΡΡ, ΠΎΡΠΏΠ°Π΄Π°Π΅Ρ ΠΈ Π²ΡΠ²ΠΎΠ΄ΠΈΡΡΡ Π½Π°ΡΡΠΆΡ.
ΠΡΠΎΠ΄ΠΎΠ»ΠΆΠΈΡΠ΅Π»ΡΠ½ΠΎΡΡΡ ΠΏΠ΅ΡΠΈΠΎΠ΄Π° Π²ΠΎΡΡΡΠ°Π½ΠΎΠ²Π»Π΅Π½ΠΈΡ Π·Π°Π²ΠΈΡΠΈΡ ΠΎΡ ΡΠΏΠΎΡΠΎΠ±Π° ΠΏΡΠΈΠΆΠΈΠ³Π°Π½ΠΈΡ ΡΡΠΎΠ·ΠΈΠΈ, ΠΏΠ»ΠΎΡΠ°Π΄ΠΈ ΠΏΠΎΠ²ΡΠ΅ΠΆΠ΄Π΅Π½ΠΈΡ, ΠΎΠ±ΡΠ΅Π³ΠΎ ΡΠΎΡΡΠΎΡΠ½ΠΈΡ Π·Π΄ΠΎΡΠΎΠ²ΡΡ ΠΆΠ΅Π½ΡΠΈΠ½Ρ ΠΈ Π½Π΅ΠΊΠΎΡΠΎΡΡΡ Π΄ΡΡΠ³ΠΈΡ ΡΠ°ΠΊΡΠΎΡΠΎΠ².
ΠΠ΅ΡΠ΅Π½ΠΈΠ΅ ΠΌΠ΅ΡΠΎΠ΄ΠΎΠΌ Π΄ΠΈΠ°ΡΠ΅ΡΠΌΠΎΠΊΠΎΠ°Π³ΡΠ»ΡΡΠΈΠΈ (ΠΏΡΠΈΠΆΠΈΠ³Π°Π½ΠΈΠ΅ ΡΠ»Π΅ΠΊΡΡΠΈΡΠ΅ΡΠΊΠΈΠΌ ΡΠΎΠΊΠΎΠΌ) β ΠΎΠ΄ΠΈΠ½ ΠΈΠ· ΡΠ°ΠΌΡΡ ΡΡΠ°Π²ΠΌΠ°ΡΠΈΡΠ½ΡΡ ΠΌΠ΅ΡΠΎΠ΄ΠΎΠ² ΡΡΡΡΠ°Π½Π΅Π½ΠΈΡ ΠΠ¨Π.
ΠΠΎΠ·Π΄Π΅ΠΉΡΡΠ²ΠΈΠ΅ ΡΠΎΠΊΠ° Π·Π°Ρ Π²Π°ΡΡΠ²Π°Π΅Ρ ΠΎΠ±Π»Π°ΡΡΡ ΠΏΠΎΡΠ°ΠΆΠ΅Π½ΠΈΡ, ΠΏΡΠΈΠ»Π΅Π³Π°ΡΡΠΈΠ΅ ΠΊ Π½Π΅ΠΉ Π·Π΄ΠΎΡΠΎΠ²ΡΠ΅ ΡΠΊΠ°Π½ΠΈ. ΠΡΠ°ΡΡ ΡΠ»ΠΎΠΆΠ½ΠΎ ΠΏΡΠΎΠΊΠΎΠ½ΡΡΠΎΠ»ΠΈΡΠΎΠ²Π°ΡΡ Π³Π»ΡΠ±ΠΈΠ½Ρ Π²ΠΎΠ·Π΄Π΅ΠΉΡΡΠ²ΠΈΡ.
ΠΠΎΡΡΠΎΠΌΡ ΠΏΠΎΡΠ»Π΅ Π΄ΠΈΠ°ΡΠ΅ΡΠΌΠΎΠΊΠΎΠ°Π³ΡΠ»ΡΡΠΈΠΈ ΡΠ°ΡΡΠΎ ΠΎΠ±ΡΠ°Π·ΡΡΡΡΡ ΡΡΠ±ΡΡ, ΡΠ»Π°ΡΡΠΈΡΠ½ΠΎΡΡΡ ΡΠ΅ΠΉΠΊΠΈ ΠΌΠ°ΡΠΊΠΈ ΡΠΌΠ΅Π½ΡΡΠ°Π΅ΡΡΡ. ΠΡΡΡ Π²Π΅ΡΠΎΡΡΠ½ΠΎΡΡΡ ΡΡΠΆΠ΅Π½ΠΈΡ ΡΠ΅ΡΠ²ΠΈΠΊΠ°Π»ΡΠ½ΠΎΠ³ΠΎ ΠΊΠ°Π½Π°Π»Π°, ΠΈΠ·ΡΠ΅Π΄ΠΊΠ° Π±ΡΠ²Π°ΡΡ ΡΠ»ΡΡΠ°ΠΈ Π·Π°ΡΠ°ΡΠ΅Π½ΠΈΡ Π²ΡΡ ΠΎΠ΄Π½ΠΎΠ³ΠΎ ΠΎΡΠ²Π΅ΡΡΡΠΈΡ.
ΠΡΠΈ Ρ ΠΈΠΌΠΈΠΎΡΠΈΠΊΡΠ°ΡΠΈΠΈ (ΠΏΡΠΈΠΆΠΈΠ³Π°Π½ΠΈΠ΅ ΡΠ°ΡΡΠ²ΠΎΡΠΎΠΌ ΠΊΠΈΡΠ»ΠΎΡ) ΠΈ ΠΊΡΠΈΠΎΠ΄Π΅ΡΡΡΡΠΊΡΠΈΠΈ (Π·Π°ΠΌΠΎΡΠ°ΠΆΠΈΠ²Π°Π½ΠΈΠ΅) Π³Π»ΡΠ±ΠΈΠ½Π° Π²ΠΎΠ·Π΄Π΅ΠΉΡΡΠ²ΠΈΡ Π·Π½Π°ΡΠΈΡΠ΅Π»ΡΠ½ΠΎ ΠΌΠ΅Π½ΡΡΠ΅, ΡΠΈΡΠΊ ΠΎΠ±ΡΠ°Π·ΠΎΠ²Π°Π½ΠΈΡ ΡΡΠ±ΡΠ° Π½Π° ΠΌΠ΅ΡΡΠ΅ ΡΡΠΎΠ·ΠΈΠΈ Π³ΠΎΡΠ°Π·Π΄ΠΎ Π½ΠΈΠΆΠ΅.
ΠΡΠΈ Π²ΡΠ±ΠΎΡΠ΅ ΠΎΠ΄Π½ΠΎΠ³ΠΎ ΠΈΠ· ΡΡΠΈΡ ΠΌΠ΅ΡΠΎΠ΄ΠΎΠ² Π»Π΅ΡΠ΅Π½ΠΈΡ Π΄Π»Ρ ΠΏΠΎΠ»Π½ΠΎΠ³ΠΎ ΡΡΡΡΠ°Π½Π΅Π½ΠΈΡ Π΄Π΅ΡΠ΅ΠΊΡΠ° ΠΈΠ½ΠΎΠ³Π΄Π° ΡΡΠ΅Π±ΡΠ΅ΡΡΡ Π½Π΅ΡΠΊΠΎΠ»ΡΠΊΠΎ ΠΏΡΠΎΡΠ΅Π΄ΡΡ.
ΠΠ°Π·Π΅ΡΠ½Π°Ρ Π΄Π΅ΡΡΡΡΠΊΡΠΈΡ ΠΈ ΡΠ°Π΄ΠΈΠΎΠ²ΠΎΠ»Π½ΠΎΠ²Π°Ρ ΠΊΠΎΠ°Π³ΡΠ»ΡΡΠΈΡ ΠΠ¨Π β ΡΠ°ΠΌΡΠ΅ ΡΠ°Π΄ΡΡΠΈΠ΅ ΠΌΠ΅ΡΠΎΠ΄Ρ Π»Π΅ΡΠ΅Π½ΠΈΡ ΠΠ¨Π. ΠΠΎΠ²ΡΠ΅ΠΆΠ΄Π΅Π½ΠΈΠ΅ Π·Π΄ΠΎΡΠΎΠ²ΠΎΠΉ ΡΠΊΠ°Π½ΠΈ ΠΏΡΠ°ΠΊΡΠΈΡΠ΅ΡΠΊΠΈ ΠΈΡΠΊΠ»ΡΡΠ΅Π½ΠΎ, ΡΠ°Π½ΠΊΠ° Π·Π°ΠΆΠΈΠ²Π°Π΅Ρ Π±ΡΡΡΡΠΎ, Π±Π΅Π· ΠΎΠ±ΡΠ°Π·ΠΎΠ²Π°Π½ΠΈΡ ΡΡΠ±ΡΠ°.
ΠΠ΅Π·Π°Π²ΠΈΡΠΈΠΌΠΎ ΠΎΡ ΠΌΠ΅ΡΠΎΠ΄Π° Π²ΠΎΠ·Π΄Π΅ΠΉΡΡΠ²ΠΈΡ Π½Π° ΡΡΠ°ΡΡΠΎΠΊ ΡΡΠΎΠ·ΠΈΠΈ ΠΏΠΎΡΠ»Π΅ Π»Π΅ΡΠ΅Π½ΠΈΡ Ρ Π°ΡΠ°ΠΊΡΠ΅Ρ ΠΈ ΠΊΠΎΠ»ΠΈΡΠ΅ΡΡΠ²ΠΎ Π²ΡΠ΄Π΅Π»Π΅Π½ΠΈΠΉ ΠΈΠ· Π²Π»Π°Π³Π°Π»ΠΈΡΠ° ΠΌΠ΅Π½ΡΡΡΡΡ.
ΠΠ°ΠΆΠ½ΠΎ Π·Π½Π°ΡΡ ΡΠ°Π·Π»ΠΈΡΠΈΡ ΠΌΠ΅ΠΆΠ΄Ρ Π½ΠΎΡΠΌΠ°Π»ΡΠ½ΡΠΌΠΈ ΠΈ ΠΏΠ°ΡΠΎΠ»ΠΎΠ³ΠΈΡΠ΅ΡΠΊΠΈΠΌΠΈ Π²ΡΠ΄Π΅Π»Π΅Π½ΠΈΡΠΌΠΈ Π² ΠΏΠ΅ΡΠΈΠΎΠ΄ Π²ΠΎΡΡΡΠ°Π½ΠΎΠ²Π»Π΅Π½ΠΈΡ, ΡΡΠΎΠ±Ρ Π²ΠΎΠ²ΡΠ΅ΠΌΡ Π·Π°ΠΌΠ΅ΡΠΈΡΡ ΡΠ°Π½Π½ΠΈΠ΅ ΠΏΡΠΈΠ·Π½Π°ΠΊΠΈ ΠΎΡΠ»ΠΎΠΆΠ½Π΅Π½ΠΈΠΉ ΠΈ ΠΎΠ±ΡΠ°ΡΠΈΡΡΡΡ ΠΊ Π²ΡΠ°ΡΡ.
ΠΊ ΠΎΠ³Π»Π°Π²Π»Π΅Π½ΠΈΡ βΠ§ΡΠΎ ΡΡΠΈΡΠ°ΡΡ Π½ΠΎΡΠΌΠΎΠΉ Π² Π²ΠΎΡΡΡΠ°Π½ΠΎΠ²ΠΈΡΠ΅Π»ΡΠ½ΡΠΉ ΠΏΠ΅ΡΠΈΠΎΠ΄
ΠΠ°ΠΆΠΈΠ²Π»Π΅Π½ΠΈΠ΅ ΡΠ°Π½ΠΊΠΈ, ΠΎΠ±ΡΠ°Π·ΠΎΠ²Π°Π²ΡΠ΅ΠΉΡΡ ΠΏΠΎΡΠ»Π΅ ΠΏΡΠΈΠΆΠΈΠ³Π°Π½ΠΈΡ ΠΠ¨Π, Π² ΡΡΠ΅Π΄Π½Π΅ΠΌ Π΄Π»ΠΈΡΡΡ 2-3 Π½Π΅Π΄Π΅Π»ΠΈ.
Π‘ΠΊΠΎΠ»ΡΠΊΠΎ ΠΎΠ½ΠΈ Π΄Π»ΡΡΡΡ ΠΈ ΠΊΠ°ΠΊΠΈΠ΅ Π²ΡΠ΄Π΅Π»Π΅Π½ΠΈΡ ΠΏΠΎΡΠ»Π΅ ΠΏΡΠΈΠΆΠΈΠ³Π°Π½ΠΈΡ ΡΡΠΎΠ·ΠΈΠΈ ΡΠ΅ΠΉΠΊΠΈ ΠΌΠ°ΡΠΊΠΈ Π² ΡΠ΅ΡΠ΅Π½ΠΈΠ΅ Π²ΠΎΡΡΡΠ°Π½ΠΎΠ²ΠΈΡΠ΅Π»ΡΠ½ΠΎΠ³ΠΎ ΠΏΠ΅ΡΠΈΠΎΠ΄Π° ΡΡΠΈΡΠ°ΡΡΡΡ Π½ΠΎΡΠΌΠΎΠΉ:
- Π²ΠΎΠ΄ΡΠ½ΠΈΡΡΡΠ΅, Π±Π΅Π»ΡΠ΅, ΠΏΡΠΎΠ·ΡΠ°ΡΠ½ΡΠ΅ ΡΠ»Π°Π±ΡΠ΅, ΠΈΠ½ΠΎΠ³Π΄Π° Ρ ΠΏΡΠΈΠΌΠ΅ΡΡΠΌΠΈ ΠΊΡΠΎΠ²ΡΠ½ΡΡ ΡΠ³ΡΡΡΠΊΠΎΠ². ΠΠΎΡΠ²Π»ΡΡΡΡΡ Π² ΡΠ΅ΡΠ΅Π½ΠΈΠ΅ ΠΏΠ΅ΡΠ²ΡΡ 10 Π΄Π½Π΅ΠΉ ΠΏΠΎΡΠ»Π΅ ΠΏΡΠΎΡΠ΅Π΄ΡΡΡ. ΠΠ½ΡΠ΅Π½ΡΠΈΠ²Π½ΠΎΡΡΡ Π²ΡΠ΄Π΅Π»Π΅Π½ΠΈΡ Π²Π»Π°Π³Π°Π»ΠΈΡΠ½ΠΎΠ³ΠΎ ΡΠ΅ΠΊΡΠ΅ΡΠ° Π²ΠΎΠ·ΡΠ°ΡΡΠ°Π΅Ρ, ΠΊΠΎΠ½ΡΠΈΡΡΠ΅Π½ΡΠΈΡ ΡΡΠ°Π½ΠΎΠ²ΠΈΡΡΡ Π±ΠΎΠ»Π΅Π΅ Π²ΡΠ·ΠΊΠΎΠΉ;
- Π³ΡΡΡΡΠ΅ ΡΠΎΠ·ΠΎΠ²ΡΠ΅ ΠΈΠ»ΠΈ ΠΊΡΠ°ΡΠ½ΡΠ΅, ΠΊΡΠΎΠ²ΡΠ½ΠΈΡΡΡΠ΅. ΠΠ°Π±Π»ΡΠ΄Π°ΡΡΡΡ Π² ΡΠ΅ΡΠ΅Π½ΠΈΠ΅ 10-14 Π΄Π½Π΅ΠΉ. ΠΡ ΠΈΠ½ΡΠ΅Π½ΡΠΈΠ²Π½ΠΎΡΡΡ ΠΈ Π³ΡΡΡΠΎΡΠ° ΠΏΠΎΡΡΠ΅ΠΏΠ΅Π½Π½ΠΎ ΡΠ²Π΅Π»ΠΈΡΠΈΠ²Π°Π΅ΡΡΡ, ΠΏΠΎΡΠ»Π΅ Π·Π°ΠΆΠΈΠ²Π»Π΅Π½ΠΈΡ ΡΡΠ°ΡΡΠΊΠ° Π²ΠΎΠ·Π΄Π΅ΠΉΡΡΠ²ΠΈΡ ΠΏΡΠ΅ΠΊΡΠ°ΡΠ°ΡΡΡΡ;
- ΠΊΠΎΡΠΈΡΠ½Π΅Π²ΡΠ΅, ΡΠ°ΠΊ Π½Π°Π·ΡΠ²Π°Π΅ΠΌΠ°Ρ ΠΌΠ°Π·Π½Ρ. ΠΠ½ΠΈ ΡΠΊΡΠ΄Π½ΡΠ΅, Π³ΡΡΡΡΠ΅, ΠΈΡΡΠ΅Π·Π°ΡΡ ΡΠ΅ΡΠ΅Π· 7-10 Π΄Π½Π΅ΠΉ.
Π Π΅Π·ΠΊΠΎ Π²ΡΡΠ°ΠΆΠ΅Π½Π½ΠΎΠ³ΠΎ ΠΈΠ»ΠΈ Π½Π΅ΠΏΡΠΈΡΡΠ½ΠΎΠ³ΠΎ Π·Π°ΠΏΠ°Ρ Π° Π½ΠΎΡΠΌΠ°Π»ΡΠ½ΡΠ΅ Π²ΡΠ΄Π΅Π»Π΅Π½ΠΈΡ Π½Π΅ ΠΈΠΌΠ΅ΡΡ. ΠΠΎΠ·ΠΌΠΎΠΆΠ½Ρ Π΄ΠΈΡΠΊΠΎΠΌΡΠΎΡΡ ΠΈΠ»ΠΈ ΡΠ»Π°Π±Π°Ρ Π±ΠΎΠ»Ρ ΠΏΠΎ Π½ΠΈΠ·Ρ ΠΆΠΈΠ²ΠΎΡΠ°, Π½Π΅ ΠΏΡΠΈΡΠΈΠ½ΡΡΡΠΈΠ΅ Π±Π΅ΡΠΏΠΎΠΊΠΎΠΉΡΡΠ²Π°.
Π‘ΡΡΡΠΏ ΠΏΠΎΡΡΠ΅ΠΏΠ΅Π½Π½ΠΎ ΡΠ»ΡΡΠΈΠ²Π°Π΅ΡΡΡ, Π΅Π³ΠΎ ΡΡΠ°Π³ΠΌΠ΅Π½ΡΡ Π²ΡΠ²ΠΎΠ΄ΡΡΡΡ Π²ΠΌΠ΅ΡΡΠ΅ Ρ Π²ΡΠ΄Π΅Π»Π΅Π½ΠΈΡΠΌΠΈ. ΠΠΎΡΠ»Π΅ Π»Π΅ΡΠ΅Π½ΠΈΡ Π±ΠΎΠ»ΡΡΠΎΠΉ ΡΡΠΎΠ·ΠΈΠΈ, ΠΏΠΎΡΠ»Π΅ ΠΏΠΎΠ»Π½ΠΎΠ³ΠΎ ΠΎΡΠΏΠ°Π΄Π΅Π½ΠΈΡ ΡΡΡΡΠΏΠ° (ΡΠ΅ΡΠ΅Π· 2-3 Π½Π΅Π΄Π΅Π»ΠΈ ΠΏΡΠΎΡΠ΅Π΄ΡΡΡ ΠΏΡΠΈΠΆΠΈΠ³Π°Π½ΠΈΡ) Π²ΠΎΠ·ΠΌΠΎΠΆΠ½ΠΎ ΠΏΠΎΡΠ²Π»Π΅Π½ΠΈΠ΅ ΠΊΡΠΎΠ²ΡΠ½ΠΈΡΡΡΡ ΡΠ³ΡΡΡΠΊΠΎΠ².
ΠΠ±ΡΡΠ½ΠΎ Π² ΡΠ΅ΡΠ΅Π½ΠΈΠ΅ 1,5-2 ΡΠ°ΡΠΎΠ² ΠΎΠ½ΠΎ ΡΠ°ΠΌΠΎΠΏΡΠΎΠΈΠ·Π²ΠΎΠ»ΡΠ½ΠΎ ΠΏΡΠ΅ΠΊΡΠ°ΡΠ°Π΅ΡΡΡ. ΠΡΠ»ΠΈ ΡΡΠΎΠ³ΠΎ Π½Π΅ ΠΏΡΠΎΠΈΠ·ΠΎΡΠ»ΠΎ, Π½ΡΠΆΠ½ΠΎ Π±Π΅Π·ΠΎΡΠ»Π°Π³Π°ΡΠ΅Π»ΡΠ½ΠΎ ΠΎΠ±ΡΠ°ΡΠΈΡΡΡΡ ΠΊ Π²ΡΠ°ΡΡ.
ΠΠΎΡΠ»Π΅ ΠΎΠΊΠΎΠ½ΡΠ°ΡΠ΅Π»ΡΠ½ΠΎΠ³ΠΎ Π·Π°ΠΆΠΈΠ²Π»Π΅Π½ΠΈΡ ΡΠ°Π½ΠΊΠΈ Π² ΠΌΠ΅ΡΡΠ΅ ΡΡΠΎΠ·ΠΈΠΈ Π²ΡΠ΄Π΅Π»Π΅Π½ΠΈΡ Π²ΠΎΠ·Π²ΡΠ°ΡΠ°ΡΡΡΡ ΠΊ ΡΠΈΠ·ΠΈΠΎΠ»ΠΎΠ³ΠΈΡΠ΅ΡΠΊΠΎΠΉ Π½ΠΎΡΠΌΠ΅ ΠΈ ΡΠΎΠΎΡΠ²Π΅ΡΡΡΠ²ΡΡΡ ΡΠ°Π·Π°ΠΌ ΠΌΠ΅Π½ΡΡΡΡΠ°Π»ΡΠ½ΠΎΠ³ΠΎ ΡΠΈΠΊΠ»Π°.
ΠΡΠ΅Π½Ρ ΠΎΠΏΠ°ΡΠ½ΡΠΉ ΡΠΈΠ³Π½Π°Π» β ΡΠ»Π°Π±ΠΎΡΡΡ, ΠΏΠΎΠ²ΡΡΠ΅Π½ΠΈΠ΅ ΡΠ΅ΠΌΠΏΠ΅ΡΠ°ΡΡΡΡ, Π³ΠΎΠ»ΠΎΠ²ΠΎΠΊΡΡΠΆΠ΅Π½ΠΈΠ΅. ΠΡΠΎΠ²ΠΎΡΠ΅ΡΠ΅Π½ΠΈΠ΅, ΡΠΎΠΏΡΠΎΠ²ΠΎΠΆΠ΄Π°ΡΡΠ΅Π΅ΡΡ ΠΏΠΎΠ΄ΠΎΠ±Π½ΡΠΌΠΈ ΡΠΈΠΌΠΏΡΠΎΠΌΠ°ΠΌΠΈ, ΠΏΠΎΡΠ΅Π½ΡΠΈΠ°Π»ΡΠ½ΠΎ ΠΎΠΏΠ°ΡΠ½ΠΎ, Π½Π΅ΠΎΠ±Ρ ΠΎΠ΄ΠΈΠΌΠΎ Π²ΡΠ·ΡΠ²Π°ΡΡ Β«Π‘ΠΊΠΎΡΡΡ ΠΏΠΎΠΌΠΎΡΡΒ».
ΠΠ΅ΡΠ΅Π΄ Π»Π΅ΡΠ΅Π½ΠΈΠ΅ΠΌ Π³ΠΈΠ½Π΅ΠΊΠΎΠ»ΠΎΠ³ ΠΎΠ±ΡΠ·Π°ΡΠ΅Π»ΡΠ½ΠΎ Π΄ΠΎΠ»ΠΆΠ΅Π½ ΠΎΠ±ΡΡΡΠ½ΠΈΡΡ ΠΆΠ΅Π½ΡΠΈΠ½Π΅, ΠΊΠ°ΠΊ Π² Π½ΠΎΡΠΌΠ΅ ΠΏΡΠΎΡΠ΅ΠΊΠ°Π΅Ρ Π²ΠΎΡΡΡΠ°Π½ΠΎΠ²ΠΈΡΠ΅Π»ΡΠ½ΡΠΉ ΠΏΠ΅ΡΠΈΠΎΠ΄, ΠΊΠ°ΠΊΠΈΠ΅ ΠΌΠΎΠ³ΡΡ Π±ΡΡΡ ΠΎΡΠ»ΠΎΠΆΠ½Π΅Π½ΠΈΡ, ΡΡΠΎ Π΄Π΅Π»Π°ΡΡ, Π΅ΡΠ»ΠΈ ΡΡΠΎ-ΡΠΎ ΠΏΠΎΡΠ»ΠΎ Π½Π΅ ΡΠ°ΠΊ.
ΠΊ ΠΎΠ³Π»Π°Π²Π»Π΅Π½ΠΈΡ βΠΠΎΠ³Π΄Π° Π½ΡΠΆΠ½ΠΎ ΠΎΠ±ΡΠ°ΡΠ°ΡΡΡΡ ΠΊ Π²ΡΠ°ΡΡ: Π²ΡΠ΄Π΅Π»Π΅Π½ΠΈΡ, ΠΊΠΎΡΠΎΡΡΠ΅ Π½Π°ΡΡΠΎΡΠ°ΠΆΠΈΠ²Π°ΡΡ
Π Π²ΠΎΠ·ΠΌΠΎΠΆΠ½ΡΡ ΠΎΡΠ»ΠΎΠΆΠ½Π΅Π½ΠΈΡΡ ΠΏΠΎΡΠ»Π΅ Π»Π΅ΡΠ΅Π½ΠΈΡ ΠΠ¨Π ΡΠ²ΠΈΠ΄Π΅ΡΠ΅Π»ΡΡΡΠ²ΡΡΡ ΠΎΠ±ΠΈΠ»ΡΠ½ΡΠ΅ ΠΆΠ΅Π»ΡΡΠ΅, Π·Π΅Π»Π΅Π½ΠΎΠ²Π°ΡΡΠ΅ ΠΈΠ»ΠΈ ΠΊΠΎΡΠΈΡΠ½Π΅Π²ΡΠ΅ Π²ΡΠ΄Π΅Π»Π΅Π½ΠΈΡ.
Π ΡΠ°ΠΊΠΈΡ ΡΠ»ΡΡΠ°ΡΡ Π½ΡΠΆΠ½ΠΎ ΠΎΠ±ΡΠ°ΡΠΈΡΡΡΡ ΠΊ Π»Π΅ΡΠ°ΡΠ΅ΠΌΡ Π²ΡΠ°ΡΡ.
ΠΠ΅Π»ΡΡΠ΅, Π·Π΅Π»Π΅Π½ΡΠ΅
ΠΡΠΈ ΠΏΠΎΡΠ²Π»Π΅Π½ΠΈΠΈ ΠΏΠΎΡΠ»Π΅ ΠΏΡΠΈΠΆΠΈΠ³Π°Π½ΠΈΡ ΡΡΠΎΠ·ΠΈΠΈ ΡΠ΅ΠΉΠΊΠΈ ΠΌΠ°ΡΠΊΠΈ ΠΎΠ±ΠΈΠ»ΡΠ½ΡΡ ΠΆΠ΅Π»ΡΡΡ Π²ΡΠ΄Π΅Π»Π΅Π½ΠΈΠΉ Ρ Π½Π΅ΠΏΡΠΈΡΡΠ½ΡΠΌ Π·Π°ΠΏΠ°Ρ ΠΎΠΌ Π½ΡΠΆΠ½ΠΎ ΠΎΠ±ΡΠ°ΡΠ°ΡΡΡΡ ΠΊ Π²ΡΠ°ΡΡ.
Π’Π°ΠΊΠΈΠ΅ ΠΈΠ·ΠΌΠ΅Π½Π΅Π½ΠΈΡ ΡΠ°ΡΡΠΎ ΡΠ²ΠΈΠ΄Π΅ΡΠ΅Π»ΡΡΡΠ²ΡΡΡ ΠΎ Π²ΠΎΠ·ΠΌΠΎΠΆΠ½ΠΎΠΌ Π²ΠΎΡΠΏΠ°Π»ΠΈΡΠ΅Π»ΡΠ½ΠΎΠΌ ΠΏΡΠΎΡΠ΅ΡΡΠ΅ Π±Π°ΠΊΡΠ΅ΡΠΈΠ°Π»ΡΠ½ΠΎΠ³ΠΎ ΠΏΡΠΎΠΈΡΡ ΠΎΠΆΠ΄Π΅Π½ΠΈΡ. Π‘ΡΠ΅Π΄ΠΈ Π½Π°ΠΈΠ±ΠΎΠ»Π΅Π΅ ΡΠ°ΡΠΏΡΠΎΡΡΡΠ°Π½Π΅Π½Π½ΡΡ ΠΏΠ°ΡΠΎΠ»ΠΎΠ³ΠΈΠΉ β Π²Π°Π³ΠΈΠ½ΠΈΡ, ΠΎΠΎΡΠΎΡΠΈΡ, ΡΠ°Π»ΡΠΏΠΈΠ½Π³ΠΈΡ.
ΠΠ΅Π½ΠΈΡΡΠ°Ρ ΠΊΠΎΠ½ΡΠΈΡΡΠ΅Π½ΡΠΈΡ ΠΆΠ΅Π»ΡΡΡ Π²ΡΠ΄Π΅Π»Π΅Π½ΠΈΠΉ Π΄Π°Π΅Ρ ΠΎΡΠ½ΠΎΠ²Π°Π½ΠΈΡ ΠΏΠΎΠ΄ΠΎΠ·ΡΠ΅Π²Π°ΡΡ ΡΠ°Π·Π²ΠΈΡΠΈΠ΅ Π³ΠΎΠ½ΠΎΡΠ΅ΠΈ ΠΈΠ»ΠΈ ΡΡΠΈΡ ΠΎΠΌΠΎΠ½ΠΈΠ°Π·Π°. ΠΠ½ΠΎΠ³Π΄Π° ΠΎΠ½ΠΈ ΠΏΡΠΈΠΎΠ±ΡΠ΅ΡΠ°ΡΡ Π·Π΅Π»Π΅Π½ΠΎΠ²Π°ΡΡΠΉ ΠΎΡΡΠ΅Π½ΠΎΠΊ.
ΠΡΠΎΡΠ²Π»Π΅Π½ΠΈΡ Π·Π΅Π»Π΅Π½ΠΎΠ³ΠΎ ΠΎΡΡΠ΅Π½ΠΊΠ° ΡΠΊΠ°Π·ΡΠ²Π°ΡΡ Π½Π° ΠΏΠ΅ΡΠ΅Ρ ΠΎΠ΄ Π²ΠΎΡΠΏΠ°Π»ΠΈΡΠ΅Π»ΡΠ½ΠΎΠ³ΠΎ ΠΏΡΠΎΡΠ΅ΡΡΠ° Π² Π³Π½ΠΎΠΉΠ½ΠΎ-Π²ΠΎΡΠΏΠ°Π»ΠΈΡΠ΅Π»ΡΠ½ΡΠΉ. ΠΠ½ΠΎΠΉΠ½ΡΠ΅ Π²ΡΠ΄Π΅Π»Π΅Π½ΠΈΡ ΠΎΠ±ΡΡΠ½ΠΎ ΠΎΠ±ΠΈΠ»ΡΠ½ΡΠ΅, Π³ΡΡΡΡΠ΅, ΠΈΠΌΠ΅ΡΡ Π²ΡΡΠ°ΠΆΠ΅Π½Π½ΡΠΉ Π³Π½ΠΈΠ»ΠΎΡΡΠ½ΡΠΉ Π·Π°ΠΏΠ°Ρ .
ΠΠ½ΠΎΠ³Π΄Π° ΠΠ¨Π ΡΠ΅ΡΠΈΠ΄ΠΈΠ²ΠΈΡΡΠ΅Ρ. ΠΠΎΠ²ΡΠΎΡΠ½ΠΎΠ΅ Π²ΠΎΠ·Π½ΠΈΠΊΠ½ΠΎΠ²Π΅Π½ΠΈΠ΅ Π΄Π΅ΡΠ΅ΠΊΡΠ° ΡΠ»ΠΈΠ·ΠΈΡΡΠΎΠΉ ΠΎΠ±ΠΎΠ»ΠΎΡΠΊΠΈ ΡΠ΅ΠΉΠΊΠΈ ΠΌΠ°ΡΠΊΠΈ Π²Π½Π΅ΡΠ½Π΅ ΠΏΡΠΎΡΠ²Π»ΡΠ΅ΡΡΡ ΠΏΠΎΡΠ²Π»Π΅Π½ΠΈΠ΅ΠΌ ΠΆΠ΅Π»ΡΡΡ Π²ΡΠ΄Π΅Π»Π΅Π½ΠΈΠΉ. Π Π΅ΡΠΈΠ΄ΠΈΠ²Ρ ΡΠ»ΡΡΠ°ΡΡΡΡ ΠΏΡΠΈ Π½Π΅Π΄ΠΎΡΡΠ°ΡΠΎΡΠ½ΠΎ ΡΠΎΡΠ½ΠΎΠΉ ΠΎΠ±ΡΠ°Π±ΠΎΡΠΊΠ΅ ΠΎΡΠ°Π³Π° ΠΏΠΎΡΠ°ΠΆΠ΅Π½ΠΈΡ.
ΠΊ ΠΎΠ³Π»Π°Π²Π»Π΅Π½ΠΈΡ βΠΠΎΡΠΈΡΠ½Π΅Π²ΡΠ΅
ΠΠΎΠ»Ρ ΠΏΠΎ Π½ΠΈΠ·Ρ ΠΆΠΈΠ²ΠΎΡΠ° ΠΈ Π΄ΠΎΠ²ΠΎΠ»ΡΠ½ΠΎ ΠΎΠ±ΠΈΠ»ΡΠ½ΡΠ΅ ΠΊΠΎΡΠΈΡΠ½Π΅Π²ΡΠ΅ Π³ΡΡΡΡΠ΅ Π²ΡΠ΄Π΅Π»Π΅Π½ΠΈΡ Π·Π° Π½Π΅ΡΠΊΠΎΠ»ΡΠΊΠΎ ΡΡΡΠΎΠΊ Π΄ΠΎ Π½Π°ΡΠ°Π»Π° ΠΌΠ΅ΡΡΡΠ½ΡΡ β Ρ Π°ΡΠ°ΠΊΡΠ΅ΡΠ½ΡΠ΅ ΡΠΈΠΌΠΏΡΠΎΠΌΡ ΡΠ½Π΄ΠΎΠΌΠ΅ΡΡΠΈΠΎΠ·Π°.
ΠΡΠ»ΠΈ ΠΎΡΠ΅ΡΠ΅Π΄Π½Π°Ρ ΠΌΠ΅Π½ΡΡΡΡΠ°ΡΠΈΡ Π½Π°ΡΠΈΠ½Π°Π΅ΡΡΡ Π΄ΠΎ ΠΏΠΎΠ»Π½ΠΎΠ³ΠΎ Π·Π°ΠΆΠΈΠ²Π»Π΅Π½ΠΈΡ ΡΠ°Π½ΠΊΠΈ Π½Π° ΠΌΠ΅ΡΡΠ΅ ΡΡΠΎΠ·ΠΈΠΈ, Π²Π΅ΡΠΎΡΡΠ½ΠΎΡΡΡ ΡΠ°Π·Π²ΠΈΡΠΈΡ ΡΡΠΎΠ³ΠΎ Π·Π°Π±ΠΎΠ»Π΅Π²Π°Π½ΠΈΡ ΠΏΠΎΠ²ΡΡΠ°Π΅ΡΡΡ Π² ΡΠ°Π·Ρ.
ΠΡΠ΄Π΅Π»Π΅Π½ΠΈΡ ΠΎΠ±ΡΡΠ½ΠΎ ΡΠ»ΠΈΠ·ΠΈΡΡΡΠ΅, Ρ ΠΏΡΠΈΠΌΠ΅ΡΡΠΌΠΈ ΠΊΡΠΎΠ²ΠΈ, ΠΎΡΡΠ΅Π½ΠΎΠΊ β ΠΎΡ ΠΊΡΠ°ΡΠ½ΠΎ-ΠΊΠΎΡΠΈΡΠ½Π΅Π²ΠΎΠ³ΠΎ Π΄ΠΎ ΠΏΠΎΡΡΠΈ ΡΠ΅ΡΠ½ΠΎΠ³ΠΎ. ΠΠ΅ΠΏΡΠΈΡΡΠ½ΡΠΉ Π·Π°ΠΏΠ°Ρ ΡΠ΅ΠΊΡΠ΅ΡΠ° ΡΠΊΠ°Π·ΡΠ²Π°Π΅Ρ Π½Π° ΡΠΎΠΏΡΡΡΡΠ²ΡΡΡΠΈΠ΅ Π²ΠΎΡΠΏΠ°Π»ΠΈΡΠ΅Π»ΡΠ½ΡΠ΅ ΠΏΡΠΎΡΠ΅ΡΡΡ.
Π£Π·Π½Π°ΠΉΡΠ΅ ΠΎ Π·Π°Π±ΠΎΠ»Π΅Π²Π°Π½ΠΈΠΈ:ΠΊ ΠΎΠ³Π»Π°Π²Π»Π΅Π½ΠΈΡ β
ΠΠ°ΠΊ ΠΈΠ·Π±Π΅ΠΆΠ°ΡΡ ΠΎΡΠ»ΠΎΠΆΠ½Π΅Π½ΠΈΠΉ ΠΈ ΠΏΠΎΡΠ»Π΅Π΄ΡΡΠ²ΠΈΠΉ
ΠΠ΅Π·Π°Π²ΠΈΡΠΈΠΌΠΎ ΠΎΡ ΡΠ°Π·ΠΌΠ΅ΡΠΎΠ² ΠΈΡΡ
ΠΎΠ΄Π½ΠΎΠ³ΠΎ ΠΏΠΎΡΠ°ΠΆΠ΅Π½ΠΈΡ ΠΏΠΎΡΠ»Π΅ ΠΏΡΠΈΠΆΠΈΠ³Π°Π½ΠΈΡ ΠΠ¨Π ΡΠ»Π΅Π΄ΡΠ΅Ρ ΡΠΎΠ±Π»ΡΠ΄Π°ΡΡ Π½Π΅ΠΊΠΎΡΠΎΡΡΠ΅ ΠΌΠ΅ΡΡ ΠΏΡΠ΅Π΄ΠΎΡΡΠΎΡΠΎΠΆΠ½ΠΎΡΡΠΈ.
Π‘ΡΠΎΠΈΡ ΠΈΠ·Π±Π΅Π³Π°ΡΡ Π·Π½Π°ΡΠΈΡΠ΅Π»ΡΠ½ΡΡ ΡΠΈΠ·ΠΈΡΠ΅ΡΠΊΠΈΡ Π½Π°Π³ΡΡΠ·ΠΎΠΊ. ΠΠ΅ΡΠ΅Π½Π°ΠΏΡΡΠΆΠ΅Π½ΠΈΠ΅ ΠΌΠΎΠΆΠ΅Ρ ΡΠΏΡΠΎΠ²ΠΎΡΠΈΡΠΎΠ²Π°ΡΡ ΠΊΡΠΎΠ²ΠΎΡΠ΅ΡΠ΅Π½ΠΈΠ΅.
ΠΠ½Π°Π»ΠΎΠ³ΠΈΡΠ½ΠΎ Π΄Π΅ΠΉΡΡΠ²ΡΠ΅Ρ ΠΈ ΠΏΠ΅ΡΠ΅Π³ΡΠ΅Π², ΠΏΠΎΡΡΠΎΠΌΡ ΠΏΠΎΡ ΠΎΠ΄ Π² Π±Π°Π½Ρ, ΡΠ°ΡΠ½Ρ ΠΈΠ»ΠΈ Π½Π° ΠΏΠ»ΡΠΆ Π»ΡΡΡΠ΅ ΠΎΡΠ»ΠΎΠΆΠΈΡΡ.
ΠΠΎ ΠΏΠΎΠ»Π½ΠΎΠ³ΠΎ Π·Π°ΠΆΠΈΠ²Π»Π΅Π½ΠΈΡ ΡΠ°Π½ΠΊΠΈ ΡΠ΅ΠΊΠΎΠΌΠ΅Π½Π΄ΡΠ΅ΡΡΡ Π²ΠΎΠ·Π΄Π΅ΡΠΆΠΈΠ²Π°ΡΡΡΡ ΠΎΡ ΠΏΠΎΡΠ΅ΡΠ΅Π½ΠΈΡ Π±Π°ΡΡΠ΅ΠΉΠ½Π°, ΠΏΡΠΈΠ½ΡΡΠΈΡ Π²Π°Π½Π½Ρ ΠΈ ΠΊΡΠΏΠ°Π½ΠΈΡ Π² ΠΎΡΠΊΡΡΡΡΡ Π²ΠΎΠ΄ΠΎΠ΅ΠΌΠ°Ρ .
ΠΠ΅Π½ΡΡΡ ΠΏΡΠΎΠΊΠ»Π°Π΄ΠΊΠΈ Π² ΡΡΠΎΡ ΠΏΠ΅ΡΠΈΠΎΠ΄ Π½ΡΠΆΠ½ΠΎ ΡΠ°ΡΠ΅ ΠΎΠ±ΡΡΠ½ΠΎΠ³ΠΎ β ΠΈΡΠΏΠΎΠ»ΡΠ·ΠΎΠ²Π°Π½Π½ΡΠ΅ Π³ΠΈΠ³ΠΈΠ΅Π½ΠΈΡΠ΅ΡΠΊΠΈΠ΅ ΡΡΠ΅Π΄ΡΡΠ²Π° ΠΏΡΠ΅Π΄ΡΡΠ°Π²Π»ΡΡΡ ΡΠΎΠ±ΠΎΠΉ ΠΈΠ΄Π΅Π°Π»ΡΠ½ΡΡ ΡΡΠ΅Π΄Ρ Π΄Π»Ρ ΡΠ°Π·ΠΌΠ½ΠΎΠΆΠ΅Π½ΠΈΡ ΠΏΠΎΡΠ΅Π½ΡΠΈΠ°Π»ΡΠ½ΠΎ ΠΎΠΏΠ°ΡΠ½ΡΡ ΠΌΠΈΠΊΡΠΎΠΎΡΠ³Π°Π½ΠΈΠ·ΠΌΠΎΠ².
ΠΠΎ ΡΡΠΎΠΉ ΠΆΠ΅ ΠΏΡΠΈΡΠΈΠ½Π΅ ΠΏΠΎΠ΄ Π·Π°ΠΏΡΠ΅Ρ ΠΏΠΎΠΏΠ°Π΄Π°Π΅Ρ ΡΠΈΠ½ΡΠ΅ΡΠΈΡΠ΅ΡΠΊΠΎΠ΅ Π±Π΅Π»ΡΠ΅, ΠΎΡΠΎΠ±Π΅Π½Π½ΠΎ ΠΏΠ»ΠΎΡΠ½ΠΎ ΠΏΡΠΈΠ»Π΅Π³Π°ΡΡΠ΅Π΅ ΠΊ ΡΠ΅Π»Ρ.
Π ΡΠ΅ΡΠ΅Π½ΠΈΠ΅ Π²ΠΎΡΡΡΠ°Π½ΠΎΠ²ΠΈΡΠ΅Π»ΡΠ½ΠΎΠ³ΠΎ ΠΏΠ΅ΡΠΈΠΎΠ΄Π° Π½Π΅Π»ΡΠ·Ρ ΡΠΏΡΠΈΠ½ΡΠ΅Π²Π°ΡΡΡΡ. ΠΡΠΈ Π½Π°Π»ΠΈΡΠΈΠΈ ΡΠ°Π½Π΅Π²ΠΎΠ³ΠΎ Π΄Π΅ΡΠ΅ΠΊΡΠ° ΡΠ»ΠΈΠ·ΠΈΡΡΠΎΠΉ ΠΎΠ±ΠΎΠ»ΠΎΡΠΊΠΈ Π΅ΡΡΡ ΡΠΈΡΠΊ ΡΡΠ°Π²ΠΌΠΈΡΠΎΠ²Π°ΡΡ ΠΎΠ±Π»Π°ΡΡΡ ΠΏΠΎΡΠ°ΠΆΠ΅Π½ΠΈΡ ΠΈΠ»ΠΈ Π·Π°Π½Π΅ΡΡΠΈ ΠΈΠ½ΡΠ΅ΠΊΡΠΈΡ.
ΠΠΎΠ»ΠΎΠ΄Π°Ρ ΡΠΊΠ°Π½Ρ, ΠΎΠ±ΡΠ°Π·ΡΡΡΠ°ΡΡΡ ΠΏΠΎΠ΄ ΡΡΡΡΠΏΠΎΠΌ, ΠΎΡΠ΅Π½Ρ ΡΡΠ·Π²ΠΈΠΌΠ°, Π΅ΡΠ»ΠΈ ΡΠ΅ΠΌΠΏΠ΅ΡΠ°ΡΡΡΠ° ΡΠ°ΡΡΠ²ΠΎΡΠ° Π΄Π»Ρ ΡΠΏΡΠΈΠ½ΡΠ΅Π²Π°Π½ΠΈΡ Π²ΡΡΠ΅ Π½Π΅ΠΎΠ±Ρ ΠΎΠ΄ΠΈΠΌΠΎΠΉ, Π΅ΡΡΡ ΡΠΈΡΠΊ ΠΎΠΆΠΎΠ³Π° ΠΈ ΠΎΠ±ΡΠ°Π·ΠΎΠ²Π°Π½ΠΈΡ ΡΡΠ±ΡΠΎΠ².
ΠΠΎΡΠ»Π΅ Π»Π΅ΡΠ΅Π½ΠΈΡ ΠΠ¨Π Π² ΡΠ΅ΡΠ΅Π½ΠΈΠ΅ 1,5-2,5 ΠΌΠ΅ΡΡΡΠ΅Π² ΡΠ΅ΠΊΠΎΠΌΠ΅Π½Π΄ΡΠ΅ΡΡΡ ΠΏΠΎΠ»ΠΎΠ²ΠΎΠΉ ΠΏΠΎΠΊΠΎΠΉ. ΠΡΠΈ Π½Π΅ΠΎΠ±Ρ ΠΎΠ΄ΠΈΠΌΠΎΡΡΠΈ ΠΏΡΠΎΠ²Π΅Π΄Π΅Π½ΠΈΡ Π£ΠΠ Π² ΡΡΠΎΡ ΠΏΠ΅ΡΠΈΠΎΠ΄ ΠΈΡΠΏΠΎΠ»ΡΠ·ΡΠ΅ΡΡΡ ΡΠΎΠ»ΡΠΊΠΎ ΡΡΠ°Π½ΡΠ°Π±Π΄ΠΎΠΌΠΈΠ½Π°Π»ΡΠ½ΡΠΉ Π΄Π°ΡΡΠΈΠΊ.
beautyladi.ru
ΠΡΠΈΠΆΠΈΠ³Π°Π½ΠΈΠ΅ ΡΡΠΎΠ·ΠΈΠΈ ΡΠ΅ΠΉΠΊΠΈ ΠΌΠ°ΡΠΊΠΈ: ΠΏΠΎΡΠ»Π΅Π΄ΡΡΠ²ΠΈΡ, Π²ΡΠ΄Π΅Π»Π΅Π½ΠΈΡ, ΠΎΡΠ»ΠΎΠΆΠ½Π΅Π½ΠΈΡ
ΠΠΎΠ³Π΄Π° ΡΡΠ΅Π±ΡΠ΅ΡΡΡ ΠΏΡΠΈΠΆΠΈΠ³Π°Π½ΠΈΠ΅ ΡΡΠΎΠ·ΠΈΠΈ ΡΠ΅ΠΉΠΊΠΈ ΠΌΠ°ΡΠΊΠΈ, Π½Π΅ΠΊΠΎΡΠΎΡΡΠ΅ ΠΏΠΎΡΠ»Π΅Π΄ΡΡΠ²ΠΈΡ: Π²ΡΠ΄Π΅Π»Π΅Π½ΠΈΡ, Π΄ΠΈΡΠΊΠΎΠΌΡΠΎΡΡ. ΠΠΎΠ²ΠΎΠ»ΡΠ½ΠΎ ΠΎΠΏΠ°ΡΠ½ΠΎΠ΅ Π·Π°Π±ΠΎΠ»Π΅Π²Π°Π½ΠΈΠ΅, ΠΊΠΎΡΠΎΡΠΎΠ΅ ΠΌΠΎΠΆΠ΅Ρ ΠΏΡΠΎΡΠ²ΠΈΡΡΡΡ Π²Π΅ΡΡΠΌΠ° Π²Π½Π΅Π·Π°ΠΏΠ½ΠΎ β ΡΡΠΎΠ·ΠΈΡ ΡΠ΅ΠΉΠΊΠΈ ΠΌΠ°ΡΠΊΠΈ. ΠΠ΅ΡΠΈΡΡΡ ΠΎΠ½ΠΎ Π΄ΠΎΠ²ΠΎΠ»ΡΠ½ΠΎ ΡΠ»ΠΎΠΆΠ½ΠΎ, ΠΈΠΌΠ΅Π½Π½ΠΎ ΠΏΠΎΡΡΠΎΠΌΡ Π½ΡΠΆΠ½ΠΎ Π·Π½Π°ΡΡ, ΡΡΠΎ ΠΏΡΠ΅Π΄ΡΡΠ°Π²Π»ΡΠ΅Ρ ΡΠΎΠ±ΠΎΠΉ ΡΡΠΎΡ Π½Π΅Π΄ΡΠ³ ΠΈ ΠΎΡΠ½ΠΎΠ²Π½ΡΠ΅ ΠΌΠ΅ΡΠΎΠ΄Ρ Π΅Π³ΠΎ Π»Π΅ΡΠ΅Π½ΠΈΡ.
Π§ΡΠΎ ΠΏΡΠ΅Π΄ΡΡΠ°Π²Π»ΡΠ΅Ρ ΡΠΎΠ±ΠΎΠΉ ΡΡΠΎ Π·Π°Π±ΠΎΠ»Π΅Π²Π°Π½ΠΈΠ΅

ΠΡΠΎ Π·Π°Π±ΠΎΠ»Π΅Π²Π°Π½ΠΈΠ΅ ΠΏΡΠ΅Π΄ΡΡΠ°Π²Π»ΡΠ΅Ρ ΡΠΎΠ±ΠΎΠΉ ΠΈΠ·ΠΌΠ΅Π½Π΅Π½ΠΈΠ΅ Π½ΠΎΡΠΌΠ°Π»ΡΠ½ΡΡ ΠΊΠ»Π΅ΡΠΎΠΊ ΠΆΠ΅Π½ΡΠΊΠΎΠ³ΠΎ ΠΏΠΎΠ»ΠΎΠ²ΠΎΠ³ΠΎ ΠΎΡΠ³Π°Π½Π°. ΠΠ°ΠΊ ΠΏΡΠ°Π²ΠΈΠ»ΠΎ, ΡΠ°Π·Π²ΠΈΠ²Π°Π΅ΡΡΡ ΠΎΠ½ΠΎ Π½Π° ΠΊΠ°ΠΊΠΎΠΌ-ΡΠΎ ΠΎΠΏΡΠ΅Π΄Π΅Π»Π΅Π½Π½ΠΎΠΌ ΡΡΠ°ΡΡΠΊΠ΅.
ΠΡΠ΅Π³ΠΎ Π²ΡΠ΄Π΅Π»ΡΡΡ Π½Π΅ΡΠΊΠΎΠ»ΡΠΊΠΎ Π²ΠΈΠ΄ΠΎΠ² ΡΡΠΎΠ·ΠΈΠΈ:
- ΠΡΠ΅Π²Π΄ΠΎΡΡΠΎΠ·ΠΈΡ.
- ΠΡΡΠΈΠ½Π½Π°Ρ ΡΡΠΎΠ·ΠΈΡ.
ΠΡΠ΅Π²Π΄ΠΎΡΡΠΎΠ·ΠΈΡ ΡΠ²Π»Π΅Π½ΠΈΠ΅ Π΄ΠΎΠ²ΠΎΠ»ΡΠ½ΠΎ ΡΠ°ΡΡΠΎΠ΅. ΠΠ½Π° ΠΌΠΎΠΆΠ΅Ρ ΡΠ°Π·Π²ΠΈΠ²Π°ΡΡΡΡ ΠΈΠ·-Π·Π° ΡΠ°Π·Π»ΠΈΡΠ½ΡΡ Π·Π°Π±ΠΎΠ»Π΅Π²Π°Π½ΠΈΠΉ Π²ΠΎΡΠΏΠ°Π»ΠΈΡΠ΅Π»ΡΠ½ΠΎΠ³ΠΎ Ρ Π°ΡΠ°ΠΊΡΠ΅ΡΠ° ΠΈ Π³ΠΎΡΠΌΠΎΠ½Π°Π»ΡΠ½ΡΡ Π½Π°ΡΡΡΠ΅Π½ΠΈΠΉ.
ΠΡΡΠΈΠ½Π½Π°Ρ ΡΡΠΎΠ·ΠΈΡ Π²ΡΠ³Π»ΡΠ΄ΠΈΡ ΠΊΠ°ΠΊ ΡΠ°Π·ΡΡΡΠ΅Π½ΠΈΠ΅ Π½Π΅Π±ΠΎΠ»ΡΡΠΎΠ³ΠΎ ΡΡΠ°ΡΡΠΊΠ° ΡΠ»ΠΈΠ·ΠΈΡΡΠΎΠΉ ΠΎΠ±ΠΎΠ»ΠΎΡΠΊΠΈ ΠΎΡΠ³Π°Π½Π°. ΠΠ° ΠΌΠ΅ΡΡΠ΅ ΡΠ°ΠΊΠΎΠ³ΠΎ ΡΠ°Π·ΡΡΡΠ΅Π½ΠΈΡ Π²ΠΎΠ·Π½ΠΈΠΊΠ°Π΅Ρ ΡΠ°Π½ΠΊΠ°. Π ΡΡΡ ΡΠ°Π½ΠΊΡ ΠΌΠΎΠ³ΡΡ ΠΏΠΎΡΠΏΠ°ΡΡΡ ΡΠ°Π·Π»ΠΈΡΠ½ΠΎΠ³ΠΎ ΡΠΎΠ΄Π° Π²ΡΠ΅Π΄ΠΎΠ½ΠΎΡΠ½ΡΠ΅ ΠΌΠΈΠΊΡΠΎΠΎΡΠ³Π°Π½ΠΈΠ·ΠΌΡ, ΡΠ°Π·Π²ΠΈΡΠΈΠ΅ ΠΊΠΎΡΠΎΡΡΡ Π² ΡΠ²ΠΎΡ ΠΎΡΠ΅ΡΠ΅Π΄Ρ ΠΌΠΎΠΆΠ΅Ρ ΡΠΏΡΠΎΠ²ΠΎΡΠΈΡΠΎΠ²Π°ΡΡ ΠΎΡΠ»ΠΎΠΆΠ½Π΅Π½ΠΈΡ. ΠΡΠΎΠΌΠ΅ ΡΠΎΠ³ΠΎ, Π΅ΡΠ»ΠΈ ΡΡΠΎ Π·Π°Π±ΠΎΠ»Π΅Π²Π°Π½ΠΈΠ΅ Π½Π΅ Π»Π΅ΡΠΈΡΡ, ΠΎΠ½ΠΎ ΠΌΠΎΠΆΠ΅Ρ ΠΏΠ΅ΡΠ΅ΠΉΡΠΈ Π² ΡΠ°Π½Π³ ΠΎΠΏΡΡ ΠΎΠ»Π΅ΠΉ.
ΠΡΠΈΡΠΈΠ½Ρ
ΠΡΠΈΡΠΈΠ½ Π²ΠΎΠ·Π½ΠΈΠΊΠ½ΠΎΠ²Π΅Π½ΠΈΡ ΡΡΠΎΠ³ΠΎ Π½Π΅Π΄ΡΠ³Π° Π΄ΠΎΡΡΠ°ΡΠΎΡΠ½ΠΎ ΠΌΠ½ΠΎΠ³ΠΎ. ΠΠ°ΠΈΠ±ΠΎΠ»Π΅Π΅ ΡΠ°ΡΠΏΡΠΎΡΡΡΠ°Π½Π΅Π½Π½ΡΠ΅ ΡΠ°ΠΊΡΠΎΡΡ, Π²ΡΠ·ΡΠ²Π°ΡΡΠΈΠ΅ ΡΠ°Π·Π²ΠΈΡΠΈΠ΅ ΡΡΠΎΠ·ΠΈΠΈ:- Π Π°Π½Π½ΡΡ ΠΏΠΎΠ»ΠΎΠ²Π°Ρ ΠΆΠΈΠ·Π½Ρ.
- ΠΠΎΠ·Π΄Π½Π΅Π΅ Π½Π°ΡΠ°Π»ΠΎ ΠΏΠΎΠ»ΠΎΠ²ΠΎΠΉ ΠΆΠΈΠ·Π½ΠΈ.
- Π Π΅Π΄ΠΊΠΈΠ΅ ΠΏΠΎΠ»ΠΎΠ²ΡΠ΅ ΠΊΠΎΠ½ΡΠ°ΠΊΡΡ.
- ΠΠΎΡΡΠΎΡΠ½Π½Π°Ρ ΡΠΌΠ΅Π½Π° ΠΏΠ°ΡΡΠ½Π΅ΡΠΎΠ².
- ΠΠ΅ΡΠ΅Π½Π΅ΡΠ΅Π½Π½ΡΠ΅ ΠΏΠΎΠ»ΠΎΠ²ΡΠ΅ ΠΈΠ½ΡΠ΅ΠΊΡΠΈΠΈ.
- ΠΠ΅Ρ Π°Π½ΠΈΡΠ΅ΡΠΊΠΈΠ΅ Π²ΠΎΠ·Π΄Π΅ΠΉΡΡΠ²ΠΈΡ Π½Π° ΠΎΡΠ³Π°Π½.
- ΠΠΎΡΠΌΠΎΠ½Π°Π»ΡΠ½ΡΠΉ ΡΠ±ΠΎΠΉ.
- ΠΠ°Π±ΠΎΠ»Π΅Π²Π°Π½ΠΈΡ ΡΠΈΡΠΎΠ²ΠΈΠ΄Π½ΠΎΠΉ ΠΆΠ΅Π»Π΅Π·Ρ.
- Π‘Π»Π°Π±ΡΠΉ ΠΈΠΌΠΌΡΠ½ΠΈΡΠ΅Ρ.
Π‘ΠΈΠΌΠΏΡΠΎΠΌΡ
ΠΡΠΎ Π·Π°Π±ΠΎΠ»Π΅Π²Π°Π½ΠΈΠ΅ Ρ
Π°ΡΠ°ΠΊΡΠ΅ΡΠΈΠ·ΡΠ΅ΡΡΡ ΡΠ΅ΠΌ, ΡΡΠΎ Π΄ΠΎΠ²ΠΎΠ»ΡΠ½ΠΎ ΡΠ΅Π΄ΠΊΠΎ ΠΏΡΠΎΡΠ²Π»ΡΠ΅Ρ ΠΊΠ°ΠΊΠΈΠ΅-Π»ΠΈΠ±ΠΎ ΡΠΈΠΌΠΏΡΠΎΠΌΡ. ΠΠ°ΠΊ ΠΏΡΠ°Π²ΠΈΠ»ΠΎ, Π΄ΠΈΠ°Π³Π½ΠΎΡΡΠΈΡΡΠ΅ΡΡΡ ΠΎΠ½ΠΎ Π½Π΅ΠΎΠΆΠΈΠ΄Π°Π½Π½ΠΎ, Π² Ρ
ΠΎΠ΄Π΅ Π³ΠΈΠ½Π΅ΠΊΠΎΠ»ΠΎΠ³ΠΈΡΠ΅ΡΠΊΠΎΠ³ΠΎ ΠΎΡΠΌΠΎΡΡΠ°.ΠΠ΄Π½Π°ΠΊΠΎ ΠΈΠ½ΠΎΠ³Π΄Π° ΡΡΠΎ Π·Π°Π±ΠΎΠ»Π΅Π²Π°Π½ΠΈΠ΅ Π²ΡΠ΅ ΠΆΠ΅ ΠΌΠΎΠΆΠ½ΠΎ ΡΠ°ΡΠΏΠΎΠ·Π½Π°ΡΡ ΠΏΠΎ ΡΠΏΠ΅ΡΠΈΡΠΈΡΠ΅ΡΠΊΠΈΠΌ ΠΏΡΠΈΠ·Π½Π°ΠΊΠ°ΠΌ. Π Π½ΠΈΠΌ ΠΌΠΎΠΆΠ½ΠΎ ΠΎΡΠ½Π΅ΡΡΠΈ:
- ΠΡΠ΄Π΅Π»Π΅Π½ΠΈΡ ΠΊΡΠΎΠ²ΡΠ½ΠΈΡΡΠΎΠ³ΠΎ Ρ Π°ΡΠ°ΠΊΡΠ΅ΡΠ°.
- ΠΠΎΠ»Π΅Π²ΡΠ΅ ΠΎΡΡΡΠ΅Π½ΠΈΡ ΠΏΡΠΈ ΠΏΠΎΠ»ΠΎΠ² Π°ΠΊΡΠ΅.
- Π‘Π»ΠΈΠ·ΠΈΡΡΡΠ΅ Π²ΡΠ΄Π΅Π»Π΅Π½ΠΈΡ.
- ΠΠ½ΠΎΠΉΠ½ΡΠ΅ Π²ΡΠ΄Π΅Π»Π΅Π½ΠΈΡ.
ΠΠ½ΠΎΠ³Π΄Π° Ρ ΠΆΠ΅Π½ΡΠΈΠ½ ΠΏΠΎ Π½Π΅ΠΏΠΎΠ½ΡΡΠ½ΡΠΌ, ΠΊΠ°Π·Π°Π»ΠΎΡΡ Π±Ρ, ΠΏΡΠΈΡΠΈΠ½Π°ΠΌ Π±ΠΎΠ»ΠΈΡ ΠΆΠΈΠ²ΠΎΡ.
ΠΠΎ ΠΌΠ½ΠΎΠ³ΠΎΠΌ ΠΏΡΠΎΡΠ²Π»Π΅Π½ΠΈΠ΅ ΡΡΠΈΡ ΠΏΡΠΈΠ·Π½Π°ΠΊΠΎΠ² ΡΠ²ΡΠ·Π°Π½ΠΎ Ρ ΡΠ΅ΠΌ, ΡΡΠΎ ΠΊ Π½Π΅Π΄ΡΠ³Ρ ΠΏΡΠΈΡΠΎΠ΅Π΄ΠΈΠ½ΡΠ΅ΡΡΡ Π²ΠΎΡΠΏΠ°Π»ΠΈΡΠ΅Π»ΡΠ½ΡΠΉ ΠΏΡΠΎΡΠ΅ΡΡ. ΠΡΠΎΡ ΡΠ°ΠΊΡΠΎΡ Π·Π½Π°ΡΠΈΡΠ΅Π»ΡΠ½ΠΎ ΡΡΡΠ³ΡΠ±Π»ΡΠ΅Ρ ΡΠ΅ΡΠ΅Π½ΠΈΠ΅ Π±ΠΎΠ»Π΅Π·Π½ΠΈ.
ΠΡΠ»ΠΈ Ρ Π²Π°Ρ Π½Π°Π±Π»ΡΠ΄Π°ΡΡΡΡ ΡΠ°ΠΊΠΈΠ΅ ΠΏΡΠΈΠ·Π½Π°ΠΊΠΈ ΠΈ Π±ΠΎΠ»ΠΈΡ ΠΆΠΈΠ²ΠΎΡ, ΡΠΎ ΡΡΠΎΠΈΡ Π½Π΅ΠΌΠ΅Π΄Π»Π΅Π½Π½ΠΎ ΠΎΠ±ΡΠ°ΡΠΈΡΡΡΡ ΠΊ Π²ΡΠ°ΡΡ.
ΠΠ°ΠΊ Π»Π΅ΡΠΈΡΡΡ ΡΡΠΎΠ·ΠΈΡ
ΠΠ° Π΄Π°Π½Π½ΡΠΉ ΠΌΠΎΠΌΠ΅Π½Ρ ΡΠΏΠ΅ΡΠΈΠ°Π»ΠΈΡΡΡ ΠΏΡΠ΅Π΄Π»Π°Π³Π°ΡΡ Π½Π΅ΡΠΊΠΎΠ»ΡΠΊΠΎ ΠΌΠ΅ΡΠΎΠ΄ΠΎΠ² Π»Π΅ΡΠ΅Π½ΠΈΡ ΡΡΠΎΠ³ΠΎ Π·Π°Π±ΠΎΠ»Π΅Π²Π°Π½ΠΈΡ. ΠΡ Π²ΡΠ±ΠΎΡ Π·Π°Π²ΠΈΡΠΈΡ ΠΎΡ ΡΠΎΡΡΠΎΡΠ½ΠΈΡ ΠΆΠ΅Π½ΡΠΈΠ½Ρ, ΡΡΠ°Π΄ΠΈΠΈ Π±ΠΎΠ»Π΅Π·Π½ΠΈ, Π²Π΅Π»ΠΈΡΠΈΠ½Ρ ΠΏΠΎΡΠ°ΠΆΠ΅Π½ΠΈΡ.
ΠΠ»Π°Π²Π½Π°Ρ ΡΠ΅Π»Ρ Π»Π΅ΡΠ΅Π½ΠΈΡ β ΡΡΡΡΠ°Π½Π΅Π½ΠΈΠ΅ ΠΈΠ·ΠΌΠ΅Π½Π΅Π½Π½ΠΎΠΉ ΡΠΊΠ°Π½ΠΈ. ΠΡΠ»ΠΈ ΠΊ Π·Π°Π±ΠΎΠ»Π΅Π²Π°Π½ΠΈΡ ΠΏΡΠΈΡΠΎΠ΅Π΄ΠΈΠ½ΠΈΠ»ΡΡ Π²ΠΎΡΠΏΠ°Π»ΠΈΡΠ΅Π»ΡΠ½ΡΠΉ ΠΏΡΠΎΡΠ΅ΡΡ, ΡΠΎ, ΠΏΡΠ΅ΠΆΠ΄Π΅ Π²ΡΠ΅Π³ΠΎ, ΠΏΡΠΎΠΈΠ·Π²ΠΎΠ΄ΠΈΡΡΡΡ ΡΡΡΡΠ°Π½Π΅Π½ΠΈΠ΅ ΠΈΠ½ΡΠ΅ΠΊΡΠΈΠΈ. ΠΠ»Ρ ΡΡΠΎΠ³ΠΎ ΡΠΏΠ΅ΡΠΈΠ°Π»ΠΈΡΡΡ, ΠΊΠ°ΠΊ ΠΏΡΠ°Π²ΠΈΠ»ΠΎ, Π½Π°Π·Π½Π°ΡΠ°ΡΡ ΠΊΡΡΡ Π°Π½ΡΠΈΠ±ΠΈΠΎΡΠΈΠΊΠΎΠ². ΠΠΎΡΠ»Π΅ ΠΏΡΠΎΡ ΠΎΠΆΠ΄Π΅Π½ΠΈΡ ΡΠ°ΠΊΠΎΠ³ΠΎ ΠΊΡΡΡΠ° Π½Π°Π·Π½Π°ΡΠ°ΡΡ ΠΏΡΠ΅ΠΏΠ°ΡΠ°ΡΡ, Π²ΠΎΡΡΡΠ°Π½Π°Π²Π»ΠΈΠ²Π°ΡΡΠΈΠ΅ ΠΎΠ±ΠΎΠ»ΠΎΡΠΊΡ ΠΎΡΠ³Π°Π½Π°. Π‘ΡΠΎΠΈΡ ΠΎΡΠΌΠ΅ΡΠΈΡΡ, ΡΡΠΎ Π² ΠΏΡΠΎΡΠ΅ΡΡΠ΅ ΡΠ°ΠΊΠΎΠ³ΠΎ Π»Π΅ΡΠ΅Π½ΠΈΡ Π±ΠΎΠ»ΠΈ ΠΌΠΎΠ³ΡΡ ΠΎΡΠ΄Π°Π²Π°ΡΡ Π² ΠΆΠΈΠ²ΠΎΡ. ΠΡΠΎ ΡΠ²Π»Π΅Π½ΠΈΠ΅ Π²ΠΏΠΎΠ»Π½Π΅ Π½ΠΎΡΠΌΠ°Π»ΡΠ½ΠΎΠ΅.ΠΠ΄Π½Π°ΠΊΠΎ Π½Π°ΠΈΠ±ΠΎΠ»Π΅Π΅ ΡΡΡΠ΅ΠΊΡΠΈΠ²Π½ΡΠΌΠΈ ΠΌΠ΅ΡΠΎΠ΄Π°ΠΌΠΈ Π»Π΅ΡΠ΅Π½ΠΈΡ ΠΏΡΠΈΠ½ΡΡΠΎ ΡΡΠΈΡΠ°ΡΡ ΡΠΈΠ·ΠΈΠΎΡ ΠΈΡΡΡΠ³ΠΈΡΠ΅ΡΠΊΠΈΠ΅. Π Π½ΠΈΠΌ ΠΎΡΠ½ΠΎΡΡΡΡΡ:
- ΠΠ»Π΅ΠΊΡΡΠΎΠΊΠΎΠ°Π³ΡΠ»ΡΡΠΈΡ.
- ΠΡΠΈΠΎΠ²ΠΎΠ·Π΄Π΅ΠΉΡΡΠ²ΠΈΠ΅.
- ΠΠ°Π·Π΅ΡΠ½Π°Ρ ΠΊΠΎΠ°Π³ΡΠ»ΡΡΠΈΡ.
- Π Π°Π΄ΠΈΠΎΠ²ΠΎΠ»Π½ΠΎΠ²Π°Ρ Ρ ΠΈΡΡΡΠ³ΠΈΡ.
ΠΡΠΈΠΆΠΈΠ³Π°Π½ΠΈΠ΅ Π»Π°Π·Π΅ΡΠΎΠΌ ΠΎΠ΄ΠΈΠ½ ΠΈΠ· ΡΠ°ΠΌΡΡ ΡΡΡΠ΅ΠΊΡΠΈΠ²Π½ΡΡ ΠΌΠ΅ΡΠΎΠ΄ΠΎΠ² Π»Π΅ΡΠ΅Π½ΠΈΡ. ΠΡΠΎ ΡΠ²ΡΠ·Π°Π½ΠΎ Ρ ΡΠ΅ΠΌ, ΡΡΠΎ ΠΏΡΠΈΠΆΠΈΠ³Π°Π½ΠΈΠ΅ Π»Π°Π·Π΅ΡΠΎΠΌ Ρ ΠΌΠ°ΠΊΡΠΈΠΌΠ°Π»ΡΠ½ΠΎΠΉ ΡΠΎΡΠ½ΠΎΡΡΡΡ ΠΏΠΎΠ·Π²ΠΎΠ»ΡΠ΅Ρ ΠΎΠ±ΡΠ°Π±ΠΎΡΠ°ΡΡ ΠΏΠΎΡΠ°ΠΆΠ΅Π½Π½ΡΠΉ ΡΡΠ°ΡΡΠΎΠΊ.
ΠΡΠΎΠΌΠ΅ ΡΠΎΠ³ΠΎ, Π»Π°Π·Π΅ΡΠ½ΠΎΠ΅ Π²ΠΎΠ·Π΄Π΅ΠΉΡΡΠ²ΠΈΠ΅ ΡΡΡΡΠ°Π½ΡΠ΅Ρ Π²ΠΎΡΠΏΠ°Π»Π΅Π½ΠΈΠ΅ ΠΈ Π²ΡΡΡΡΠΏΠ°Π΅Ρ Π² ΡΠΎΠ»ΠΈ ΠΎΠ΄Π½ΠΎΠ³ΠΎ ΠΈΠ· ΡΠ°ΠΌΡΡ Π±Π΅Π·ΠΎΠΏΠ°ΡΠ½ΡΡ .
ΠΠΎΡΠ»Π΅Π΄ΡΡΠ²ΠΈΡ ΠΏΡΠΈΠΆΠΈΠ³Π°Π½ΠΈΡ ΡΡΠΎΠ·ΠΈΠΈ ΡΠ΅ΠΉΠΊΠΈ ΠΌΠ°ΡΠΊΠΈ
ΠΠΎΠ²ΠΎΠ»ΡΠ½ΠΎ ΡΠ°ΡΡΠΎ ΠΏΠΎΡΠ»Π΅ Π»Π΅ΡΠ΅Π½ΠΈΡ ΡΠ°ΠΊΠΈΠΌ ΠΌΠ΅ΡΠΎΠ΄ΠΎΠΌ, Ρ ΠΆΠ΅Π½ΡΠΈΠ½ Π² ΡΠ΅ΡΠ΅Π½ΠΈΠ΅ Π½Π΅ΡΠΊΠΎΠ»ΡΠΊΠΈΡ Π½Π΅Π΄Π΅Π»Ρ ΠΌΠΎΠ³ΡΡ Π½Π°Π±Π»ΡΠ΄Π°ΡΡΡΡ Π²ΡΠ΄Π΅Π»Π΅Π½ΠΈΡ ΠΈΠ»ΠΈ Π΄ΡΡΠ³ΠΈΠ΅ Π½Π΅ΠΏΡΠΈΡΡΠ½ΡΠ΅ ΡΠ²Π»Π΅Π½ΠΈΡ. ΠΠ΄Π½ΠΈ ΠΈΠ· Π½ΠΈΡ ΡΠ²Π»ΡΡΡΡΡ Π±Π΅Π·ΠΎΠΏΠ°ΡΠ½ΡΠΌΠΈ, Π° Π΄ΡΡΠ³ΠΈΠ΅ ΠΌΠΎΠ³ΡΡ ΠΏΠΎΡΡΠ΅Π±ΠΎΠ²Π°ΡΡ ΡΡΠΎΡΠ½ΠΎ ΠΎΠ±ΡΠ°ΡΠΈΡΡΡΡ ΠΊ Π³ΠΈΠ½Π΅ΠΊΠΎΠ»ΠΎΠ³Ρ.
ΠΡΠ΄Π΅Π»Π΅Π½ΠΈΡ
ΠΠ°ΠΊ ΠΏΡΠ°Π²ΠΈΠ»ΠΎ, ΠΏΠ΅ΡΠΈΠΎΠ΄ ΡΠΎ 2 ΠΏΠΎ 10 Π΄Π΅Π½Ρ ΠΏΠΎΡΠ»Π΅ ΠΏΡΠΎΡΠ΅Π΄ΡΡΡ Ρ Π°ΡΠ°ΠΊΡΠ΅ΡΠΈΠ·ΡΠ΅ΡΡΡ ΠΏΠΎΡΠ²Π»Π΅Π½ΠΈΠ΅ΠΌ Π½Π΅Π±ΠΎΠ»ΡΡΠΈΡ ΠΆΠΈΠ΄ΠΊΠΈΡ Π²ΡΠ΄Π΅Π»Π΅Π½ΠΈΠΉ. Π Π·Π°Π²ΠΈΡΠΈΠΌΠΎΡΡΠΈ ΠΎΡ ΡΠΎΡΡΠΎΡΠ½ΠΈΡ ΠΈ ΠΎΡΠΎΠ±Π΅Π½Π½ΠΎΡΡΠ΅ΠΉ ΠΎΡΠ³Π°Π½ΠΈΠ·ΠΌΠ°, ΠΌΠΎΠΆΠ΅Ρ Π½Π°Π±Π»ΡΠ΄Π°ΡΡΡΡ ΠΊΡΠΎΠ²ΡΠ½ΠΈΡΡΠΎΡΡΡ.ΠΠΎ ΠΏΡΠΎΡΠ΅ΡΡΠ²ΠΈΠΈ ΡΡΠΎΠ³ΠΎ ΠΏΠ΅ΡΠΈΠΎΠ΄Π° ΠΊΠΎΠ»ΠΈΡΠ΅ΡΡΠ²ΠΎ ΡΠ΅ΠΊΡΠ΅ΡΠΈΠΈ ΡΠ²Π΅Π»ΠΈΡΠΈΠ²Π°Π΅ΡΡΡ. ΠΡΠΎΠΌΠ΅ ΡΠΎΠ³ΠΎ, ΠΎΠ½Π° ΠΎΠΊΡΠ°ΡΠΈΠ²Π°Π΅ΡΡΡ Π² ΡΠΎΠ·ΠΎΠ²ΡΠΉ ΡΠ²Π΅Ρ. ΠΠ·Π½Π°ΡΠ°Π»ΡΠ½ΠΎ ΡΠ΅ΠΊΡΠ΅ΡΠΈΡ Π΄ΠΎΠ²ΠΎΠ»ΡΠ½ΠΎ ΠΆΠΈΠ΄ΠΊΠ°Ρ, Π½ΠΎ Π² ΠΏΠΎΡΠ»Π΅Π΄ΡΡΠ²ΠΈΠΈ ΠΌΠΎΠΆΠ΅Ρ ΡΡΠ°ΡΡ Π±ΠΎΠ»Π΅Π΅ Π²ΡΠ·ΠΊΠΎΠΉ. Π Π½Π΅ΠΉ ΠΌΠΎΠ³ΡΡ Π½Π°Π±Π»ΡΠ΄Π°ΡΡΡΡ ΠΏΡΠΈΠΌΠ΅ΡΠΈ ΠΊΡΠΎΠ²ΠΈ. ΠΠΎΡΠ»Π΅ ΡΡΠΎΠ³ΠΎ ΠΏΠΎΡΠ²Π»ΡΡΡΡΡ Π½Π΅ΠΎΠ±ΠΈΠ»ΡΠ½ΡΠ΅, Π³ΡΡΡΡΠ΅, Π±Π΅Π»ΡΠ΅ Π²ΡΠ΄Π΅Π»Π΅Π½ΠΈΡ. Π’Π°ΠΊΠΈΠ΅ Π²ΡΠ΄Π΅Π»Π΅Π½ΠΈΡ Π½Π°Π±Π»ΡΠ΄Π°ΡΡΡΡ ΠΎΡ 2 Π΄ΠΎ 10 Π΄Π½Π΅ΠΉ.
ΠΠΎΡΠ»Π΅ ΡΡΠΎΠΉ ΡΠ°Π·Ρ Π²ΡΠ΄Π΅Π»Π΅Π½ΠΈΡ ΡΡΠ°Π½ΠΎΠ²ΡΡΡΡ Π½Π΅ΠΎΠ±ΠΈΠ»ΡΠ½ΡΠΌΠΈ, Π³ΡΡΡΡΠΌΠΈ, ΠΊΠΎΡΠΈΡΠ½Π΅Π²ΠΎΠ³ΠΎ ΡΠ²Π΅ΡΠ°. ΠΠ»ΠΈΡΡΡΡ ΡΠ°Π·Π° ΡΡΠ°Π²Π½ΠΈΡΠ΅Π»ΡΠ½ΠΎ Π½Π΅Π΄ΠΎΠ»Π³ΠΎ, Π²ΡΠ΅Π³ΠΎ 7 Π΄Π½Π΅ΠΉ. ΠΡΠΎ ΠΏΠΎΡΠ»Π΅Π΄Π½ΠΈΠΉ ΡΠΈΠΏ Π²ΡΠ΄Π΅Π»Π΅Π½ΠΈΠΉ, ΠΊΠΎΡΠΎΡΡΠΉ ΠΌΠΎΠΆΠ΅Ρ Π½Π°Π±Π»ΡΠ΄Π°ΡΡΡΡ ΠΏΠΎΡΠ»Π΅ ΠΏΡΠΈΠΆΠΈΠ³Π°Π½ΠΈΡ. Π Π½ΠΎΡΠΌΠ΅ Π½ΠΈΠΊΠ°ΠΊΠΈΠ΅ Π΄ΡΡΠ³ΠΈΠ΅ ΡΠ²Π»Π΅Π½ΠΈΡ Π½Π°Π±Π»ΡΠ΄Π°ΡΡΡΡ Π½Π΅Π΄ΠΎΠ»ΠΆΠ½Ρ.
ΠΠ° Π»ΡΠ±ΠΎΠΌ ΠΈΠ· ΡΡΠΈΡ ΡΡΠ°ΠΏΠΎΠ² Ρ ΠΆΠ΅Π½ΡΠΈΠ½Ρ ΠΌΠΎΠ³ΡΡ Π½Π°Π±Π»ΡΠ΄Π°ΡΡΡΡ Π½Π΅Π±ΠΎΠ»ΡΡΠΈΠ΅ ΠΊΡΠΎΠ²ΡΠ½ΡΠ΅ ΠΏΡΠΈΠΌΠ΅ΡΠΈ.
ΠΡΠΎΠ±Π΅Π½Π½ΠΎΡΡΠΈ ΡΡΠ°ΠΏΠ° Π·Π°ΠΆΠΈΠ²Π»Π΅Π½ΠΈΡ
ΠΡΠΎΠ±Π΅Π½Π½ΠΎΡΡΡΡ ΠΏΡΠΎΡΠ΅ΡΡΠ° Π·Π°ΠΆΠΈΠ²Π»Π΅Π½ΠΈΡ Π²ΡΡΡΡΠΏΠ°Π΅Ρ Π½Π°Π»ΠΈΡΠΈΠ΅ Π² Π²ΡΠ΄Π΅Π»Π΅Π½ΠΈΡΡ
Π½Π΅Π·Π½Π°ΡΠΈΡΠ΅Π»ΡΠ½ΡΡ
ΡΠ΅ΠΌΠ½ΡΡ
ΡΡΠ°Π³ΠΌΠ΅Π½ΡΠΎΠ². ΠΡΠΈ ΡΡΠ°Π³ΠΌΠ΅Π½ΡΡ ΠΏΡΠ΅Π΄ΡΡΠ°Π²Π»ΡΡΡ ΡΠΎΠ±ΠΎΠΉ ΡΡΡΡΠΏ. ΠΠΎΠ»Π½ΠΎΠ΅ ΠΎΡΠΏΠ°Π΄Π΅Π½ΠΈΠ΅ ΡΡΡΡΠΏΠ° ΠΏΡΠΎΠΈΡΡ
ΠΎΠ΄ΠΈΡ Π½Π° 8-20 Π΄Π΅Π½Ρ ΠΏΠΎΡΠ»Π΅ ΠΏΡΠΎΡΠ΅Π΄ΡΡΡ. Π ΡΡΠΎΡ ΠΏΠ΅ΡΠΈΠΎΠ΄ Ρ ΠΆΠ΅Π½ΡΠΈΠ½Ρ ΠΌΠΎΠΆΠ΅Ρ Π½Π°Π±Π»ΡΠ΄Π°ΡΡΡΡ Π½Π΅ΡΠΈΠ»ΡΠ½ΠΎΠ΅ ΠΊΡΠΎΠ²ΠΎΡΠ΅ΡΠ΅Π½ΠΈΠ΅. ΠΠ°ΠΊ ΠΏΡΠ°Π²ΠΈΠ»ΠΎ, ΠΎΠ½ΠΎ Π΄ΠΎΠ»ΠΆΠ½ΠΎ ΠΏΡΠ΅ΠΊΡΠ°ΡΠΈΡΡΡΡ Π² ΡΠ΅ΡΠ΅Π½ΠΈΠ΅ Π½Π΅ΡΠΊΠΎΠ»ΡΠΊΠΈΡ
ΡΠ°ΡΠΎΠ², ΠΎΠ΄Π½Π°ΠΊΠΎ, Π΅ΡΠ»ΠΈ ΡΡΠΎΠ³ΠΎ Π½Π΅ ΠΏΡΠΎΠΈΠ·ΠΎΡΠ»ΠΎ, ΡΠΎ ΡΡΠΎΠΈΡ ΠΎΠ±ΡΠ°ΡΠΈΡΡΡΡ ΠΊ Π²ΡΠ°ΡΡ. ΠΠ»ΠΈΡΠ΅Π»ΡΠ½ΠΎ ΠΊΡΠΎΠ²ΠΎΡΠ΅ΡΠ΅Π½ΠΈΠ΅ ΠΌΠΎΠΆΠ΅Ρ Π±ΡΡΡ Π²ΡΠ·Π²Π°Π½ΠΎ ΠΏΠΎΠ²ΡΠ΅ΠΆΠ΄Π΅Π½ΠΈΠ΅ΠΌ ΡΠΎΡΡΠ΄Π°.Π Π½ΠΎΡΠΌΠ΅ ΠΎΠ±ΡΠ΅ΠΌ Π²ΡΠ΄Π΅Π»Π΅Π½ΠΈΠΉ Π½Π° ΡΡΠ°ΠΏΠ΅ Π·Π°ΠΆΠΈΠ²Π»Π΅Π½ΠΈΡ Π΄ΠΎΠ»ΠΆΠ΅Π½ ΡΠΎΠΎΡΠ²Π΅ΡΡΡΠ²ΠΎΠ²Π°ΡΡ ΠΌΠ΅Π½ΡΡΡΡΠ°Π»ΡΠ½ΠΎΠΌΡ. ΠΠ΅ΡΡ ΠΏΡΠΎΡΠ΅ΡΡ Π·Π°ΠΆΠΈΠ²Π»Π΅Π½ΠΈΡ ΠΌΠΎΠ³ΡΡ Π½Π°Π±Π»ΡΠ΄Π°ΡΡΡΡ Π±ΠΎΠ»ΠΈ. ΠΡΠΎ Π°Π±ΡΠΎΠ»ΡΡΠ½ΠΎ Π΅ΡΡΠ΅ΡΡΠ²Π΅Π½Π½Π°Ρ ΡΠ΅Π°ΠΊΡΠΈΡ ΠΎΡΠ³Π°Π½ΠΈΠ·ΠΌΠ° Π½Π° ΠΏΡΠΎΡΠ΅Π΄ΡΡΡ.
ΠΡΠ»ΠΈ ΠΏΠΎΡΠ»Π΅ ΠΏΡΠΎΡ ΠΎΠΆΠ΄Π΅Π½ΠΈΡ ΠΏΡΠΎΡΠ΅Π΄ΡΡΡ Π½Π°Π±Π»ΡΠ΄Π°ΡΡΡΡ Π΄ΠΎΠ²ΠΎΠ»ΡΠ½ΠΎ ΠΎΠ±ΠΈΠ»ΡΠ½ΡΠ΅ Π²ΡΠ΄Π΅Π»Π΅Π½ΠΈΡ ΠΊΡΠΎΠ²ΡΠ½ΠΎΠ³ΠΎ Ρ Π°ΡΠ°ΠΊΡΠ΅ΡΠ°, ΠΏΠΎΠ²ΡΡΠ΅Π½Π½Π°Ρ ΡΠ΅ΠΌΠΏΠ΅ΡΠ°ΡΡΡΠ° ΠΈ ΡΠΈΠ»ΡΠ½ΡΠ΅ Π±ΠΎΠ»ΠΈ ΡΡΠΎΠΈΡ Π½Π΅ΠΌΠ΅Π΄Π»Π΅Π½Π½ΠΎ ΠΎΠ±ΡΠ°ΡΠΈΡΡΡΡ ΠΊ Π²ΡΠ°ΡΡ. ΠΡΠΎ ΠΌΠΎΠΆΠ΅Ρ ΡΠ²ΠΈΠ΄Π΅ΡΠ΅Π»ΡΡΡΠ²ΠΎΠ²Π°ΡΡ ΠΎ ΡΠ°Π·Π²ΠΈΡΠΈΠΈ ΠΎΡΠ»ΠΎΠΆΠ½Π΅Π½ΠΈΡ Π² ΡΠΎΡΠΌΠ΅ ΠΌΠ°ΡΠΎΡΠ½ΠΎΠ³ΠΎ ΠΊΡΠΎΠ²ΠΎΡΠ΅ΡΠ΅Π½ΠΈΡ.
ΠΠΎΠ³Π΄Π° ΡΡΠΎΠΈΡ ΠΎΠ±ΡΠ°ΡΠΈΡΡΡΡ ΠΊ Π²ΡΠ°ΡΡ
ΠΡΠΎΡΠ΅ΡΡ Π·Π°ΠΆΠΈΠ²Π»Π΅Π½ΠΈΡ Π²ΡΠ΅Π³Π΄Π° Π΄ΠΎΠ²ΠΎΠ»ΡΠ½ΠΎ ΡΠΏΠ΅ΡΠΈΡΠΈΡΠ΅ΡΠΊΠΈΠΉ ΡΡΠ°ΠΏ. Π£ ΠΊΠ°ΠΆΠ΄ΠΎΠΉ ΠΆΠ΅Π½ΡΠΈΠ½Ρ Π² Π·Π°Π²ΠΈΡΠΈΠΌΠΎΡΡΠΈ ΠΎΡ Π½Π΅ΠΊΠΎΡΠΎΡΡΡ ΠΎΡΠΎΠ±Π΅Π½Π½ΠΎΡΡΠ΅ΠΉ ΠΎΠ½ ΠΌΠΎΠΆΠ΅Ρ ΠΏΡΠΎΡ ΠΎΠ΄ΠΈΡΡ ΠΏΠΎ-ΡΠ°Π·Π½ΠΎΠΌΡ. ΠΠ΄Π½Π°ΠΊΠΎ Π΅ΡΠ»ΠΈ Ρ Π²Π°Ρ Π±ΠΎΠ»ΠΈΡ ΠΆΠΈΠ²ΠΎΡ ΠΈΠ»ΠΈ ΠΆΠ΅ Π½Π°Π±Π»ΡΠ΄Π°ΡΡΡΡ Π½Π΅Π΅ΡΡΠ΅ΡΡΠ²Π΅Π½Π½ΡΠ΅ ΡΠ²Π»Π΅Π½ΠΈΡ ΡΡΠΎΠΈΡ ΠΎΠ±ΡΠ°ΡΠΈΡΡΡΡ ΠΊ ΡΠΏΠ΅ΡΠΈΠ°Π»ΠΈΡΡΡ.
ΠΠ°ΠΊ ΠΏΡΠ°Π²ΠΈΠ»ΠΎ, ΠΆΠΈΠ²ΠΎΡ ΠΎΠ΄Π½Π° ΠΈΠ· Π½Π°ΠΈΠ±ΠΎΠ»Π΅Π΅ Π·Π½Π°ΡΠΈΠΌΡΡ ΠΎΠ±Π»Π°ΡΡΠ΅ΠΉ Π² ΠΏΡΠΎΡΠ΅ΡΡΠ΅ Π·Π°ΠΆΠΈΠ²Π»Π΅Π½ΠΈΡ. ΠΠΎΠ·ΠΌΠΎΠΆΠ½ΡΠ΅ Π±ΠΎΠ»ΠΈ Π±ΡΠ΄ΡΡ Π½Π°Π±Π»ΡΠ΄Π°ΡΡΡΡ ΠΈΠΌΠ΅Π½Π½ΠΎ Π² ΡΡΠΎΠΉ ΠΎΠ±Π»Π°ΡΡΠΈ. ΠΠΎΡΡΠΎΠΌΡ ΠΆΠΈΠ²ΠΎΡ ΡΡΠΎΠΈΡ ΠΊΠΎΠ½ΡΡΠΎΠ»ΠΈΡΠΎΠ²Π°ΡΡ Π² ΡΠ΅ΡΠ΅Π½ΠΈΠ΅ 20 Π΄Π½Π΅ΠΉ ΠΏΠΎΡΠ»Π΅ ΠΏΡΠΎΡΠ΅Π΄ΡΡΡ. ΠΠΎΠ»ΠΈ Π² ΡΡΠΎΠΉ ΠΎΠ±Π»Π°ΡΡΠΈ ΠΌΠΎΠ³ΡΡ Π±ΡΡΡ ΡΠ²ΡΠ·Π°Π½Ρ Ρ Π΅ΡΡΠ΅ΡΡΠ²Π΅Π½Π½ΡΠΌ ΠΏΡΠΎΡΠ΅ΡΡΠΎΠΌ Π·Π°ΠΆΠΈΠ²Π»Π΅Π½ΠΈΡ. ΠΠ΄Π½Π°ΠΊΠΎ Π½Π΅ΡΠ΅Π΄ΠΊΠΎ Π±ΠΎΠ»ΠΈ ΠΌΠΎΠ³ΡΡ ΡΠ²ΠΈΠ΄Π΅ΡΠ΅Π»ΡΡΡΠ²ΠΎΠ²Π°ΡΡ ΠΎ ΡΠ°Π·Π²ΠΈΡΠΈΠΈ ΠΎΡΠ»ΠΎΠΆΠ½Π΅Π½ΠΈΠΉ.ΠΠΎΠ΄Π²ΠΎΠ΄Ρ ΠΈΡΠΎΠ³, ΠΌΠΎΠΆΠ½ΠΎ ΡΠΊΠ°Π·Π°ΡΡ, ΡΡΠΎ ΡΡΠΎΠ·ΠΈΡ ΡΠ΅ΠΉΠΊΠΈ ΠΌΠ°ΡΠΊΠΈ Π·Π°Π±ΠΎΠ»Π΅Π²Π°Π½ΠΈΠ΅ Π΄ΠΎΠ²ΠΎΠ»ΡΠ½ΠΎ ΡΠΏΠ΅ΡΠΈΡΠΈΡΠ΅ΡΠΊΠΎΠ΅. ΠΠ½Π° ΠΌΠΎΠΆΠ΅Ρ ΠΏΡΠΎΡΠ²Π»ΡΡΡΡΡ Π² Π½Π΅ΡΠΊΠΎΠ»ΡΠΊΠΈΡ ΡΠΎΡΠΌΠ°Ρ ΠΈ, ΠΊΠ°ΠΊ ΠΏΡΠ°Π²ΠΈΠ»ΠΎ, Π½ΠΈ ΠΎΠ΄Π½Π° ΠΈΠ· Π½ΠΈΡ Π½Π΅ Π²ΡΠ·ΡΠ²Π°Π΅Ρ ΡΠΏΠ΅ΡΠΈΡΠΈΡΠ΅ΡΠΊΠΈΠ΅ ΡΠΈΠΌΠΏΡΠΎΠΌΡ. ΠΠΎΠ²ΠΎΠ»ΡΠ½ΠΎ ΡΠ°ΡΡΠΎ Ρ ΠΆΠ΅Π½ΡΠΈΠ½ ΠΏΡΠΈ ΡΡΠΎΠ·ΠΈΠΈ ΠΏΠΎ Π½Π΅ΠΏΠΎΠ½ΡΡΠ½ΡΠΌ ΠΏΡΠΈΡΠΈΠ½Π°ΠΌ ΠΆΠΈΠ²ΠΎΡ ΡΡΠ°Π½ΠΎΠ²ΠΈΡΡΡ ΡΠΏΠΈΡΠ΅Π½ΡΡΠΎΠΌ Π±ΠΎΠ»ΠΈ, ΠΎΠ΄Π½Π°ΠΊΠΎ, ΡΡΠΎ Π²ΠΏΠΎΠ»Π½Π΅ Π΅ΡΡΠ΅ΡΡΠ²Π΅Π½Π½ΠΎΠ΅ ΡΠ²Π»Π΅Π½ΠΈΠ΅. ΠΠ»ΠΈΡΡΡ Π½Π° ΡΠ°Π·Π²ΠΈΡΠΈΠ΅ ΡΡΠΎΠ³ΠΎ Π·Π°Π±ΠΎΠ»Π΅Π²Π°Π½ΠΈΡ ΠΌΠΎΠΆΠ΅Ρ Π΄ΠΎΡΡΠ°ΡΠΎΡΠ½ΠΎ Π±ΠΎΠ»ΡΡΠΎΠ΅ ΡΠΈΡΠ»ΠΎ ΡΠ°Π·Π»ΠΈΡΠ½ΡΡ ΡΠ°ΠΊΡΠΎΡΠΎΠ². ΠΠ΄Π½Π°ΠΊΠΎ ΡΡΠΎΠ±Ρ Π½Π΅ Π²ΡΡΡΡΠΏΠΈΠ»ΠΎ Π² ΡΠΎΠ»ΠΈ ΠΏΡΠΈΡΠΈΠ½Ρ Π΅Π³ΠΎ ΡΠ°Π·Π²ΠΈΡΠΈΡ Π·Π°Π±ΠΎΠ»Π΅Π²Π°Π½ΠΈΠ΅ Π½ΡΠΆΠ½ΠΎ ΠΎΠ±ΡΠ·Π°ΡΠ΅Π»ΡΠ½ΠΎ Π»Π΅ΡΠΈΡΡ.
ΠΠ΄ΠΈΠ½ ΠΈΠ· ΡΡΡΠ΅ΠΊΡΠΈΠ²Π½Π΅ΠΉΡΠΈΡ ΠΌΠ΅ΡΠΎΠ΄ΠΎΠ² Π²ΠΎΠ·Π΄Π΅ΠΉΡΡΠ²ΠΈΡ β ΠΏΡΠΈΠΆΠΈΠ³Π°Π½ΠΈΠ΅ Π»Π°Π·Π΅ΡΠΎΠΌ. Π’Π°ΠΊΠΎΠ΅ Π²ΠΎΠ·Π΄Π΅ΠΉΡΡΠ²ΠΈΠ΅ ΠΏΠΎΠΌΠΎΠ³Π°Π΅Ρ ΡΡΡΡΠ°Π½ΠΈΡΡ Π½Π΅ ΡΠΎΠ»ΡΠΊΠΎ ΡΡΠΎΠ·ΠΈΡ, Π½ΠΎ ΠΈ Π²ΠΎΠ·ΠΌΠΎΠΆΠ½ΠΎΠ΅ Π²ΠΎΡΠΏΠ°Π»Π΅Π½ΠΈΠ΅.
ΠΠΎ ΠΏΡΠΎΡΠ΅ΡΡ Π·Π°ΠΆΠΈΠ²Π»Π΅Π½ΠΈΡ ΠΏΠΎΡΠ»Π΅ ΡΡΠΎΠΉ ΠΏΡΠΎΡΠ΅Π΄ΡΡΡ Π΄ΠΎΠ²ΠΎΠ»ΡΠ½ΠΎ Π΄ΠΎΠ»Π³ΠΈΠΉ ΠΈ Π±ΠΎΠ»Π΅Π·Π½Π΅Π½Π½ΡΠΉ, ΠΏΠΎΡΡΠΎΠΌΡ Π² ΡΡΠΎΡ ΠΏΠ΅ΡΠΈΠΎΠ΄ Π½Π΅ΠΎΠ±Ρ ΠΎΠ΄ΠΈΠΌΠΎ ΡΠ΄Π΅Π»ΡΡΡ Π΄ΠΎΠΏΠΎΠ»Π½ΠΈΡΠ΅Π»ΡΠ½ΠΎΠ΅ Π²Π½ΠΈΠΌΠ°Π½ΠΈΠ΅ ΡΠΎΡΡΠΎΡΠ½ΠΈΡ ΡΠ²ΠΎΠ΅Π³ΠΎ ΠΎΡΠ³Π°Π½ΠΈΠ·ΠΌΠ°. ΠΠΎ Π²ΡΠ΅ΠΌΡ Π·Π°ΠΆΠΈΠ²Π»Π΅Π½ΠΈΡ ΠΌΠΎΠ³ΡΡ Π½Π°Π±Π»ΡΠ΄Π°ΡΡΡΡ ΡΠ°Π·Π»ΠΈΡΠ½ΠΎΠ³ΠΎ ΡΠΎΠ΄Π° Π²ΡΠ΄Π΅Π»Π΅Π½ΠΈΡ. ΠΠ°ΠΊ ΠΏΡΠ°Π²ΠΈΠ»ΠΎ, Π² Π½ΠΎΡΠΌΠ΅ ΡΡΠΎΡ ΠΏΡΠΎΡΠ΅ΡΡ Ρ Π°ΡΠ°ΠΊΡΠ΅ΡΠΈΠ·ΡΠ΅ΡΡΡ ΠΏΠΎΡΠ²Π»Π΅Π½ΠΈΠ΅ΠΌ 3 ΡΠΈΠΏΠΎΠ² Π²ΡΠ΄Π΅Π»Π΅Π½ΠΈΠΉ. ΠΠΎ, Π΅ΡΠ»ΠΈ Ρ Π²Π°Ρ ΠΏΠΎΡΠ²ΠΈΠ»ΠΈΡΡ Π½Π΅Ρ Π°ΡΠ°ΠΊΡΠ΅ΡΠ½ΡΠ΅ Π΄Π»Ρ ΡΡΠΎΠ³ΠΎ ΠΏΡΠΎΡΠ΅ΡΡΠ° ΡΠ²Π»Π΅Π½ΠΈΡ, ΡΠΎ ΡΡΠΎΠΈΡ ΡΡΠ°Π·Ρ ΠΆΠ΅ ΠΎΠ±ΡΠ°ΡΠΈΡΡΡΡ ΠΊ Π²ΡΠ°ΡΡ.
Π Π΅ΠΊΠΎΠΌΠ΅Π½Π΄ΡΠ΅ΠΌ ΠΏΡΠΎΡΠΈΡΠ°ΡΡ:
ΠΠ²ΡΠΎΡ ΡΡΠ°ΡΡΠΈ:
ΠΠΎΠ»ΡΡΠΈΡΡ Π±Π΅ΡΠΏΠ»Π°ΡΠ½ΡΡ ΠΊΠΎΠ½ΡΡΠ»ΡΡΠ°ΡΠΈΡΠΡΠ΅Π½ΠΈΡΡ ΡΡΠ°ΡΡΡ:
matka03.ru
Π‘Π²Π΅ΡΠΈ ΠΏΠΎΡΠ»Π΅ ΠΏΡΠΈΠΆΠΈΠ³Π°Π½ΠΈΡ ΡΡΠΎΠ·ΠΈΠΈ
Π‘Π²Π΅ΡΠΈ ΡΠ²Π»ΡΡΡΡΡ ΠΎΠ΄Π½ΠΎΠΉ ΠΈΠ· ΡΠ°ΠΌΡΡ ΡΠ°ΡΡΠΎ ΠΈΡΠΏΠΎΠ»ΡΠ·ΡΠ΅ΠΌΡΡ Π»Π΅ΠΊΠ°ΡΡΡΠ²Π΅Π½Π½ΡΡ ΡΠΎΡΠΌ Π² Π³ΠΈΠ½Π΅ΠΊΠΎΠ»ΠΎΠ³ΠΈΠΈ. Π‘Π²Π΅ΡΠΈ ΠΏΠΎΠ·Π²ΠΎΠ»ΡΡΡ Π°ΠΊΡΠΈΠ²Π½ΠΎΠΌΡ Π²Π΅ΡΠ΅ΡΡΠ²Ρ Π΄Π΅ΠΉΡΡΠ²ΠΎΠ²Π°ΡΡ Π²Π±Π»ΠΈΠ·ΠΈ ΠΏΠΎΡΠ°ΠΆΡΠ½Π½ΠΎΠ³ΠΎ ΠΎΡΠ³Π°Π½Π° ΠΈΠ»ΠΈ ΡΠΊΠ°Π½Π΅ΠΉ, Π½Π΅ ΠΎΠΊΠ°Π·ΡΠ²Π°Ρ ΠΏΠ°Π³ΡΠ±Π½ΠΎΠ³ΠΎ Π²Π»ΠΈΡΠ½ΠΈΡ Π½Π° ΠΆΠ΅Π»ΡΠ΄ΠΎΡΠ½ΠΎ-ΠΊΠΈΡΠ΅ΡΠ½ΡΠΉ ΡΡΠ°ΠΊΡ. ΠΠΎΠ²ΠΎΠ»ΡΠ½ΠΎ ΡΠ°ΡΡΠΎ ΡΠ²Π΅ΡΠΈ ΠΈΡΠΏΠΎΠ»ΡΠ·ΡΡΡΡΡ ΠΏΡΠΈ Π»Π΅ΡΠ΅Π½ΠΈΠΈ ΡΠΎΠ½ΠΎΠ²ΡΡ Π±ΠΎΠ»Π΅Π·Π½Π΅ΠΉ, Π² ΡΠ°ΡΡΠ½ΠΎΡΡΠΈ, ΡΡΠΎΠ·ΠΈΠΈ ΡΠ΅ΠΉΠΊΠΈ ΠΌΠ°ΡΠΊΠΈ.
Π€ΠΎΠ½ΠΎΠ²ΡΠ΅ Π·Π°Π±ΠΎΠ»Π΅Π²Π°Π½ΠΈΡ ΡΠ΅ΠΉΠΊΠΈ ΠΌΠ°ΡΠΊΠΈ Π² ΡΠΎΠ²ΡΠ΅ΠΌΠ΅Π½Π½ΠΎΠΉ Π³ΠΈΠ½Π΅ΠΊΠΎΠ»ΠΎΠ³ΠΈΠΈ Π·Π°Π½ΠΈΠΌΠ°ΡΡ ΠΎΡΠΎΠ±ΠΎΠ΅ ΠΌΠ΅ΡΡΠΎ. Π ΠΏΠ΅ΡΠ²ΡΡ ΠΎΡΠ΅ΡΠ΅Π΄Ρ, ΡΡΠΎ ΡΠ²ΡΠ·Π°Π½ΠΎ Ρ ΠΈΡ ΡΠ°ΡΠΏΡΠΎΡΡΡΠ°Π½ΡΠ½Π½ΠΎΡΡΡΡ ΠΈ ΠΎΠ±ΡΠΈΠΌ ΠΊΠΎΠ»ΠΈΡΠ΅ΡΡΠ²ΠΎΠΌ, ΠΊΠΎΡΠΎΡΠΎΠ΅ Π½Π΅ΡΠΊΠ»ΠΎΠ½Π½ΠΎ ΡΠ°ΡΡΡΡ. ΠΠ΅Π»ΡΠ·Ρ ΡΠ°ΠΊΠΆΠ΅ Π·Π°Π±ΡΠ²Π°ΡΡ ΠΎ ΡΠΎΠΌ, ΡΡΠΎ ΠΌΠ½ΠΎΠ³ΠΈΠ΅ Π΄ΠΎΠ±ΡΠΎΠΊΠ°ΡΠ΅ΡΡΠ²Π΅Π½Π½ΡΠ΅ ΠΏΠ°ΡΠΎΠ»ΠΎΠ³ΠΈΠΈ ΠΏΡΠΈ ΠΎΡΡΡΡΡΡΠ²ΠΈΠΈ Π»Π΅ΡΠ΅Π½ΠΈΡ ΠΌΠΎΠ³ΡΡ ΡΡΠ°Π½ΡΡΠΎΡΠΌΠΈΡΠΎΠ²Π°ΡΡΡΡ Π² ΠΏΡΠ΅Π΄ΡΠ°ΠΊΠΎΠ²ΡΠ΅ ΠΏΡΠΎΡΠ΅ΡΡΡ ΠΈ ΡΠ°ΠΊ.
ΠΠ΄Π½ΠΎΠΉ ΠΈΠ· ΡΠ°ΡΡΠΎ Π΄ΠΈΠ°Π³Π½ΠΎΡΡΠΈΡΡΠ΅ΠΌΡΡ ΠΏΠ°ΡΠΎΠ»ΠΎΠ³ΠΈΠΉ ΡΠ²Π»ΡΠ΅ΡΡΡ ΡΡΠΎΠ·ΠΈΡ ΡΠ΅ΠΉΠΊΠΈ ΠΌΠ°ΡΠΊΠΈ. Π‘ Π΄Π°Π½Π½ΡΠΌ Π΄ΠΈΠ°Π³Π½ΠΎΠ·ΠΎΠΌ ΡΡΠ°Π»ΠΊΠΈΠ²Π°ΡΡΡΡ Π±ΠΎΠ»Π΅Π΅ 50% ΠΆΠ΅Π½ΡΠΈΠ½ Π² ΡΠ°Π·Π½ΠΎΠΌ Π²ΠΎΠ·ΡΠ°ΡΡΠ΅. Π Π΄Π΅ΠΉΡΡΠ²ΠΈΡΠ΅Π»ΡΠ½ΠΎΡΡΠΈ Π΄ΠΈΠ°Π³Π½ΠΎΠ· Β«ΡΡΠΎΠ·ΠΈΡΒ» Π½Π΅ ΡΠΎΠ²ΡΠ΅ΠΌ Π²Π΅ΡΠ½ΡΠΉ, ΡΠ°ΠΊ ΠΊΠ°ΠΊ Π½Π΅ ΠΎΡΡΠ°ΠΆΠ°Π΅Ρ Π²ΡΠ΅ ΠΈΠ·ΠΌΠ΅Π½Π΅Π½ΠΈΡ, ΠΊΠΎΡΠΎΡΡΠ΅ ΠΏΡΠΎΠΈΡΡ ΠΎΠ΄ΡΡ Π² ΡΠ΅ΠΉΠΊΠ΅ ΠΌΠ°ΡΠΊΠΈ. Π’Π΅ΡΠΌΠΈΠ½ ΠΎΠ±ΡΠ΅Π΄ΠΈΠ½ΡΠ΅Ρ Π½Π΅ΡΠΊΠΎΠ»ΡΠΊΠΎ ΡΠΎΡΡΠΎΡΠ½ΠΈΠΉ ΡΠ΅ΠΉΠΊΠΈ ΠΌΠ°ΡΠΊΠΈ, ΠΊΠΎΡΠΎΡΡΠ΅ ΡΠ°Π·Π»ΠΈΡΠ°ΡΡΡΡ ΡΡΠΈΠΎΠ»ΠΎΠ³ΠΈΠ΅ΠΉ ΠΈ ΠΏΠ°ΡΠΎΠ³Π΅Π½Π΅Π·ΠΎΠΌ.

ΠΠΎΠ³Π΄Π° Π½Π° ΡΠ΅ΠΉΠΊΠ΅ ΠΌΠ°ΡΠΊΠΈ ΠΏΠΎΡΠ²Π»ΡΠ΅ΡΡΡ Π΄Π΅ΡΠ΅ΠΊΡ Π² Π²ΠΈΠ΄Π΅ ΠΏΡΡΠ½Π° ΠΈΠ»ΠΈ ΡΠ°Π½Ρ, Π³ΠΎΠ²ΠΎΡΡΡ ΠΎ ΡΠ°Π·Π²ΠΈΡΠΈΠΈ ΡΡΠΎΠ·ΠΈΠΈ ΡΠ΅ΠΉΠΊΠΈ ΠΌΠ°ΡΠΊΠΈ. ΠΡΠΎ ΡΠΎΠ½ΠΎΠ²ΠΎΠ΅ Π΄ΠΎΠ±ΡΠΎΠΊΠ°ΡΠ΅ΡΡΠ²Π΅Π½Π½ΠΎΠ΅ ΡΠΎΡΡΠΎΡΠ½ΠΈΠ΅, ΠΊΠΎΡΠΎΡΠΎΠ΅ Π½Π΅ Π²ΡΠ΅Π³Π΄Π° Π½ΡΠΆΠ΄Π°Π΅ΡΡΡ Π² Π»Π΅ΡΠ΅Π½ΠΈΠΈ. ΠΠ»Ρ ΡΠΎΠ³ΠΎ ΡΡΠΎΠ±Ρ ΠΎΠΏΡΠ΅Π΄Π΅Π»ΠΈΡΡΡΡ Ρ ΡΠ°ΠΊΡΠΈΠΊΠΎΠΉ Π»Π΅ΡΠ΅Π½ΠΈΡ, ΠΆΠ΅Π½ΡΠΈΠ½Π° ΠΏΡΠΎΡ ΠΎΠ΄ΠΈΡ ΡΡΠ°ΡΠ΅Π»ΡΠ½ΠΎΠ΅ ΠΎΠ±ΡΠ»Π΅Π΄ΠΎΠ²Π°Π½ΠΈΠ΅. ΠΠΈΠ°Π³Π½ΠΎΡΡΠΈΠΊΠ° Π½Π΅ΠΎΠ±Ρ ΠΎΠ΄ΠΈΠΌΠ° ΡΠ°ΠΊΠΆΠ΅ Ρ ΡΠ΅Π»ΡΡ ΠΈΡΠΊΠ»ΡΡΠ΅Π½ΠΈΡ ΠΎΠΏΠ°ΡΠ½ΡΡ Π±ΠΎΠ»Π΅Π·Π½Π΅ΠΉ, Π½Π°ΠΏΡΠΈΠΌΠ΅Ρ, Π·Π»ΠΎΠΊΠ°ΡΠ΅ΡΡΠ²Π΅Π½Π½ΠΎΠΉ ΠΎΠΏΡΡ ΠΎΠ»ΠΈ, ΠΈΠ»ΠΈ ΠΏΡΠ΅Π΄ΡΠ°ΠΊΠΎΠ²ΠΎΠ³ΠΎ ΠΏΡΠΎΡΠ΅ΡΡΠ° β Π΄ΠΈΡΠΏΠ»Π°Π·ΠΈΠΈ.
ΠΡΠΎΠ³ΡΠ΅ΡΡΠΈΡΠΎΠ²Π°Π½ΠΈΠ΅ ΡΡΠΎΠ·ΠΈΠΈ, ΠΊΠ°ΠΊ ΠΈ Π΅Ρ Π²Π½Π΅ΡΠ½ΠΈΠΉ Π²ΠΈΠ΄, Π·Π°Π²ΠΈΡΠΈΡ ΠΎΡ ΠΊΠ»ΠΈΠ½ΠΈΡΠ΅ΡΠΊΠΎΠΉ ΡΠ°Π·Π½ΠΎΠ²ΠΈΠ΄Π½ΠΎΡΡΠΈ ΡΡΠΎΠ·ΠΈΠΈ.
ΠΠΏΡΠ΅Π΄Π΅Π»Π΅Π½ΠΈΠ΅ Π²ΠΈΠ΄Π° ΡΡΠΎΠ·ΠΈΠ²Π½ΠΎΠ³ΠΎ Π΄Π΅ΡΠ΅ΠΊΡΠ° ΡΠ°ΠΊΠΆΠ΅ Π½Π΅ΠΎΠ±Ρ ΠΎΠ΄ΠΈΠΌΠΎ Π΄Π»Ρ Π½Π°Π·Π½Π°ΡΠ΅Π½ΠΈΡ Π»Π΅ΡΠ΅Π½ΠΈΡ, ΠΊΠΎΡΠΎΡΠΎΠ΅ ΠΌΠΎΠΆΠ΅Ρ Π±ΡΡΡ ΠΊΠ°ΠΊ ΠΊΠΎΠ½ΡΠ΅ΡΠ²Π°ΡΠΈΠ²Π½ΡΠΌ, ΡΠ°ΠΊ ΠΈ Ρ ΠΈΡΡΡΠ³ΠΈΡΠ΅ΡΠΊΠΈΠΌ. ΠΠ°ΠΊ ΠΏΡΠ°Π²ΠΈΠ»ΠΎ, Π²ΡΠ°ΡΠΈ ΠΏΡΠΈΠΌΠ΅Π½ΡΡΡ ΠΊΠΎΠΌΠΏΠ»Π΅ΠΊΡΠ½ΡΠΉ ΠΏΠΎΠ΄Ρ ΠΎΠ΄, ΠΊΠΎΡΠΎΡΡΠΉ ΠΏΠΎΠ΄ΡΠ°Π·ΡΠΌΠ΅Π²Π°Π΅Ρ ΠΈΡΠΏΠΎΠ»ΡΠ·ΠΎΠ²Π°Π½ΠΈΠ΅ ΠΏΡΠΈΠΆΠΈΠ³Π°Π½ΠΈΡ ΠΈ ΡΠ°Π·Π»ΠΈΡΠ½ΡΡ ΡΠ²Π΅ΡΠ΅ΠΉ.
ΠΡΠΎΠ·ΠΈΡ ΠΌΠΎΠΆΠ΅Ρ ΠΏΡΠΎΡΠ²Π»ΡΡΡΡΡ Π² Π½Π΅ΡΠΊΠΎΠ»ΡΠΊΠΈΡ ΡΠΎΡΠΌΠ°Ρ .
- ΠΡΡΠΈΠ½Π½Π°Ρ ΡΡΠΎΠ·ΠΈΡ ΠΏΠΎΡΠ²Π»ΡΠ΅ΡΡΡ, ΠΊΠΎΠ³Π΄Π° ΠΏΠΎΠΊΡΠΎΠ²Π½ΡΠΉ ΡΠΏΠΈΡΠ΅Π»ΠΈΠΉ ΠΏΠΎΠ²ΡΠ΅ΠΆΠ΄Π°Π΅ΡΡΡ ΠΈΠ·-Π·Π° Π½Π΅Π³Π°ΡΠΈΠ²Π½ΠΎΠ³ΠΎ Π²Π»ΠΈΡΠ½ΠΈΡ ΠΏΠΎΠ²ΡΠ΅ΠΆΠ΄Π°ΡΡΠΈΡ ΡΠ°ΠΊΡΠΎΡΠΎΠ². Π’Π°ΠΊΠΎΠΉ Π΄Π΅ΡΠ΅ΠΊΡ ΠΏΡΠ΅Π΄ΡΡΠ°Π²Π»ΡΠ΅Ρ ΡΠΎΠ±ΠΎΠΉ ΡΠ·Π²Ρ ΠΈΠ»ΠΈ ΡΠ°Π½Π΅Π²ΡΡ ΠΏΠΎΠ²Π΅ΡΡ Π½ΠΎΡΡΡ, Π·Π°ΡΡΠ³ΠΈΠ²Π°ΡΡΡΡΡΡ Π² ΡΠ΅ΡΠ΅Π½ΠΈΠ΅ Π΄Π΅ΡΡΡΠΈ β ΡΠ΅ΡΡΡΠ½Π°Π΄ΡΠ°ΡΠΈ Π΄Π½Π΅ΠΉ.
- ΠΡΠ΅Π²Π΄ΠΎΡΡΠΎΠ·ΠΈΡ. Π ΠΌΠ΅Π΄ΠΈΡΠΈΠ½ΡΠΊΠΎΠΉ Π»ΠΈΡΠ΅ΡΠ°ΡΡΡΠ΅ ΡΠ°ΡΠ΅ Π²ΡΡΡΠ΅ΡΠ°Π΅ΡΡΡ ΡΠ΅ΡΠΌΠΈΠ½ Β«ΡΠΊΡΠΎΠΏΠΈΡΒ», ΠΎΠ·Π½Π°ΡΠ°ΡΡΠΈΠΉ Π·Π°ΠΌΠ΅ΡΠ΅Π½ΠΈΠ΅ ΠΏΠ»ΠΎΡΠΊΠΈΡ ΠΊΠ»Π΅ΡΠΎΠΊ ΠΌΠ½ΠΎΠ³ΠΎΡΠ»ΠΎΠΉΠ½ΠΎΠ³ΠΎ ΡΠΏΠΈΡΠ΅Π»ΠΈΡ ΡΠΈΠ»ΠΈΠ½Π΄ΡΠΈΡΠ΅ΡΠΊΠΈΠΌΠΈ ΡΠ»Π΅ΠΌΠ΅Π½ΡΠ°ΠΌΠΈ. ΠΡΠ΅Π²Π΄ΠΎΡΡΠΎΠ·ΠΈΡ Π²ΡΠ³Π»ΡΠ΄ΠΈΡ ΠΊΠ°ΠΊ ΠΏΡΡΠ½ΠΎ Π½Π΅ΡΠΎΠ²Π½ΠΎΠΉ ΡΠΎΡΠΌΡ ΠΈ Π·Π°ΡΠ°ΡΡΡΡ ΠΈΠΌΠ΅Π΅Ρ ΠΏΡΠΈΠ·Π½Π°ΠΊΠΈ ΡΠΎΠΏΡΡΡΡΠ²ΡΡΡΠ΅Π³ΠΎ Π²ΠΎΡΠΏΠ°Π»Π΅Π½ΠΈΡ.
- ΠΡΠΎΠΆΠ΄ΡΠ½Π½Π°Ρ ΡΡΠΎΠ·ΠΈΡ. ΠΡΠΎ Π½Π΅ ΠΏΠ°ΡΠΎΠ»ΠΎΠ³ΠΈΡ, Π° Π²ΡΠ΅ΠΌΠ΅Π½Π½ΡΠΉ Π΄Π΅ΡΠ΅ΠΊΡ, ΠΊΠΎΡΠΎΡΡΠΉ Π²ΠΎΠ·Π½ΠΈΠΊΠ°Π΅Ρ Π² ΡΠ΅Π·ΡΠ»ΡΡΠ°ΡΠ΅ Π½Π°ΡΡΡΠ΅Π½ΠΈΡ Π΄ΠΈΡΡΠ΅ΡΠ΅Π½ΡΠΈΠ°ΡΠΈΠΈ ΠΏΠ»ΠΎΡΠΊΠΎΠ³ΠΎ ΠΈ ΡΠΈΠ»ΠΈΠ½Π΄ΡΠΈΡΠ΅ΡΠΊΠΎΠ³ΠΎ ΡΠΏΠΈΡΠ΅Π»ΠΈΡ. ΠΡΠΎΠΆΠ΄ΡΠ½Π½Π°Ρ ΡΡΠΎΠ·ΠΈΡ ΠΏΡΠ΅Π΄ΡΡΠ°Π²Π»ΡΠ΅Ρ ΡΠΎΠ±ΠΎΠΉ ΠΏΡΡΠ½ΠΎ ΠΏΡΠ°Π²ΠΈΠ»ΡΠ½ΠΎΠΉ ΡΠΎΡΠΌΡ, ΠΏΡΠΈΠ·Π½Π°ΠΊΠΈ Π²ΠΎΡΠΏΠ°Π»Π΅Π½ΠΈΡ ΠΎΠ±ΡΡΠ½ΠΎ ΠΎΡΡΡΡΡΡΠ²ΡΡΡ.
Π¨Π΅ΠΉΠΊΠ° ΡΠΎΠ΅Π΄ΠΈΠ½ΡΠ΅Ρ ΡΠ΅Π»ΠΎ ΠΌΠ°ΡΠΊΠΈ ΠΈ Π²Π»Π°Π³Π°Π»ΠΈΡΠ΅. ΠΠ½ΡΡΡΠΈ ΡΡΠΎΠΉ ΠΌΡΡΠ΅ΡΠ½ΠΎΠΉ ΡΡΡΠ±ΠΊΠΈ Π½Π°Ρ ΠΎΠ΄ΠΈΡΡΡ ΡΠ΅ΡΠ²ΠΈΠΊΠ°Π»ΡΠ½ΡΠΉ ΠΊΠ°Π½Π°Π». ΠΠ½ ΠΎΠ±Π΅ΡΠΏΠ΅ΡΠΈΠ²Π°Π΅Ρ Π·Π°ΡΠΈΡΠ½ΡΡ ΡΡΠ½ΠΊΡΠΈΡ Π±Π»Π°Π³ΠΎΠ΄Π°ΡΡ ΠΏΠΎΠΊΡΡΡΠΈΡ ΡΠΈΠ»ΠΈΠ½Π΄ΡΠΈΡΠ΅ΡΠΊΠΈΠΌΠΈ ΠΊΠ»Π΅ΡΠΊΠ°ΠΌΠΈ ΠΈ Π½Π°Π»ΠΈΡΠΈΡ ΡΠΏΠ΅ΡΠΈΠ°Π»ΡΠ½ΡΡ ΠΆΠ΅Π»Π΅Π·, ΠΊΠΎΡΠΎΡΡΠ΅ Π²ΡΡΠ°Π±Π°ΡΡΠ²Π°ΡΡ ΡΠ»ΠΈΠ·Ρ. ΠΠΈΠ΄ΠΈΠΌΠ°Ρ ΡΠ°ΡΡΡ ΡΠ΅ΠΉΠΊΠΈ ΠΌΠ°ΡΠΊΠΈ Π²ΡΡΡΠΈΠ»Π°Π΅ΡΡΡ ΠΏΠ»ΠΎΡΠΊΠΈΠΌ ΠΌΠ½ΠΎΠ³ΠΎΡΠ»ΠΎΠΉΠ½ΡΠΌ ΡΠΏΠΈΡΠ΅Π»ΠΈΠ΅ΠΌ. ΠΠ²Π° Π²ΠΈΠ΄Π° ΡΠΏΠΈΡΠ΅Π»ΠΈΠ°Π»ΡΠ½ΠΎΠΉ ΡΠΊΠ°Π½ΠΈ ΡΠΎΠ΅Π΄ΠΈΠ½ΡΠ΅ΡΡΡ Π² Π·ΠΎΠ½Π΅ ΡΡΠ°Π½ΡΡΠΎΡΠΌΠ°ΡΠΈΠΈ.
ΠΡΠΈΡΠΈΠ½Ρ ΠΏΠΎΡΠ²Π»Π΅Π½ΠΈΡ
ΠΠ΅Ρ Π°Π½ΠΈΠ·ΠΌ Π²ΠΎΠ·Π½ΠΈΠΊΠ½ΠΎΠ²Π΅Π½ΠΈΡ Π΄Π΅ΡΠ΅ΠΊΡΠ° ΡΠΎΡΠ½ΠΎ Π½Π΅ΡΡΠ΅Π½. Π‘ΡΠΈΡΠ°Π΅ΡΡΡ, ΡΡΠΎ ΡΡΠΎΠ·ΠΈΡ ΠΌΠΎΠ³ΡΡ Π²ΡΠ·ΡΠ²Π°ΡΡ ΡΠ°Π·Π»ΠΈΡΠ½ΡΠ΅ ΡΠ°ΠΊΡΠΎΡΡ. ΠΡΠΈΠΌΠ΅ΡΠ°ΡΠ΅Π»ΡΠ½ΠΎ, ΡΡΠΎ Π΄Π»Ρ ΠΊΠ°ΠΆΠ΄ΠΎΠΉ ΡΠ°Π·Π½ΠΎΠ²ΠΈΠ΄Π½ΠΎΡΡΠΈ ΡΡΠΎΠ·ΠΈΠ²Π½ΠΎΠ³ΠΎ ΠΏΡΡΠ½Π° Ρ Π°ΡΠ°ΠΊΡΠ΅ΡΠ½Ρ ΠΎΠΏΡΠ΅Π΄Π΅Π»ΡΠ½Π½ΡΠ΅ ΠΏΡΠΈΡΠΈΠ½Ρ ΡΠ°Π·Π²ΠΈΡΠΈΡ.
ΠΠΈΠ½Π΅ΠΊΠΎΠ»ΠΎΠ³ΠΈ Π²ΡΠ΄Π΅Π»ΡΡΡ ΡΠ»Π΅Π΄ΡΡΡΠΈΠ΅ ΠΏΡΠΈΡΠΈΠ½Ρ, ΠΊΠΎΡΠΎΡΡΠ΅ ΠΌΠΎΠ³ΡΡ ΡΠΏΠΎΡΠΎΠ±ΡΡΠ²ΠΎΠ²Π°ΡΡ ΡΠΎΡΠΌΠΈΡΠΎΠ²Π°Π½ΠΈΡ ΡΡΠΎΠ·ΠΈΠΈ, Π»ΠΎΠΊΠ°Π»ΠΈΠ·ΠΎΠ²Π°Π½Π½ΠΎΠΉ Π² ΠΎΠ±Π»Π°ΡΡΠΈ ΡΠ΅ΠΉΠΊΠΈ ΠΌΠ°ΡΠΊΠΈ.
- ΠΡΠΎΠΆΠ΄ΡΠ½Π½ΡΠ΅ Π½Π°ΡΡΡΠ΅Π½ΠΈΡ. ΠΠ½ΠΎΠ³Π΄Π° ΠΏΡΡΠ½ΠΎ ΠΎΠ±Π½Π°ΡΡΠΆΠΈΠ²Π°Π΅ΡΡΡ Ρ Π΄Π΅Π²ΠΎΡΠ΅ΠΊ ΠΈ Π΄Π΅Π²ΡΡΠ΅ΠΊ Π΄ΠΎ Π½Π°ΡΠ°Π»Π° ΠΏΠΎΠ»ΠΎΠ²ΠΎΠ³ΠΎ ΡΠΎΠ·ΡΠ΅Π²Π°Π½ΠΈΡ ΠΈ ΠΈΠ½ΡΠΈΠΌΠ½ΠΎΠΉ ΠΆΠΈΠ·Π½ΠΈ. ΠΠΎΠ·Π½ΠΈΠΊΠ½ΠΎΠ²Π΅Π½ΠΈΠ΅ ΡΠ°ΠΊΠΎΠ³ΠΎ Π΄Π΅ΡΠ΅ΠΊΡΠ° ΡΠ²ΡΠ·Π°Π½ΠΎ Ρ Π²Π½ΡΡΡΠΈΡΡΡΠΎΠ±Π½ΡΠΌΠΈ Π½Π°ΡΡΡΠ΅Π½ΠΈΡΠΌΠΈ, Π² ΡΠ΅Π·ΡΠ»ΡΡΠ°ΡΠ΅ ΠΊΠΎΡΠΎΡΡΡ Π½ΠΎΡΠΌΠ°Π»ΡΠ½Π°Ρ Π΄ΠΈΡΡΠ΅ΡΠ΅Π½ΡΠΈΠ°ΡΠΈΡ ΡΠΏΠΈΡΠ΅Π»ΠΈΡ Π½Π°ΡΡΡΠ°Π΅ΡΡΡ.
ΠΠ»Π°Π³Π°Π»ΠΈΡΠ½Π°Ρ ΡΠ°ΡΡΡ ΡΠ΅ΠΉΠΊΠΈ ΠΌΠ°ΡΠΊΠΈ Π²ΡΡΡΠΈΠ»Π°Π΅ΡΡΡ ΡΠΈΠ»ΠΈΠ½Π΄ΡΠΈΡΠ΅ΡΠΊΠΈΠΌΠΈ ΠΊΠ»Π΅ΡΠΊΠ°ΠΌΠΈ. ΠΡΠΎ Π·Π½Π°ΡΠΈΡ, ΡΡΠΎ Π·ΠΎΠ½Π° ΡΡΠ°Π½ΡΡΠΎΡΠΌΠ°ΡΠΈΠΈ, ΠΊΠΎΡΠΎΡΠ°Ρ Π½Π΅ Π΄ΠΎΠ»ΠΆΠ½Π° Π±ΡΡΡ Π²ΠΈΠ΄ΠΈΠΌΠΎΠΉ, ΡΠΌΠ΅ΡΠ°Π΅ΡΡΡ ΠΈ ΠΌΠΎΠΆΠ΅Ρ Π±ΡΡΡ Π²ΠΈΠ·ΡΠ°Π»ΠΈΠ·ΠΈΡΠΎΠ²Π°Π½Π° Π²ΠΎ Π²ΡΠ΅ΠΌΡ ΠΎΡΠΌΠΎΡΡΠ°. ΠΠΎΡΠ»Π΅ Π·Π°Π²Π΅ΡΡΠ΅Π½ΠΈΡ ΠΏΠΎΠ»ΠΎΠ²ΠΎΠ³ΠΎ ΡΠΎΠ·ΡΠ΅Π²Π°Π½ΠΈΡ, ΠΏΠΎ ΠΌΠ΅ΡΠ΅ ΡΡΠ°Π±ΠΈΠ»ΠΈΠ·Π°ΡΠΈΠΈ Π³ΠΎΡΠΌΠΎΠ½Π°Π»ΡΠ½ΠΎΠ³ΠΎ ΡΠΎΠ½Π° Π²ΡΠΎΠΆΠ΄ΡΠ½Π½ΠΎΠ΅ ΠΏΡΡΠ½ΠΎ ΡΠ΅Π³ΡΠ΅ΡΡΠΈΡΡΠ΅Ρ.
- ΠΠ°ΡΠ°Π»ΠΎ ΠΏΠΎΠ»ΠΎΠ²ΠΎΠΉ ΠΆΠΈΠ·Π½ΠΈ Π΄ΠΎ ΠΏΠΎΠ»Π½ΠΎΠ³ΠΎ ΡΠΎΠ·ΡΠ΅Π²Π°Π½ΠΈΡ ΡΠ΅Π΅ΡΠ½ΠΎΠ³ΠΎ ΡΠΏΠΈΡΠ΅Π»ΠΈΡ. ΠΠ΅Π·ΡΠ΅Π»ΡΠΉ ΡΠΏΠΈΡΠ΅Π»ΠΈΠΉ ΡΠ²Π»ΡΠ΅ΡΡΡ Π²ΠΎΡΠΏΡΠΈΠΈΠΌΡΠΈΠ²ΡΠΌ ΠΊ ΠΈΠ½ΡΠ΅ΠΊΡΠΈΡΠΌ ΠΈ Π²Π½Π΅ΡΠ½Π΅ΠΌΡ Π²ΠΎΠ·Π΄Π΅ΠΉΡΡΠ²ΠΈΡ. ΠΠΎΠ»ΠΎΠ²ΡΠ΅ ΠΊΠΎΠ½ΡΠ°ΠΊΡΡ Π΄ΠΎ 18-Π»Π΅ΡΠ½Π΅Π³ΠΎ Π²ΠΎΠ·ΡΠ°ΡΡΠ° Π½Π΅ΡΠ΅Π΄ΠΊΠΎ ΠΏΡΠΈΠ²ΠΎΠ΄ΡΡ ΠΊ ΡΠ°Π·Π²ΠΈΡΠΈΡ ΠΈΡΡΠΈΠ½Π½ΠΎΠΉ ΡΡΠΎΠ·ΠΈΠΈ ΠΈ ΡΠΊΡΠΎΠΏΠΈΠΈ.
- ΠΠ½ΡΠ΅ΠΊΡΠΈΠΈ. ΠΠ°ΡΠΎΠ³Π΅Π½Π½Π°Ρ ΠΌΠΈΠΊΡΠΎΡΠ»ΠΎΡΠ° Π³ΡΠ±ΠΈΡΠ΅Π»ΡΠ½ΠΎ Π²ΠΎΠ·Π΄Π΅ΠΉΡΡΠ²ΡΠ΅Ρ Π½Π° ΠΏΠΎΠΊΡΠΎΠ²Π½ΡΠΉ ΡΠΏΠΈΡΠ΅Π»ΠΈΠΉ, Π²ΡΠ·ΡΠ²Π°Ρ ΠΈΡΡΠΈΠ½Π½ΡΡ ΡΡΠΎΠ·ΠΈΡ, Π° Π·Π°ΡΠ΅ΠΌ ΡΠΊΡΠΎΠΏΠΈΡ.
- Π’ΡΠ°Π²ΠΌΡ ΡΠ΅ΠΉΠΊΠΈ ΠΌΠ°ΡΠΊΠΈ. Π‘Π»ΠΎΠΆΠ½ΡΠ΅ ΡΠΎΠ΄Ρ, Π°Π±ΠΎΡΡΡ, Π²ΡΡΠΊΠ°Π±Π»ΠΈΠ²Π°Π½ΠΈΡ ΠΏΡΠΈΠ²ΠΎΠ΄ΡΡ ΠΊ Π²ΡΠ²ΠΎΡΠΎΡΡ ΡΠ΅ΠΉΠΊΠΈ ΠΌΠ°ΡΠΊΠΈ ΠΈΠ»ΠΈ ΡΠΊΡΡΠΎΠΏΠΈΠΎΠ½Ρ. ΠΠΏΠΎΡΠ»Π΅Π΄ΡΡΠ²ΠΈΠΈ Π½Π° ΡΡΠ°Π²ΠΌΠΈΡΠΎΠ²Π°Π½Π½ΠΎΠΉ ΡΠ΅ΠΉΠΊΠ΅ ΠΌΠ°ΡΠΊΠΈ ΠΎΠ±ΡΠ°Π·ΡΠ΅ΡΡΡ ΡΠ·Π²Π΅Π½Π½ΡΠΉ Π΄Π΅ΡΠ΅ΠΊΡ.
- ΠΠΎΡΠΌΠΎΠ½Π°Π»ΡΠ½ΡΠΉ Π΄ΠΈΡΠ±Π°Π»Π°Π½Ρ. Π£ΡΡΠ°Π½ΠΎΠ²Π»Π΅Π½ΠΎ, ΡΡΠΎ ΡΡΠΎΠ·ΠΈΡ Π½Π΅ΡΠ΅Π΄ΠΊΠΎ Π²ΠΎΠ·Π½ΠΈΠΊΠ°Π΅Ρ Π² ΡΠ΅Π·ΡΠ»ΡΡΠ°ΡΠ΅ ΠΈΠ·ΠΌΠ΅Π½Π΅Π½ΠΈΡ ΡΡΠΎΠ²Π½Ρ ΠΏΠΎΠ»ΠΎΠ²ΡΡ Π³ΠΎΡΠΌΠΎΠ½ΠΎΠ². Π ΡΠ°ΡΡΠ½ΠΎΡΡΠΈ, ΡΠ΅Π·ΠΊΠΎΠ΅ ΡΠ½ΠΈΠΆΠ΅Π½ΠΈΠ΅ ΡΡΡΡΠΎΠ³Π΅Π½ΠΎΠ² Π²Π»ΠΈΡΠ΅Ρ Π½Π° ΡΠΎΡΡΠΎΡΠ½ΠΈΠ΅ ΡΠ΅Π΅ΡΠ½ΠΎΠ³ΠΎ ΡΠΏΠΈΡΠ΅Π»ΠΈΡ, Π²ΡΠ·ΡΠ²Π°Ρ ΡΠΎΡΠΌΠΈΡΠΎΠ²Π°Π½ΠΈΠ΅ ΡΠ·Π²Ρ. Π’Π°ΠΊΠΎΠ΅ ΠΏΠ°ΡΠΎΠ»ΠΎΠ³ΠΈΡΠ΅ΡΠΊΠΎΠ΅ ΡΠΎΡΡΠΎΡΠ½ΠΈΠ΅ Π½Π΅ΡΠ΅Π΄ΠΊΠΎ Π΄ΠΈΠ°Π³Π½ΠΎΡΡΠΈΡΡΠ΅ΡΡΡ ΠΏΡΠΈ Π±Π΅ΡΠ΅ΠΌΠ΅Π½Π½ΠΎΡΡΠΈ ΠΈΠ»ΠΈ ΠΊΠ»ΠΈΠΌΠ°ΠΊΡΠ΅.
ΠΠΈΠ½Π΅ΠΊΠΎΠ»ΠΎΠ³ΠΈ ΠΎΡΠΌΠ΅ΡΠ°ΡΡ, ΡΡΠΎ ΡΡΡΡΠ°Π½Π΅Π½ΠΈΠ΅ ΠΏΡΠΎΠ²ΠΎΡΠΈΡΡΡΡΠΈΡ ΡΠ°ΠΊΡΠΎΡΠΎΠ² ΠΎΠΊΠ°Π·ΡΠ²Π°Π΅Ρ ΡΡΡΠ΅ΡΡΠ²Π΅Π½Π½ΠΎΠ΅ Π²Π»ΠΈΡΠ½ΠΈΠ΅ Π½Π° ΠΏΡΠΎΠ³Π½ΠΎΠ· ΠΈΠ·Π»Π΅ΡΠ΅Π½ΠΈΡ. Π§ΡΠΎΠ±Ρ ΠΈΠ·Π±Π΅ΠΆΠ°ΡΡ ΡΠ΅ΡΠΈΠ΄ΠΈΠ²ΠΎΠ² Π½Π΅Π΄ΡΠ³Π°, ΠΆΠ΅Π»Π°ΡΠ΅Π»ΡΠ½ΠΎ ΠΏΠΎ Π²ΠΎΠ·ΠΌΠΎΠΆΠ½ΠΎΡΡΠΈ ΡΡΡΡΠ°Π½ΠΈΡΡ ΠΏΡΠΎΠ²ΠΎΡΠΈΡΡΡΡΠΈΠ΅ ΡΠ°ΠΊΡΠΎΡΡ.

Π‘ΠΈΠΌΠΏΡΠΎΠΌΠ°ΡΠΈΠΊΠ° ΠΈ ΠΏΡΠΈΠ·Π½Π°ΠΊΠΈ ΠΏΡΠΈ ΡΠ°Π·Π»ΠΈΡΠ½ΡΡ Π²ΠΈΠ΄Π°Ρ
ΠΠΏΠ°ΡΠ½ΠΎΡΡΡ ΡΡΠΎΠ·ΠΈΠΈ Π·Π°ΠΊΠ»ΡΡΠ°Π΅ΡΡΡ Π² ΡΠΎΠΌ, ΡΡΠΎ ΠΎΠ½Π° ΠΏΡΠΎΡΠ΅ΠΊΠ°Π΅Ρ Π±Π΅ΡΡΠΈΠΌΠΏΡΠΎΠΌΠ½ΠΎ. ΠΡΠΎ Π·Π½Π°ΡΠΈΡ, ΡΡΠΎΠ±Ρ Π²ΡΡΠ²ΠΈΡΡ Π΄Π΅ΡΠ΅ΠΊΡ ΠΏΠΎΠΊΡΠΎΠ²Π½ΠΎΠ³ΠΎ ΡΠΏΠΈΡΠ΅Π»ΠΈΡ Π½Π΅ΠΎΠ±Ρ ΠΎΠ΄ΠΈΠΌΠΎ ΠΎΠ±ΡΠ°ΡΠΈΡΡΡΡ ΠΊ Π²ΡΠ°ΡΡ ΠΈ ΠΏΡΠΎΠΉΡΠΈ ΠΎΠ±ΡΠ»Π΅Π΄ΠΎΠ²Π°Π½ΠΈΠ΅. ΠΠ°ΡΠ°ΡΡΡΡ ΡΠΏΠ΅ΡΠΈΠ°Π»ΠΈΡΡΡ ΠΎΠΏΡΠ΅Π΄Π΅Π»ΡΡΡ ΡΠΊΡΠΎΠΏΠΈΡ, ΠΊΠΎΡΠΎΡΠ°Ρ ΠΎΠ·Π½Π°ΡΠ°Π΅Ρ Π½Π°Π»ΠΈΡΠΈΠ΅ ΡΡΠ°ΡΡΠΊΠ°, ΠΎΠ±ΡΠ°Π·ΠΎΠ²Π°Π½Π½ΠΎΠ³ΠΎ ΡΠΈΠ»ΠΈΠ½Π΄ΡΠΈΡΠ΅ΡΠΊΠΈΠΌΠΈ ΠΊΠ»Π΅ΡΠΊΠ°ΠΌΠΈ ΡΠ΅ΡΠ²ΠΈΠΊΠ°Π»ΡΠ½ΠΎΠ³ΠΎ ΠΊΠ°Π½Π°Π»Π°.
ΠΠ΄ΠΈΠ½ΡΡΠ²Π΅Π½Π½ΡΠΌ ΡΠΈΠΌΠΏΡΠΎΠΌΠΎΠΌ ΠΏΡΠ΅Π²Π΄ΠΎΡΡΠΎΠ·ΠΈΠΈ ΡΠ²Π»ΡΡΡΡΡ ΡΠ»ΠΈΠ·ΠΈΡΡΡΠ΅ Π²ΡΠ΄Π΅Π»Π΅Π½ΠΈΡ, ΠΊΠΎΡΠΎΡΡΠ΅ ΠΏΠΎΡΠ²Π»ΡΡΡΡΡ Π² ΡΠ΅Π·ΡΠ»ΡΡΠ°ΡΠ΅ ΡΡΠ½ΠΊΡΠΈΠΎΠ½ΠΈΡΠΎΠ²Π°Π½ΠΈΡ ΠΆΠ΅Π»Π΅Π· ΠΎΠ΄Π½ΠΎΡΠ»ΠΎΠΉΠ½ΠΎΠ³ΠΎ ΡΠΏΠΈΡΠ΅Π»ΠΈΡ Π½Π° ΡΡΠ°ΡΡΠΊΠ΅ ΡΡΠΎΠ·ΠΈΠΈ. ΠΡΠΈ ΠΏΠΎΠ»ΠΎΠ²ΡΡ ΠΊΠΎΠ½ΡΠ°ΠΊΡΠ°Ρ ΠΈΠ»ΠΈ ΠΎΡΠΌΠΎΡΡΠ΅ Π³ΠΈΠ½Π΅ΠΊΠΎΠ»ΠΎΠ³ΠΎΠΌ ΠΌΠΎΠ³ΡΡ ΠΎΡΠΌΠ΅ΡΠ°ΡΡΡΡ ΠΊΡΠΎΠ²ΡΠ½ΠΈΡΡΡΠ΅ Π²ΡΠ΄Π΅Π»Π΅Π½ΠΈΡ Π²ΡΠ»Π΅Π΄ΡΡΠ²ΠΈΠ΅ ΡΡΠ°Π²ΠΌΠ°ΡΠΈΠ·Π°ΡΠΈΠΈ ΠΏΡΡΠ½Π°, ΠΊΠΎΡΠΎΡΠΎΠ΅ Π²ΠΎΡΠΏΡΠΈΠΈΠΌΡΠΈΠ²ΠΎ ΠΊ Π²Π½Π΅ΡΠ½ΠΈΠΌ Π²ΠΎΠ·Π΄Π΅ΠΉΡΡΠ²ΠΈΡΠΌ.
ΠΡΠΈΠ·Π½Π°ΠΊΠΈ ΡΡΠΎΠ·ΠΈΠΈ Π²ΡΡΠ²Π»ΡΡΡΡΡ ΠΏΡΠΈ Π²ΠΈΠ·ΡΠ°Π»ΡΠ½ΠΎΠΌ ΠΎΡΠΌΠΎΡΡΠ΅ ΡΠ΅ΠΉΠΊΠΈ ΠΌΠ°ΡΠΊΠΈ ΠΈ ΠΎΡΠ΅Π½ΠΊΠΈ ΡΠΎΡΡΠΎΡΠ½ΠΈΡ Π΅Ρ ΡΠ»ΠΈΠ·ΠΈΡΡΠΎΠΉ.
- ΠΡΡΠΈΠ½Π½Π°Ρ ΡΡΠΎΠ·ΠΈΡ ΠΈΠΌΠ΅Π΅Ρ Π²ΠΈΠ΄ ΡΠ°Π½Ρ, ΠΊΠΎΡΠΎΡΠ°Ρ ΠΌΠΎΠΆΠ΅Ρ ΠΊΡΠΎΠ²ΠΎΡΠΎΡΠΈΡΡ ΠΏΡΠΈ ΠΊΠΎΠ½ΡΠ°ΠΊΡΠ΅ Ρ ΠΈΠ½ΡΡΡΡΠΌΠ΅Π½ΡΠΎΠΌ Π΄ΠΎΠΊΡΠΎΡΠ°. ΠΡΠΈ ΠΈΡΡΠΈΠ½Π½ΠΎΠΉ ΡΡΠΎΠ·ΠΈΠΈ Π½Π΅ΡΠ΅Π΄ΠΊΠΎ Π²ΠΎΠ·Π½ΠΈΠΊΠ°Π΅Ρ Π²ΠΎΡΠΏΠ°Π»ΠΈΡΠ΅Π»ΡΠ½ΡΠΉ ΠΏΡΠΎΡΠ΅ΡΡ.
- ΠΡΠΎΠΆΠ΄ΡΠ½Π½Π°Ρ ΡΡΠΎΠ·ΠΈΡ ΠΈΠΌΠ΅Π΅Ρ Π²ΠΈΠ΄ ΠΏΡΡΠ½ΠΎ ΠΊΡΠ°ΡΠ½ΠΎΠ²Π°ΡΠΎΠ³ΠΎ ΠΎΡΡΠ΅Π½ΠΊΠ°, ΠΊΠΎΡΠΎΡΠΎΠ΅ ΠΎΡΠ»ΠΈΡΠ°Π΅ΡΡΡ ΠΎΡ Π·Π΄ΠΎΡΠΎΠ²ΠΎΠΉ Π±Π»Π΅Π΄Π½ΠΎ-ΡΠΎΠ·ΠΎΠ²ΠΎΠΉ ΡΠ»ΠΈΠ·ΠΈΡΡΠΎΠΉ. ΠΡΠΈΠ·Π½Π°ΠΊΠΈ ΠΈΠ½ΡΠΈΡΠΈΡΠΎΠ²Π°Π½ΠΈΡ ΠΎΠ±ΡΡΠ½ΠΎ ΠΎΡΡΡΡΡΡΠ²ΡΡΡ.
- ΠΠΊΡΠΎΠΏΠΈΡ ΠΏΡΠΎΡΠ²Π»ΡΠ΅ΡΡΡ ΠΎΠ±ΡΠ°Π·ΠΎΠ²Π°Π½ΠΈΠ΅ΠΌ ΠΏΡΡΠ½Π°, ΠΊΠΎΡΠΎΡΠΎΠ΅ ΠΌΠΎΠΆΠ΅Ρ ΠΈΠΌΠ΅ΡΡ ΡΠ°Π·Π»ΠΈΡΠ½ΡΡ ΡΠΎΡΠΌΡ ΠΈ Π²Π΅Π»ΠΈΡΠΈΠ½Ρ. Π₯Π°ΡΠ°ΠΊΡΠ΅ΡΠ½ΡΠΌ ΡΠΈΠΌΠΏΡΠΎΠΌΠΎΠΌ ΠΏΡΠ΅Π²Π΄ΠΎΡΡΠΎΠ·ΠΈΠΈ ΡΠ²Π»ΡΠ΅ΡΡΡ Π½Π°Π»ΠΈΡΠΈΠ΅ Π²ΠΎΡΠΏΠ°Π»ΠΈΡΠ΅Π»ΡΠ½ΠΎΠ³ΠΎ ΠΏΡΠΎΡΠ΅ΡΡΠ°.
ΠΡΠΎΠ·ΠΈΡ Π½Π΅ ΠΏΡΠΈΠ²ΠΎΠ΄ΠΈΡ ΠΊ ΡΠ°Π·Π²ΠΈΡΠΈΡ Π±ΠΎΠ»Π΅Π²ΡΡ ΠΎΡΡΡΠ΅Π½ΠΈΠΉ, Π½Π°ΡΡΡΠ΅Π½ΠΈΡ ΡΠΈΠΊΠ»Π°, ΠΊΡΠΎΠ²ΠΎΡΠ΅ΡΠ΅Π½ΠΈΡΠΌ Π°ΡΠΈΠΊΠ»ΠΈΡΠ΅ΡΠΊΠΎΠ³ΠΎ Ρ Π°ΡΠ°ΠΊΡΠ΅ΡΠ°. ΠΠ΄Π½Π°ΠΊΠΎ Π½Π΅Π΄ΡΠ³ ΠΎΠ±ΡΡΠ½ΠΎ ΡΠΎΠΏΡΠΎΠ²ΠΎΠΆΠ΄Π°Π΅ΡΡΡ Π΄ΡΡΠ³ΠΈΠΌΠΈ Π·Π°Π±ΠΎΠ»Π΅Π²Π°Π½ΠΈΡΠΌΠΈ Π³ΠΈΠ½Π΅ΠΊΠΎΠ»ΠΎΠ³ΠΈΡΠ΅ΡΠΊΠΎΠ³ΠΎ ΠΏΠ»Π°Π½Π°, Π² ΡΠ΅Π·ΡΠ»ΡΡΠ°ΡΠ΅ ΡΠ΅Π³ΠΎ ΠΏΠΎΡΠ²Π»ΡΠ΅ΡΡΡ ΡΠΈΠΏΠΈΡΠ½Π°Ρ ΠΊΠ»ΠΈΠ½ΠΈΡΠ΅ΡΠΊΠ°Ρ ΠΊΠ°ΡΡΠΈΠ½Π° Π΄Π»Ρ ΠΊΠ°ΠΆΠ΄ΠΎΠΉ ΠΏΠ°ΡΠΎΠ»ΠΎΠ³ΠΈΠΈ.
ΠΠΈΠ°Π³Π½ΠΎΡΡΠΈΠΊΠ°
Π‘Π²ΠΎΠ΅Π²ΡΠ΅ΠΌΠ΅Π½Π½ΠΎΠ΅ Π²ΡΡΠ²Π»Π΅Π½ΠΈΠ΅ Π½Π΅Π΄ΡΠ³Π° ΠΏΡΠ΅Π΄ΠΎΡΠ²ΡΠ°ΡΠ°Π΅Ρ Π²ΠΎΠ·Π½ΠΈΠΊΠ½ΠΎΠ²Π΅Π½ΠΈΠ΅ ΡΠ΅ΡΡΡΠ·Π½ΡΡ ΠΏΠ°ΡΠΎΠ»ΠΎΠ³ΠΈΠΉ. ΠΠΎΡΠΊΠΎΠ»ΡΠΊΡ ΡΡΠΎΠ·ΠΈΡ Π½Π΅ ΠΎΡΠ»ΠΈΡΠ°Π΅ΡΡΡ Π²ΡΡΠ°ΠΆΠ΅Π½Π½ΠΎΠΉ ΡΠΈΠΌΠΏΡΠΎΠΌΠ°ΡΠΈΠΊΠΎΠΉ, Π³ΠΈΠ½Π΅ΠΊΠΎΠ»ΠΎΠ³ΠΈ ΠΎΠ±ΡΠ°ΡΠ°ΡΡ Π²Π½ΠΈΠΌΠ°Π½ΠΈΠ΅ Π½Π° Π²Π°ΠΆΠ½ΠΎΡΡΡ ΠΏΡΠΎΡΠΈΠ»Π°ΠΊΡΠΈΡΠ΅ΡΠΊΠΈΡ ΠΎΡΠΌΠΎΡΡΠΎΠ². Π Π΅Π³ΡΠ»ΡΡΠ½ΠΎΠ΅ ΠΎΠ±ΡΠ»Π΅Π΄ΠΎΠ²Π°Π½ΠΈΠ΅ ΠΏΠΎΠ·Π²ΠΎΠ»ΡΠ΅Ρ ΡΠ²ΠΎΠ΅Π²ΡΠ΅ΠΌΠ΅Π½Π½ΠΎ ΠΎΠ±Π½Π°ΡΡΠΆΠΈΡΡ Π΄Π΅ΡΠ΅ΠΊΡ ΡΠ΅ΠΉΠΊΠΈ ΠΌΠ°ΡΠΊΠΈ ΠΈ Π²ΠΎΠ²ΡΠ΅ΠΌΡ Π½Π°ΡΠ°ΡΡ Π½Π΅ΠΎΠ±Ρ ΠΎΠ΄ΠΈΠΌΠΎΠ΅ Π»Π΅ΡΠ΅Π½ΠΈΠ΅.
ΠΡΠ½ΠΎΠ²Π½ΠΎΠ΅ Π»Π΅ΡΠ΅Π½ΠΈΠ΅ ΠΏΠΎΠ΄ΡΠ°Π·ΡΠΌΠ΅Π²Π°Π΅Ρ ΠΎΡΡΡΠ΅ΡΡΠ²Π»Π΅Π½ΠΈΠ΅ ΠΏΡΠΈΠΆΠΈΠ³Π°Π½ΠΈΡ ΡΠ°Π·Π»ΠΈΡΠ½ΡΠΌΠΈ ΠΌΠ΅ΡΠΎΠ΄Π°ΠΌΠΈ. ΠΠΏΡΠ΅Π΄Π΅Π»Π΅Π½ΠΈΠ΅ ΡΡΠΎΠ·ΠΈΠ²Π½ΠΎΠ³ΠΎ ΠΏΡΡΠ½Π° Π½Π° ΡΠ°Π½Π½Π΅ΠΉ ΡΡΠ°Π΄ΠΈΠΈ ΠΏΠΎΠ·Π²ΠΎΠ»ΡΠ΅Ρ ΠΈΡΠΏΠΎΠ»ΡΠ·ΠΎΠ²Π°ΡΡ Π² ΠΊΠ°ΡΠ΅ΡΡΠ²Π΅ ΡΠ΅ΡΠ°ΠΏΠΈΠΈ ΡΠ²Π΅ΡΠΈ, ΠΎΠ±Π»Π°Π΄Π°ΡΡΠΈΠ΅ ΠΏΡΠΎΡΠΈΠ²ΠΎΠ²ΠΎΡΠΏΠ°Π»ΠΈΡΠ΅Π»ΡΠ½ΡΠΌ ΠΈ ΡΠ΅Π³Π΅Π½Π΅ΡΠΈΡΡΡΡΠΈΠΌ Π΄Π΅ΠΉΡΡΠ²ΠΈΠ΅ΠΌ.
ΠΡΠ°Ρ ΡΡΠ°Π²ΠΈΡ Π΄ΠΈΠ°Π³Π½ΠΎΠ· Π²ΠΎ Π²ΡΠ΅ΠΌΡ ΠΎΡΠΌΠΎΡΡΠ° ΠΈ ΠΎΡΠ΅Π½ΠΊΠΈ ΡΠ»ΠΈΠ·ΠΈΡΡΠΎΠΉ ΡΠ΅ΠΉΠΊΠΈ Π² Π·Π΅ΡΠΊΠ°Π»Π°Ρ . ΠΡΠΎΠΌΠ΅ ΡΠΎΠ³ΠΎ, ΠΏΠΎ Π²Π½Π΅ΡΠ½Π΅ΠΌΡ Π²ΠΈΠ΄Ρ Π΄Π΅ΡΠ΅ΠΊΡΠ° ΠΌΠΎΠΆΠ½ΠΎ Π΄ΠΈΡΡΠ΅ΡΠ΅Π½ΡΠΈΡΠΎΠ²Π°ΡΡ Π΅Π³ΠΎ Π²ΠΈΠ΄. ΠΠ΄Π½Π°ΠΊΠΎ ΠΎΠ΄Π½ΠΎΠ³ΠΎ ΠΎΡΠΌΠΎΡΡΠ° Π³ΠΈΠ½Π΅ΠΊΠΎΠ»ΠΎΠ³Π° Π½Π΅Π΄ΠΎΡΡΠ°ΡΠΎΡΠ½ΠΎ. ΠΠ·Π²Π΅ΡΡΠ½ΠΎ, ΡΡΠΎ ΠΏΠΎΠ΄ ΡΡΠΎΠ·ΠΈΠ΅ΠΉ ΠΌΠΎΠ³ΡΡ ΡΠΊΡΡΠ²Π°ΡΡΡΡ ΠΎΠΏΠ°ΡΠ½ΡΠ΅ Π±ΠΎΠ»Π΅Π·Π½ΠΈ, Π² ΡΠΎΠΌ ΡΠΈΡΠ»Π΅, ΡΠ°ΠΊ.
ΠΠ»Ρ ΡΠΎΠ³ΠΎ ΡΡΠΎΠ±Ρ ΠΈΡΠΊΠ»ΡΡΠΈΡΡ ΠΏΡΠ΅Π΄ΡΠ°ΠΊΠΎΠ²ΡΠ΅ ΠΏΡΠΎΡΠ΅ΡΡΡ ΠΈ ΡΠ°ΠΊ, Π²ΡΡΠ²ΠΈΡΡ ΡΠΎΠΏΡΡΡΡΠ²ΡΡΡΠΈΠ΅ Π³ΠΈΠ½Π΅ΠΊΠΎΠ»ΠΎΠ³ΠΈΡΠ΅ΡΠΊΠΈΠ΅ Π·Π°Π±ΠΎΠ»Π΅Π²Π°Π½ΠΈΡ, Π½ΡΠΆΠ½ΠΎ ΠΏΡΠΎΠΉΡΠΈ ΠΎΠ±ΡΠ»Π΅Π΄ΠΎΠ²Π°Π½ΠΈΠ΅:
- ΠΌΠ°Π·ΠΎΠΊ Π½Π° ΡΠ»ΠΎΡΡ;
- ΡΠΈΡΠΎΠ»ΠΎΠ³ΠΈΡΠ΅ΡΠΊΠΎΠ΅ ΠΈΡΡΠ»Π΅Π΄ΠΎΠ²Π°Π½ΠΈΠ΅;
- Π±Π°ΠΊΠΏΠΎΡΠ΅Π²;
- ΠΠ¦Π -Π΄ΠΈΠ°Π³Π½ΠΎΡΡΠΈΠΊΡ ΠΏΠΎΠ»ΠΎΠ²ΡΡ ΠΈΠ½ΡΠ΅ΠΊΡΠΈΠΉ;
- ΠΊΠΎΠ»ΡΠΏΠΎΡΠΊΠΎΠΏΠΈΡ;
- Π±ΠΈΠΎΠΏΡΠΈΡ.
ΠΡΠ½ΠΎΠ²Π½ΡΠΌΠΈ ΠΌΠ΅ΡΠΎΠ΄Π°ΠΌΠΈ Π΄ΠΈΠ°Π³Π½ΠΎΡΡΠΈΠΊΠΈ ΡΠ²Π»ΡΡΡΡΡ Π²ΠΈΠ·ΡΠ°Π»ΡΠ½ΡΠΉ ΠΎΡΠΌΠΎΡΡ ΠΈ ΠΊΠΎΠ»ΡΠΏΠΎΡΠΊΠΎΠΏΠΈΡ. ΠΡΠΈ Π΄Π²Π° ΠΈΡΡΠ»Π΅Π΄ΠΎΠ²Π°Π½ΠΈΡ ΠΏΠΎΡ ΠΎΠΆΠΈ. ΠΡΠ»ΠΈΡΠΈΠ΅ Π·Π°ΠΊΠ»ΡΡΠ°Π΅ΡΡΡ Π² ΡΠΎΠΌ, ΡΡΠΎ Π²ΠΎ Π²ΡΠ΅ΠΌΡ ΠΊΠΎΠ»ΡΠΏΠΎΡΠΊΠΎΠΏΠΈΠΈ Π΄ΠΎΠΊΡΠΎΡ ΠΈΠ·ΡΡΠ°Π΅Ρ ΡΠ΅ΠΉΠΊΡ ΠΌΠ°ΡΠΊΠΈ ΠΏΠΎΡΡΠ΅Π΄ΡΡΠ²ΠΎΠΌ ΠΊΠΎΠ»ΡΠΏΠΎΡΠΊΠΎΠΏΠ°. ΠΡΠΎΡ ΠΏΡΠΈΠ±ΠΎΡ ΡΠΎΡΡΠΎΠΈΡ ΠΈΠ· ΡΠ²Π΅Π»ΠΈΡΠΈΡΠ΅Π»ΡΠ½ΠΎΠΉ ΠΈ ΠΎΡΠ²Π΅ΡΠΈΡΠ΅Π»ΡΠ½ΠΎΠΉ ΡΠΈΡΡΠ΅ΠΌ, ΠΏΠΎΠ·Π²ΠΎΠ»ΡΡΡΠΈΡ Π΄Π΅ΡΠ°Π»ΡΠ½ΠΎ ΡΠ°ΡΡΠΌΠΎΡΡΠ΅ΡΡ ΡΠ»ΠΈΠ·ΠΈΡΡΡΡ.
ΠΠ»Ρ ΡΠΎΠ³ΠΎ ΡΡΠΎΠ±Ρ ΡΠΎΡΠ½ΠΎ ΠΎΠΏΡΠ΅Π΄Π΅Π»ΠΈΡΡ ΠΏΠΎΡΠ°ΠΆΡΠ½Π½ΡΠΉ ΡΡΠ°ΡΡΠΎΠΊ, Π²ΡΠ°Ρ ΠΏΡΠΎΠ²ΠΎΠ΄ΠΈΡ ΡΠ°ΡΡΠΈΡΠ΅Π½Π½ΡΠΉ Π²Π°ΡΠΈΠ°Π½Ρ ΠΊΠΎΠ»ΡΠΏΠΎΡΠΊΠΎΠΏΠΈΠΈ, Π² ΠΏΡΠΎΡΠ΅ΡΡΠ΅ ΠΊΠΎΡΠΎΡΠΎΠ³ΠΎ ΡΠ΅ΠΉΠΊΠ° ΠΌΠ°ΡΠΊΠΈ ΠΎΠ±ΡΠ°Π±Π°ΡΡΠ²Π°Π΅ΡΡΡ ΡΠΏΠ΅ΡΠΈΠ°Π»ΡΠ½ΡΠΌΠΈ ΡΠ°ΡΡΠ²ΠΎΡΠ°ΠΌΠΈ. ΠΠ΅ΠΎΠΊΡΠ°ΡΠ΅Π½Π½ΡΠΉ ΡΡΠ°ΡΡΠΎΠΊ ΠΌΠΎΠΆΠ΅Ρ ΡΠ²ΠΈΠ΄Π΅ΡΠ΅Π»ΡΡΡΠ²ΠΎΠ²Π°ΡΡ ΠΎ ΡΠ°Π·Π²ΠΈΡΠΈΠΈ Π΄ΠΈΡΠΏΠ»Π°Π·ΠΈΠΈ.
Π‘ ΡΠ΅Π»ΡΡ ΠΈΡΠΊΠ»ΡΡΠ΅Π½ΠΈΡ Π΄ΠΈΡΠΏΠ»Π°Π·ΠΈΠΈ ΠΈ ΡΠ°ΠΊΠ° ΡΠ΅ΠΉΠΊΠΈ ΠΌΠ°ΡΠΊΠΈ, Π³ΠΈΠ½Π΅ΠΊΠΎΠ»ΠΎΠ³ ΠΏΡΠΎΠ²ΠΎΠ΄ΠΈΡ Π±ΠΈΠΎΠΏΡΠΈΡ. ΠΠ½ ΠΏΡΠΎΠΈΠ·Π²ΠΎΠ΄ΠΈΡ Π·Π°Π±ΠΎΡ ΠΊΡΡΠΎΡΠΊΠ° ΠΏΠΎΡΠ°ΠΆΡΠ½Π½ΠΎΠΉ ΡΠΊΠ°Π½ΠΈ Π΄Π»Ρ ΠΈΡΡΠ»Π΅Π΄ΠΎΠ²Π°Π½ΠΈΡ ΠΏΠΎΠ΄ ΠΌΠΈΠΊΡΠΎΡΠΊΠΎΠΏΠΎΠΌ, ΠΊΠΎΡΠΎΡΠΎΠ΅ Π±ΡΠ΄Π΅Ρ ΠΏΡΠΎΠ²ΠΎΠ΄ΠΈΡΡΡΡ Π² Π»Π°Π±ΠΎΡΠ°ΡΠΎΡΠΈΠΈ.

Π’ΡΠ°ΡΠ΅Π»ΡΠ½Π°Ρ Π΄ΠΈΠ°Π³Π½ΠΎΡΡΠΈΠΊΠ° ΠΈΠΌΠ΅Π΅Ρ ΡΡΡΠ΅ΡΡΠ²Π΅Π½Π½ΠΎΠ΅ Π·Π½Π°ΡΠ΅Π½ΠΈΠ΅ ΠΏΡΠΈ Π½Π°Π·Π½Π°ΡΠ΅Π½ΠΈΠΈ Π»Π΅ΡΠ΅Π½ΠΈΡ. ΠΠ°ΠΏΡΠΈΠΌΠ΅Ρ, ΠΏΡΠΎΠ²ΠΎΠ΄ΠΈΡΡ ΠΏΡΠΈΠΆΠΈΠ³Π°Π½ΠΈΠ΅ ΠΌΠ΅ΡΠΎΠ΄ΠΎΠΌ Π΄ΠΈΠ°ΡΠ΅ΡΠΌΠΎΠΊΠΎΠ°Π³ΡΠ»ΡΡΠΈΠΈ ΠΈΠ»ΠΈ Π΄ΡΡΠ³ΠΈΠΌ ΡΠΏΠΎΡΠΎΠ±ΠΎΠΌ ΠΏΡΠΎΡΠΈΠ²ΠΎΠΏΠΎΠΊΠ°Π·Π°Π½ΠΎ ΠΏΡΠΈ Π½Π°Π»ΠΈΡΠΈΠΈ Π·Π»ΠΎΠΊΠ°ΡΠ΅ΡΡΠ²Π΅Π½Π½ΠΎΠΉ ΠΎΠΏΡΡ ΠΎΠ»ΠΈ. ΠΡΠΈΠΌΠ΅Π½Π΅Π½ΠΈΠ΅ ΡΠ²Π΅ΡΠ΅ΠΉ Π² Π΄Π°Π½Π½ΠΎΠΌ ΡΠ»ΡΡΠ°Π΅ ΡΠ°ΠΊΠΆΠ΅ Π½Π΅ ΠΎΠΏΡΠ°Π²Π΄Π°Π½ΠΎ.
ΠΡΠΏΠΎΠ»ΡΠ·ΠΎΠ²Π°Π½ΠΈΠ΅ ΡΠ²Π΅ΡΠ΅ΠΉ
Π’Π΅ΡΠ°ΠΏΠ΅Π²ΡΠΈΡΠ΅ΡΠΊΠ°Ρ ΡΠ°ΠΊΡΠΈΠΊΠ° Π·Π°Π²ΠΈΡΠΈΡ ΠΎΡ Π²ΠΈΠ΄Π° ΡΡΠΎΠ·ΠΈΠ²Π½ΠΎΠ³ΠΎ ΠΎΠ±ΡΠ°Π·ΠΎΠ²Π°Π½ΠΈΡ. ΠΡΠΎΠΆΠ΄ΡΠ½Π½Π°Ρ ΡΠΎΡΠΌΠ° ΡΠ΅Π³ΡΠ΅ΡΡΠΈΡΡΠ΅Ρ ΡΠ°ΠΌΠΎΡΡΠΎΡΡΠ΅Π»ΡΠ½ΠΎ, Π»Π΅ΡΠ΅Π½ΠΈΠ΅ ΡΠ²Π΅ΡΠ°ΠΌΠΈ ΡΡΠ΅Π±ΡΠ΅ΡΡΡ ΡΠΎΠ»ΡΠΊΠΎ ΠΏΡΠΈ ΠΏΡΠΈΡΠΎΠ΅Π΄ΠΈΠ½Π΅Π½ΠΈΠΈ ΠΈΠ½ΡΠ΅ΠΊΡΠΈΠΈ. ΠΡΡΠΈΠ½Π½Π°Ρ ΡΡΠΎΠ·ΠΈΡ Π΄ΠΈΠ°Π³Π½ΠΎΡΡΠΈΡΡΠ΅ΡΡΡ ΠΊΡΠ°ΠΉΠ½Π΅ ΡΠ΅Π΄ΠΊΠΎ ΠΈΠ·-Π·Π° ΡΠ»ΠΈΡΠΊΠΎΠΌ ΠΊΠΎΡΠΎΡΠΊΠΎΠ³ΠΎ ΠΏΠ΅ΡΠΈΠΎΠ΄Π° ΠΏΡΠΎΠ³ΡΠ΅ΡΡΠΈΡΠΎΠ²Π°Π½ΠΈΡ. Π’Π΅ΡΠ°ΠΏΠΈΡ Π² ΡΠ°ΠΊΠΎΠΌ ΡΠ»ΡΡΠ°Π΅ Π½Π°ΠΏΡΠ°Π²Π»Π΅Π½Π° Π½Π° ΡΡΡΡΠ°Π½Π΅Π½ΠΈΠ΅ ΠΏΡΠΈΡΠΈΠ½Ρ Π΄Π΅ΡΠ΅ΠΊΡΠ° ΠΈ ΡΡΠΈΠΌΡΠ»ΡΡΠΈΡ ΠΏΡΠΎΡΠ΅ΡΡΠΎΠ² Π·Π°ΠΆΠΈΠ²Π»Π΅Π½ΠΈΡ, ΡΡΠΎ Π²ΠΎΠ·ΠΌΠΎΠΆΠ½ΠΎ ΠΎΡΡΡΠ΅ΡΡΠ²ΠΈΡΡ ΠΏΡΠΈΡΠΌΠΎΠΌ ΡΠ°Π·Π»ΠΈΡΠ½ΡΡ ΡΠ²Π΅ΡΠ΅ΠΉ, Π½Π°ΠΏΡΠΈΠΌΠ΅Ρ, ΠΠ΅ΠΏΠ°Π½ΡΠΎΠ»Π°.
ΠΡΠΈΠΆΠΈΠ³Π°Π½ΠΈΠ΅ ΠΏΡΠΎΠ²ΠΎΠ΄ΠΈΡΡΡ ΠΏΡΠΈ ΠΎΠ±Π½Π°ΡΡΠΆΠ΅Π½ΠΈΠΈ ΡΠΊΡΠΎΠΏΠΈΠΈ. ΠΠ΅ΡΠ΅Π΄ ΡΠ΅ΠΌ ΠΊΠ°ΠΊ ΠΎΡΡΡΠ΅ΡΡΠ²ΠΈΡΡ ΠΏΡΠΈΠΆΠΈΠ³Π°Π½ΠΈΠ΅, Π½ΡΠΆΠ½ΠΎ ΡΡΡΡΠ°Π½ΠΈΡΡ ΠΈΠ½ΡΠ΅ΠΊΡΠΈΡ ΠΈ Π²ΠΎΡΠΏΠ°Π»Π΅Π½ΠΈΠ΅. ΠΡΠΈΠΆΠΈΠ³Π°Π½ΠΈΠ΅ ΠΏΡΠΎΠ²ΠΎΠ΄ΠΈΡΡΡ ΠΏΠΎΡΡΠ΅Π΄ΡΡΠ²ΠΎΠΌ Π½Π΅ΡΠΊΠΎΠ»ΡΠΊΠΈΡ ΠΌΠ΅ΡΠΎΠ΄ΠΈΠΊ, ΠΎΠ΄Π½ΠΎΠΉ ΠΈΠ· ΠΊΠΎΡΠΎΡΡΡ ΡΠ²Π»ΡΠ΅ΡΡΡ Π΄ΠΈΠ°ΡΠ΅ΡΠΌΠΎΠΊΠΎΠ°Π³ΡΠ»ΡΡΠΈΡ. ΠΠΎΡΠ»Π΅ ΡΠΎΠ³ΠΎ ΠΊΠ°ΠΊ ΠΏΠ°ΡΠΈΠ΅Π½ΡΠΊΠ° ΠΏΡΠΈΠΆΠ³Π»Π° ΡΡΠΎΠ·ΠΈΡ, Π³ΠΈΠ½Π΅ΠΊΠΎΠ»ΠΎΠ³ΠΈ ΠΈΠ½ΠΎΠ³Π΄Π° ΡΠ΅ΠΊΠΎΠΌΠ΅Π½Π΄ΡΡΡ ΠΏΡΠΈΡΠΌ ΡΠ²Π΅ΡΠ΅ΠΉ, Π½Π°ΠΏΡΠΈΠΌΠ΅Ρ, ΠΠ΅ΠΏΠ°Π½ΡΠΎΠ».
Π‘Π²Π΅ΡΠΈ ΠΏΠΎΡΠ»Π΅ ΠΏΡΠΈΠΆΠΈΠ³Π°Π½ΠΈΡ ΡΡΠΎΠ·ΠΈΠΈ ΡΠ΅ΠΉΠΊΠΈ ΠΌΠ°ΡΠΊΠΈ ΡΠΏΠΎΡΠΎΠ±ΡΡΠ²ΡΡΡ Π·Π°ΠΆΠΈΠ²Π»Π΅Π½ΠΈΡ ΡΠΏΠΈΡΠ΅Π»ΠΈΠ°Π»ΡΠ½ΠΎΠΉ ΡΠΊΠ°Π½ΠΈ, ΡΠ°ΡΡΠ²ΠΎΡΠ΅Π½ΠΈΡ ΡΡΡΡΠΏΠ° ΠΈΠ»ΠΈ ΠΊΠΎΡΠΎΡΠΊΠΈ, ΠΏΡΠ΅ΠΏΡΡΡΡΠ²ΡΡΡ ΠΏΡΠΈΡΠΎΠ΅Π΄ΠΈΠ½Π΅Π½ΠΈΡ ΠΈΠ½ΡΠ΅ΠΊΡΠΈΠΈ. ΠΠ΄Π½Π°ΠΊΠΎ Π½Π΅ ΠΊΠ°ΠΆΠ΄Π°Ρ ΡΠ°ΠΊΡΠΈΠΊΠ° ΠΏΡΠΈΠΆΠΈΠ³Π°Π½ΠΈΡ ΡΡΠ΅Π±ΡΠ΅Ρ ΠΈΡΠΏΠΎΠ»ΡΠ·ΠΎΠ²Π°Π½ΠΈΡ ΡΠ²Π΅ΡΠ΅ΠΉ. ΠΠΎΡΠ»Π΅ ΡΠΎΠ³ΠΎ ΠΊΠ°ΠΊ ΠΆΠ΅Π½ΡΠΈΠ½Π° ΠΏΡΠΈΠΆΠ³Π»Π° Π΄Π΅ΡΠ΅ΠΊΡ Π΄ΠΈΠ°ΡΠ΅ΡΠΌΠΎΠΊΠΎΠ°Π³ΡΠ»ΡΡΠΈΠ΅ΠΉ, ΠΆΠ΅Π»Π°ΡΠ΅Π»ΡΠ½ΠΎ ΠΏΡΠΈΠΌΠ΅Π½ΡΡΡ ΡΠ²Π΅ΡΠΈ, Π² ΡΠ°ΡΡΠ½ΠΎΡΡΠΈ, ΠΠ΅ΠΏΠ°Π½ΡΠΎΠ».
ΠΠΎΡΠ»Π΅ ΠΏΡΠΈΠΆΠΈΠ³Π°Π½ΠΈΡ Π΄ΠΎΠΊΡΠΎΡΠ° Π½Π°Π·Π½Π°ΡΠ°ΡΡ ΠΏΡΠΎΡΠΈΠ²ΠΎΠ²ΠΎΡΠΏΠ°Π»ΠΈΡΠ΅Π»ΡΠ½ΡΠ΅, Π°Π½ΡΠΈΠ±Π°ΠΊΡΠ΅ΡΠΈΠ°Π»ΡΠ½ΡΠ΅, Π·Π°ΠΆΠΈΠ²Π»ΡΡΡΠΈΠ΅ ΠΈ Π΄ΡΡΠ³ΠΈΠ΅ ΡΠ°Π·Π½ΠΎΠ²ΠΈΠ΄Π½ΠΎΡΡΠΈ ΡΠ²Π΅ΡΠ΅ΠΉ.
ΠΠΊΡΠΎΠΏΠΈΡ ΠΌΠΎΠΆΠ½ΠΎ ΡΡΡΡΠ°Π½ΠΈΡΡ ΠΏΡΠΈ ΠΏΠΎΠΌΠΎΡΠΈ ΡΠ»Π΅Π΄ΡΡΡΠΈΡ ΡΠΏΠΎΡΠΎΠ±ΠΎΠ² ΠΏΡΠΈΠΆΠΈΠ³Π°Π½ΠΈΡ ΠΈ ΠΊΡΡΡΠ° ΡΠ²Π΅ΡΠ΅ΠΉ.
- ΠΠΈΠ°ΡΠ΅ΡΠΌΠΎΠΊΠΎΠ°Π³ΡΠ»ΡΡΠΈΡ. ΠΠ΄ΠΈΠ½ ΠΈΠ· ΡΠ°ΠΌΡΡ ΡΡΡΠ΅ΠΊΡΠΈΠ²Π½ΡΡ ΡΠΏΠΎΡΠΎΠ±ΠΎΠ² ΠΏΡΠΈΠΆΠΈΠ³Π°Π½ΠΈΡ, Π½Π°Π·ΡΠ²Π°Π΅ΠΌΡΠΉ Π΄ΠΈΠ°ΡΠ΅ΡΠΌΠΎΠΊΠΎΠ°Π³ΡΠ»ΡΡΠΈΠ΅ΠΉ, ΠΈΠΌΠ΅Π΅Ρ ΠΌΠ½ΠΎΠΆΠ΅ΡΡΠ²ΠΎ ΠΎΡΡΠΈΡΠ°ΡΠ΅Π»ΡΠ½ΡΡ ΡΡΠΎΡΠΎΠ½. ΠΡΠΎΠ·ΠΈΡ ΠΌΠΎΠΆΠ½ΠΎ ΠΏΡΠΈΠΆΠ΅ΡΡ ΡΠ»Π΅ΠΊΡΡΠΈΡΠ΅ΡΠΊΠΈΠΌ ΡΠΎΠΊΠΎΠΌ ΠΈΠ»ΠΈ Π΄ΠΈΠ°ΡΠ΅ΡΠΌΠΎΠΊΠΎΠ°Π³ΡΠ»ΡΡΠΈΠ΅ΠΉ, ΠΏΠΎΡΠ»Π΅ ΡΠ΅Π³ΠΎ ΡΠΎΡΠΌΠΈΡΡΠ΅ΡΡΡ ΠΊΠΎΡΠΎΡΠΊΠ° Π½Π° ΠΏΠΎΠ²Π΅ΡΡ Π½ΠΎΡΡΠΈ ΡΠ΅ΠΉΠΊΠΈ ΠΌΠ°ΡΠΊΠΈ, Π½Π°Π·ΡΠ²Π°Π΅ΠΌΠ°Ρ ΡΡΡΡΠΏΠΎΠΌ. ΠΡΡΠ΅Π·Π½ΠΎΠ²Π΅Π½ΠΈΠ΅ ΡΡΡΡΠΏΠ° Π½Π°Π±Π»ΡΠ΄Π°Π΅ΡΡΡ Π½Π° Π΄Π΅ΡΡΡΡΠΉ β ΡΠ΅ΡΡΡΠ½Π°Π΄ΡΠ°ΡΡΠΉ Π΄Π΅Π½Ρ. ΠΠΎΡΡΡΠ°Π½ΠΎΠ²Π»Π΅Π½ΠΈΠ΅ ΡΠΊΠ°Π½ΠΈ ΠΏΠΎΡΠ»Π΅ ΠΏΡΠΈΠΆΠΈΠ³Π°Π½ΠΈΡ ΡΠΎΠΊΠΎΠΌ ΠΈΠ»ΠΈ Π΄ΠΈΠ°ΡΠ΅ΡΠΌΠΎΠΊΠΎΠ°Π³ΡΠ»ΡΡΠΈΠΈ ΠΏΡΠΎΠΈΡΡ ΠΎΠ΄ΠΈΡ Π² ΡΠ΅ΡΠ΅Π½ΠΈΠ΅ Π΄Π²ΡΡ ΠΌΠ΅ΡΡΡΠ΅Π². Π ΠΏΠ΅ΡΠΈΠΎΠ΄ Π·Π°ΠΆΠΈΠ²Π»Π΅Π½ΠΈΡ Π½Π΅ ΠΈΡΠΊΠ»ΡΡΠ΅Π½Ρ ΠΊΡΠΎΠ²ΡΠ½ΠΈΡΡΡΠ΅ ΠΈ ΡΡΠΊΡΠΎΠ²ΠΈΡΠ½ΡΠ΅ Π²ΡΠ΄Π΅Π»Π΅Π½ΠΈΡ.
Π Π²ΠΎΡΡΡΠ°Π½ΠΎΠ²ΠΈΡΠ΅Π»ΡΠ½ΠΎΠΌ ΠΏΠ΅ΡΠΈΠΎΠ΄Π΅ ΠΏΠΎΡΠ»Π΅ Π΄ΠΈΠ°ΡΠ΅ΡΠΌΠΎΠΊΠΎΠ°Π³ΡΠ»ΡΡΠΈΠΈ ΠΆΠ΅Π½ΡΠΈΠ½Π΅ ΡΠ΅ΠΊΠΎΠΌΠ΅Π½Π΄ΠΎΠ²Π°Π½ΠΎ ΠΈΡΠΏΠΎΠ»ΡΠ·ΠΎΠ²Π°ΡΡ ΡΠ²Π΅ΡΠΈ, ΠΎΠ±Π»Π°Π΄Π°ΡΡΠΈΠ΅ ΠΏΡΠΎΡΠΈΠ²ΠΎΠ²ΠΎΡΠΏΠ°Π»ΠΈΡΠ΅Π»ΡΠ½ΡΠΌ ΠΈ Π·Π°ΠΆΠΈΠ²Π»ΡΡΡΠΈΠΌ Π΄Π΅ΠΉΡΡΠ²ΠΈΠ΅ΠΌ. Π‘Π²Π΅ΡΠΈ, ΡΠΏΠΎΡΠΎΠ±ΡΡΠ²ΡΡΡΠΈΠ΅ ΡΠ΅Π³Π΅Π½Π΅ΡΠ°ΡΠΈΠΈ ΡΠΊΠ°Π½Π΅ΠΉ, ΠΏΡΠΈΠΌΠ΅Π½ΡΡΡ ΠΏΠΎΡΠ»Π΅ Π½ΠΎΡΠΌΠ°Π»ΠΈΠ·Π°ΡΠΈΠΈ Π²ΡΠ΄Π΅Π»Π΅Π½ΠΈΠΉ. ΠΠΎΠ²ΠΎΠ»ΡΠ½ΠΎ ΡΠ°ΡΡΠΎ Π³ΠΈΠ½Π΅ΠΊΠΎΠ»ΠΎΠ³ΠΈ ΡΠ΅ΠΊΠΎΠΌΠ΅Π½Π΄ΡΡΡ ΡΠ²Π΅ΡΠΈ ΠΠ΅ΠΏΠ°Π½ΡΠΎΠ», ΠΏΠΎΡΠ»Π΅ ΡΠΎΠ³ΠΎ ΠΊΠ°ΠΊ ΠΆΠ΅Π½ΡΠΈΠ½Π° ΠΏΡΠΈΠΆΠ³Π»Π° ΡΡΠΎΠ·ΠΈΡ Π΄ΠΈΠ°ΡΠ΅ΡΠΌΠΎΠΊΠΎΠ°Π³ΡΠ»ΡΡΠΈΠ΅ΠΉ.
ΠΠ΅ΠΏΠ°Π½ΡΠΎΠ» ΠΈΠΌΠ΅Π΅Ρ Π½Π΅ΡΠΊΠΎΠ»ΡΠΊΠΎ Π»Π΅ΠΊΠ°ΡΡΡΠ²Π΅Π½Π½ΡΡ ΡΠΎΡΠΌ. Π ΡΠ°ΡΡΠ½ΠΎΡΡΠΈ, ΠΌΠ½ΠΎΠ³ΠΈΠ΅ ΠΆΠ΅Π½ΡΠΈΠ½Ρ ΠΈ ΠΈΡΠΏΠΎΠ»ΡΠ·ΡΡΡ ΠΠ΅ΠΏΠ°Π½ΡΠΎΠ» Π² Π²ΠΈΠ΄Π΅ Π³Π΅Π»Ρ, ΡΠ²Π΅ΡΠ΅ΠΉ, ΠΌΠ°Π·ΠΈ ΠΈΠ»ΠΈ Π°ΡΡΠΎΠ·ΠΎΠ»Ρ. ΠΠ΅ΠΏΠ°Π½ΡΠΎΠ» ΠΎΠ±Π»Π°Π΄Π°Π΅Ρ Ρ ΠΎΡΠΎΡΠ΅ΠΉ Π²ΡΠ°ΡΡΠ²Π°Π΅ΠΌΠΎΡΡΡΡ ΠΈ Π²ΡΡΠΎΠΊΠΎΠΉ ΡΡΡΠ΅ΠΊΡΠΈΠ²Π½ΠΎΡΡΡΡ.
- Π Π°Π΄ΠΈΠΎΠ²ΠΎΠ»Π½ΠΎΠ²ΠΎΠ΅ ΠΏΡΠΈΠΆΠΈΠ³Π°Π½ΠΈΠ΅. ΠΠΎΡΠ»Π΅ ΡΠΎΠ³ΠΎ ΠΊΠ°ΠΊ ΠΏΠ°ΡΠΈΠ΅Π½ΡΠΊΠ° ΠΏΡΠΈΠΆΠ³Π»Π° ΡΡΠΎΠ·ΠΈΡ ΡΠ°Π΄ΠΈΠΎΠ²ΠΎΠ»Π½Π°ΠΌΠΈ, ΠΎΡΠ»ΠΎΠΆΠ½Π΅Π½ΠΈΡ ΠΎΠ±ΡΡΠ½ΠΎ Π½Π΅ Π²ΡΡΡΠ΅ΡΠ°ΡΡΡΡ, Π² ΠΎΡΠ»ΠΈΡΠΈΠ΅ ΠΎΡ Π΄ΠΈΠ°ΡΠ΅ΡΠΌΠΎΠΊΠΎΠ°Π³ΡΠ»ΡΡΠΈΠΈ. Π Π°Π΄ΠΈΠΎΠ²ΠΎΠ»Π½ΠΎΠ²ΠΎΠ΅ ΠΏΡΠΈΠΆΠΈΠ³Π°Π½ΠΈΠ΅ ΡΡΠΈΡΠ°Π΅ΡΡΡ ΡΠ°ΠΌΡΠΌ ΡΠ°Π΄ΡΡΠΈΠΌ ΠΌΠ΅ΡΠΎΠ΄ΠΎΠΌ ΡΡΡΡΠ°Π½Π΅Π½ΠΈΡ ΡΡΠΎΠ·ΠΈΠΈ, ΠΊΠΎΡΠΎΡΠΎΠ΅ Π½Π΅ ΡΡΠ΅Π±ΡΠ΅Ρ ΠΈΡΠΏΠΎΠ»ΡΠ·ΠΎΠ²Π°Π½ΠΈΡ ΠΏΡΠΎΡΠΈΠ²ΠΎΠ²ΠΎΡΠΏΠ°Π»ΠΈΡΠ΅Π»ΡΠ½ΡΡ ΡΠ²Π΅ΡΠ΅ΠΉ. Π ΠΊΠ°ΡΠ΅ΡΡΠ²Π΅ ΠΏΡΠΎΡΠΈΠ»Π°ΠΊΡΠΈΠΊΠΈ ΠΌΠΎΠΆΠ½ΠΎ ΠΏΡΠΈΠΌΠ΅Π½ΡΡΡ ΡΠ²Π΅ΡΠΈ ΠΠ΅ΠΏΠ°Π½ΡΠΎΠ».
- ΠΡΠΈΠΎΠ΄Π΅ΡΡΡΡΠΊΡΠΈΡ. ΠΡΠΈΠΆΠ΅ΡΡ ΠΆΠΈΠ΄ΠΊΠΈΠΌ Π°Π·ΠΎΡΠΎΠΌ ΠΌΠΎΠΆΠ½ΠΎ ΡΠΎΠ»ΡΠΊΠΎ Π½Π΅Π·Π½Π°ΡΠΈΡΠ΅Π»ΡΠ½ΡΡ ΠΏΠΎ ΡΠ°Π·ΠΌΠ΅ΡΠ°ΠΌ ΡΡΠΎΠ·ΠΈΡ. ΠΠΎΡΠ»Π΅ ΠΎΡΡ ΠΎΠΆΠ΄Π΅Π½ΠΈΡ ΡΡΡΡΠΏΠ° Π²ΠΎΠ·ΠΌΠΎΠΆΠ½ΠΎ ΠΈΡΠΏΠΎΠ»ΡΠ·ΠΎΠ²Π°Π½ΠΈΠ΅ ΡΠ΅Π³Π΅Π½Π΅ΡΠΈΡΡΡΡΠΈΡ ΡΠ²Π΅ΡΠ΅ΠΉ, Π½Π°ΠΏΡΠΈΠΌΠ΅Ρ, ΠΠ΅ΠΏΠ°Π½ΡΠΎΠ»Π° ΠΈΠ»ΠΈ ΠΠ΅ΡΠΈΠ»ΡΡΠ°ΡΠΈΠ»Π°.
- ΠΠ°Π·Π΅ΡΠ½Π°Ρ Π²Π°ΠΏΠΎΡΠΈΠ·Π°ΡΠΈΡ. Π ΠΎΡΠ½ΠΎΠ²Π΅ ΠΌΠ΅ΡΠΎΠ΄Π° ΠΏΡΠΈΠΆΠΈΠ³Π°Π½ΠΈΡ β ΠΈΡΠΏΠΎΠ»ΡΠ·ΠΎΠ²Π°Π½ΠΈΠ΅ Π»Π°Π·Π΅ΡΠ½ΠΎΠ³ΠΎ Π»ΡΡΠ°, Π²ΡΠΏΠ°ΡΠΈΠ²Π°ΡΡΠ΅Π³ΠΎ ΡΡΠΎΠ·ΠΈΠ²Π½ΡΠ΅ ΠΊΠ»Π΅ΡΠΊΠΈ. ΠΠΎΠ³Π΄Π° ΠΏΠ°ΡΠΈΠ΅Π½ΡΠΊΠ° ΠΏΡΠΈΠΆΠ³Π»Π° Π΄Π΅ΡΠ΅ΠΊΡ ΠΌΠ΅ΡΠΎΠ΄ΠΎΠΌ Π»Π°Π·Π΅ΡΠ½ΠΎΠΉ Π²Π°ΠΏΠΎΡΠΈΠ·Π°ΡΠΈΠΈ, ΡΠ΅ΡΠ΅Π· Π½Π΅ΡΠΊΠΎΠ»ΡΠΊΠΎ Π΄Π½Π΅ΠΉ ΠΌΠΎΠΆΠ½ΠΎ Π²ΠΎΡΠΏΠΎΠ»ΡΠ·ΠΎΠ²Π°ΡΡΡΡ ΠΠ΅ΠΏΠ°Π½ΡΠΎΠ»ΠΎΠΌ ΠΈΠ»ΠΈ Π΄ΡΡΠ³ΠΈΠΌΠΈ Π·Π°ΠΆΠΈΠ²Π»ΡΡΡΠΈΠΌΠΈ ΡΠ²Π΅ΡΠ°ΠΌΠΈ.
ΠΡΠΈΠΌΠ΅Π½ΡΡΡ ΡΠ²Π΅ΡΠΈ ΠΏΠΎΡΠ»Π΅ ΠΏΡΠΈΠΆΠΈΠ³Π°Π½ΠΈΡ ΡΡΠΎΠ·ΠΈΠΈ, Π² ΡΠ°ΡΡΠ½ΠΎΡΡΠΈ, ΠΌΠ΅ΡΠΎΠ΄ΠΎΠΌΒ Π΄ΠΈΠ°ΡΠ΅ΡΠΌΠΎΠΊΠΎΠ°Π³ΡΠ»ΡΡΠΈΠΈ, ΠΌΠΎΠΆΠ½ΠΎ ΡΠΎΠ»ΡΠΊΠΎ ΠΏΠΎ Π½Π°Π·Π½Π°ΡΠ΅Π½ΠΈΡ Π²ΡΠ°ΡΠ°.
ginekola.ru
Π‘Π²Π΅ΡΠΈ ΠΏΠΎΡΠ»Π΅ ΠΏΡΠΈΠΆΠΈΠ³Π°Π½ΠΈΡ ΡΡΠΎΠ·ΠΈΠΈ ΡΠ΅ΠΉΠΊΠΈ ΠΌΠ°ΡΠΊΠΈ: ΠΏΠΎΠΊΠ°Π·Π°Π½ΠΈΡ ΠΈ ΡΠ΅ΠΊΠΎΠΌΠ΅Π½Π΄ΡΠ΅ΠΌΡΠ΅ ΠΏΡΠ΅ΠΏΠ°ΡΠ°ΡΡ
ΠΡΠΎΠ·ΠΈΠ²Π½ΡΠ΅ ΠΏΠΎΡΠ°ΠΆΠ΅Π½ΠΈΡ ΡΠ΅ΠΉΠΊΠΈ ΠΌΠ°ΡΠΊΠΈ ΠΈΠΌΠ΅ΡΡ ΡΠΈΡΠΎΠΊΠΎΠ΅ ΡΠ°ΡΠΏΡΠΎΡΡΡΠ°Π½Π΅Π½ΠΈΠ΅ ΡΡΠ΅Π΄ΠΈ ΠΆΠ΅Π½ΡΠΈΠ½. ΠΠ½ΠΈ ΠΏΡΠ΅Π΄ΡΡΠ°Π²Π»ΡΡΡ ΡΠΎΠ±ΠΎΠΉ ΡΠ·Π²ΠΎΡΠΊΠΈ Π½Π° ΠΏΠΎΠ²Π΅ΡΡ Π½ΠΎΡΡΠΈ ΡΠ»ΠΈΠ·ΠΈΡΡΠΎΠΉ. ΠΡΠΈ ΡΡΠ΅Π΄Π½ΠΈΡ ΠΈ ΡΡΠΆΠ΅Π»ΡΡ ΡΠΎΡΡΠΎΡΠ½ΠΈΡΡ , ΠΊΠΎΠ³Π΄Π° ΠΌΠ΅ΡΡΠ½ΡΠ΅ ΡΡΠ΅Π΄ΡΡΠ²Π° Π½Π΅ ΠΏΠΎΠΌΠΎΠ³Π°ΡΡ, ΠΏΡΠΈΠΌΠ΅Π½ΡΡΡ Π°ΠΏΠΏΠ°ΡΠ°ΡΠ½ΡΠ΅ ΠΌΠ΅ΡΠΎΠ΄Ρ Π»Π΅ΡΠ΅Π½ΠΈΡ. Π Π½ΠΈΠΌ ΠΎΡΠ½ΠΎΡΠΈΡΡΡΡ ΠΏΡΠΈΠΆΠΈΠ³Π°Π½ΠΈΠ΅ ΠΈΠ·ΡΡΠ·Π²Π»Π΅Π½ΠΈΠΉ (Π»Π°Π·Π΅ΡΠΎΠΌ, Π°Π·ΠΎΡΠΎΠΌ ΠΈΠ»ΠΈ ΡΠΎΠΊΠΎΠΌ). ΠΠΎΡΠ»Π΅ ΠΏΡΠΎΡΠ΅Π΄ΡΡΡ Π½Π΅ΠΎΠ±Ρ ΠΎΠ΄ΠΈΠΌΠΎ Π²ΡΠ΅ΠΌΡ Π½Π° Π²ΠΎΡΡΡΠ°Π½ΠΎΠ²Π»Π΅Π½ΠΈΠ΅ ΠΈ Π·Π°ΠΆΠΈΠ²Π»Π΅Π½ΠΈΠ΅ ΡΠΊΠ°Π½Π΅ΠΉ. Π‘Π²Π΅ΡΠΈ ΠΏΠΎΡΠ»Π΅ ΠΏΡΠΈΠΆΠΈΠ³Π°Π½ΠΈΡ ΡΡΠΎΠ·ΠΈΠΈ ΡΠ΅ΠΉΠΊΠΈ ΠΌΠ°ΡΠΊΠΈ ΡΠΏΠΎΡΠΎΠ±ΡΡΠ²ΡΡΡ Π±ΡΡΡΡΠΎΠΌΡ ΠΏΡΠΎΡΠ΅ΡΡΡ ΡΠ΅Π³Π΅Π½Π΅ΡΠ°ΡΠΈΠΈ.
Π ΠΎΠ»Ρ ΡΠ²Π΅ΡΠ΅ΠΉ ΠΏΠΎΡΠ»Π΅ Π»Π΅ΡΠ΅Π½ΠΈΡ ΠΏΡΠΈΠΆΠΈΠ³Π°Π½ΠΈΠ΅ΠΌ
ΠΠ΅ΡΠΎΠ΄ ΠΏΡΠΈΠΆΠΈΠ³Π°Π½ΠΈΡ Π΄Π»Ρ Π»Π΅ΡΠ΅Π½ΠΈΡ ΡΡΠΎΠ·ΠΈΠΈ Π½Π°Π·Π½Π°ΡΠ°Π΅ΡΡΡ ΠΈΠ½Π΄ΠΈΠ²ΠΈΠ΄ΡΠ°Π»ΡΠ½ΠΎ Π΄Π»Ρ ΠΊΠ°ΠΆΠ΄ΠΎΠΉ ΠΆΠ΅Π½ΡΠΈΠ½Ρ. ΠΠ³ΠΎ ΠΏΡΠΈΠΌΠ΅Π½Π΅Π½ΠΈΠ΅ Π·Π°Π²ΠΈΡΠΈΡ ΠΎΡ ΡΠΎΡΡΠΎΡΠ½ΠΈΡ ΡΠ΅ΠΉΠΊΠΈ, ΠΎΡ ΡΠ΅Π·ΡΠ»ΡΡΠ°ΡΠΎΠ² Π°Π½Π°Π»ΠΈΠ·ΠΎΠ² ΠΈ ΠΎΡΠΌΠΎΡΡΠ° Π³ΠΈΠ½Π΅ΠΊΠΎΠ»ΠΎΠ³Π°.
ΠΡΠΈΠΆΠΈΠ³Π°Π½ΠΈΠ΅ ΠΏΡΠΎΠΈΠ·Π²ΠΎΠ΄ΡΡ Ρ ΠΈΡΠΏΠΎΠ»ΡΠ·ΠΎΠ²Π°Π½ΠΈΠ΅ΠΌ Ρ ΠΈΠΌΠΈΡΠ΅ΡΠΊΠΈΡ Π²Π΅ΡΠ΅ΡΡΠ² (ΡΠΎΠ»ΠΊΠΎΠ²Π°Π³ΠΈΠ½) ΠΈΠ»ΠΈ ΠΌΠ΅ΡΠΎΠ΄Π°ΠΌΠΈ ΡΠΈΠ·ΠΈΡΠ΅ΡΠΊΠΎΠ³ΠΎ Π²ΠΎΠ·Π΄Π΅ΠΉΡΡΠ²ΠΈΡ:
- Π΄ΠΈΠ°ΡΠ΅ΡΠΌΠΎΡΠ»Π΅ΠΊΡΡΠΎΠΊΠΎΠ°Π³ΡΠ»ΡΡΠΈΡ (Π΄Π΅ΠΉΡΡΠ²ΠΈΠ΅ ΡΠΎΠΊΠΎΠΌ) ΡΠ²Π»ΡΠ΅ΡΡΡ ΡΠ°ΡΠΏΡΠΎΡΡΡΠ°Π½ΡΠ½Π½ΡΠΌ ΠΈ ΡΡΡΠ°ΡΠ΅Π²ΡΠΈΠΌ ΡΠΏΠΎΡΠΎΠ±ΠΎΠΌ Π»Π΅ΡΠ΅Π½ΠΈΡ. Π¨ΠΈΡΠΎΠΊΠΎ ΠΏΡΠΈΠΌΠ΅Π½ΡΠ»Π°ΡΡ Π½Π΅ΡΠΊΠΎΠ»ΡΠΊΠΎ Π»Π΅Ρ Π½Π°Π·Π°Π΄.
- ΠΏΡΠΈΠΆΠΈΠ³Π°Π½ΠΈΠ΅ Π»Π°Π·Π΅ΡΠΎΠΌ (Π»Π°Π·Π΅ΡΠΎΠΊΠΎΠ°Π³ΡΠ»ΡΡΠΈΡ),
- ΠΏΡΠΈΠΆΠΈΠ³Π°Π½ΠΈΠ΅ Π°Π·ΠΎΡΠΎΠΌ (ΠΊΡΠΈΠΎΠ΄Π΅ΡΡΡΡΠΊΡΠΈΡ),
- ΠΏΡΠΈΠΆΠΈΠ³Π°Π½ΠΈΠ΅ Ρ ΠΈΡΠΏΠΎΠ»ΡΠ·ΠΎΠ²Π°Π½ΠΈΠ΅ΠΌ ΡΠ°Π΄ΠΈΠΎΠ²ΠΎΠ»Π½ (ΡΠ°Π΄ΠΈΠΎΠ²ΠΎΠ»Π½ΠΎΠ²Π°Ρ ΠΊΠΎΠ°Π³ΡΠ»ΡΡΠΈΡ).
ΠΠ° ΠΌΠ΅ΡΡΠ΅ Π²ΠΎΠ·Π΄Π΅ΠΉΡΡΠ²ΠΈΡ Π»ΡΠ±ΡΠΌ ΡΠΏΠΎΡΠΎΠ±ΠΎΠΌ ΠΎΠ±ΡΠ°Π·ΡΠ΅ΡΡΡ ΡΡΠ±ΡΠΎΠ²Π°Ρ ΡΠΊΠ°Π½Ρ. ΠΠΎΠ΄ Π½Π΅ΠΉ ΠΏΡΠΎΠΈΡΡ ΠΎΠ΄ΠΈΡ ΡΠ΅Π³Π΅Π½Π΅ΡΠ°ΡΠΈΡ ΠΊΠ»Π΅ΡΠΎΠΊ. Π ΡΡΠΎΡ ΠΏΠ΅ΡΠΈΠΎΠ΄ Π½Π°Π·Π½Π°ΡΠ°ΡΡ Π·Π°ΠΆΠΈΠ²Π»ΡΡΡΠΈΠ΅ ΡΠ²Π΅ΡΠΈ ΠΏΠΎΡΠ»Π΅ ΠΏΡΠΈΠΆΠΈΠ³Π°Π½ΠΈΡ ΡΡΠΎΠ·ΠΈΠΈ ΡΠ΅ΠΉΠΊΠΈ ΠΌΠ°ΡΠΊΠΈ.
Π‘ΡΠΏΠΏΠΎΠ·ΠΈΡΠΎΡΠΈΠΈ ΠΎΠΊΠ°Π·ΡΠ²Π°ΡΡ ΠΏΠΎΠ»ΠΎΠΆΠΈΡΠ΅Π»ΡΠ½ΡΠ΅ ΡΡΡΠ΅ΠΊΡΡ ΠΏΠΎΡΠ»Π΅ ΠΏΡΠΎΡΠ΅Π΄ΡΡΡ:
- ΡΠΏΠΎΡΠΎΠ±ΡΡΠ²ΡΡΡ Π±ΡΡΡΡΠΎΠΌΡ Π·Π°ΠΆΠΈΠ²Π»Π΅Π½ΠΈΡ,
- ΠΏΡΠ΅ΠΏΡΡΡΡΠ²ΡΡΡ ΡΠ°Π·Π²ΠΈΡΠΈΡ ΠΈΠ½ΡΠ΅ΠΊΡΠΈΠΉ, Π½Π΅ Π½Π°ΡΡΡΠ°Ρ Π±Π°Π»Π°Π½Ρ ΠΌΠΈΠΊΡΠΎΡΠ»ΠΎΡΡ Π²Π»Π°Π³Π°Π»ΠΈΡΠ°,
- ΡΡΡΡΠ°Π½ΡΡΡ Π±ΠΎΠ»Π΅Π²ΡΠ΅ ΠΎΡΡΡΠ΅Π½ΠΈΡ, Π·Π° ΡΡΠ΅Ρ ΡΠΌΡΠ³ΡΠ°ΡΡΠ΅Π³ΠΎ Π΄Π΅ΠΉΡΡΠ²ΠΈΡ,
- ΡΠΌΠ΅Π½ΡΡΠ°ΡΡ Π²ΠΎΡΠΏΠ°Π»ΠΈΡΠ΅Π»ΡΠ½ΡΠΉ ΠΏΡΠΎΡΠ΅ΡΡ.
Π‘Π²Π΅ΡΠΈ, Π½Π°Π·Π½Π°ΡΠ°Π΅ΠΌΡΠ΅ ΠΏΠΎΡΠ»Π΅ ΠΏΡΠΈΠΆΠΈΠ³Π°Π½ΠΈΡ
ΠΠ°ΠΊΠΈΠ΅ ΡΠ²Π΅ΡΠΈ ΠΏΠΎΡΠ»Π΅ ΠΏΡΠΈΠΆΠΈΠ³Π°Π½ΠΈΡ ΡΡΠΎΠ·ΠΈΠΈ ΡΠ΅ΠΉΠΊΠΈ ΠΌΠ°ΡΠΊΠΈ Π½Π°Π·Π½Π°ΡΠΈΡΡ ΡΠ΅ΡΠ°Π΅Ρ Π»Π΅ΡΠ°ΡΠΈΠΉ Π²ΡΠ°Ρ. ΠΠ½Π°ΡΠ΅Π½ΠΈΠ΅ ΠΏΡΠΈ Π²ΡΠ±ΠΎΡΠ΅ ΠΏΡΠ΅ΠΏΠ°ΡΠ°ΡΠ° ΠΈΠΌΠ΅Π΅Ρ ΡΠ»Π΅Π΄ΡΡΡΠ΅Π΅:
- ΠΈΡΠΏΠΎΠ»ΡΠ·ΡΠ΅ΠΌΡΠΉ ΡΠΏΠΎΡΠΎΠ± Π»Π΅ΡΠ΅Π½ΠΈΡ (ΠΊΡΠΈΠΎΠ΄Π΅ΡΡΡΡΠΊΡΠΈΡ Π½Π΅ ΡΡΠ΅Π±ΡΠ΅Ρ Π΄ΠΎΠΏΠΎΠ»Π½ΠΈΡΠ΅Π»ΡΠ½ΡΡ ΠΌΠ΅Ρ Π»Π΅ΡΠ΅Π½ΠΈΡ, Π° ΠΏΠΎΡΠ»Π΅ Π΄ΠΈΠ°ΡΠ΅ΡΠΌΠΎΡΠ»Π΅ΠΊΡΡΠΎΠΊΠΎΠ°Π³ΡΠ»ΡΡΠΈΠΈ ΠΏΡΠΈΠΌΠ΅Π½Π΅Π½ΠΈΠ΅ Π·Π°ΠΆΠΈΠ²Π»ΡΡΡΠΈΡ Π»Π΅ΠΊΠ°ΡΡΡΠ² Π½Π΅ΠΎΠ±Ρ ΠΎΠ΄ΠΈΠΌΠΎ),
- ΡΠΎΡΡΠΎΡΠ½ΠΈΠ΅ ΡΠ΅ΠΉΠΊΠΈ ΠΏΠΎΡΠ»Π΅ ΠΏΡΠΎΡΠ΅Π΄ΡΡΡ,
- Π½Π°Π»ΠΈΡΠΈΠ΅ Ρ ΠΆΠ΅Π½ΡΠΈΠ½Ρ ΠΈΠ½ΡΠ΅ΠΊΡΠΈΠΎΠ½Π½ΡΡ Π·Π°Π±ΠΎΠ»Π΅Π²Π°Π½ΠΈΠΉ, Π΄ΠΈΡΠ±Π°ΠΊΡΠ΅ΡΠΈΠΎΠ·Π° Π²Π»Π°Π³Π°Π»ΠΈΡΠ°,
- ΡΠΎΡΡΠΎΡΠ½ΠΈΠ΅ Π·Π°ΡΠΈΡΠ½ΡΡ ΡΡΠ½ΠΊΡΠΈΠΉ ΠΎΡΠ³Π°Π½ΠΈΠ·ΠΌΠ° (ΠΈΠΌΠΌΡΠ½ΠΈΡΠ΅Ρ),
- ΠΎΡΠΎΠ±Π΅Π½Π½ΠΎΡΡΠΈ ΡΠ΅Π³Π΅Π½Π΅ΡΠ°ΡΠΈΠ²Π½ΠΎΠΉ ΡΡΠ½ΠΊΡΠΈΠΈ ΠΎΡΠ³Π°Π½ΠΈΠ·ΠΌΠ°, ΡΠΊΠΎΡΠΎΡΡΡ Π·Π°ΠΆΠΈΠ²Π»Π΅Π½ΠΈΡ ΡΠ°Π½.
Π Π·Π°Π²ΠΈΡΠΈΠΌΠΎΡΡΠΈ ΠΎΡ ΡΡΠΈΡ ΡΠ°ΠΊΡΠΎΡΠΎΠ² ΠΏΡΠΈΠΌΠ΅Π½ΡΡΡΡΡ ΡΡΠΏΠΏΠΎΠ·ΠΈΡΠΎΡΠΈΠΈ Ρ ΠΏΡΠΎΡΠΈΠ²ΠΎΠ²ΠΎΡΠΏΠ°Π»ΠΈΡΠ΅Π»ΡΠ½ΡΠΌ, Π·Π°ΠΆΠΈΠ²Π»ΡΡΡΠΈΠΌ ΠΈΠ»ΠΈ Π°Π½ΡΠΈΠ±Π°ΠΊΡΠ΅ΡΠΈΠ°Π»ΡΠ½ΡΠΌ ΡΡΡΠ΅ΠΊΡΠΎΠΌ.
ΠΊ ΡΠΎΠ΄Π΅ΡΠΆΠ°Π½ΠΈΡ βΠΠΎΡΠ»Π΅ Π΄ΠΈΠ°ΡΠ΅ΡΠΌΠΎΡΠ»Π΅ΠΊΡΡΠΎΠΊΠΎΠ°Π³ΡΠ»ΡΡΠΈΠΈ
ΠΡΠΈΠΆΠΈΠ³Π°Π½ΠΈΠ΅ ΡΡΠΎΠ·ΠΈΠΈ ΡΠΎΠΊΠΎΠΌ ΠΏΡΠΈΠ²ΠΎΠ΄ΠΈΡ ΠΊ ΠΎΠ±ΡΠ°Π·ΠΎΠ²Π°Π½ΠΈΡ Π½Π° Π΅Π΅ ΠΌΠ΅ΡΡΠ΅ ΡΡΡΡΠΏΠ°, ΠΊΠΎΡΠΎΡΡΠΉ ΠΏΡΠΎΡ ΠΎΠ΄ΠΈΡ ΡΠ΅ΡΠ΅Π· Π΄Π²Π΅ Π½Π΅Π΄Π΅Π»ΠΈ. ΠΠΎ Π²ΡΠ΅ΠΌΡ Π²ΠΎΡΡΡΠ°Π½ΠΎΠ²Π»Π΅Π½ΠΈΡ ΡΠΊΠ°Π½Π΅ΠΉ ΠΌΠΎΠ³ΡΡ Π½Π°Π±Π»ΡΠ΄Π°ΡΡΡΡ ΠΊΡΠΎΠ²ΡΠ½ΠΈΡΡΡΠ΅, Π³Π½ΠΎΠΉΠ½ΡΠ΅ Π²ΡΠ΄Π΅Π»Π΅Π½ΠΈΡ. ΠΠΎΡΠ»Π΅ Π½Π° ΡΠ»ΠΈΠ·ΠΈΡΡΠΎΠΉ ΡΠΎΡΠΌΠΈΡΡΠ΅ΡΡΡ Π³ΡΡΠ±ΡΠΉ ΡΡΠ±Π΅Ρ, ΠΊΠΎΡΠΎΡΡΠΉ ΠΌΠΎΠΆΠ΅Ρ ΠΏΡΠΈΠ²Π΅ΡΡΠΈ ΠΊ Π²ΠΎΠ·Π½ΠΈΠΊΠ½ΠΎΠ²Π΅Π½ΠΈΡ ΠΏΡΠΎΠ±Π»Π΅ΠΌ Π·Π°ΡΠ°ΡΠΈΡ, ΠΊ ΠΎΡΠ»ΠΎΠΆΠ½Π΅Π½ΠΈΡΠΌ ΠΏΡΠΈ Π±Π΅ΡΠ΅ΠΌΠ΅Π½Π½ΠΎΡΡΠΈ ΠΈ ΠΊ ΡΠ»ΠΎΠΆΠ½ΡΠΌ ΡΠΎΠ΄Π°ΠΌ.
ΠΡΠΎΡΠΈΠ²ΠΎΠ²ΠΎΡΠΏΠ°Π»ΠΈΡΠ΅Π»ΡΠ½ΡΠ΅ ΡΠ²Π΅ΡΠΈ Π½Π°Π·Π½Π°ΡΠ°ΡΡ ΠΏΠ΅ΡΠ΅Π΄ ΠΏΡΠΈΠΆΠΈΠ³Π°Π½ΠΈΠ΅ΠΌ. ΠΡΠΈΠΌΠ΅Π½Π΅Π½ΠΈΠ΅ ΠΈΡ Π·Π° Π½Π΅Π΄Π΅Π»Ρ Π΄ΠΎ ΠΏΡΠΎΡΠ΅Π΄ΡΡΡ ΠΏΠΎΠ·Π²ΠΎΠ»ΡΠ΅Ρ ΡΠΎΠΊΡΠ°ΡΠΈΡΡ ΡΠΈΡΠΊ ΡΠ°Π·Π²ΠΈΡΠΈΡ ΠΈΠ½ΡΠ΅ΠΊΡΠΈΠΎΠ½Π½ΡΡ Π·Π°Π±ΠΎΠ»Π΅Π²Π°Π½ΠΈΠΉ ΠΈ ΡΠΌΠ΅Π½ΡΡΠΈΡΡ Π²ΠΎΡΠΏΠ°Π»ΠΈΡΠ΅Π»ΡΠ½ΡΠΉ ΠΏΡΠΎΡΠ΅ΡΡ. Π Π½ΠΈΠΌ ΠΎΡΠ½ΠΎΡΠΈΡΡΡΡ:
- ΠΠ΅ΠΊΡΠΈΠΊΠΎΠ½, ΠΎΠΊΠ°Π·ΡΠ²Π°Π΅Ρ Π°Π½ΡΠΈΡΠ΅ΠΏΡΠΈΡΠ΅ΡΠΊΠΎΠ΅, ΠΏΡΠΎΡΠΈΠ²ΠΎΠ²ΠΎΡΠΏΠ°Π»ΠΈΡΠ΅Π»ΡΠ½ΠΎΠ΅ Π΄Π΅ΠΉΡΡΠ²ΠΈΠ΅,
- ΠΠΎΠ»ΠΈΠΆΠΈΠ½Π°ΠΊΡ, Π’Π΅ΡΠΆΠΈΠ½Π°Π½ β ΠΊΠΎΠΌΠ±ΠΈΠ½ΠΈΡΠΎΠ²Π°Π½Π½ΡΠ΅ ΠΏΡΠ΅ΠΏΠ°ΡΠ°ΡΡ, ΠΎΠ±Π»Π°Π΄Π°ΡΡ ΠΏΡΠΎΡΠΈΠ²ΠΎΠΌΠΈΠΊΡΠΎΠ±Π½ΡΠΌ, ΠΏΡΠΎΡΠΈΠ²ΠΎΠ³ΡΠΈΠ±ΠΊΠΎΠ²ΡΠΌ Π΄Π΅ΠΉΡΡΠ²ΠΈΠ΅ΠΌ.
- ΠΠΈΠ²Π°ΡΠΎΠ», ΠΠ°Π»Π°ΠΈΠ½, ΠΠΈΠΌΠ°ΡΡΡΠΈΠ½ β ΠΏΡΠΎΡΠΈΠ²ΠΎΠ³ΡΠΈΠ±ΠΊΠΎΠ²ΡΠ΅ ΠΏΡΠ΅ΠΏΠ°ΡΠ°ΡΡ,
- Π‘ΠΈΠ½ΡΠΎΠΌΠΈΡΠΈΠ½ΠΎΠ²ΡΠ΅ ΡΠ²Π΅ΡΠΈ, ΠΎΠ±Π»Π°Π΄Π°ΡΡ Π°Π½ΡΠΈΠ±Π°ΠΊΡΠ΅ΡΠΈΠ°Π»ΡΠ½ΡΠΌ ΡΡΡΠ΅ΠΊΡΠΎΠΌ.
ΠΠ°ΠΆΠΈΠ²Π»ΡΡΡΠΈΠ΅ ΡΠ²Π΅ΡΠΈ ΠΏΠΎΡΠ»Π΅ ΠΏΡΠΈΠΆΠΈΠ³Π°Π½ΠΈΡ ΡΡΠΎΠ·ΠΈΠΈ ΡΠ΅ΠΉΠΊΠΈ ΠΌΠ°ΡΠΊΠΈ ΠΏΡΠΈΠΌΠ΅Π½ΡΡΡ, ΠΊΠΎΠ³Π΄Π° Ρ ΠΆΠ΅Π½ΡΠΈΠ½Ρ ΠΏΡΠ΅ΠΊΡΠ°ΡΠ°ΡΡΡΡ ΠΌΠ°ΠΆΡΡΠΈΠ΅ Π²ΡΠ΄Π΅Π»Π΅Π½ΠΈΡ (ΡΠ΅ΡΠ΅Π· ΠΏΡΡΡ Π΄Π½Π΅ΠΉ ΠΏΠΎΡΠ»Π΅ Π΄ΠΈΠ°ΡΠ΅ΡΠΌΠΎΡΠ»Π΅ΠΊΡΡΠΎΠΊΠΎΠ°Π³ΡΠ»ΡΡΠΈΠΈ). ΠΠ΅ΡΠ΅Π΄ ΠΈΡΠΏΠΎΠ»ΡΠ·ΠΎΠ²Π°Π½ΠΈΠ΅ΠΌ ΡΠ²Π΅ΡΠ΅ΠΉ Π½Π΅ΠΎΠ±Ρ ΠΎΠ΄ΠΈΠΌΠΎ ΠΏΡΠΎΠ²Π΅ΡΡΠΈ ΡΠΏΡΠΈΠ½ΡΠ΅Π²Π°Π½ΠΈΠ΅ ΡΠ°ΡΡΠ²ΠΎΡΠΎΠΌ ΡΡΡΠ°ΡΠΈΠ»ΠΈΠ½Π°. ΠΠ°Π·Π½Π°ΡΠ°ΡΡ:
- Π‘Π²Π΅ΡΠΈ ΠΠ΅ΠΏΠ°Π½ΡΠΎΠ», ΠΎΠΊΠ°Π·ΡΠ²Π°ΡΡ ΡΠ΅Π³Π΅Π½Π΅ΡΠΈΡΡΡΡΠ΅Π΅, ΠΏΡΠΎΡΠΈΠ²ΠΎΠΌΠΈΠΊΡΠΎΠ±Π½ΠΎΠ΅ Π΄Π΅ΠΉΡΡΠ²ΠΈΠ΅. ΠΡΠΈΠΌΠ΅Π½ΡΡΡ Π΄Π²Π°ΠΆΠ΄Ρ Π² ΡΡΡΠΊΠΈ, Π² ΡΠ΅ΡΠ΅Π½ΠΈΠ΅ Π½Π΅Π΄Π΅Π»ΠΈ.

- Π‘Π²Π΅ΡΠΈ ΠΠ΅ΡΠΈΠ»ΡΡΠ°ΡΠΈΠ», ΠΎΠ±Π»Π°Π΄Π°ΡΡ Π·Π°ΠΆΠΈΠ²Π»ΡΡΡΠΈΠΌ, ΠΏΡΠΎΡΠΈΠ²ΠΎΠ²ΠΎΡΠΏΠ°Π»ΠΈΡΠ΅Π»ΡΠ½ΡΠΌ Π΄Π΅ΠΉΡΡΠ²ΠΈΠ΅ΠΌ, ΡΠΏΠΎΡΠΎΠ±Π½Ρ Π²ΠΎΡΡΡΠ°Π½ΠΎΠ²ΠΈΡΡ ΠΈΠΌΠΌΡΠ½ΠΈΡΠ΅Ρ. Π£Π»ΡΡΡΠ°ΡΡ ΠΎΠ±ΠΌΠ΅Π½Π½ΡΠ΅ ΠΏΡΠΎΡΠ΅ΡΡΡ ΠΈ ΠΏΠΈΡΠ°Π½ΠΈΠ΅ Π² ΠΊΠ»Π΅ΡΠΊΠ°Ρ
. Π‘Π²Π΅ΡΠΈ ΠΠ΅ΡΠΈΠ»ΡΡΠ°ΡΠΈΠ» ΡΠ²Π»ΡΡΡΡΡ ΡΠ΅ΠΊΡΠ°Π»ΡΠ½ΡΠΌΠΈ, Π½ΠΎ ΠΌΠΎΠ³ΡΡ Π½Π°Π·Π½Π°ΡΠ°ΡΡΡΡ Π³ΠΈΠ½Π΅ΠΊΠΎΠ»ΠΎΠ³Π°ΠΌΠΈ Π΄Π»Ρ ΠΈΡΠΏΠΎΠ»ΡΠ·ΠΎΠ²Π°Π½ΠΈΡ Π²Π°Π³ΠΈΠ½Π°Π»ΡΠ½ΠΎ. Π Π°Π·ΠΎΠ²Π°Ρ Π΄ΠΎΠ·Π° 1-2 ΡΡΠΏΠΏΠΎΠ·ΠΈΡΠΎΡΠΈΡ Π΄ΠΎ 4-Ρ
ΡΠ°Π· Π² Π΄Π΅Π½Ρ. ΠΡΠΎΠ΄ΠΎΠ»ΠΆΠΈΡΠ΅Π»ΡΠ½ΠΎΡΡΡ Π»Π΅ΡΠ΅Π½ΠΈΡ ΠΎΠΏΡΠ΅Π΄Π΅Π»ΡΠ΅ΡΡΡ Π²ΡΠ°ΡΠΎΠΌ, Π½ΠΎ Π½Π΅ Π±ΠΎΠ»Π΅Π΅ 4-Ρ
ΠΌΠ΅ΡΡΡΠ΅Π².

- Π‘ΡΠΏΠΏΠΎΠ·ΠΈΡΠΎΡΠΈΠΈ Ρ ΠΎΠ±Π»Π΅ΠΏΠΈΡ ΠΎΠ²ΡΠΌ ΠΌΠ°ΡΠ»ΠΎΠΌ. ΠΠ±Π»Π°Π΄Π°ΡΡ Π·Π°ΠΆΠΈΠ²Π»ΡΡΡΠΈΠΌ Π΄Π΅ΠΉΡΡΠ²ΠΈΠ΅ΠΌ, ΡΠ½ΠΈΠΌΠ°ΡΡ Π±ΠΎΠ»Π΅Π²ΡΠ΅ ΠΎΡΡΡΠ΅Π½ΠΈΡ, ΡΠ³Π½Π΅ΡΠ°ΡΡ ΠΏΠ°ΡΠΎΠ³Π΅Π½Π½ΡΠ΅ ΠΌΠΈΠΊΡΠΎΠΎΡΠ³Π°Π½ΠΈΠ·ΠΌΡ, ΡΠ½ΠΈΠΌΠ°ΡΡ ΠΎΡΠ΅ΡΠ½ΠΎΡΡΡ ΠΈ Π²ΠΎΡΠΏΠ°Π»Π΅Π½ΠΈΠ΅ ΠΏΠΎΡΠ»Π΅ ΠΏΡΠΈΠΆΠΈΠ³Π°Π½ΠΈΡ. ΠΠ΅ΡΠ΅Π½ΠΈΠ΅ ΠΏΡΠΎΠ²ΠΎΠ΄ΡΡ Π² ΡΠ΅ΡΠ΅Π½ΠΈΠ΅ 14 Π΄Π½Π΅ΠΉ, ΠΏΠΎ ΠΎΠ΄Π½ΠΎΠΉ 2 ΡΠ°Π·Π° Π² Π΄Π΅Π½Ρ.
ΠΠΎΡΠ»Π΅ Π»Π΅ΡΠ΅Π½ΠΈΡ ΡΠ°Π΄ΠΈΠΎΠ²ΠΎΠ»Π½Π°ΠΌΠΈ
ΠΠ΅ΡΠ΅Π½ΠΈΠ΅ ΡΡΠΎΠ·ΠΈΠΈ ΡΠ°Π΄ΠΈΠΎΠ²ΠΎΠ»Π½Π°ΠΌΠΈ β ΡΡΠΎ ΡΠΎΠ²ΡΠ΅ΠΌΠ΅Π½Π½ΡΠΉ ΠΌΠ΅ΡΠΎΠ΄, ΠΊΠΎΡΠΎΡΡΠΉ ΠΎΡΠ»ΠΈΡΠ°Π΅ΡΡΡ:
- Π²ΡΡΠΎΠΊΠΈΠΌ ΡΡΠΎΠ²Π½Π΅ΠΌ ΡΡΡΠ΅ΠΊΡΠΈΠ²Π½ΠΎΡΡΠΈ,
- ΠΎΡΡΡΡΡΡΠ²ΠΈΠ΅ΠΌ Π±ΠΎΠ»Π΅Π·Π½Π΅Π½Π½ΡΡ ΠΎΡΡΡΠ΅Π½ΠΈΠΉ,
- Π±ΡΡΡΡΡΠΌ Π²ΠΎΡΡΡΠ°Π½ΠΎΠ²Π»Π΅Π½ΠΈΠ΅ΠΌ ΡΠΊΠ°Π½Π΅ΠΉ Π±Π΅Π· ΠΎΠ±ΡΠ°Π·ΠΎΠ²Π°Π½ΠΈΡ ΡΡΠ±ΡΠ°, ΠΏΠΎΡΡΠΎΠΌΡ ΠΏΠΎΠ΄Ρ ΠΎΠ΄ΠΈΡ Π½Π΅ΡΠΎΠΆΠ°Π²ΡΠΈΠΌ ΠΆΠ΅Π½ΡΠΈΠ½Π°ΠΌ,
- Π°Π½ΡΠΈΠ±Π°ΠΊΡΠ΅ΡΠΈΠ°Π»ΡΠ½ΡΠΌ ΡΡΡΠ΅ΠΊΡΠΎΠΌ,
- Π΅Π΄ΠΈΠ½ΡΡΠ²Π΅Π½Π½ΡΠΌ Π½Π΅Π΄ΠΎΡΡΠ°ΡΠΊΠΎΠΌ β Π²ΡΡΠΎΠΊΠΎΠΉ ΡΡΠΎΠΈΠΌΠΎΡΡΡΡ.
ΠΡΠΎΡΠ΅Π΄ΡΡΠ° Π΄Π»ΠΈΡΡΡ 15 ΠΌΠΈΠ½ΡΡ, ΠΏΡΠΎΡ ΠΎΠ΄ΠΈΡ Π±Π΅Π·Π±ΠΎΠ»Π΅Π·Π½Π΅Π½Π½ΠΎ. ΠΠΎΡΠ»Π΅ ΠΏΡΠΈΠΆΠΈΠ³Π°Π½ΠΈΡ ΡΡΠΎΠ·ΠΈΠΈ ΡΠ΅ΠΉΠΊΠΈ ΠΌΠ°ΡΠΊΠΈ ΡΠ°Π΄ΠΈΠΎΠ²ΠΎΠ»Π½Π°ΠΌΠΈ ΠΏΡΠΈΠΌΠ΅Π½Π΅Π½ΠΈΠ΅ ΠΌΠ΅ΡΡΠ½ΡΡ ΠΏΡΠ΅ΠΏΠ°ΡΠ°ΡΠΎΠ² Π½Π΅ ΡΡΠ΅Π±ΡΠ΅ΡΡΡ, ΠΈΠ»ΠΈ Π²ΡΠ°Ρ ΠΌΠΎΠΆΠ΅Ρ Π½Π°Π·Π½Π°ΡΠΈΡΡ ΡΠ²Π΅ΡΠΈ ΠΠ΅ΠΏΠ°Π½ΡΠΎΠ». ΠΠ»Ρ ΠΏΠΎΠ»Π½ΠΎΠ³ΠΎ Π²ΠΎΡΡΡΠ°Π½ΠΎΠ²Π»Π΅Π½ΠΈΡ ΡΠ»ΠΈΠ·ΠΈΡΡΠΎΠΉ ΡΠΊΠ°Π½ΠΈ ΠΏΠΎΡΠ»Π΅ ΠΏΡΠΈΠΌΠ΅Π½Π΅Π½ΠΈΡ ΡΠ°Π΄ΠΈΠΎΠ²ΠΎΠ»Π½ ΡΡΠ΅Π±ΡΠ΅ΡΡΡ ΠΌΠ΅ΡΡΡ.
ΠΊ ΡΠΎΠ΄Π΅ΡΠΆΠ°Π½ΠΈΡ βΠΠΎΡΠ»Π΅ ΠΏΡΠΈΠΌΠ΅Π½Π΅Π½ΠΈΡ Π°Π·ΠΎΡΠ°
ΠΡΠΏΠΎΠ»ΡΠ·ΠΎΠ²Π°Π½ΠΈΠ΅ Π² Π»Π΅ΡΠ΅Π½ΠΈΠΈ ΡΡΠΎΠ·ΠΈΠΈ ΠΆΠΈΠ΄ΠΊΠΎΠ³ΠΎ Π°Π·ΠΎΡΠ° ΠΎΡΠ½ΠΎΠ²Π°Π½ΠΎ Π½Π° Π΅Π³ΠΎ ΡΠΏΠΎΡΠΎΠ±Π½ΠΎΡΡΠΈ Π·Π°ΠΌΠΎΡΠ°ΠΆΠΈΠ²Π°ΡΡ ΡΠΊΠ°Π½ΠΈ, Ρ ΠΎΠ±ΡΠ°Π·ΠΎΠ²Π°Π½ΠΈΠ΅ΠΌ ΠΊΠΎΡΠΎΡΠ΅ΠΊ, ΠΊΠΎΡΠΎΡΡΠ΅ Π²ΠΏΠΎΡΠ»Π΅Π΄ΡΡΠ²ΠΈΠΈ ΠΎΡΠΌΠΈΡΠ°ΡΡ. ΠΡΠΎΡΠ΅Π΄ΡΡΠ° Π½Π΅ Π²ΡΠ·ΡΠ²Π°Π΅Ρ Π±ΠΎΠ»Π΅Π²ΠΎΠΉ ΡΠ΅Π°ΠΊΡΠΈΠΈ, ΠΏΠΎΡΠ»Π΅ ΠΊΠΎΠ°Π³ΡΠ»ΡΡΠΈΠΈ Π½Π΅ ΠΎΡΡΠ°Π΅ΡΡΡ ΡΡΠ±ΡΠ° (ΠΌΠΎΠΆΠ½ΠΎ ΠΏΡΠΈΠΌΠ΅Π½ΡΡΡ Π½Π΅ΡΠΎΠΆΠ°Π²ΡΠΈΠΌ ΠΆΠ΅Π½ΡΠΈΠ½Π°ΠΌ).
ΠΠ΅ΡΠΎΠ΄ ΡΡΡΠ΅ΠΊΡΠΈΠ²Π΅Π½ ΡΠΎΠ»ΡΠΊΠΎ ΠΏΡΠΈ ΡΡΠΎΠ·ΠΈΠΈ Π½Π΅Π±ΠΎΠ»ΡΡΠΈΡ ΡΠ°Π·ΠΌΠ΅ΡΠΎΠ².
Π§Π΅ΡΠ΅Π· Π΄Π²Π΅ Π½Π΅Π΄Π΅Π»ΠΈ Π½Π° ΠΌΠ΅ΡΡΠ΅ Π²ΠΎΠ·Π΄Π΅ΠΉΡΡΠ²ΠΈΡ Π°Π·ΠΎΡΠΎΠΌ ΠΏΡΠΎΠΈΡΡ ΠΎΠ΄ΠΈΡ ΡΠΎΡΠΌΠΈΡΠΎΠ²Π°Π½ΠΈΠ΅ Π·Π΄ΠΎΡΠΎΠ²ΠΎΠΉ ΡΠΊΠ°Π½ΠΈ, ΡΡΡΡΠΏ ΠΎΡΡΠΎΡΠ³Π°Π΅ΡΡΡ. ΠΠΎΡΠ»Π΅ ΡΡΠΎΠ³ΠΎ ΠΏΡΠΈΠΌΠ΅Π½ΡΡΡΡΡ ΠΏΡΠ΅ΠΏΠ°ΡΠ°ΡΡ ΠΠ΅ΠΏΠ°Π½ΡΠΎΠ» ΠΈΠ»ΠΈ ΠΠ΅ΡΠΈΠ»ΡΡΠ°ΡΠΈΠ» Π΄Π»Ρ Π·Π°ΠΆΠΈΠ²Π»Π΅Π½ΠΈΡ. ΠΠ° ΠΏΠΎΠ»Π½ΠΎΠ΅ Π²ΠΎΡΡΡΠ°Π½ΠΎΠ²Π»Π΅Π½ΠΈΠ΅ ΡΠ»ΠΈΠ·ΠΈΡΡΠΎΠΉ ΡΡΠ΅Π±ΡΠ΅ΡΡΡ ΠΏΠΎΠ»ΡΠΎΡΠ° ΠΌΠ΅ΡΡΡΠ°, Π² ΡΡΠΎΡ ΠΏΠ΅ΡΠΈΠΎΠ΄ Π²ΠΎΠ·ΠΌΠΎΠΆΠ½Ρ Π½Π΅Π±ΠΎΠ»ΡΡΠΈΠ΅ ΠΌΠ°ΠΆΡΡΠΈΠ΅ Π²ΡΠ΄Π΅Π»Π΅Π½ΠΈΡ.
ΠΊ ΡΠΎΠ΄Π΅ΡΠΆΠ°Π½ΠΈΡ βΠΠΎΡΠ»Π΅ ΠΏΡΠΈΠΌΠ΅Π½Π΅Π½ΠΈΡ Π»Π°Π·Π΅ΡΠ°
ΠΠ°Π·Π΅ΡΠ½Π°Ρ Π²Π°ΠΏΠΎΡΠΈΠ·Π°ΡΠΈΡ β ΡΡΠΎ Π±Π΅Π·ΠΎΠΏΠ°ΡΠ½ΡΠΉ ΠΈ Π²ΡΡΠΎΠΊΠΎΡΡΡΠ΅ΠΊΡΠΈΠ²Π½ΡΠΉ ΠΌΠ΅ΡΠΎΠ΄ Π»Π΅ΡΠ΅Π½ΠΈΡ, ΡΠ΅ΡΠΈΠ΄ΠΈΠ²Ρ ΡΡΠΎΠ·ΠΈΠΈ Π²ΠΎΠ·Π½ΠΈΠΊΠ°ΡΡ ΠΊΡΠ°ΠΉΠ½Π΅ ΡΠ΅Π΄ΠΊΠΎ. ΠΠ΅ΡΠΎΠ΄ ΠΏΠΎΠ·Π²ΠΎΠ»ΡΠ΅Ρ ΡΠΎΡΠ½ΠΎ Π²ΠΎΠ·Π΄Π΅ΠΉΡΡΠ²ΠΎΠ²Π°ΡΡ Π½Π° ΠΎΡΠ°Π³ΠΈ ΡΡΠΎΠ·ΠΈΠΈ ΠΏΠΎΠ΄ ΠΊΠΎΠ½ΡΡΠΎΠ»Π΅ΠΌ Π²ΠΈΠ΄Π΅ΠΎΠΊΠΎΠ»ΡΠΏΠΎΡΠΊΠΎΠΏΠ°, ΠΏΡΠΎΠ²ΠΎΠ΄ΠΈΡΡΡ Π±Π΅Π· ΠΏΡΠΈΠΌΠ΅Π½Π΅Π½ΠΈΡ ΠΎΠ±Π΅Π·Π±ΠΎΠ»ΠΈΠ²Π°ΡΡΠΈΡ ΡΡΠ΅Π΄ΡΡΠ².
ΠΠΎΡΠ»Π΅ ΠΏΡΠΈΠΆΠΈΠ³Π°Π½ΠΈΡ Π½Π° ΡΠ΅ΠΉΠΊΠ΅ Π½Π΅ ΠΎΡΡΠ°Π΅ΡΡΡ ΡΡΠ±ΡΠΎΠ², ΠΏΠΎΡΡΠΎΠΌΡ ΡΠΈΡΠΎΠΊΠΎ ΠΏΡΠΈΠΌΠ΅Π½ΡΠ΅ΡΡΡ Π΄Π»Ρ Π»Π΅ΡΠ΅Π½ΠΈΡ ΡΡΠΎΠ·ΠΈΠΈ Ρ Π½Π΅ΡΠΎΠΆΠ°Π²ΡΠΈΡ .
ΠΠ»Ρ ΡΡΠΊΠΎΡΠ΅Π½ΠΈΡ Π·Π°ΠΆΠΈΠ²Π»Π΅Π½ΠΈΡ ΡΠΊΠ°Π½Π΅ΠΉ ΠΏΠΎΡΠ»Π΅ ΠΏΡΠΈΠΆΠΈΠ³Π°Π½ΠΈΡ Π½Π°Π·Π½Π°ΡΠ°ΡΡ Π»ΡΠ±ΡΠ΅ ΡΠ²Π΅ΡΠΈ Ρ ΡΠ΅Π³Π΅Π½Π΅ΡΠΈΡΡΡΡΠΈΠΌ Π΄Π΅ΠΉΡΡΠ²ΠΈΠ΅ΠΌ (ΠΠ΅ΠΏΠ°Π½ΡΠΎΠ» ΠΈ Π΄Ρ.).
ΠΊ ΡΠΎΠ΄Π΅ΡΠΆΠ°Π½ΠΈΡ βΠΠΎΡΠ»Π΅ Ρ ΠΈΠΌΠΈΡΠ΅ΡΠΊΠΎΠΉ ΠΊΠΎΠ°Π³ΡΠ»ΡΡΠΈΠΈ
ΠΠ΅ΡΠΎΠ΄ Ρ ΠΈΠΌΠΈΡΠ΅ΡΠΊΠΎΠΉ ΠΊΠΎΠ°Π³ΡΠ»ΡΡΠΈΠΈ Π·Π°ΠΊΠ»ΡΡΠ°Π΅ΡΡΡ Π² Π½Π°Π½Π΅ΡΠ΅Π½ΠΈΠΈ Π½Π° ΠΏΠΎΠ²ΡΠ΅ΠΆΠ΄Π΅Π½Π½ΡΠ΅ ΡΡΠ°ΡΡΠΊΠΈ ΡΠ»ΠΈΠ·ΠΈΡΡΠΎΠΉ ΡΠ΅ΠΉΠΊΠΈ Π°ΠΊΡΠΈΠ²Π½ΡΡ ΠΏΡΠ΅ΠΏΠ°ΡΠ°ΡΠΎΠ². ΠΡΠΎΡΠ΅Π΄ΡΡΡ ΠΏΡΠΎΠ²ΠΎΠ΄ΡΡ Ρ ΠΏΡΠΈΠΌΠ΅Π½Π΅Π½ΠΈΠ΅ΠΌ ΠΊΠΎΠ»ΡΠΏΠΎΡΠΊΠΎΠΏΠ°, ΡΡΠΎ ΠΎΠ±Π΅ΡΠΏΠ΅ΡΠΈΠ²Π°Π΅Ρ ΡΠΎΡΠ½ΠΎΡΡΡ ΠΎΠ±ΡΠ°Π±ΠΎΡΠΊΠΈ. ΠΠ»Ρ ΠΏΡΠΈΠΆΠΈΠ³Π°Π½ΠΈΡ ΠΈΡΠΏΠΎΠ»ΡΠ·ΡΡΡ Π‘ΠΎΠ»ΠΊΠΎΠ²Π°Π³ΠΈΠ½ ΠΈ ΠΠ°Π³ΠΎΡΠΈΠ». ΠΠ΅ΠΉΡΡΠ²ΡΡΡΠΈΠ΅ Π²Π΅ΡΠ΅ΡΡΠ²Π° ΠΏΡΠ΅ΠΏΠ°ΡΠ°ΡΠΎΠ² ΡΠ°Π·ΡΡΡΠ°ΡΡ Π²Π΅ΡΡ Π½ΠΈΠΉ ΡΠ»ΠΎΠΉ ΠΊΠ»Π΅ΡΠΎΠΊ, Π½Π° ΠΌΠ΅ΡΡΠ΅ ΠΊΠΎΡΠΎΡΡΡ Π½Π°ΡΠΈΠ½Π°Π΅Ρ ΡΠΎΡΠΌΠΈΡΠΎΠ²Π°ΡΡΡΡ Π·Π΄ΠΎΡΠΎΠ²ΡΠΉ ΡΠ»ΠΎΠΉ ΡΠ»ΠΈΠ·ΠΈΡΡΠΎΠΉ.
Π ΠΎΡΡΠΈΡΠ°ΡΠ΅Π»ΡΠ½ΡΠΌ ΠΌΠΎΠΌΠ΅Π½ΡΠ°ΠΌ ΠΌΠ΅ΡΠΎΠ΄Π° ΠΎΡΠ½ΠΎΡΡΡΡΡ Π΄Π»ΠΈΡΠ΅Π»ΡΠ½ΠΎΡΡΡ Π²ΠΎΠ·Π΄Π΅ΠΉΡΡΠ²ΠΈΡ ΠΏΡΠ΅ΠΏΠ°ΡΠ°ΡΠΎΠ² Π΄ΠΎ Π½Π°ΡΡΡΠΏΠ»Π΅Π½ΠΈΡ ΡΡΡΠ΅ΠΊΡΠ°, ΡΠΎΡΠΌΠΈΡΠΎΠ²Π°Π½ΠΈΠ΅ ΡΡΠ±ΡΠΎΠ², Π½ΠΈΠ·ΠΊΠ°Ρ ΡΡΡΠ΅ΠΊΡΠΈΠ²Π½ΠΎΡΡΡ ΠΈ Π²ΡΡΠΎΠΊΠΈΠΉ ΠΏΡΠΎΡΠ΅Π½Ρ ΡΠ΅ΡΠΈΠ΄ΠΈΠ²ΠΎΠ².
ΠΡΠΈΠΌΠ΅Π½Π΅Π½ΠΈΠ΅ ΠΏΠΎΡΠ»Π΅ Ρ ΠΈΠΌΠΈΡΠ΅ΡΠΊΠΎΠΉ ΠΊΠΎΠ°Π³ΡΠ»ΡΡΠΈΠΈ Π·Π°ΠΆΠΈΠ²Π»ΡΡΡΠΈΡ ΠΈ ΠΏΡΠΎΡΠΈΠ²ΠΎΠ²ΠΎΡΠΏΠ°Π»ΠΈΡΠ΅Π»ΡΠ½ΡΡ ΡΠ²Π΅ΡΠ΅ΠΉ ΠΎΠ±ΡΠ·Π°ΡΠ΅Π»ΡΠ½ΠΎ, Π½ΠΎ ΠΏΠΎ Π½Π°Π·Π½Π°ΡΠ΅Π½ΠΈΡ Π²ΡΠ°ΡΠ°.
ΠΊ ΡΠΎΠ΄Π΅ΡΠΆΠ°Π½ΠΈΡ βΠΠΎΡΠ»Π΅ ΠΏΡΠΈΠΆΠΈΠ³Π°Π½ΠΈΡ Π°ΡΠ³ΠΎΠ½ΠΎΠΌ
Π‘ΠΎΠ²ΡΠ΅ΠΌΠ΅Π½Π½ΡΠΉ ΠΌΠ΅ΡΠΎΠ΄ Π°ΡΠ³ΠΎΠ½ΠΎΠ²ΠΎΠΉ ΠΊΠΎΠ°Π³ΡΠ»ΡΡΠΈΠΈ Π·Π°ΠΊΠ»ΡΡΠ°Π΅ΡΡΡ Π² Π²ΠΎΠ·Π΄Π΅ΠΉΡΡΠ²ΠΈΠΈ Π½Π° ΡΡΠΎΠ·ΠΈΡ Π°ΡΠ³ΠΎΠ½ΠΎΠ²ΠΎΠΉ ΠΏΠ»Π°Π·ΠΌΠΎΠΉ. ΠΡΠΎΠΈΡΡ ΠΎΠ΄ΠΈΡ Π½Π°Π³ΡΠ΅Π²Π°Π½ΠΈΠ΅ ΠΈ ΠΎΡΠΌΠΈΡΠ°Π½ΠΈΠ΅ ΠΎΠ±ΡΠ°Π±Π°ΡΡΠ²Π°Π΅ΠΌΠΎΠ³ΠΎ ΡΡΠ°ΡΡΠΊΠ°.
ΠΠ΅ΡΠ΅Π½ΠΈΠ΅ Π°ΡΠ³ΠΎΠ½ΠΎΠΌ ΠΏΡΠΎΡ ΠΎΠ΄ΠΈΡ Π±Π΅Π·Π±ΠΎΠ»Π΅Π·Π½Π΅Π½Π½ΠΎ, Π½Π΅ ΠΎΡΡΠ°Π²Π»ΡΠ΅Ρ ΡΡΠ±ΡΠΎΠ² Π½Π° ΡΠ»ΠΈΠ·ΠΈΡΡΠΎΠΉ ΡΠΊΠ°Π½ΠΈ, ΡΠ΅ΠΊΠΎΠΌΠ΅Π½Π΄ΠΎΠ²Π°Π½ΠΎ Π½Π΅ΡΠΎΠΆΠ°Π²ΡΠΈΠΌ ΠΆΠ΅Π½ΡΠΈΠ½Π°ΠΌ.
ΠΠΎΠ»Π½ΠΎΠ΅ Π²ΠΎΡΡΡΠ°Π½ΠΎΠ²Π»Π΅Π½ΠΈΠ΅ ΠΏΡΠΎΠΈΡΡ ΠΎΠ΄ΠΈΡ Π·Π° ΠΊΠΎΡΠΎΡΠΊΠΎΠ΅ Π²ΡΠ΅ΠΌΡ, Π² ΡΡΠΎΡ ΠΏΠ΅ΡΠΈΠΎΠ΄ Π½Π°Π·Π½Π°ΡΠ°ΡΡ ΡΠ²Π΅ΡΠΈ Ρ Π·Π°ΠΆΠΈΠ²Π»ΡΡΡΠΈΠΌ ΡΡΡΠ΅ΠΊΡΠΎΠΌ (ΠΠ΅ΠΏΠ°Π½ΡΠΎΠ», ΠΠ΅ΡΠΈΠ»ΡΡΠ°ΡΠΈΠ»).
ΠΊ ΡΠΎΠ΄Π΅ΡΠΆΠ°Π½ΠΈΡ βΠΡΠΎΡΠΈΠ²ΠΎΠΏΠΎΠΊΠ°Π·Π°Π½ΠΈΡ ΠΊ ΠΏΡΠΈΠΌΠ΅Π½Π΅Π½ΠΈΡ ΡΠ²Π΅ΡΠ΅ΠΉ
- ΠΠΎΡΠΏΠ°Π»ΠΈΡΠ΅Π»ΡΠ½ΡΠ΅ ΠΈ ΠΈΠ½ΡΠ΅ΠΊΡΠΈΠΎΠ½Π½ΡΠ΅ Π·Π°Π±ΠΎΠ»Π΅Π²Π°Π½ΠΈΡ ΠΏΠΎ Π³ΠΈΠ½Π΅ΠΊΠΎΠ»ΠΎΠ³ΠΈΠΈ.
- Π Π°Π·Π½ΡΠ΅ ΠΊΡΠΎΠ²ΠΎΡΠ΅ΡΠ΅Π½ΠΈΡ.
- ΠΠ»ΠΎΠΊΠ°ΡΠ΅ΡΡΠ²Π΅Π½Π½ΡΠ΅ ΠΎΠ±ΡΠ°Π·ΠΎΠ²Π°Π½ΠΈΡ ΡΠ΅ΠΉΠΊΠΈ ΠΌΠ°ΡΠΊΠΈ.
- ΠΠ΅ΡΠ΅ΠΌΠ΅Π½Π½ΠΎΡΡΡ ΠΈΠ»ΠΈ ΠΏΠ΅ΡΠΈΠΎΠ΄ ΡΡΠ°Π·Ρ ΠΏΠΎΡΠ»Π΅ ΡΠΎΠ΄ΠΎΠ², ΠΏΡΠΈΠΌΠ΅Π½Π΅Π½ΠΈΠ΅ ΠΊΠ΅ΡΠ°ΡΠ΅Π²ΠΎ ΡΠ΅ΡΠ΅Π½ΠΈΡ, Π΄Π»ΠΈΡΠ΅Π»ΡΠ½ΠΎΠ΅ Π²ΠΎΡΡΡΠ°Π½ΠΎΠ²Π»Π΅Π½ΠΈΠ΅ ΠΏΠΎΡΠ»Π΅ ΡΠΎΠ΄ΠΎΠ².
- Π₯ΡΠΎΠ½ΠΈΡΠ΅ΡΠΊΠΈΠ΅ Π·Π°Π±ΠΎΠ»Π΅Π²Π°Π½ΠΈΡ Π² ΡΡΠ°Π΄ΠΈΠΈ ΠΎΠ±ΠΎΡΡΡΠ΅Π½ΠΈΡ, ΠΏΡΠΈΡ ΠΈΡΠ΅ΡΠΊΠΈΠ΅ Π½Π°ΡΡΡΠ΅Π½ΠΈΡ, ΡΠ°Ρ Π°ΡΠ½ΡΠΉ Π΄ΠΈΠ°Π±Π΅Ρ.
- ΠΠ°Π±ΠΎΠ»Π΅Π²Π°Π½ΠΈΡ ΠΊΡΠΎΠ²ΠΈ (Π½Π°ΡΡΡΠ΅Π½ΠΈΠ΅ ΡΠ²ΡΡΡΡΠ²Π°Π΅ΠΌΠΎΡΡΠΈ).
- ΠΡΠΏΠΎΠ»ΡΠ·ΠΎΠ²Π°Π½ΠΈΠ΅ Π²Π½ΡΡΡΠΈΠΌΠ°ΡΠΎΡΠ½ΠΎΠΉ ΡΠΏΠΈΡΠ°Π»ΠΈ.
- ΠΠ½ΡΠΈΡΠΈΡΠΎΠ²Π°Π½ΠΈΠ΅ Π²ΠΈΡΡΡΠΎΠΌ ΠΏΠ°ΠΏΠΈΠ»Π»ΠΎΠΌΡ ΡΠ΅Π»ΠΎΠ²Π΅ΠΊΠ°.
vashamatka.ru

